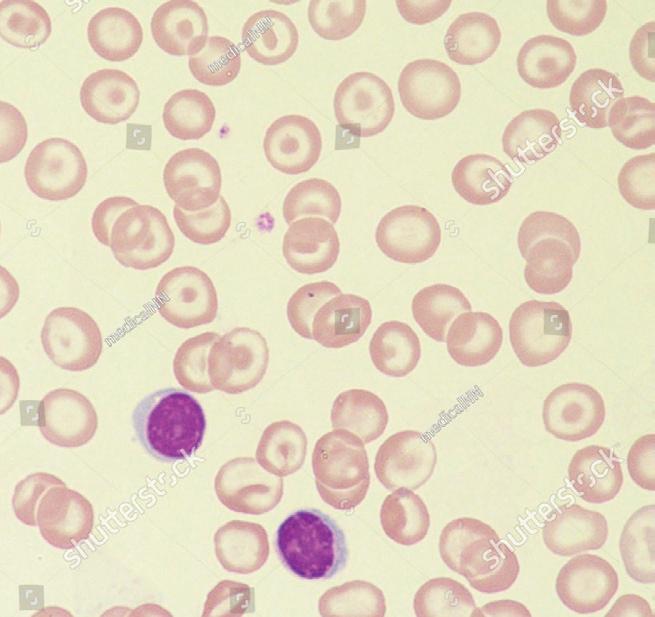
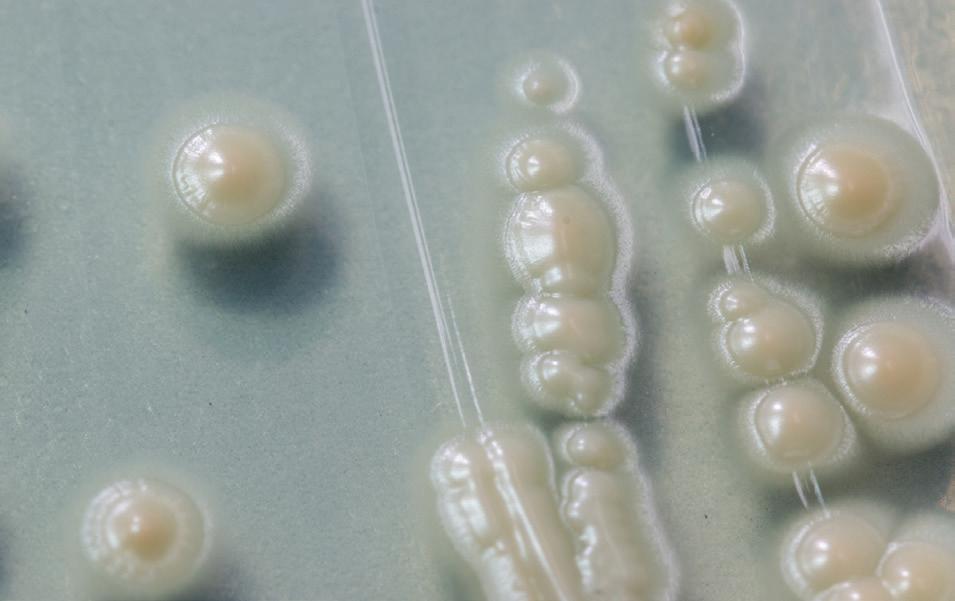

BIOLOGY

PAGE PROOF
This
To
oup.com.au/qldbio.


This
To
oup.com.au/qldbio.
Using Biology for Queensland Units 1 & 2
Module 1 Biology toolkit
1.1 Studying QCE Biology
1.2 Considering First Nations perspectives in biology
1.3 Understanding the scientific method
1.4 Planning investigations
1.5 Considering safety and ethics
1.6 Collecting data
1.7 Presenting and analysing data
1.8 Evaluating evidence
1.9 Communicating scientifically
1.10 Preparing for your data test
1.11 Conducting your student experiment
1.12 Conducting your research investigation
1.13 Preparing for your exams
Module 1 review
2.1 The cell as the building block of life
2.2 Eukaryotic cell organelles
2.3 Practical: Use of the light microscope
2.4 Practical: Preparation and examination of wet mount specimens
2.5 The cell membrane
2.6 Movement of substances into and out of the cell
2.7 Practical: Identifying organelles from electron micrographs
2.8 Cell size
Module 2 review
3.1 Formation of the multicellular organism
3.2 Organisation of cells in multicellular organisms
3.3 Practical: Organisation of cells into tissues, organs and systems
3.4 Mitosis
3.5 Stem cells
3.6 Cell specialisation
Module 3 review
Topic 1 review
4.1 Organic compounds in living things
4.2 Enzymes
4.3 Practical: The effect of enzyme concentration on the rate of reaction
Module 4 review
5.1 Transport in animals
5.2 The mammalian circulatory system
Module 5 review
6.1 Digestion
6.2 The human digestive system
6.3 Practical: The effect of temperature on the rate of reactions of an enzyme
6.4 Practical: The effect of pH on the rate of enzyme reactions
6.5 Excretion
Module 6 review
Topic 2 review
7.1 Cellular energy
7.2 Biological energy transformations
7.3 Aerobic respiration
7.4 Practical: Investigating respiration
7.5 Anaerobic cellular respiration
Module 7 review
8.1 Gas exchange in humans
8.2 Carriage of respiratory gases in the blood
Module 8 review
Module 9 Plant physiology
9.1 Photosynthesis
9.2 Gas exchange in plants
9.3 Practical: Stomatal function
9.4 Movement of water in the xylem
9.5 Practical: The passage of water through flowering plants
9.6 Practical: Factors affecting the rate of transpiration
9.7 Movement of organic molecules in the phloem
Module 9 review
Topic 3 review
Unit 1 review
10.1 Homeostasis
10.2 Practical: Tolerance limits for water or salt balance in plants
10.3 The nervous system
10.4 Practical: The reflex arc
10.5 Organisation of the nervous system
10.6 Sensory receptors
10.5 Chemical control
10.6 The endocrine system
Module 10 review
11.1 Thermoregulation
11.2 Thermoregulatory mechanisms of endotherms
11.3 Thermoregulation in humans
11.4 Osmoregulation in humans
11.5 Osmoregulation in plants
11.6 Practical: The role of the leaf in plant osmoregulation
Module 11 review
Topic 1 review
12.1 Infectious and non-infectious disease
12.2 Non-living pathogens
12.3 Living pathogens
12.4 Practical: The effect of an antimicrobial on the growth of a microbial organism
12.5 Pathogen virulence
12.6 The immune response
12.7 Immunity
12.8 Plant immune responses
Module 12 review
13.1 Transmission of disease
13.2 Identifying and monitoring disease
13.3 Controlling the spread of disease
Module 13 review
Topic 2 review
Glossary Index

In Unit 1, students explore the ways biology is used to describe and explain how the structure and function of cells and their components are related to the need to exchange matter and energy with their immediate environment. An understanding of the structure and function of cells is essential to appreciate the processes vital for survival. Students investigate the structure and function of cells and multicellular organisms. They examine the structure and function of plant and animal systems at cell and tissue levels in order to analyse how they facilitate the efficient provision or removal of materials.
Topic 1
Cells as the basis of life
Topic 2
Exchange of nutrients and wastes
Topic 3 Cellular energy, gas exchange and plant physiology

2 and 3
4 to 6
7 to 9
1 Describe ideas and findings about cells as the basis of life, exchange of nutrients and wastes, and cellular energy and gas exchange.
2 Apply understanding of cells as the basis of life, exchange of nutrients and wastes and cellular energy and gas exchange.
3 Analyse data about cells as the basis of life, exchange of nutrients and wastes, and cellular energy and gas exchange.
4 Interpret evidence about cells as the basis of life, exchange of nutrients and wastes, and cellular energy and gas exchange.
5 Evaluate processes, claims and conclusions about cells as the basis of life, exchange of nutrients and wastes and cellular energy and gas exchange.
6 Investigate phenomena associated with cells as the basis of life, exchange of nutrients and wastes, and cellular energy and gas exchange.
The basic unit of structure and function in living organisms is the cell. More complex cells contain several smaller structures that perform important functions within the cell. To survive, the cell must be physically separated from the environment and yet capable of exchanging material with it. The cell membrane forms this boundary. The efficiency of exchange decreases as cells increase in size0, so there is limit to how large a cell can grow. Most cells, therefore, can be seen only when viewed through a microscope.
Prior knowledge quiz

Check your understanding of concepts related to cell structure before you start.
→ Compare prokaryotic and eukaryotic cells.
→ Identify key organelles and their functions, including the nucleus, mitochondria, rough ER, ribosomes, smooth ER, Golgi apparatus, lysosomes, vacuoles and chloroplasts.
→ Explain that each body system contains specialised cells and tissues that are structurally suited to function, including – size and shape (SA:V ratio) – organelle composition.
→ Describe the structure and function of the cell membrane based on the fluid mosaic model, including the role of protein channels, phospholipids, cholesterol and glycoproteins.
Full lessons for this module are available exclusively on Oxford Digital.

→ Explain how the cell membrane regulates movement of substances into and out of the cell via
– osmosis
– simple diffusion
– facilitated diffusion
– protein-mediated active transport
– endocytosis and exocytosis.
→ Compare active and passive transport.
→ Explain how the size of a cell is limited by surface area-to-volume ratio and rate of diffusion.
→ Interpret data from an experiment investigating the effect of surface area-to-volume ratio on the rate of diffusion.
→ Compare organelle composition of different cell types using electron micrographs
→ Investigate the effect of surface area-to-volume ratio on rate of diffusion.
Biology 2025 v1.1 General Senior Syllabus © State of Queensland (QCAA) 2025
These lessons are available exclusively on Oxford Digital.
Lesson 2.3 Preparation and examination of wet mount specimens
Lesson 2.4 Identifying organelles from electron micrographs
Lesson 2.7 Modelling the selectively permeable cell membrane
Lesson 2.9 The effect of surface area to volume ratio on the rate of diffusion
Learning intentions and success criteria
organism a living thing
cell
the basic unit of life, able to perform all fundamental processes of life
unicellular composed of a single cell
microscopic so small that it can only be seen with a microscope
multicellular composed of m any cells
colonial composed of many unicellular organisms joined into a cluster, where each individual cell can carry out all the functions necessary for life
cell membrane
a selectively permeable barrier that controls the movement of substances into and out of the cell
cytoplasm cell contents not including the nucleus
Study tip
Most cells are very small in size, but there are a few notable exceptions. For example, an unfertilised emu’s egg is made up of a single cell 13 cm long.
→ All living things are composed of cells, the building blocks of life.
→ Unicellular organisms consist of one cell, while multicellular organisms consist of many cells.
→ Prokaryotes are unicellular organisms that do not have membrane-bound organelles.
→ Eukaryotes are organisms whose cells have membrane-bound organelles.
Every organism (living thing) is made up of cells, the basic unit of life. Cells are membrane-bound structures that perform all the processes required to sustain life. They tend to be very small (0.5–10 µ, or micrometres, in diameter, where 1 µ = 10 –6 m = 1 millionth of a metre). The smallest organisms, which consist of only one cell, are called unicellular organisms (“uni” = one). Almost all unicellular organisms are microscopic. Larger organisms, which can consist of anything from two to trillions of cells working together, are called multicellular organisms. In multicellular organisms, different cells perform different jobs to keep the organism alive. Each cell works with, and relies on, other cells to survive.


Occasionally, cells in a group can be closely associated with each other but not directly connected. These groups of cells are described as colonial. Colonial cells work together and divide their functions, but each cell is technically able to live independently. An example of this is the bluebottle jellyfish, which is not a single animal but, rather, a colony of four kinds of highly modified individuals (zooids) that work together to survive.

Bluebottle or Pacific Man-of-War is not a single animal but a colony of four kinds of highly modified individuals (zooids).
All the chemical reactions required for a cell to stay alive occur in the internal environment of a cell. To maintain this internal environment, the cell must be physically separated from the environment but still able to acquire nutrients and remove wastes. To enable this, all cells have the following features:
• a cell membrane that encases the cell and forms a boundary between the chemical reactions occurring inside the cell and the external environment that surrounds the cell
• cytoplasm , a liquid medium that fills the cell and holds other cellular components
• deoxyribonucleic acid (DNA), a type of nucleic acid that contains all the genetic information and instructions needed for the cell to survive
• ribosomes, small intracellular structures that are used to create proteins. While all cells have these structural features in common, there are two main categories of cells: prokaryotic cells and eukaryotic cells
deoxyribonucleic acid (DNA) a molecule found in nearly all living cells which contains the genetic information responsible for the development and function of an organism
ribosome a complex molecular structure found in all cells which creates proteins in a process called protein synthesis
It is believed that the first life forms arose in unique environmental conditions about four billion years ago, in a process called abiogenesis. These first organisms were prokaryotes, singlecelled organisms that lacked smaller membrane-bound components. These early cells consisted of a cell membrane that contained a watery mixture of organic chemicals and a nucleic acid strand. It is highly likely that there were many types of nucleic acid, each coding for slightly different proteins, and so the earliest cells would have been slightly different from each other right from the beginning. All the chemical processes required to sustain life occurred in these single cells.
Prokaryotes include all bacteria and archaea. It is theorised that they mutated and changed over billions of years into diverse types with different physical and chemical characteristics. However, all prokaryotes have the following general features:
• consist of a single cell
• small size
• contained within a semi-rigid cell wall
• do not contain membrane-bound organelles
The DNA or genetic material of prokaryotes is usually located in an area of the cell called the nucleoid region in the form of a single circular chromosome (Figure 3). Prokaryotes do not have compartmentalisation of cell contents for specific functions; however, they do contain ribosomes scattered throughout the cytoplasm of the cell.
prokaryotic cell a cell that does not contain a membranebound nucleus or membrane-bound organelles
eukaryotic cell a cell that contains membrane-bound organelles
abiogenesis the theory that living organisms formed from non-living matter
prokaryote an organism without a membrane-bound nucleus or membranebound organelles
cell wall
a rigid structure surrounding plant, fungal and prokaryotic cells; provides protection and support for the cell; made up of murein (prokaryotic cells), cellulose (plant cells) or chitin (fungal cells)
organelle
a subcellular structure that has at least one specific function
nucleoid region in prokaryotic cells, the region within the cell in which genetic material is located; not bounded by a membrane
chromosome a thread-shaped body consisting of nucleic acid (usually DNA) and protein (except in bacteria)
capsule the outermost layer of a prokaryotic cell, made of polysaccharides; plays a role in adhering to surfaces, substances and other bacteria
flagellum a whip-like extension of the cell, used in locomotion by some bacteria, protozoa and spermatozoa; plural “flagella”
pili in many prokaryotes, small hair-like projections that are used for adhesion to surfaces, other bacteria and host cells
Some prokaryotes have evolved specialised features to help them survive, such as:
• a capsule – a sticky outer layer that protects the cell and helps it adhere to substances
• a flagellum – a hair-like appendage that helps the cell to move around or swim in an aqueous or liquid environment
• pili – small hair-like structures on the cell’s surface that help the cell attach to other surfaces. In addition to having different structural features, prokaryotes have also evolved to survive in specific environments. Some prokaryotes will die in the presence of oxygen, while others cannot survive without it. Some are heterotrophs (feed on other organisms), some use inorganic molecules to provide for their energy needs (chemosynthesis) and others rely on photosynthesis.

4 All
nucleus control centre of the eukaryotic cell
eukaryote an organism whose cells contain membrane-bound organelles
For larger cells, it is more difficult and inefficient for nutrients to get to all parts of the cell, and for waste products to leave the cell. Eukaryotic cells, which are larger than prokaryotes, contain membrane-bound organelles. The DNA of eukaryotes is enclosed by a double-layered membrane, forming a nucleus. The cytoplasm contains membrane-bound organelles that have different functions and work together to help the cell survive. Having membranebound organelles has enabled eukaryotic cells to be larger in size than a typical prokaryotic cell. You will learn more about eukaryotic cell organelles in Lesson 2.2. Organisms made up of eukaryotic cells are known as eukaryotes. Animals, plants, protists and fungi are all examples of eukaryotes.
One theory of the evolution of eukaryotic cells is the endosymbiotic hypothesis, in which small prokaryotic cells survived within a larger prokaryotic cell in a symbiotic relationship, later becoming the organelles of a now eukaryotic cell. Further mutations in these cells resulted in different types of single-celled eukaryotic organisms. The development of the eukaryotic cell paved the way for the evolution of the multicellular organism. Different cells could become specialised for specific functions because of the numbers and types of organelles they possessed.
Membrane of larger cell
Membrane of smaller cell
FIGURE 7 Endosymbiosis is thought to have led to the evolution of cells with organelles.
Prokaryotes are the most ancient cells. They are smaller than eukaryotic cells and have a simpler structure (Table 1). Like plant cells, prokaryotes have a semi-rigid cell wall surrounding the cell membrane; however, in prokaryotes the cell wall is made of murein (a protein–carbohydrate complex). Prokaryotes also lack distinct membrane-bound organelles and a cytoskeleton. The genetic material is bound into a single circular DNA molecule floating within the cytoplasm. Smaller circular molecules of DNA, called plasmids, are not part of the prokaryote’s chromosome, but can carry antibiotic resistance and other genetic advantages. Although many ribosomes are present in prokaryotes, they are not attached to any other structure and differ chemically from those of eukaryotes. Some bacteria have flagella. However, the flagellum is outside the cell membrane and is different in structure from those of animals. Table 1 provides a comparison of the structures in prokaryotic and eukaryotic cells.
Eukaryotic cell
Prokaryotic cell
Nucleus
Ribosomes
Golgi apparatus
Endoplasmic reticulum
Plasma membrane
Mitochondrion
Cytoplasm Lysosome

FIGURE 6 Eukaryotic and prokaryotic cell structure
murein a glycoprotein that forms the cell wall in bacteria antibiotic resistance the ability of bacteria to resist the effects of an antibiotic to which they were once sensitive
TABLE 1 Comparison of eukaryotic and prokaryotic cells
Structure
Cell wall
Eukaryotic cells
Absent in animal cells, present in plant cells (cellulose) and fungal cells (chitin)
Prokaryotic cells
Present (murein)
Cell membrane Present Present
Nucleus Surrounded by membrane
Chromosomes Multiple, composed of nucleic acid (linear DNA) and proteins
Ribosomes Present
Chloroplasts
Endoplasmic reticulum
Golgi apparatus
Lysosomes
Membrane-bound organelles
Mitochondria
Vacuoles
Present (chloroplasts only in plants)
Not surrounded by membrane
Singular, composed only of nucleic acid (circular DNA)
Present but are different chemically
Absent
Flagella Complex, with microtubules
Check your learning 2.1
Check Your Learning 2.1: Complete these questions online or in your workbook.
Retrieval and comprehension
1 Define the following terms:
a cell (1 mark)
b unicellular (1 mark)
c multicellular. (1 mark)
2 Identify two structural features that could be used determine whether a cell is prokaryotic or eukaryotic. (2 marks)
3 Identify two differences between animal cells and plant cells. (2 marks)
4 E xplain why eukaryotic cells require specialised organelles. (1 mark)
Simple, with no microtubules (extracellular, i.e. not enclosed by the cell membrane)
Analytical processes
5 Differentiate between a prokaryote and a eukaryote. (2 marks)
Knowledge utilisation
6 Determine whether the following cells are prokaryotic or eukaryotic based on the descriptions given.
a The cell appears to have no membranebound nucleus. (1 mark)
b The cell has numerous organelles. (1 mark)
c The sample is a specialised human skin cell. (1 mark)
Key ideas
→ Organelles have different structures and functions.
→ Animal cells and plant cells are organised differently.
The cells of eukaryotic organisms contain membrane-bound organelles. Most of these structures are not normally visible under the light microscope but can be viewed with an electron microscope. Organelles are not scattered randomly throughout the cytoplasm. In most cells, the nucleus has a central position in the cell and the other organelles are located around the nucleus in a way that facilitates a range of cellular functions. In this lesson you will learn about the functions of organelles in eukaryotic organisms. Many organelles are found in both animal and plant cells – these include the nucleus, mitochondria, rough ER, ribosomes, smooth ER, Golgi apparatus, lysosomes and vacuoles.
Learning intentions and success criteria
chromatin the nucleoprotein (complex of DNA bound around proteins) of chromosomes seen as fine, dispersed threads of genetic material and found in eukaryotic cells
The nucleus is the control centre of a cell. It controls cell activity through DNA, the genetic material that controls protein production and cell division. In a non-dividing cell, DNA and protein form a diffuse network of threads called chromatin. During cell division, chromatin condenses into chromosomes. The nucleus is surrounded by a double membrane, called the nuclear envelope, which has pores that allow specific molecules into and out of the nucleus. The nucleus contains the nucleolus, which is composed of proteins, DNA and RNA, and produces ribosomes. The nucleoplasm is the total contents of the nucleus.
Mitochondria (singular “mitochondrion”) are the site of chemical reactions that release energy in a usable form. They are often referred to as the “powerhouse” of the cell. They are cigar-shaped organelles that are bound by a double membrane. The inner membrane is folded into cristae, which increase the surface area for attachment of enzymes and their metabolic reactions. The membranes enclose a fluid matrix. Mitochondria contain special mitochondrial DNA and ribosomes that control their enzyme production, and allow them to replicate. Mitochondria are crucial for the process of cellular respiration.

The endoplasmic reticulum is a network of flattened, membrane-bound sacs called cisternae. It is located relatively close to the nucleus of the cell, because it is primarily involved in synthesising and transporting molecules around the cell. There are two types of endoplasmic reticulum:
nuclear envelope the membrane that encloses the nucleus and is structurally similar to the cell membrane; allows the transport of specific molecules into and out of the nucleus; must be broken down for cell division to occur
nucleolus a spherical area within the nucleus that is the site of ribosome production; contains RNA and proteins
nucleoplasm a protoplasm within the nuclear membrane; contains DNA, RNA and proteins; involved in control of cell activities through protein production and cell division
mitochondrion a membrane-bound cellular organelle; has enzymes for cellular respiration on inner folded membrane (cristae), and a fluid matrix; plural “mitochondria”
cellular respiration a cellular process in which glucose is broken down to release energy in many small, enzymecontrolled reactions
smooth endoplasmic reticulum (smooth ER)
a membranous structure with connections to both nuclear and cell membranes, involved in production, storage and transport of materials within the cell; lipids and steroids are produced here
rough endoplasmic reticulum (rough ER)
a membranous structure with connections to both nuclear and cell membranes, involved in production, storage and transport of materials within the cell; proteins are synthesised on ribosomes
Inner membrane
Outer membrane
Ribosomes Matrix
Cristae
Mitochondrial DNA
FIGURE 2 The structure of a mitochondrion
Outer membrane Inner membrane
Matrix space Cristae

Inter-membrane space Cytosol
FIGURE 3 Electron micrograph of a mitochondrion
• smooth endoplasmic reticulum – responsible for the synthesis and transport of lipids and steroids
• rough endoplasmic reticulum – studded with ribosomes on the membrane surface to facilitate the synthesis of proteins. The transport of proteins occurs in the cisternae. The extensive network of the endoplasmic reticulum provides a large surface area for enzyme-mediated metabolic reactions to occur.
Nuclear membrane
Rough endoplasmic reticulum Ribosomes Pore
Golgi apparatus
a membranous stack of cisternae involved in the packaging and secretion of cell products
Chromatin
Nucleolus Smooth endoplasmic reticulum


The Golgi apparatus is a stack of flattened membranous sacs (cisternae), which are continually being formed at one end and budding off as vesicles at the other. They are closely associated with the endoplasmic reticulum and receive enzymes, proteins, lipids, glycoproteins and polysaccharides that are synthesised there. Once these substances are received, the Golgi apparatus encloses them in membranes and releases them either into the cytoplasm or outside the cell. Consequently, they serve as collecting, sorting, processing and distribution centres for these molecules, much like a “post office” for the cell.
A vacuole is a membranous sac that stores different molecules. In animal cells, vacuoles are small and are typically used for food storage and digestion. Plant cells tend to have one large central vacuole that contains cell sap and is used for storage of substances and control of water levels in the cell (osmotic balance).
A lysosome is a simple spherical sac containing digestive enzymes. Lysosomes can fuse with vesicles or food vacuoles to digest their contents. Unwanted cellular products and wastes are broken down (autophagy) by lysosomes. Lysosomes can also break down damaged cells (autolysis) and destroy invading bacteria.
Plant and animal cells have many organelles in common; however, plants contain some organelles that are not found in animals. These organelles, including chloroplasts and cell walls, have evolved in plant cells to optimise the plants’ chances of survival.


vacuole a cellular inclusion or space within the cell; small in animal cells (food storage or digestion), large in plant cells (storage and osmotic control)
lysosome an organelle that contains digestive enzymes involved in intracellular digestion
Chloroplasts are large, consisting of a fluid matrix or stroma and stacks of flattened membranous discs called grana (single stack = “granum”). A single disc is called a thylakoid. Chloroplasts contain chlorophyll, and their function is photosynthesis. Like mitochondria, they also contain DNA and ribosomes, and can replicate.
Chloroplasts are an important site of photosynthesis. Photosynthesis is a process that occurs in plant cells, in which light energy is converted into the chemical energy of glucose through a series of reactions. These reactions require chlorophyll, sunlight, water and carbon dioxide.

chloroplast a plastid (small membrane-bound organelle containing pigment) in the cells of green plants; contains chlorophyll on membranous grana, and enzymes in the liquid stroma; a photosynthetic organelle grana stacked portions of membranes within chloroplasts; the site of light-dependent reactions for photosynthesis; a single stack is a “granum”

A cell wall is a non-living structure composed of cellulose that encases the cell membrane. It may be secondarily thickened with the chemical lignin. The cell wall provides mechanical support and protection of the cell. It prevents the cell from rupturing when large amounts of water diffuse into the cell (turgor pressure). A middle lamella between the walls of adjacent cells cements neighbouring cells together. The gaps in the cell wall can allow two plant cells to connect to each other. These links are called plasmodesmata. They allow rapid movement of materials from cell to cell.
The number of specific organelles in a cell can vary, depending on the cell’s function. For example, human heart muscle cells contain much higher concentrations of mitochondria than other human cells, because the heart requires large amounts of energy to function.
In a similar way, the presence or lack of certain organelles in a cell is also determined by the cell’s function. For example, plant root cells do not have chloroplasts, because they are not exposed to sunlight and do not need to use sunlight to make glucose. Leaf cells, which are directly exposed to light, contain many chloroplasts. The chloroplasts in leaf cells are packed close to the surface, and are positioned with their grana facing the light source.
While animal and plant cells share many common organelles, their general organisation differs. Figures 12 and 13 show the general structure of animal cells and plant cells.
Cell wall
Central vacuole
Chloroplast
Microbody
Mitochondrion
14 A plant cell
Nucleus
Rough endoplasmic reticulum
Smooth endoplasmic reticulum Ribosomes
Golgi body
Lysosome
Plasma membrane
Microtubule
Microfilament Cytoskeleton
cell theory the theory that all organisms are made up of cells and their products, and that growth and reproduction are fundamentally due to division of cells
The relationship between science and technology is clearly demonstrated in the development of the cell theory. Anatomy and the study of body organs can be traced back to at least 1600 BC. However, prior to 1665, there was no knowledge of cells because they were too small to be seen by the naked eye. Before this time, living things were believed to have generated spontaneously. For example, it was believed that maggots sprouted directly from rotting meat. It was only after the invention of the microscope that scientists discovered the previously unseen world of cells. Following the discovery of cells in the seventeenth century, advances in our understanding of cells slowed. Two scientists (Matthias Schleiden and Theodor Schwann) are credited with having developed the cell theory in the nineteenth century. According to the cell theory:
• all known living things are made up of one or more cells
• all living cells arise from pre-existing cells by division.
This more complex understanding of the existence and function of cells developed as scientists discovered previously unknown organisms, such as protists and bacteria, that were too small to be seen without a microscope. They were also able to observe the structural differences between various types of cells, such as red blood cells and sperm cells.
Later developments in technology allowed scientists to investigate these smaller structures, including the different organelles within cells. Lysosomes and peroxisomes, for example, were only discovered in the midtwentieth century. Today, scientists continue to “zoom in” on the smaller components of cells, to discover the chemical composition and functions of organelles and other features, such as the role of DNA in cell activities.
1 Describe the cell theory. (1 mark)
2 E xplain why scientists were limited in their understanding of cells until the 1600s despite the human body having been studied since at least 1600 BC. (2 marks)
Check your learning 2.2
Check Your Learning 2.2: Complete these questions online or in your workbook.
Retrieval and comprehension
1 Describe the main functions of the following cell parts. Indicate the type(s) of cells in which they are usually found. (18 marks)
a Cell wall
b Chloroplast
c Endoplasmic reticulum
d Golgi apparatus
e Lysosome
f Mitochondrion
g Nucleus
h Ribosome
i Vacuole
2 Using the letters in the diagram, identify each of the organelles in this plant cell. (12 marks)
ANALYTICAL PROCESSES
3 Compare rough and smooth endoplasmic reticulum. (3 marks)

4 C ompare the structures and functions of a chloroplast and a mitochondrion. (3 marks)
Learning intentions and success criteria Lesson 2.4
This lesson is available exclusively on Oxford Digital.
This lesson is available exclusively on Oxford Digital.
→ The cell membrane is a selectively permeable barrier.
→ The fluid mosaic model describes the chemical structure of the cell membrane.
→ Protein channels, phospholipids, cholesterol and glycoproteins all have specific roles in the cell membrane.
The cell membrane is a selectively permeable barrier that controls the movement of substances into and out of the cell. It is described as “selectively permeable” because some small molecules (such as water) can diffuse through easily, while larger molecules (such as proteins) are prevented from moving through the membrane. A permeable membrane allows the free movement of all molecules in both directions. A selectively permeable membrane allows particular molecules that fit with the selective criteria to move through.
The structure of the cell membrane allows it to carry out the following functions:
• aid in the transport of materials into and out of the cell
• provide mechanical support to the cell, so the cell can maintain its shape
• act as a receptor for chemical materials (e.g. hormones) and maintain the specificity of a particular cell type.
Learning intentions and success criteria

FIGURE 1 Light microscope image of liver cells (hepatocytes). Each cell is encased in a cell membrane.
phospholipid bilayer
The cell membrane is very thin – about 7.5 nm (nanometres) (1 nm = 10 –9 m). The basic structure of the membrane is known as a phospholipid bilayer. This is because it consists of two thin sheets of polar phospholipids. A phospholipid is a molecule that has a negatively charged phosphate “head” and two fatty acid “tails”. The phosphate end of the molecule can mix well with water and is therefore described as hydrophilic (water-loving). The fatty acid tails do not mix with water and are described as hydrophobic (water-hating). The hydrophobic nature of the fatty acid tails means that only small, uncharged, relatively hydrophobic molecules can easily pass across the phospholipid bilayer.
the main structure of the cell membrane, consisting of two layers of phospholipids arranged with the hydrophilic heads facing the internal and external fluid environments phospholipid the major unit of the phospholipid bilayer, composed of a hydrophilic phosphate head and hydrophobic fatty acid tails; provides structure for the cell and helps separate the cytoplasm from the external environment
This part of the molecule is very soluble in water. Organic
These parts of the molecule are very insoluble in water. Tail
Hydrophobic ends face each other.
Polar hydrophilic head
A phospholipid molecule
Non-polar hydrophobic tail
Extracellular fluid
Hydrophilic ends face the water environment.
Cell cytoplasm
2 Phospholipid molecule: (A) simplified version (B) molecule and arrangement of the phospholipid bilayer
fluid mosaic model a description of how molecules are arranged in the cell membrane; “mosaic” refers to the many types of molecules (including phospholipids) that make up the structure of the membrane; “fluid” refers to the constant movement of the phospholipids and other molecules that make up the membrane
The cell membrane must be arranged as a double layer because it is surrounded on both sides by a water-based mixture (the extracellular fluid and the cytoplasm). This also dictates the orientation of the individual phospholipid molecules. The hydrophobic tails repulse water, so the phospholipid molecules automatically arrange themselves so that the hydrophobic tails are sandwiched between the hydrophilic phosphate heads. This arrangement of these molecules is termed a bilayer.
As with all molecules, the phospholipid molecules move about. However, their polarity restricts their movement mainly to the lateral plane. A lot of energy is required to move the phospholipid molecules from one layer to the other, because the hydrophilic head must pass through the hydrophobic tail region. The tails must come into contact with water in this action. As a result, “flip-flop” movement is very rare.
‘Flip-flops’
The cell membrane is not just made up of phospholipids. According to the fluid mosaic model, the cell membrane is a dynamic structure that is embedded with a range of molecules, such as protein channels, cholesterol and glycoproteins. Some of these molecules are able to move about freely, while others are fixed in position by microfilaments running into the cytoplasm.
Some proteins, known as integral proteins, penetrate either part of the way into the cell membrane (monotopic) or all the way through it (transmembrane). The middle parts of these proteins are hydrophobic and can therefore mix freely with the hydrocarbon tails of the membrane lipids. The parts of the protein in contact with extracellular or intracellular fluid are hydrophilic. Peripheral proteins are proteins that are situated outside the cell membrane or attached to the outer surfaces of integral proteins. These peripheral proteins are weakly bound to the membrane or other proteins.
Carbohydrates
Peripheral proteins
Peripheral protein
Integral proteins
Peripheral protein
FIGURE 5 The cell membrane consists of integral proteins, which penetrate either partially or fully through the membrane, and peripheral proteins, which are situated along the surface of the membrane.
Integral proteins usually have a hydrophobic portion that interacts with the phospholipids, and a hydrophilic portion facing the water-based surroundings. Some of the proteins (of which thousands may occur in membranes) may be purely structural in function. Others act as carrier molecules in transporting specific substances through the membrane. It is thought that hydrophilic channels called protein channels occur within integral proteins or between adjacent protein molecules. These channels allow the passage of large molecules, and some water-soluble molecules (such as glucose and amino acids) that otherwise would be excluded by the phospholipid molecules. Other membrane proteins may act as recognition markers or receptor molecules that bind to chemical messengers that may be in the fluid outside the cell.
integral protein a protein within the structure of the cell membrane peripheral protein a protein attached to, or partially embedded in, the cell membrane protein channel a channel that passes through the centre of a protein; its lining is hydrophilic and it is the site of facilitated diffusion of large or highly polarised molecules
FIGURE 6 Protein channels allow large molecules, and some water-soluble molecules, to pass through the cell membrane.
glycoprotein a peripheral protein with attached polysaccharides, used in signalling, cell-cell communication and tissue formation
Glycoproteins are peripheral proteins in the cell membrane. They have branching carbohydrate portions on their free surfaces. These antennae-like carbohydrate chains are made up of several sugar molecules and have a range of precisely defined patterns. Glycoproteins are important recognition features that:
• facilitate cell-to-cell binding when the sugar recognition site on one glycoprotein adheres to the surface of another cell (this triggers cells to orientate themselves a certain way and aids with tissue formation)
Carbohydrate chain
antigen a protein on the surface of matter that is foreign to the body
• act as specific markers when the body is trying to defend itself (for example, antigens in the immune response)
• facilitate cell-to-cell communication and targeted response (for example, hormones and other chemicals have recognition sites that enable them to be taken up specifically by cells that have the complementary sites).
cholesterol a steroid in animals; an important component of cell membranes and a precursor molecule for other steroids
Glycoprotein
FIGURE 7 Glycoproteins are proteins that have an attached carbohydrate chain that extends out from the surface of the cell membrane.
Cholesterol is located between the phospholipid molecules in the bilipid layer. It also has hydrophobic and hydrophilic portions. Cholesterol regulates the fluidity of the membrane so that it is neither too rigid nor too fluid for the functioning of the cell. The fluidity of the cell membrane is temperature dependent: as temperature increases, membrane fluidity increases. Therefore, the role of cholesterol is also temperature dependent. At high temperatures, cholesterol stabilises the cell membrane, decreasing the fluidity and keeping the cell from rupturing. At low temperatures, the cholesterol tail helps to separate the phospholipid tails, maintaining fluidity within the cell membrane. Cholesterol also plays a role in regulating “flip-flopping” of phospholipids and proteins, and causes integral proteins to change their conformation or distribution throughout the cell membrane.
Different types of phospholipids in the membrane affect its properties, such as fluidity and permeability. In turn, these properties affect the ease with which membranes fuse with each other, and the activity of the protein channels and glycoproteins. The variations in membrane properties of different cells can be attributed to differences in:
• lipid composition – this affects the membrane’s fluidity
• integral proteins – this affects the sizes and specificity of the protein channels
• peripheral and integral proteins – this affects the: – recognition sites – carrier molecules
enzymes attached.
Check your learning 2.5
Check Your Learning 2.5: Complete these questions online or in your workbook.
Retrieval and comprehension
1 Summarise two functions of proteins in the cell membrane. (2 marks)
2 Identify three factors that determine whether a particle will pass through a cell membrane’s phospholipid bilayer. (3 marks)
3 Describe the three functions of the cell membrane. (3 marks)
4 Describe the role of cholesterol in the cell membrane. (1 mark)
Analytical processes
5 Deduce why recognition sites on the outside of cell membranes are significant for living things. (3 marks)
Key ideas
→ Passive transport is a way of moving molecules across the cell membrane that does not require energy.
→ Simple diffusion, facilitated diffusion and osmosis are forms of passive transport.
→ Active transport is the energy-consuming transport of molecules or ions across a membrane against a concentration gradient or an ionic gradient.
→ Protein-mediated active transport, exocytosis and endocytosis are forms of active transport.
The cell membrane is a major barrier that is impermeable to many water-soluble substances, such as ions, glucose and amino acids. Lipid-soluble substances such as oxygen, nitrogen and alcohols can dissolve into phospholipids and diffuse rapidly through the cell membrane as if it were not there. Even though water is highly insoluble in the membrane phospholipids, it is readily able to penetrate the phospholipid layer. The reason for this is not certain. It is theorised that water molecules are small enough in size and have enough kinetic energy to penetrate the lipid portion before the hydrophobic “tails” can stop them. Water is also able to pass through protein channels.
The very fluid nature of the cell membrane ensures that it is in constant motion, so small molecules can pass between the lipid molecules. At any time, there are “pores” in the membrane that allow small molecules, such as water, or water-soluble molecules, such as urea, to pass through.
The phospholipid bilayer is impermeable to ions because of their electrical charge, and to glucose and amino acids because of their larger size. These molecules must enter the cell through the channels in the integral proteins.
Learning intentions and success criteria
solvent the liquid in which other substances (solutes) are dissolved to form a solution
solute the substance that is dissolved in a solution passive transport the movement of materials into and out of a cell without the expenditure of energy active transport the movement of materials into and out of a cell, usually against a concentration or ionic gradient, requiring cellular energy (ATP)
Various materials must move into and out of cells so that biological activities can take place in the cell. The cell membrane allows some solute molecules or ions, but not others, to move freely through it – it is selectively permeable. A permeable membrane allows the free movement of all molecules in both directions. Often, a selectively permeable membrane allows solvent molecules and excludes solute molecules.
Materials move into and out of cells via passive transport or active transport .
bilayer
Phospholipid
Phospholipid molecule
Certain water-soluble molecules and ions (simple di usion)
Hydrophobic tail
Protein channel
Hydrophilic head
diffusion the movement of molecules from an area of greater concentration to an area of lower concentration
Outside of the cell
Protein molecules
Inside of the cell
Lipid-soluble molecules (simple di usion)
Tiny molecules
Carrier proteins
Facilitated di usion
Energy
Active transport
Passive transport is a way of moving molecules across the cell membrane that does not require energy. Many molecules do not need extra energy to move across a membrane. Passive transport can be further broken into categories as shown in Figure 1.
Diffusion is the process by which molecules, or ions of liquids or gases, tend to spread out from regions of higher concentration to regions of lower concentration. This results from their random movement (Brownian motion). Eventually, the molecules become evenly distributed throughout the space they occupy. For example, a sugar cube (solute) placed in water (solvent) will dissolve and slowly spread throughout the solution.
Three main factors affect the rate of diffusion.
• Temperature – molecules move faster at higher temperatures, so diffusion is faster at high temperatures.
• Particle size – small molecules require less energy to move, so smaller particles diffuse faster than larger particles.
• Concentration – the greater the difference in concentration between the two locations (the concentration gradient), the more quickly diffusion occurs. Diffusion through the cell membrane consists of two processes: simple diffusion and facilitated diffusion
Simple diffusion is the free and unaided movement of molecules or ions through the cell membrane from an area of high solute concentration to an area of low solute concentration. Certain molecules, such as those that are soluble in both water and lipids, can pass freely through the cell membrane. If the concentration of such a molecule outside a cell is higher than that inside the cell, a concentration gradient exists. Initially, the number of molecules entering the cell is greater than the number exiting the cell, and so there is a net flow into the cell. Once inside the cell, some molecules continue to move and are used in cellular processes. As the concentrations on both sides of the membrane become equal, the number of molecules passing from each direction becomes the same. This point is called dynamic equilibrium – when the number of molecules entering the system is equal to the number of molecules leaving.
concentration gradient a difference in the concentration of a solution at two different points, e.g. across a barrier such as a cell membrane
simple diffusion the unaided movement of molecules or ions across a differentially permeable membrane from an area of high solute concentration to an area of low solute concentration
Lipid bilayer (plasma membrane)
Time
Cytoplasm Extracellular fluid
Figure 3 Simple diffusion occurs when molecules move freely from an area of high concentration to an area of low concentration until equilibrium is reached.
Sometimes, specific proteins in the cell membrane provide a pathway for particular molecules that cannot pass freely through the membrane. This passive movement through a membrane with the help of a protein, from an area of high solute concentration to an area of low solute concentration, is called facilitated diffusion. For example, glucose molecules are insoluble in the phospholipid bilayer of the cell membrane and are too large to pass through. However, the glucose plus its protein carrier is soluble in lipids and can diffuse across. It is thought that no overall energy is expended in this process. Two types of proteins make facilitated diffusion possible.
facilitated diffusion the passive movement of molecules loosely bound to carrier molecules through the cell membrane from an area of high solute concentration to an area of low solute concentration
dynamic equilibrium a state of balance that exists when the amount of a particular substance entering a cell is the same as the amount leaving it
isotonic describes a solution that has an equal solute concentration to that of its surroundings
carrier protein a protein in the cell membrane that transports a molecule across the phospholipid bilayer through an enzyme-like structural change
• Channel proteins are typically used to transport ions into and out of the cell. Open channel proteins act as an open pore in the membrane that allows particles to flow into and out of the cell. Gated channel proteins are specific – they will open and shut in response to certain molecules or triggers.
• Carrier proteins change shape to allow a molecule to pass through the membrane after the molecule binds to a specific receptor on the surface of the protein.
osmosis the movement of water through a selectively permeable membrane, from a region of low solute concentration to a region of high solute concentration, to counteract the difference in solute concentration
4 Channel proteins and carrier proteins are involved in facilitated diffusion.
Osmosis is the passive movement of water molecules across a selectively permeable membrane from an area of low solute concentration to an area of high solute concentration. Osmosis occurs when there is a concentration gradient of solute (dissolved molecules) across a membrane that is impermeable to the solute. Because the high solute concentration traps many of the water molecules around the hydrophilic solute, the water molecules are not free to move back across the membrane. For example, when a cell is placed in a strong sugar solution, the sugar cannot diffuse through the cell membrane. There is a net flow of water out of the cell to a region of high solute concentration, until the concentration on both sides of the cell is equal. Water moves from area of low solute concentration to high concentration.
FIGURE 5 Osmosis is the movement of water molecules across a selectively permeable membrane from an area of low solute concentration to an area of high solute concentration.
Osmotic potential is the capacity of a solution to lose water molecules through a selectively permeable membrane. If the osmotic potential of a cell is low, there will be a net flow of water into the cell by osmosis. If the osmotic potential is high, there will be a net flow of water out of the cell by osmosis. In an isotonic solution, the same amount of water leaves the cell as enters.
Osmotic potential is determined by the concentration of the solute in the solution (e.g. the cytoplasm of a cell), compared with the concentration on the other side of the membrane (e.g. extracellular fluid). If the solute concentration in the extracellular fluid is higher than the solute concentration in the cytoplasm, the surrounding extracellular solution is said to be hypertonic , and its osmotic potential is low. Water will move out of the cell. If the solute concentration of the surrounding extracellular fluid is lower than the solute concentration of the cytoplasm in the cell, the solution of the extracellular fluid is hypotonic , and its osmotic potential is high. Water will move into the cell. When the solute concentration of the extracellular fluid is the same as that inside the cell, the solutions are said to be isotonic (Table 1).
osmotic potential the potential for water to move through a permeable membrane from an area of low solute concentration to an area of high solute concentration
hypertonic describes a solution that has a higher solute concentration than that of its surroundings
hypotonic describes a solution that has a lower solute concentration than that of its surroundings
TABLE 1 Relationship between solute concentration and osmotic potential between extracellular fluid and the cytoplasm in cells
Extracellular solute concentration
Cytoplasm solute concentration
Osmotic potential of extracellular fluid and direction of water movement
Example in animal cell
Low – water moves out of the cell Nil – water moves into and out of the cell at an even rate


High – water moves into the cell





























plasmolysis
the shrinkage of the cytoplasm of a plant cell away from the cell wall as a result of loss of water from the cell by osmosis
turgor pressure the inward pressure exerted on plant cells due to the presence of the cell wall
Study tip
“Where salt goes, water flows.” This suggests that there is a net water movement towards the higher solute concentration.
Plant cells have large vacuoles that are involved in maintaining the water balance of the cell. In doing so, they are important in the support structure of non-woody plants. When plant cells are placed in a hypertonic solution, the cell wall remains rigid but the protoplasm loses water through osmosis and the membrane shrinks away from it, because the fluid of the vacuole is reduced in volume by osmosis. Shrinkage of the cytoplasmic membrane away from the cell wall is known as plasmolysis. If these cells are then placed in distilled water or a hypotonic solution, water enters the cytoplasm and the vacuole, and restores the cell to its normal state. The cell is now deplasmolysed.
Plasma membrane
protein-mediated active transport the transport of molecules or ions against a concentration gradient via specific proteins; requires energy (ATP) and is therefore considered “active”
When plant cells are placed in a hypotonic solution, water enters the cell by osmosis. The volume of the total cell contents increases and exerts turgor pressure against the rigid cell wall. When this is at a maximum, no net movement of water into the cell can occur. The cell is fully turgid. The cell wall prevents further uptake and so protects the cell membrane from rupturing.
A similar phenomenon occurs in animal cells. However, because animal cells do not have a cell wall, in a hypertonic solution the entire cell shrinks and shrivels (crenation). In a hypotonic solution the cell expands, stretching the cell membrane, which may burst (lysis).

Water enters cell


Nucleus
• protein-mediated active transport
• endocytosis
• exocytosis.








FIGURE 6 If an animal cell is placed in a hypotonic solution and swells too much, it may burst. This is known as lysis.
Active transport is the energy-consuming transport of molecules or ions across a membrane against a concentration gradient or an ionic gradient. Energy is required because the substance must be moved against its natural tendency to diffuse in the opposite direction. Movement is unidirectional. In contrast, diffusion is reversible, depending on the direction of the concentration gradient. Three types of active transport are:
In protein-mediated active transport , integral proteins require energy to act as pumps or channels to move specific molecules or ions against a concentration gradient. This energy comes from the common chemical energy molecule, adenosine triphosphate (ATP), which gets broken down by the protein. This breaking down of ATP releases a form of energy that can be used to transport the molecule across the cell membrane. One example of protein-mediated active transport is the sodium–potassium pump. This pump uses energy from ATP to transport sodium ions out of the cell and import potassium ions. This transport of ions is particularly important for nerve cells to respond to stimuli and transmit impulses.
Endocytosis is a type of active transport that allows substances to enter the cell. In endocytosis, the cell membrane engulfs a particle by folding inward and encasing the target particle in its own vesicle. Energy is used to fold the plasma membrane inwards. The vesicle carrying the substance then moves through the cytoplasm and is delivered to the relevant organelle. There are two types of endocytosis:
• phagocytosis (“cell eating”), in which solid particles are engulfed
• pinocytosis (“cell drinking”), in which liquid particles are engulfed.
endocytosis
the movement of materials into the cell
phagocytosis
“cell eating”: engulfing of a solid material by a cell through extension of the cell membrane over the particle, and formation of a food vacuole
pinocytosis
“cell drinking”: formation of channels in the cell membrane that take in fluid at their base
phagosome
a small food vacuole that encapsulates a phagocytosed particle for digestion
pinosome a vesicle filled with extracellular fluid, brought into the cytoplasm through pinocytosis
exocytosis
the movement of materials out of the cell
Phagocytosis involves part of the cell membrane extending out and surrounding a solid particle outside the cell. The cell membrane fuses around the particle and, in doing so, forms a vesicle called a phagosome, which becomes incorporated into the cytoplasm. The term “vacuole” is used when large particles are taken up. Lysosomes fuse with this food vacuole, releasing enzymes. The resulting digested molecules diffuse into the cytoplasm.
Pinocytosis occurs by infolding of the cell membrane to form a channel. The liquid material enclosed in the channel is pinched off in a vesicle, called a pinosome, as the membrane fuses at the surface. The molecules are digested and released by the lysosome in the same manner as in phagocytosis.
Phagocytosis and pinocytosis do not occur in plant cells, because of the relatively inflexible cell wall. In many single-celled animals (Protozoa), phagocytosis is an important feeding mechanism. In multicellular animals, it is one means of destroying invading bacteria and viruses.
The Latin prefix “phago-” means “eating”, and “pino-” means “drinking”. This is why phagocytosis describes a cell engulfing solid particles and pinocytosis describes a cell engulfing liquids.
When explaining the method of transport through a cell membrane, always name the mode of transport, describe whether it is active or passive, and specify the direction of motion (e.g. simple diffusion, passive movement from an area of high solute concentration to an area of low solute concentration).
Exocytosis is a type of active transport that allows substances to exit the cell. In exocytosis, substances held in vacuoles and vesicles inside the cell move towards the plasma membrane. When the vesicle reaches the cell membrane, it fuses with the membrane, which opens the contents of the vesicle and expels it out into the external environment. Energy is used to allow the vesicles to fuse with the cell membrane and release their contents. White blood cells use exocytosis to expel the digested remains of bacterial cells. Nerve cells (neurones) use exocytosis to pass chemical messenger molecules to other cells.
Extracellular fluid
Cell membrane
Cytoplasm
Vesicle containing wastes or secreted particles
Vesicle fuses with cell membrane
Contents of vesicle are released outside the cell
FIGURE 9 The process of exocytosis
TABLE 2 Comparison of passive and active transport
Feature
Movement of substance
Site of transport
Energy requirement
Passive transport Active transport
Down concentration gradient
Phospholipid bilayer or protein channels
No energy required
Characteristics of substance Small, lipid-soluble
Selectivity
Partially selective
Example Water moves through the cell membrane through osmosis.
Against concentration gradient
Carrier proteins or protein pumps
Uses energy, usually provided by ATP
Charged, large or lipid-insoluble
Highly selective
Glucose molecules are actively transported into body cells from the blood.
Check Your Learning 2.6: Complete these questions online or in your workbook.
Retrieval and comprehension
1 Describe what is meant by the terms “passive transport” and “active transport”. (2 marks)
2 Describe the difference between a permeable membrane and a selectively permeable membrane. (2 marks)
3 E xplain what is meant by dynamic equilibrium between two solutions separated by a selectively permeable membrane. (2 marks)
4 Identify how simple diffusion differs from facilitated diffusion. (2 marks)
5 Describe the different methods of active transport used by cells. (3 marks)
Analytical processes
6 C ompare diffusion and osmosis. (3 marks)
7 Animal cells placed in a hypotonic solution swell and burst. Plant cells placed in a hypotonic solution swell only to a certain point and do not rupture.
a Classify the process involved in the swelling. (1 mark)
b Consider why animal cells rupture but plant cells do not. (2 marks)
c Deduce the name given to this action in plant cells. (1 mark)
8 A protozoan is a single-celled eukaryotic organism. Many freshwater protozoans contain contractile vacuoles that can change their
volume. Analysis shows that these vacuoles contain a lower concentration of dissolved substances than the same substances in the rest of the organism. Determine the method of transport used. Provide a justified reason for your answer.
(3 marks)
9 The image below shows a tube containing an aqueous solution of glucose and NaCl in a beaker of water. If the tube is permeable to NaCl and water, but not to glucose, predict the movement of substances and any other changes that would be observed in this experiment. (3 marks)
Selectively permeable tube
NaCl
Water
Glucose
Learning intentions and success criteria
→ Cell size is limited by the ability to diffuse substances.
→ The rate of diffusion is affected by the surface area-to-volume ratio of a cell.
→ Cells have specific shapes and structures to increase their surface area-to-volume ratio.
→ The effect of surface area-to-volume ratio on the rate of diffusion can be observed experimentally.
surface areato-volume ratio (SA:V)
the ratio of a cell’s surface area compared to its volume, a critical factor in the survival of cells; cells with greater surface area in proportion to their volume are able to transport nutrients and wastes of metabolic processes more efficiently
Cells come in many shapes and sizes (Figure 1), which can make them difficult to compare. As a cell grows in size, both the surface area and the volume of the cell increase. However, the cell’s volume increases at a faster rate than its surface area. In fact, as a cell grows (assuming it stays the same shape), the surface area increases exponentially by the power of 2, whereas the volume increases exponentially by the power of 3. For this reason, biologists use the surface area-to-volume ratio (SA:V) of cells to compare cell size. Large cells tend to have a small SA:V, while small cells tend to have a large SA:V. In this lesson you will learn about how SA:V and rate of diffusion limit cell size.
FIGURE 1 Cells come in all shapes and sizes
rate of diffusion the speed at which various substances diffuse into or out of a cell
Chemical reactions necessary for survival occur throughout the cell. Cells need to be small so that the substances that fuel these reactions can move easily into the centre of the cell and wastes from these reactions can move easily out of the cell. The speed at which substances diffuse into or out of a cell is known as the rate of diffusion. Cells with a small SA:V are not as efficient at moving molecules into and out the cell. This is because when surface area is less than volume, the cell is less efficient at collecting the nutrients needed to fuel the cell.
If volume exceeds surface area, the distance that nutrients and wastes need to travel increases along with the time taken to move them. In other words, the smaller the SA:V the slower the rate of diffusion. If nutrients take too long to be imported and/or wastes are not removed quickly enough, the cell will struggle to survive. Therefore, cells are limited by SA:V, because they must have an SA:V that allows materials to diffuse at a rate that can sustain the cell.
The formulae for calculating SA and V in different shapes is summarised in Table 1.
TABLE 1 Formulae for calculating surface area and volume of a range of shapes
When SA and V have been calculated, you can work out SA:V by dividing SA over V to determine the ratio of SA to V. For example, if a cube has a side length of 5 mm, the SA of the cube is 6 × 52 or 150 mm 2 . The volume of the cube is 53 or 125 mm 3 . 150 125 is 1.2, so the SA:V ratio is 1.2:1 (the surface area is 1.2 times the volume).
Cells overcome the constraints of being large by forming into shapes that increase their surface area or by developing projections. A flattened or lengthened shape, or numerous fine projections of the cell membrane (microvilli), can increase a cell’s SA:V.
Cube 10 × 10 × 10 units
Volume = 1000 units3
Surface area = 600 units2
SA:Vol = 6:10
Change shape
8 cubes each 5 × 5 × 5 units
Volume of each = 125 units3
Surface area of each = 150 units2
Total volume = 1000 units3
Total surface area = 1200 units2
Total SA:Vol = 12:10
Rectangular prism 5 × 5 × 40 units
Volume = 1000 units3
Surface area = 850 units2
SA:Vol = 8.5:10
FIGURE 2 SA:V changes with size and shape. If the large cube is cut into eight equal-sized cubes, its SA:V increases from 6:10 to 12:10 – its surface area doubles, even though the volume is the same. If the cube is changed to a rectangular prism, the SA:V increases from 6:10 to 8.5:10 – the flatter the “cell”, the greater the SA:V for the same volume.
microvillus a minute finger-like projection from a cell’s surface; microvilli can form a “brush” border; plural “microvilli”
Root hair protrusion increases SA:V and aids with water uptake.
Highly folded membrane (microvilli) increases SA:V and aids with nutrient uptake
FIGURE 3 Root hair cells in plants and epithelial cells in animals are shaped in a way that maximises their SA:V and ability to acquire nutrients.
One of the largest plant cells known is that of the green alga Valonia , at approximately 1 cm in diameter (the average diameter of plant cells is 30–50 µm). This alga lives in the warm waters of the Great Barrier Reef. Tidal movement ensures the rapid supply of nutrients and removal of wastes. The longest animal cell is the nerve cell of the giant squid (Architeuthis), at 2 m long (and width of less than 1 mm). An increase in the internal membranes of the eukaryotic cell can also improve exchange with its environment. However, cells tend to be small and large organisms tend to be multicellular. The cells of multicellular organisms are also arranged in a way that increases the SA:V of various organs – an example is the the folding of human intestinal tissue. B
Eukaryotic cells contain membrane-bound organelles in which specific metabolic reactions occur. In some of these organelles, the membrane is highly folded – examples are the inner membrane of the mitochondria and the endoplasmic reticulum. This increases the surface area for attachment of enzymes involved in enzyme-controlled reactions. The more enzymes available, the greater the reaction rate for the available substrate.


Caulerpa taxifolia (Figure 5) is the largest unicellular organism in the world. It is a marine alga that can grow up to twelve inches long. It looks similar to a fern you might see on land, but it consists of only one cell. This single cell has multiple nuclei, and when a section of the cell is broken off, it becomes a separate individual cell that will grow independently.
1 Use your understanding of SA:V ratio to explain how Caulerpa taxifolia can grow to such lengths.

Skill drill
Calculating surface area-to-volume ratio
Science inquiry skill: Collecting data
A student wants to determine which of the following cell shapes has the highest SA:V.
1 Calculate the surface area, volume and SA:V of the following cells.
Rectangular prism Cylinder Sphere
2 Determine which cell shape is likely to result in the greatest rate of diffusion. Need help translating information such as ratios? Go to Lesson 1.X in your Biology toolkit.
Check Your Learning 2.8: Complete these questions online or in your workbook.
Retrieval and comprehension
1 Define rate of diffusion. (1 mark)
2 E xplain, in terms of the cell’s nutrients and wastes, why cells generally need to have a large surface area-to-volume ratio. (2 marks)
3 Explain how membrane folds or projections out from the body of a cell help to increase the rate of diffusion. (2 marks)
Analytical processes
4 A large, mature cell reproduces by splitting in half through mitosis. Apply your understanding of surface area-to-volume ratio to deduce what will happen to the cell’s rate of diffusion.
Knowledge utilisation
5 A student used modelling clay to make models of ‘cells’ that were a sphere, a rectangular prism, a cylinder and a flat sheet. All had the same volume. Predict which shape(s) would have: a the largest surface area-to-volume ratio (1 mark) b the smallest surface area-to-volume ratio. (1 mark)
• All living things are composed of cells, the building blocks of life.
• Unicellular organisms consist of one cell, while multicellular organisms consist of many cells.
• Prokaryotes are unicellular organisms that do not have membrane-bound organelles.
• Eukaryotes are organisms whose cells have membrane-bound organelles.
• Organelles have different structures and functions.
• Animal cells and plant cells are organised differently.
• Practical: Preparation and examination of wet mount specimens
• Practical: Identifying organelles from electron micrographs
• The cell membrane is a selectively permeable barrier.
• The fluid mosaic model describes the chemical structure of the cell membrane.
• Protein channels, phospholipids, cholesterol and glycoproteins all have specific roles in the cell membrane.
• Passive transport is a way of moving molecules across the cell membrane that does not require energy.
• Simple diffusion, facilitated diffusion and osmosis are forms of passive transport.
• Active transport is the energy-consuming transport of molecules or ions across a membrane against a concentration gradient or an ionic gradient.
• Protein-mediated active transport, exocytosis and endocytosis are forms of active transport.
• Practical: Modelling the selectively permeable membrane
• Cell size is limited by the ability to diffuse substances.
• The rate of diffusion is affected by the surface area-to-volume ratio of a cell.
• Cells have specific shapes and structures to increase their surface area-to-volume ratio.
• The effect of surface area-to-volume ratio on the rate of diffusion can be observed experimentally.
• Practical: The effect of surface area to volume ratio on the rate of diffusion
1 Plant cells can usually be distinguished from animal cells because only plant cells possess
A cell walls and mitochondria.
B Golgi apparatus and central vacuoles.
C cell walls and central vacuoles.
D chromosomes and mitochondria.
2 In a multicellular organism, the growth rate of a cell decreases as the cell gets larger. Which of the following is the most probable reason for this?
A The materials needed for growth are in short supply in the surroundings.
B As the cell gets larger it approaches maturity and assumes a very specialised role, depending on its position in the organism.
C Most of the energy available for growth of the cell has already been used.
D Small cells can more readily obtain nutrients and release wastes than large cells in the same environment.
3 A plant cell is in a turgid condition when
A it is put in an isotonic solution.
B it is haemolysed.
C water enters it and causes the vacuole to press the cytoplasm against the cell wall.
D it is put in a hypertonic solution.
4 Which of the following do all living cells have?
A mitochondria
B a cell wall
C DNA
D chloroplasts
5 Which of the following diagrams of the movement of water in different solutions is incorrect?
6 Identify the term used for the transport of water across a membrane.
A facilitated diffusion
B osmosis
C active transport
D phagocytosis
7 Which of the following is a form of active transport?
A simple diffusion
B facilitated diffusion
C osmosis
D endocytosis
8 Which of the following is not found in animal cells?
A chloroplasts
B ribosomes
C cell membrane
D vacuole
Selectively permeable membrane
Cell fluid (internal – equal concentration)
Solution (external – equal concentration)
Selectively permeable membrane
Cell fluid (internal – lower concentration)
Solution (external – higher concentration)
Selectively permeable membrane
Cell fluid (internal – higher concentration)
Solution (external – lower concentration)
Selectively permeable membrane
Cell fluid (internal – higher concentration)
Solution (external – lower concentration)
Review questions: Complete these questions online or in your workbook.
9 E xplain the meaning of the terms “diffusion” and “concentration gradient”. (2 marks)
10 Describe a simple experiment to demonstrate diffusion in water. (3 marks)
11 E xplain how diffusion and osmosis are necessary for cells to exist. (2 marks)
12 Identify the function of the Golgi apparatus. (1 mark)
13 Identify the function of lysosomes. (1 mark)
14 The surface area of a cube = 6 x s2 , where s is the length of one side.
The volume of a cube = s3
The surface area of a cylinder (both ends included) = (2πr x h) + 2 r 2 , where r is the radius,
π = 3.14 and h is the height.
The volume of a cylinder = πr 2 x h
Showing your working for all calculations, calculate surface area, volume and SA:V:
a of a cube where s is: i 1 µm (3 marks) ii 3 µm (3 marks)
b of a cylinder where r = 0.5 µm and h = 1 µm. (3 marks)
c Referring to the calculations above, infer the most efficient size and shape for a cell. (1 mark)
15 C ompare prokaryotic and eukaryotic cells. (3 marks)
16 The electron micrograph (photograph produced from an electron microscope) in the image below shows a cell organelle, labelled A.

a Identify this organelle. Give one reason to support your answer. (2 marks)
b Judge whether this organelle is found in plant cells, animal cells or both. (2 marks)
c Identify the function of this organelle. (1 mark)
17 Examine the three electron micrographs of cell organelles shown in i, ii and iii.



a Identify each organelle, giving one reason to support each of your choices. (6 marks)
b Judge whether you would expect to find all three organelles in the same cell type. (2 marks)
18 The green alga Valonia has the largest known plant cells. This alga lives in tropical oceans with high water movement. The cells are spherical and contain a large, highly folded central vacuole. Apply your understanding of surface area-tovolume ratio and transport of nutrients and waste to explain how the Valonia cell can be so large. (3 marks)
19 A group of students on an excursion to a beach collected 50 sandworms of approximately equal size. They organised the worms into five groups of 10. Each group was weighed. Each group of worms was then placed in a separate jar. The students poured into each of the first four jars a different concentration of saline (salt) solution. The fifth jar was filled with normal sea water. The worms were left in the solutions for one hour and then
reweighed. (Sandworms can tolerate extremes of salt concentration for several hours.) The weight change for each group of worms was recorded and is shown in the table below.
Analyse the relationship between the weight of the worms and the solution in which they were placed, suggesting reasons for any variation in weight. (2 marks)
20 A 5% glucose solution is often given intravenously to patients who have undergone surgery. Predict whether the 5% glucose solution will be hypertonic, hypotonic or approximately isotonic. Justify your answer. (2 marks)Data drill
Surface area-to-volume ratio and rate of diffusion
A student is investigating the effect of surface area-to volume ratio on the rate of diffusion for cells with the same volume. The student created three different-shaped model cells using agar gel infused with the base sodium hydroxide (NaOH) and the pH indicator phenolphthalein, which appears pink in the presence of a base, or colourless in a neutral or acidic environment. She placed the three model cells into a solution of hydrochloric acid (HCl) for 5 minutes. The results of the experiment are shown in the diagram below.
Results of rate of diffusion experiment
Apply your understanding
1 Examine the qualitative results in Figure 1 to identify which cell appears to have the highest rate of diffusion. (1 mark)
2 Complete the table by calculating the results for cell C. (6 marks)
Analyse evidence
3 Identify which cell had the greatest rate of diffusion (as measured by percentage diffusion) after 5 minutes. (1 mark)
Interpret evidence
4 Interpret the relationship between surface area-to-volume ratio and percentage diffusion in this experiment. (1 mark)
You can find the following resources for this lesson in your obook pro.

A multicellular organism originates from a single stem cell. Stem cells can replicate as the same type of cell or become a different type of cell. The processes involved in the development of a multicellular organism include cell proliferation (mitosis), cell specialisation (from stem cells), and cellular interactions and movements, leading to the formation of tissues, organs and systems. These systems improve the efficiency of obtaining nutrients, gas exchange and waste removal in multicellular organisms.
Check your understanding of concepts related to multicellular organisms before you start.
→ Describe how stem cells originate through the process of mitosis and differentiate into specialised cells to form tissues.
→ Distinguish between unipotent, multipotent, pluripotent and totipotent stem cells.
→ Describe how the hierarchical organisation of cells, tissues, organs and systems allow multicellular organisms to – obtain nutrients, e.g. digestive and circulatory systems – exchange gases, e.g. respiratory and circulatory systems – remove wastes, e.g. respiratory, circulatory and excretory systems.
Science as a human endeavour
→ Appreciate that – pluripotent stem cells have the potential to be grown into specialised cells that can be used to repair or replace ailing organs and tissues. Advances in technology have allowed scientists to reprogram cells to become pluripotent
→ Use a light microscope or photographs to
– view tissues from the respiratory, circulatory, excretory, digestive and/or plant systems
– compare epithelial, connective, muscle and nervous tissues – calculate total magnification and field of view.
→ Explore the safety, ethics and efficacy of stem cell technologies. Biology 2025 v1.0 General Senior Syllabus © State of Queensland (QCAA) 2025

These lessons are available exclusively on Oxford Digital.
3.3 Organisation of cells into tissues, organs and systems
Learning intentions and success criteria
→ The size of a cell is limited by its ability to exchange materials with its environment.
→ Large organisms are composed of many cells organised into tissues, organs and systems, each of which has its own function. These cells communicate with each other for the overall functioning of the organism.
All organisms have the same life functions.
daughter cell
a cell produced by the division of a parent (mother) cell
cell proliferation the formation of new cells via cell division
cell specialisation the process in which a generic cell develops the structures needed to function as a specific type of cell
cell interaction any form of communication or exchange between cells
• They require nutrients and gases from their environment to carry out metabolic reactions.
• They remove the waste products of metabolic reactions.
• They reproduce.
For a unicellular organism to carry out these functions, there must be chemical communication between the different parts of the cell that allow it to coordinate its activities. Because the exchange of nutrients and waste across the cell membrane needs materials to be in solution, unicellular eukaryotic organisms are often restricted to environments that are rich in moisture or fully aquatic.
As you learnt in Module 2, to operate efficiently, cells cannot grow too large. As a cell grows, its surface area-to-volume ratio (SA:V) decreases, limiting the rate of diffusion of nutrients into a cell and the removal of wastes out of the cell. It is very difficult for a unicellular organism to grow into a large organism. The way in which a eukaryotic organism can grow larger and overcome this limitation is to divide into many small cells. This ensures that each cell has an appropriate SA:V to maximise its functionality. These cells need to be able to hold together, communicate with each other and allow materials to be exchanged and transported to other cells.
All multicellular organisms start life as a single cell. In sexually reproducing organisms this cell has a combination of the genetic material of both parents, with each parent contributing half its genetic material to the offspring. In asexually reproducing organisms, the cell is a daughter cell , a genetically identical copy of the parent’s cells. In both cases, the first cell that makes up a multicellular organism contains all the genetic instructions needed to produce every type of cell in the multicellular organism. This first cell must undergo a series of stages to produce the final organism.
1 Cell proliferation – the cell produces many more daughter cells with the same genetic code. Every cell in an individual organism will contain the same genetic code as this first cell.
2 Cell specialisation – daughter cells have a specialised structure and function. For example, in humans, red blood cells are specialised to carry oxygen around the body, while immune cells attack pathogens.
3 Cell interaction – cells communicate with each other in a coordinated manner. For example, a muscle cell that needs extra nutrients such as glucose or oxygen must be able to communicate to the rest of the multicellular organism that more glucose or oxygen should be supplied.
4 Cell movement – cells start forming the multicellular organism by moving to their correct positions. This ensures that each cell is surrounded by other cells that provide essential requirements. In this way, specialised tissues form.
cell movement the migration of cells from one location to another tissue a group of cells of the same cell type, performing a function
FIGURE 1 Stages in the development of the multicellular organism
FIGURE 2 Multicellular organisms all share the same basic structural hierarchy.
Check your learning 3.1
Check Your Learning 3.1: Complete these questions online or in your workbook.
Retrieval and comprehension
1 Identify the factor that limits the size of unicellular organisms. (1 mark)
2 Summarise the division of cell function in unicellular and multicellular organisms. (2 marks)
3 Describe the four processes involved in the formation of a multicellular organism from a single cell. (4 marks)
Analytical processes
4 Deduce why unicellular organisms are found only in moist environments. (1 mark)
Learning intentions and success criteria
→ Tissues are composed of cells of one type that are differentiated for a particular function (e.g. cardiac muscle).
→ Organs are functional and structural units made up of more than one type of tissue (e.g. the heart).
→ A system comprises different organs working together for one main function (e.g. the respiratory system).
→ Plants have tissues arranged into organs (e.g. the leaf) and two systems (root and shoot).
As multicellular organisms become more complex, the number of specialised cell types they have increases. To ensure that specific cells can function to support the survival of an organism, complex multicellular organisms are organised in a hierarchy: cells → tissues → organs → systems




In Lesson 3.1 you learnt that cells specialise into different cell types, each type developing specific structures that suit their function(s). Because different genes are activated during cell specialisation, each cell type produces different proteins. This difference in protein production dictates the cell’s structure and function. Cell types commonly found in mammals include red blood cells, nerve cells, muscle cells, epithelial cells, immune cells, sex cells, bone cells and fat cells. Each of these cell types has a different function and is made up of a selection of organelles that allows it to perform its role. For example, mature red blood cells, which carry oxygen around the body, lack a nucleus to increase their carrying capacity. Muscle cells, which contract to facilitate movement, contain higher concentrations
of mitochondria because they use up more energy to contract. Other complex organisms like plants also have specialised cell types. For example, the function of root hair cells is to absorb water, while guard cells control gas exchange.
2 Specialised cells perform different functions.
In most multicellular organisms, the cells are arranged into tissues. A tissue is a group of the same type of cells specialised to perform a specific function. The cells in a tissue are bathed in extracellular fluid . Exchanges of chemicals occur between the cell and its surrounding fluid in a similar way to those between unicellular organisms and their aquatic environment. The cells within a tissue are held together by integral proteins along the cell membrane that attach to cells of the same type. Common tissue types in mammals are:
• epithelial tissue – made up of epithelial cells that coat or line the surface of organs. Provides protection and support and secretes and absorbing nutrients
• connective tissue – connects, supports and separates other tissue types (e.g. blood, bone, cartilage, lymph)
• muscle tissue – made up of muscle cells that can contract and allow the body to move
• nervous tissue – made up of nerve cells that allow the body to send and receive neural messages.
Connective tissue Nervous tissue Epithelial tissue Muscle tissue

3 Tissue types in mammals


Sometimes specialisation for a function results in a change to the shape of cells. For example, epithelial tissue that lines parts of an animal is called epithelium Cells on the outside of the organism tend to be flat; this type of tissue is called squamous epithelium. This shape provides stability and binding, so the underlying tissues are protected. The cells of other epithelial tissues may be column or cube shaped. Tissue formation also involves structural changes to the individual cells of each tissue type. Some cells that make up epithelial tissue have cilia or microvilli on their surface, to increase their surface area for absorption of nutrients.
Like mammals, plants also consist of more than one type of plant tissue. These tissues include vascular tissue, which controls the flow of water and nutrients around the plant, epidermal tissue, which covers the external parts of the plant, and parenchyma tissue (the location of photosynthesis).
extracellular fluid
body fluid outside the cells of any multicellular organism; enables the transport of materials between cells and maintains a constant environment for cellular processes
epithelium
body tissue that forms the lining of all internal and external surfaces in the body
cilia
microscopic hairlike projections from the cell membrane that pulse, causing currents in the surrounding fluid
organ a group of different tissues bound together to perform a particular function system different organs working together to perform a specific function
An organ is a structural and functional unit composed of more than one type of tissue and multiple cell types. For example, the human heart is made up of muscular, epithelial, connective and nervous tissue. Other examples of organs in mammals are the brain, lungs, liver, kidneys and stomach. Plants also have organs, such as roots, stems and leaves.
A system is composed of different organs working together to perform one main function. For example, the excretory system includes the kidneys, ureter, bladder and urethra working together to remove wastes and excess fluid from the body. Systems are coordinated to facilitate the supply of nutrients to, and production/removal of materials from, all cells of the organism.
System
Nervous
Circulatory
Respiratory
Digestive
Excretory
Endocrine
Most vertebrates have similar body systems. However, each system’s precise structure and function vary according to the environment in which the organism lives. While some systems are regarded as more important than others, almost every body system is needed for survival. If one organ within a system is damaged or malfunctions, this can have major consequences for other systems, which could result in the death of the organism. A summary of the major mammalian body systems is given in Table 1. You will learn more about each of these systems throughout Units 1&2 Biology.
Function(s)
• Sends and receives messages around the body
• Circulation of blood, loaded with nutrients and oxygen, throughout the body
• Removal of waste products of metabolism to excretory systems
• Exchange of gases
• Body temperature control
• Transport of hormones
• Absorbs oxygen through breathing actions
• Releases carbon dioxide from the body
• Removal of wastes
• Breaks down food (complex molecules to monomers) into nutrients to be absorbed by the blood and taken to different parts of the body
• Elimination of undigested food
• Extracts nitrogenous and other wastes from the blood and removes them from the body
• Releases hormones into the body
• Helps the body maintain homeostasis (internal balance)
Components
Brain, spinal cord and nerves
Heart, blood vessels (arteries, veins and capillaries) and blood
Lungs, bronchi, diaphragm, pharynx and larynx
Mouth, salivary glands, oesophagus, stomach, intestines (and associated organs
– liver, pancreas, gall bladder)
Kidneys, ureters, urinary bladder, urethra
Pancreas, glands (e.g. pituitary, thyroid, parathyroid, thymus, adrenal)


Ovaries (Women) Testes (Men)
FIGURE 4 Major mammalian systems
There are two plant systems. The shoot system is composed of all the tissues above the ground, and the root system controls the function of tissues below the ground. The shoot system consists of organs, including the leaf, shoots and reproductive organs (e.g. flowers). The root system consists of the roots, tubers (storage organs) and rhizomes (underground stems).
For an organism to survive, its cells, tissues, organs and systems must coordinate with each other. Communication among the cells of tissues, between organs and therefore between systems, is achieved by chemical signals, in a similar way to how messages are sent within a cell. Substances transported out of a cell travel to another cell, causing a change in the recipient (target) cell. In animals, cells coordinate in two ways: slowly, through the transmission of chemical hormones; or quickly, via electrical impulses in the nervous system.
Check your learning 3.2
Check Your Learning 3.2: Complete these questions online or in your workbook.
Retrieval and comprehension
1 Describe the following:
a a cell (1 mark)
b a tissue (1 mark)
c an organ (1 mark)
d a system. (1 mark)
2 Explain why a particular type of cell might have a higher energy requirement than another type of cell. (1 mark)
3 Identify the role of extracellular fluid in multicellular organisms. (1 mark)
4 E xplain how coordination between tissues, organs and systems occurs in animals. (2 marks)
5 For each of the scenarios below, determine the system that is most likely to be affected and propose one negative side effect that may result based on that system’s function.
a Ayesha is in a car accident, in which her kidney is punctured. (2 marks)
b After years of smoking, Reuben develops chronic bronchitis (long-term inflammation of the bronchi). (2 marks)
Learning intentions and success criteria
This lesson is available exclusively on Oxford Digital.
Learning intentions and success criteria
cell cycle
the continuous cycle of growth and division in cells interphase stage in the cell cycle in which the cell grows, stores energy and replicates chromosomes mitosis nuclear division resulting in daughter cells with the same number and types of chromosomes as in the parent cell cytokinesis division of cells after mitosis
→ There are three stages of the cell cycle: interphase, mitosis and cytokinesis.
→ During interphase, the cell grows and prepares for cell division.
→ During mitosis, the nucleus of the cell is replicated.
→ During cytokinesis, the cytoplasm of the cell divides, forming two identical daughter cells.
The cell cycle is an organised series of events that involves the growth of a cell and its division into two genetically identical daughter cells. There are three stages of the cell cycle:
• interphase – the longest stage, when the cell undergoes normal growth and prepares for cell division
• mitosis – the nucleus of the cell divides
• cytokinesis – after mitosis, the cytoplasm of the cell divides, forming two identical daughter cells.
In this lesson you will learn about each of these stages and the processes involved when a cell replicates.
Checkpoint
FIGURE 1 The cell cycle
During interphase, a cell actively undergoes the many chemical reactions needed for it to stay alive. This includes reactions necessary to prepare the cell for division. There are three phases of interphase:
• gap 1 (G1)
• synthesis (S)
• gap 2 (G2).
In multicellular organisms, the cells spend most of their time undergoing the everyday metabolic activities of the first stage of interphase, the G1 phase. During this phase, a cell grows to its maximum size for efficient nutrient and waste exchange across the membrane. When the cell has reached this point it will either maintain its function level (e.g. adult brain cells) or prepare to undergo cellular division.
Before a cell can undergo mitosis, it must first check that all the genetic material (DNA) is intact and that all its organelles and enzymes are functioning correctly. Chemical messengers inside the cell check the health of the cell at the G1 checkpoint. If this check suggests that something is wrong, the cell will undergo a process of organised cell death, called apoptosis
If the chemical messengers inside the cell indicate that cellular functioning is occurring correctly, the cell will pass into the second part of interphase, the S phase.
chromatin a complex structure made up of DNA wrapped around proteins called histones; condenses to form a chromosome
Deoxyribonucleic acid (DNA) is strung out in long threads, called chromatin. Before a cell can replicate, it must make a copy of each DNA molecule in the cell. The second stage of interphase, S phase, is when DNA is replicated. During S phase, the cell’s DNA unwinds and separates into two single strands (Figure 2).
chromatid a replicated chromosome, still attached to the original at the centromere
centromere the point of attachment of two chromatids
FIGURE 2 DNA unwinding into two single strands
centriole an organelle that produces spindle fibres, which separate the chromosomes during mitosis
Each strand then synthesises a new complementary strand of DNA, which results in two molecules of identical DNA, called chromatids (Figure 3). Chromatids remain attached at a central point called the centromere. After the DNA has been replicated and the chromatids are attached to the centromere, the cell can enter the G2 phase.
FIGURE 3 DNA replication results in two identical molecules of DNA, called chromatids. Each chromatid is made up of one original strand of DNA and one newly synthesised strand of DNA.
The third and final stage of interphase is G2, a stage that requires energy and nutrients. During G2, the cell synthesises an extra copy of each organelle and protein to prepare the cell for division. In animal cells, the centrioles replicate. Strands of protein that will form the spindle fibres start to develop. By the end of the G2 phase, the cell will have accumulated the chemical resources and energy necessary to make a whole new copy of the nucleus (mitosis).
Mitosis or “nuclear division” is the second stage of the cell cycle, when the cell’s nucleus replicates. It has four stages: prophase, metaphase, anaphase and telophase.
During prophase, the cell’s chromatin condenses into a form of DNA called a chromosome. Each chromosome consists of two “sister” chromatids, which lie parallel to each other and are joined at the centromere (Figure 4). Each chromatid contains one side of the original DNA and a new complementary, replicated side. While the chromosomes are condensing, a series of protein threads form a structure, called a spindle, that extends the full length of the cell. The two ends of the spindle are called the poles and the middle region is the equator. In animal cells, the spindle-producing centrioles separate and migrate to opposite poles of the spindle. The nucleolus of the nucleus breaks down, as does the nuclear membrane.
Centromere
Sister chromatids Sister chromatids
FIGURE 4 A chromosome consists of two sister chromatids attached at the centromere.
Metaphase follows the breaking down of the nuclear membrane. The chromosomes migrate to the centre (equator) of the cell and each attaches its centromere to an individual spindle fibre. The arrangement of the chromosomes on the spindle fibres is apparently random and may change from division to division.
During anaphase, the sister chromatids of each chromosome separate, and are no longer attached by their centromeres. The identical sister chromatids are each pulled by the spindle to opposite poles of the cell. The exact mechanism is not known, but congregation of mitochondria around the spindle suggests that large amounts of energy are required. It is thought that the spindle fibres, with the input of energy, contract and separate at the equator and, as they pull towards opposite poles, the centromeres separate to release the sister chromatids.
During telophase, chromosomes congregate tightly together when they reach the polar ends of the spindle. The spindle then breaks down and a nuclear membrane forms around each bundle of chromosomes. The nucleolus starts producing nucleotides and the chromosomes uncoil and revert to chromatin threads.
Cytokinesis is when the entire cell divides, so each new daughter cell has a complete set of chromosomes as well as cytoplasm and organelles. While telophase is occurring, division of the cytoplasm between the new groups of chromosomes commences. In animal cells, the cell membrane constricts across the centre (equator) of the cell, forming two new cells. In plants, a cell plate formed from vesicles of the Golgi apparatus grows across the middle of the cell. The new membrane joins with the existing cell membrane to form two cells. New cell walls are produced between the membranes of the plate prior to separation. Each new cell formed from cytokinesis then enters interphase and the cycle repeats. Although cytokinesis normally follows the formation of the new nuclei (mitosis), there are exceptions. The formation of skeletal muscle fibres in vertebrate animals, for example, results from mitosis without cytokinesis. These cells often have multiple nuclei in a single cell.
prophase the first stage of cell division, in which the chromosomes condense, sister chromatids join together and the nucleolus and nuclear membrane dissolve
chromosome highly condensed chromatin fibres that form for the process of cell division
metaphase the second stage of cell division, in which the chromosomes align in the middle of the cell and spindle fibres attach to the centromeres
anaphase the third stage of cell division, in which sister chromatids separate and are pulled to opposite poles of the cell
telophase the fourth stage of cell division, in which sister chromatids reach the ends of the cell and unravel back to chromatin, and the nuclear membrane and nucleolus re-form
cytokinesis the division of a cell after mitosis
In Metaphase, the chromosomes line up along the Middle of the cell.
In Anaphase, the chromosomes move Away from each other.
Some cell types go through the cell cycle – growth, mitosis and cytokinesis – continuously throughout the life of the organism. Because the red blood cells of vertebrates do not have a nucleus and live only for about 120 days, special stem cells in the bone marrow constantly divide to maintain enough red blood cells in the body. Other cell types (e.g. some brain cells) do not undergo further division once the organism is mature. A third category of cells divide only at a sufficient rate to produce the number of cells that are required for growth and replacement. Human liver cells, for example, do not normally divide after the liver has reached a certain size. If some of the liver is surgically removed, the existing cells are triggered into division mode until the liver has regained its original size. Cell division then stops.




Plant cells divide in a similar way to animal cells, but higher plant cells do not contain centrioles and a cell plate needs to be laid down before cytokinesis can occur. The two new cell walls are formed to complete the division.





The cell cycle is a complex process with many events. The key events of the cell cycle can be summarised as follows:
• Just prior to division, the DNA replicates. Each chromosome now consists of two identical chromatids.
• Each chromosome attaches to a separate spindle fibre.
• The chromatids of each chromosome separate and move to opposite poles of the spindle. This ensures that each pole contains the same number and types of new chromosomes.
• The daughter cells will therefore have an identical set of chromosomes to the original cell.
• At each division, two daughter cells are produced.
• The time between divisions (interphase) is needed for the cell to grow, store energy, and replicate its DNA and organelles.
The nature of the control system or systems that regulate the cell cycle is still not fully understood. Certain hormones (e.g. growth hormones) and other chemicals have been shown to stimulate cell division. Other chemicals, or cell overcrowding, can inhibit division. The control of cell division is of particular interest to researchers, because cancers result from uncontrolled cell division in multicellular organisms.
Within each cell of multicellular organisms is a series of genes that program for cell death, or apoptosis. Other genes suppress these death genes. It appears that the balance of activity between the two sets of genes determines whether a cell lives or dies. In many cases studied, damage to the cell’s DNA triggers the activity of the death genes and suppresses that of the survival genes. These sets of genes help prevent a cell from growing uncontrollably. For a cell to mutate and become a cancer-causing cell, up to six changes to the operation of its DNA have to occur.
1 The cell becomes self-sufficient. Most cells need signals from other cells before they can undergo mitosis. Cancerous cells can signal themselves to divide.
2 The cell blocks the signal that stops mitosis. All cells have genes that supress mitosis and prevent the cell from growing uncontrollably. A mutation in these genes allows a cell to divide at any time.
3 The cell avoids apoptosis. This is caused by a mutation in the genes that would normally make the cell apoptose.
4 The cell is able to undergo limitless cell cycles. Cancerous cells can divide an unlimited number of times.
5 The cell has access to nutrients through a good blood supply. Most cancerous cells can encourage blood vessels to grow around them.
6 The cell is able to migrate (metastasise) around the body. This enables it to spread to new sources of nutrition. Cancer cells kill the surrounding cells, either by strangling them or by being more competitive in using the

limited resources available. Vital functions of the body are therefore disrupted and this can affect the survival of the multicellular organism. The causes of cancer are numerous. All cancer cells result from changes in the DNA of body cells. Some cancers result from constant injury or aggravation of tissue (e.g. when a benign mole becomes cancerous), mutagens (radiation and chemicals that cause DNA changes or mutations) or viruses.
Apply your understanding
1 Explain the importance of ‘death genes’ and ‘survival genes’ in a normal cell. (2 marks)
2 Identify why it is important for scientists to learn about the control process of cell division. (1 mark)
3 According to the Skin Cancer Foundation, a person's risk for melanoma doubles if they have had more than five sunburns.
a Hypothesise why multiple burns are stated. (1 mark)
b Pose a research question to address an aspect of this claim. (1 mark)
Check Your Learning 3.4: Complete these questions online or in your workbook.
Retrieval and comprehension
1 S elect the correct order for the following events of the cell cycle. (7 marks)
• DNA replicates.
• Chromosomes line up at the equator of the spindle.
• Spindle forms.
• Nuclear membranes form.
• Chromatids separate.
• Nuclear membrane disintegrates.
• Chromosomes move to opposite ends of the spindle.
2 Identify the longest stage in the cell cycle for most cells. (1 mark)
3 Describe the structure that is unique to plant cell division. (1 mark)
4 Describe the importance of DNA replicating before mitosis takes place. (1 mark)
Analytical processes
5 Identify the stages of mitosis shown in the following images. Justify your decision. (4 marks)


Knowledge utilisation
6 A student is reading an old biology textbook and comes across a description of interphase as a ‘resting phase’. Apply your knowledge to argue why this term is inappropriate. (3 marks)
→ A stem cell is a cell that can replicate or differentiate into one or more cell types.
→ There are two types of stem cells: embryonic stem cells and adult stem cells.
→ Stem stells can be classified as totipotent, pluripotent, multipotent or unipotent.
Multicellular organisms begin life as a fertilised egg cell (zygote), which has the potential to form an entire organism. The first few cycles of cell division via mitosis produce identical, unspecialised cells, called stem cells. After several cycles, these cells begin to specialise, preparing to form the different organs and tissues of the body. Even when the organism is fully formed, the cells need remnant sets of unspecialised cells.
When an organism is damaged or a cell “wears out”, the cell may need to be replaced. If the cell is specialised, it must be replaced by another cell with the same specialisation. Because the body cannot afford to store extra specialised cell types to replace damaged cells, stem cells are maintained throughout the body. When required, these stem cells will undergo mitosis to produce specialised replacement cells.
Learning intentions and success criteria
zygote a fertilised egg cell that has the potential to form all the cells of an organism stem cell a cell that is capable of forming different cell types
replicate














di erentiate into many cell types.








self-renewal the ability to divide to produce more stem cells potency the ability to differentiate into other cell types
blastula a hollow ball of cells resulting from division in an animal zygote
gastrula the early embryonic stage in animals, formed from the ingrowth of cells at one end of the blastula to produce a double layer of cells from which future tissues and organs develop
embryonic stem cell an undifferentiated, totipotent or pluripotent cell in the early embryo
adult stem cell a partially differentiated animal cell, responsible for repair and maintenance of the adult body
totipotent stem cell an undifferentiated cell that can later differentiate into any type of cell
pluripotent stem cell a stem cell that can differentiate into any cell type within a broad group
multipotent stem cell a stem cell that can only differentiate into a limited number of closely related cell types
Stem cells are unspecialised cells that have the capacity to develop into different cell types under special conditions. Some of these cells can activate any part of their genetic material if it is needed.
All stem cells have two main properties:
• self-renewal – the ability to go through several cell cycles without further differentiation. Stem cells are unique in this as they can continually self-renew throughout the life of the organism.
• potency – the ability to differentiate (change) into specialised cell types. Different types of stem cells have varying degrees of potency.
Cell potency is the capacity of a cell to differentiate into different cell types. Cells with high potency can differentiate into many different types of cells, while cells with low potency are limited in the number of cells they can differentiate into. A stem cell’s potency is determined by the stage in which the stem cell developed.
In animals, the first mass of cells formed in the embryo develop as a hollow ball with a single layer of outer cells, called the blastula . As further division occurs, in all animals except sponges, one end of the mass begins to push into the cavity of the embryo to form a double layer, called the gastrula . This triggers the first stage of cell differentiation. Depending on where the cell is in the gastrula, it will receive a chemical message to switch the DNA of specific genes on or off.
Embryonic stem cells, which are those that formed in the embryo during the early stages of an organism’s life, can differentiate into many cell types – they have high cell potency. Adult stem cells, which are those that formed outside of the embryo, are more restricted in their ability to differentiate into different cell types. Different levels of potency include totipotent, pluripotent, multipotent and unipotent.
Totipotent stem cells are the first cells that form during cell proliferation in a multicellular organism – all their genetic material is expressed in the daughter cells formed. Totipotent stem cells are embryonic stem cells and can differentiate into any cell type in an organism. They are only produced in the early stages of embryo development.
Pluripotent stem cells are also embryonic stem cells and can differentiate into almost any cell type in an organism. Unlike totipotent cells, pluripotent cells are unable to differentiate into placental cells. This is because they are formed inside the blastocyst at a later stage of embryo development than totipotent cells, after the first stage of cell differentiation. With further development, pluripotent cells become more and more specialised. Once an infant is born, cells become so specialised that they can only differentiate into a limited number of cell types.
Multipotent stem cells are adult stem cells and can only specialise into a single, closely related “family” of cells. For example, cells in the bone marrow are multipotent as they can become any of the cells found in the blood (red blood cells, white blood cells or platelets) but cannot produce any other cell types.
Unipotent stem cells are adult stem cells that can produce only their own cell type. For example, stem cells within the ovaries are only able to differentiate into oocytes (egg cells) and no other types. Unipotent and multipotent stem cells are often responsible for repair and maintenance of the adult body.

unipotent stem cell a stem cell that can only form one cell type on division
Axolotls are a type of salamander that may hold the key to regrowing human limbs. There are more than 1 mi llion limb amputations every year, as a result of accidents and medical conditions such as diabetes. Until now, the only answer for amputees has been prosthetic limbs, but the axolotl’s ability to regrow amputated limbs is being studied in the hope of one day enabling regeneration of limbs in humans.
In axolotls, regeneration of a lost limb begins with the formation of a wound epidermis, as a layer of cells quickly cover the amputation. These cells and the cells below the epidermis rapidly divide, forming a cone-shaped structure called a blastema. The blastema is a mass of stem cells, as well as other cells that de-differentiate to return to a multipotent state. These cells within the blastema then differentiate again to form a structure that resembles the lost limb, including nerves, blood vessels and connective tissues.
Scientists have found that various tissues work together to detect the loss of a limb and coordinate the regrowth, including the cells of the immune system and the nerve cells. Their removal interferes with the regeneration and creates scar tissue, although their roles are still undetermined. Scientists have also found that genes used in the formation of the structure during embryonic development are reactivated to regenerate the limb. Researchers are now comparing the mechanisms governing regeneration in axolotls and mice. Perhaps one day, with further research into the process, drugs can be manufactured to modulate these genes in order to help regenerate a human limb.

1 Identify the three factors that have been recognised as playing a role in axolotl limb regeneration. (3 marks)
2 Explain why it is important for research to compare axolotl and mice regeneration. (2 marks)
3 “Perhaps one day, with further research into the process, drugs can be manufactured to modulate these genes in order to help regenerate a human limb.” Pose a research question that addresses an aspect of this claim. (1 mark)
In plants, the embryo, and later the adult plant, grows outwards by forming an extra layer at its outer edges. These groups of cells are called apical meristems, and they contain pluripotent stem cells. When each pluripotent cell divides, it creates a daughter cell that enlarges and differentiates to build roots, shoots and leaves. The other cell from this division becomes the new mother stem cell.
Some cells outside the apical meristems are multipotent stem cells. In this way the trunk and roots of trees and other perennial plants can increase in girth over time or sprout new shoots from dormant cells if the plant is damaged. The cells responsible for this are in the cambium , a zone of tissues between the water-conducting (xylem) and food-conducting (phloem) vessels.
Apical meristem

apical meristem the growing point of the tip of the root and stem in vascular plants cambium a layer of actively dividing plant cells
FIGURE 4 Magnified section of a huckleberry shoot. The pale pink cells are stem cells that are undergoing elongation and vacuolisation. The smaller and darker pink cells towards the top are undergoing mitosis. Surrounding the apical meristem and stem cells are young leaves.
Check your learning 3.5
Check Your Learning 3.5: Complete these questions online or in your workbook.
Retrieval and comprehension
1 Define stem cell. (1 mark)
2 E xplain the meanings of ‘self-renewal’ and ‘potency’ with respect to stem cells. (2 marks)
3 Identify the potential products of mitosis of human stem cells. (2 marks)
4 Explain the importance of self-renewal of stem cells. (1 mark)
Analytical processes
5 D istinguish between totipotent, pluripotent, multipotent and unipotent stem cells. (4 marks)
Knowledge utilisation
6 Stem cells provide opportunities to generate healthy cells to replace cells affected by disease. Apply your knowledge to determine why embryonic stem cells provide more opportunities for research in this field than do adult stem cells. (2 marks)
7 P ropose why it is beneficial that adult stem cells are multipotent or unipotent, rather than pluripotent. (2 marks)
Learning intentions and success criteria
→ Specialisation of cells into different cell types leads to groups of cells that have different structures and functions.
→ Cell specialisation is controlled by internal factors. Chemical cell-to-cell contact and mechanical forces play a role in determining cell specialisation.
→ Transcription factors turn specific genes on or off, determining cell specialisation and function.
→ There are both advantages and concerns associated with embryonic stem cell research.
Multicellular organisms are too large for all cells in the body to be able to exchange materials directly with the external environment. Cells must therefore undergo specialisation to perform particular functions within the organism. Cell specialisation involves a succession of changes in a cell line, in cell morphology and metabolic activity, which leads to the development of cells with a specific role within the organism. This specialisation can lead to the new cells increasing the presence of some structures needed for their function, while decreasing or losing other structures that are not required.

During mitosis of a stem cell, the parent cell produces two daughter cells. Scientists have found that, in humans, the two daughter cells produced may be either two stem cells, to maintain the pool of stem cells, or two specialised cells, to replace dead or damaged cells. The processes involved in cell specialisation are not fully understood, but scientists have identified several factors. The signals that influence stem cell specialisation can be
categorised as either internal or external. External signals include the presence of certain chemicals secreted by the surrounding tissue, physical contact between cells, transmembrane molecules used for signalling, and mechanical forces causing changes in cell shape. Internal signals include the use of specific molecules called transcription factors, which are a group of proteins that regulate the expression of certain genes, switching them on or off. These transcription factors can also be influenced by external signals, such as the presence of vitamin A, which has been found to play a role in the differentiation of neurons. Specialised cells may have some parts of their DNA switched off permanently. For example, a skin cell does not need many of the molecules that are used by kidney cells. Therefore, in the skin cell, the parts of DNA (genes) that contain instructions to produce kidney cell molecules are switched off. The skin cell is now described as specialised or differentiated.
Expression of muscle-specific gene
Identical daughter cells
Single cell
transcription factors proteins that switch particular genes on or off gene a segment of DNA that codes for a specific protein and provides the instructions for the formation of a cell
Expression of epithelial-specific gene
2 For a cell to specialise, certain genes are expressed and others are switched off.
Scientists study the process of specialisation in different cell types, in order to study the effect of diseases or reactions to various drugs or environmental factors. Although human trials using embryonic stem cells for research in spinal cord injuries were conducted in 2010, the research was stopped because of two major concerns about the use of embryonic stem cells.
• Because cell specialisation is controlled by several factors, including chemical signalling, embryonic stem cells injected into the body may form many different cell types, leading to the formation of cysts.

• Because the embryonic stem cells are not from the patient’s body, their immune system will recognise the cells as ‘foreign’ (in the same way that it would for an infection) and so the implanted cells may be rejected.
Further research in many countries has not been permitted for ethical reasons, as the harvesting of embryonic stem cells requires the destruction of an embryo. For this reason, recent research has focused on techniques aiming to revert adult stem cells to a pluripotent state.
Stem cells have the potential to be one of the most important breakthroughs in modern medicine. In 1962, John Gurdon cloned frogs by inserting adult somatic cells into an egg cell, showing that specialised cells could revert to pluripotency. In 1987, another study found that it was possible to reprogram specialised cells to become completely different cell types. In 2006, Shinya Yamanaka and Kazutoshi Takahashi reprogrammed an adult stem cell to revert back to a pluripotent cell. These cells were called induced pluripotent stem cells (iPSCs). This breakthrough has led to research into the possibility of

using iPSCs to repair or replace ailing organs and tissues, and even the potential to reverse ageing.
Induced pluripotent stem cells are more effective than adult stem cells, because they are able to differentiate into any type of cell in the body and avoid the use of embryos in stem cell therapy. Because they can be made by reprogramming the patient’s own cells, iPSCs also pose no risk of immune rejection, which is a concern for other stem cell therapies and organ transplants.






Many serious medical conditions could potentially be treated using stem cells. Clinical trials are currently underway for patients with type 1 diabetes, where stem cells have been induced to form insulin-producing cells. Neural stem cell therapy has the potential to treat spinal cord injuries and
Apply your understanding
1 Explain why the discoveries made in 1962 and 1987 were critical to the development of iPSCs. (2 marks)



stop neurodegenerative diseases such as Parkinson’s disease and Alzheimer’s disease. Because iPSCs are pluripotent, in time, any ailing organs may be able to be replaced. Stem cells may even be used to reverse the effects of ageing.
2 State the importance of the development of iPSCs for medical research, with consideration of embryonic stem cells. (1 mark)
3 “Stem cells may even be used to reverse the effects of ageing.” Pose a research question that addresses an aspect of this claim. (1 mark) induced pluripotent stem cell (iSPC) a differentiated cell that has been genetically reprogrammed back to a pluripotent state
Science inquiry skill: Processing and analysing data
A group of researchers monitored 30 patients who had received stem cell therapy to treat hip injuries, for four years. They wanted to determine whether the average functionality of the hip had improved four years after receiving stem cell therapy. Their results are provided in the table.
6
*100% = fully functioning hip
Practise your skills
1 P resent the results from the table as a graph. (3 marks)
2 Determine the average percentage of improved hip function after four years following stem cell therapy. (1 mark)
Need help graphing data? Go to Lesson 1.6 in your biology toolkit.
Embryonic stem cell research
Some areas of research, such as embryonic stem cell research, are strictly regulated and must adhere to certain guidelines. The aim of these regulations and guidelines is to provide the opportunity for scientific advancement in the field of stem cell research while also considering the ethical issues involved.
1 Research the policies that regulate embryonic stem cell research in Australia, and evaluate whether you believe it meets ethical standards. (4 marks)
Check Your Learning 3.6: Complete these questions online or in your workbook.
Retrieval and comprehension
1 Identify the four factors involved in cell specialisation. (4 marks)
2 Describe the role of transcription factors in cell specialisation. (1 mark)
3 State the importance of specialised cells in multicellular organisms. (2 marks)
5 D iscuss why the concerns that arose with the use of embryonic stem cells would not apply to the use of the induced pluripotent stem cells described in Real-world Biology. (3 marks) Check your learning 3.6
Analytical processes
4 Identify two advantages and two disadvantages of using embryonic stem cells. (4 marks)
Knowledge utilisation
• The size of a cell is limited by its ability to exchange materials with its environment.
• Large organisms are composed of many cells organised into tissues, organs and systems, each of which has its own function. These cells communicate with each other for the overall functioning of the organism.
• Tissues are composed of cells of one type that are differentiated for a particular function (e.g. cardiac muscle).
• Organs are functional and structural units made up of more than one type of tissue (e.g. the heart).
• A system comprises different organs working together for one main function (e.g. the respiratory system).
• Plants have tissues arranged in organs (e.g. the leaf), and two systems (root and shoot).
• Practical: Organisation of cells into tissues, organs and systems
• There are three stages of the cell cycle: interphase, mitosis and cytokinesis.
• During interphase, a cell grows and prepares for cell division.
• During mitosis, the nucleus of a cell is replicated.
• During cytokinesis, the cytoplasm of the cell divides, forming two identical daughter cells.
• A stem cell is a cell that can replicate or differentiate into one or more cell types.
• There are two types of stem cells: embryonic stem cells and adult stem cells.
• Stem stells can be classified as totipotent, pluripotent, multipotent or unipotent.
• Specialisation of cells into different cell types leads to groups of cells that have different structures and functions.
• Cell specialisation is controlled by internal factors. Chemical cell-to-cell contact and mechanical forces play a role in determining cell specialisation.
• Transcription factors turn specific genes on or off, determining cell specialisation and function.
Review questions: Complete these questions online or in your workbook.
1 The table shows the results recorded for cells of a tissue during a cell cycle.
Time taken (min) 6 7 4 9 14
Which of the following statements is correct?
A The spindle would be visible for no more than 26 minutes.
B Separation of the chromatids would take approximately 11 minutes.
C One cell cycle would be completed every 26 minutes.
D The cytoplasm would start dividing after the chromosomes became visible.
2 If you were observing a cell undergoing mitosis, which of the following would be evidence that it was a plant cell rather than an animal cell?
A absence of a spindle
B development of a cell plate in the middle of the cell
0 C replication of chromosomes
D disappearance of the nuclear membrane
3 Two cells that are the product of mitosis each have
A double the number of chromosomes of the “parent” cell.
B half the number of chromosomes of the “parent” cell.
C the same number of chromosomes as the “parent” cell.
D a mixture of chromosomes from each “parent” cell.
4 In order, the stages of the cell cycle are
A prophase, anaphase, interphase, metaphase, telophase, cytokinesis.
B interphase, prophase, metaphase, anaphase, telophase, cytokinesis.
C interphase, cytokinesis, prophase, telophase, metaphase, anaphase.
D prophase, interphase, cytokinesis, anaphase, metaphase, telophase.
5 Totipotent stem cells
A have many genes permanently switched off.
B can only differentiate into a single cell type.
C can differentiate into a limited number of cell types.
D can turn on any gene in their genetic material.
6 The potency of a stem cell refers to its ability to
A go through several cell cycles in a short period of time.
B maintain its integrity even with long delays between cell divisions.
C remain unspecialised.
D differentiate into specialised cell types.]
7 In plants, pluripotent stem cells are found in the A apical meristems.
B leaf stalks.
C leaf blades.
D main stem.
8 An embryonic animal system develops in the following sequence:
A organs → cells → tissues.
B tissue → cells → organs.
C cells → organs → tissues.
D cells → tissues → organs.
9 A stem cell is
A a specialised cell in the brain, responsible for transmitting electrical impulses.
B a cell with a specific shape and function.
C an unspecialised cell, capable of replicating and differentiating.
D an unspecialised cell, capable of producing one type of cell.
10 Cell specialisation can be defined as
A the process of cell replication by division.
B the ability of cells to change shape.
C the coordination of cells during development to form tissues.
D the development of cells with a specific shape and function, from a stem cell.
11 A stem cell that can differentiate into a few, related cell types would be described as
A totipotent.
B multipotent.
C pluripotent.
D unipotent.
12 Lung epithelial cells are specialised to enable the rapid movement of gases into or out of the body.
The structural specialisation that is most important for this function is
A a thin, flattened shape.
B a high concentration of mitochondria.
C cilia.
D a high concentration of lysosomes.
Review questions: Complete these questions online or in your workbook.
13 Describe one ethical issue involved in embryonic stem cell research for medical therapies. (1 mark)
14 Cells are invariably very small in size and can usually only be seen under a microscope. As organisms become larger, their cells remain the
same size but increase in number. Explain the importance of this phenomenon for body systems. (2 marks)
15 Describe the role of mitosis of stem cells in the development of an organism. (1 mark)
16 Describe how stem cells differentiate into specialised cells. (2 marks)
17 Explain how cells coordinate to form tissues and organ systems. (2 marks)
Analytical processes
18 Differentiate between totipotent, pluripotent, multipotent and unipotent stem cells in terms of life cycle stage and potency. (8 marks)
19 D istinguish between an embryonic stem cell and an adult stem cell. (2 marks)
Calculating total magnification and field of view
20 In the United States there are ‘banks’ of stem cell samples. In one such stem cell bank in North Carolina, there are over 100,000 samples of stem cells that have been collected from the amniotic fluid surrounding embryos within wombs. This form of collection does not harm the embryo. Evaluate three advantages of such a bank of stem cells for producing a compatible bioartificial organ for a recipient. (3 marks)
21 Evaluate the effectiveness of current stem cell therapies.
While observing samples under a microscope, it is important to determine the total magnification and field of view of the image. The magnification of a microscope is determined by multiplying the magnification of the optical lens by the magnification of the objective lens. The field of view is calculated by dividing the field number (the aperture of the objective lens) by the total magnification.
Total magnification = optical magnification × objective magnification
Field of view (FOV) = field number ÷ total magnification
Apply understanding
1 Calculate the total magnification and field of view to complete the two tables. (10 marks)
Calculation of total magnification
Total magnification = 10 × 4 = 40×
Calculation of field of view
2 The figure shows a human blood smear containing a large number of leukaemia cells (indicated) at 100× magnification, using an objective lens with a field number of 20.
a Calculate the field of view of the image. (1 mark)
b Determine the approximate diameter of the leukaemia cells in microns (1 mm = 1000 microns). (1 mark)
Interpret evidence
3 Infer the relationship between magnification and field of view. (1 mark)
4 Infer the relationship between field number and field of view. (1 mark)

Question 1
Prokaryotic organisms have the following characteristics:
A cell cytoplasm, nucleus and are unicellular.
B cell wall, organelles and are multicellular.
C cell wall, unicellular and have a nucleoid region.
D nucleus, ribosomes and are unicellular.
Question 2
Ribosomes produce proteins from monomers called
A amino acids.
B lipids.
C phosphates.
D sugars.
Question 3
The cell membrane is
A hydrophobic.
B impermeable to water.
C present in animal cells but not in plant cells.
D semi-permeable.
Question 4
Molecules that make up the cell membrane are called
A fatty acid tails.
B fluid mosaic membranes.
C hydrophilic phosphate heads.
D phospholipids.
Question 5
The purpose of extracellular fluid is to
A allow transport of materials between cells.
B secrete enzymes to aid digestion.
C suspend organelles within the cell membrane.
D transport hormones.
Question 6
Which of the following statements about organelles is correct?
A Amino acids are produced by ribosomes.
B Mitochondria are the powerhouse of the nucleus.
C Ribosomes are found only on the smooth endoplasmic reticulum.
D The endoplasmic reticulum and the Golgi apparatus are both made of cisternae.
Question 7
Glycoproteins are best described as
A integral proteins.
B monomers.
C nutrients.
D organelles.
Question 8
The body system responsible for breaking complex molecules into monomers to allow nutrients to be absorbed is called the
A circulatory system.
B digestive system.
C endocrine system.
D excretory system.
Question 9
Simple diffusion
A occurs across the cell membrane only.
B allows molecules to be moved against a concentration gradient.
C is a form of passive transport.
D requires energy in the form of ATP.
Question 10
The component of the cell membrane that prevents it being too rigid or too fluid is called
A a glycoprotein.
B cholesterol.
C dynamic equilibrium.
D integral proteins.
Which of the following statements about eukaryotic and prokaryotic organisms is correct?
A Eukaryotic organisms are unicellular and prokaryotic organisms are multicellular.
B Eukaryotic organisms are animals and prokaryotic organisms are plants.
C Eukaryotic organisms evolved from prokaryotic organisms.
D Prokaryotic organisms evolved from eukaryotic organisms.
Question 12
The figure below shows a cell in which phase of mitosis?
A anaphase
B cytokinesis
C metaphase
D prophase

FIGURE 1 A cell during mitosis
Question 13
14
Apoptosis in cells can be described as a A phase of mitosis.
B process that allows DNA to replicate before mitosis.
C process of organised cell death.
D structure that produces spindle fibres to pull chromosomes to the poles of a cell.
15
Cells grow during a phase of the cell cycle called
A anaphase.
B interphase.
C metaphase.
D telophase.
“Cristae” is a term used to describe the
A folds of the internal membrane in mitochondria.
B stacks of thylakoids in chloroplasts.
C organelles that produce proteins from amino acids.
D tail-like extension of some cells used for locomotion.
Question 1 (6 marks)
The surface area and volume measurements of different cells and organelles are given in the table. The surface area-to-volume ratio (SA:V) of the sperm cell is provided.
a Calculate the SA:V of the mitochondrion, red blood cell and egg cell to 1 decimal place. (3 marks)
b Sequence each cell/organelle from highest SA:V to lowest SA:V. (1 mark)
c Contrast the SA:V of the sperm and egg cells (2 marks)
Question 2 (2 marks)
Describe the function of chloroplasts in plant cells.
Question 3 (7 marks)
Bubble tea is a popular drink made with syrup and water. Sometimes small spheres of gelatine containing concentrated syrup, called popping pearls, are added.

FIGURE 2 Bubble tea
Students drinking bubble tea noticed that when they left their drinks for an hour, the popping pearls increased in size and burst. The students decided to conduct an experiment. They prepared three drinks at different concentrations of syrup and water, as shown in the table. They then added popping pearls to each of the three teas. Each popping pearl contains 1 ml of water and 1 ml of syrup.
Bubble tea preparation Water Syrup
Bubble tea 1
Bubble tea 2
Bubble tea 3
Question 5 (4 marks)
Explain why cells cannot grow to a very large size.
Question 6 (2 marks)
Contrast endocytosis and exocytosis.
Question 7 (4 marks)
While house sitting for a friend, you watered one of their house plants with water left over from cooking pasta. The water had cooled but it had salt in it from seasoning the pasta. Using your knowledge of diffusion and osmosis, explain why the plant died despite being given enough water.

150 m l 50 ml
100 m l 50 ml
50 ml 200 ml
TABLE 1 Water and syrup concentrations of three bubble tea preparations
a Determine the direction of water movement between the bubble tea and the popping pearls for each of the three drinks. (3 marks)
b Infer what may happen to the popping pearls when they are put into the most concentrated bubble tea drink. (2 marks)
c Suggest two improvements the students could make to their experiment to improve the reliability of their results. (2 marks)
Question 4 (3 marks)
Explain the role of the cell membrane in controlling the internal environment of the cell.
FIGURE 3 Why did watering the plant kill it?
Question 8 (3 marks)
Explain the importance of cell specialisation in eukaryotic organisms.
Question 9 (3 marks)
Describe the process of facilitated diffusion across a cell membrane.
Question 10 (4 marks)
Describe the structure and function of the endocrine system.
TOTAL MARKS /53 marks
All living organisms require an energy source and matter to survive. Organic matter is composed of carbohydrates, proteins, lipids and other compounds. The gases carbon dioxide and oxygen, water and mineral ions from the surroundings are prerequisite to the formation of these organic compounds. The energy required for cellular activities is released from organic compounds under the influence of enzymes, proteins that regulate the rate of chemical reactions in living organisms.
Prior knowledge quiz

Check your understanding of concepts related to the chemicals of life before you start.
→ Describe the structure and function of carbohydrates, proteins and lipids.
→ Describe the structure and function of enzymes, including the role of the active site.
→ Compare the induced-fit and lock-and-key models of enzyme function.
→ Explain how enzyme activity is affected by factors such as temperature, pH, presence of inhibitors and substrate concentration.
→ Investigate the effect of temperature/pH/substrate concentration on the reaction rate of different enzymes.
→ Explore how understanding enzymes, and their roles in metabolism, can be used to diagnose and treat metabolic disease.


These lessons are available exclusively on Oxford Digital.
Lesson 4.3 The effect of enzyme concentration on the rate of reaction
Learning intentions and success criteria
inorganic compound
a chemical compound that does not contain carbon (except for carbonates and cyanides) or carbon–hydrogen bonds organic compound
a complex carbon compound formed by living things; usually a macromolecule
macromolecule a large, complex molecule or polymer consisting of repeated smaller subunits (monomers)
carbohydrate a molecule of carbon hydrated with water; the general formula for monosaccharides is (CH2O)n (C:H:O = 1:2:1) and for polysaccharides is (C6H10O5)n (less hydrogen and oxygen because of glycosidic bonds)
monomer a molecule that can bond to other identical molecules to form a large molecule (polymer)
saccharide a sugar compound
monosaccharide a monomer of carbohydrates
disaccharide a molecule composed of two chemically bound monosaccharides (e.g. sucrose)
glycosidic bond a bond formed by condensation between two monosaccharides
→ Matter can be divided into two categories: inorganic compounds (non-living substances) and organic compounds (substances).
→ The three main types of organic compounds are carbohydrates, proteins and lipids.
→ Carbohydrates, proteins and lipids are large “macromolecules” that are made up of smaller subunits.
Matter can be divided into two categories.
• Inorganic compounds are non-living substances such as water, oxygen, carbon dioxide, nitrates and phosphates.
• Organic compounds are living substances made from carbon, hydrogen and other elements arranged into large, complex structures (called macromolecules).
Macromolecules are large organic molecules that play many important roles in biological processes. In this lesson we will look at the three main types of macromolecules – carbohydrates, proteins and lipids – including how they are formed and their functions in living organisms.
A carbohydrate is a macromolecule that consists of the elements carbon, hydrogen and oxygen. Carbohydrates are “hydrated carbons”, as they generally form in a set ratio where, for each carbon in a carbohydrate, there is one water molecule. The monomers (subunits) that make up carbohydrates are simple sugars, called saccharides. A monosaccharide (“mono” means one) is a single sugar molecule. Glucose, maltose and fructose are all examples of monosaccharides and have the same general formula, C6 H12O6 . Two monosaccharides can be linked together through a condensation reaction to form a disaccharide (“di” means two).
Disaccharides have the general formula C12 H 22O11, with the condensation reaction releasing a water molecule. The specific bond that links saccharides together is called a glycosidic bond Polysaccharides (“poly” means many) are long-chained carbohydrates that consist of multiple saccharides bonded together.
FIGURE 1 Monosaccharides, disaccharides and polysaccharides are types of carbohydrates.
Carbohydrates are an important energy source. They can be stored in the form of the polysaccharide starch in plants or glycogen in fungi and animals. Some polysaccharides also help provide structural integrity to living things (e.g. cellulose in plant cell walls, chitin in fungi and the exoskeletons of invertebrates). Polysaccharides are good storage molecules because:
• their large size makes them practically insoluble in water, so they do not affect the water balance of the cell
• they can fold into compact shapes
• they can readily be converted to sugars when energy is needed.


polysaccharide a complex carbohydrate composed of many monosaccharides bonded together
starch a complex carbohydrate made up of many glucose units joined by glycosidic bonds
glycogen a branched carbohydrate made from many glucose units, which animals use as an energy reserve
2 Some carbohydrates help improve the structural integrity of living things. (A) Cellulose is a component of plant cell walls. (B) Chitin forms the exoskeletons of invertebrates.
Proteins are chained macromolecules that contain the elements C (carbon), H (hydrogen), O (oxygen) and N (nitrogen). The monomers of proteins are called amino acids.
FIGURE 3 A protein molecule is a chain of amino acids.
Each amino acid has the same basic structure except for one group of atoms, which varies and is given the general letter ‘R’ (Figure 4). There are 20 ty pes of amino acid in the human body, each differing only in the composition of the R group, which can vary from a single atom to a large molecule. Although there are only 20 ty pes of amino acid, the differing order of the amino acids results in an enormous number of potential unique amino acid sequences. For example, there are more than 19,000 types of proteins in humans, each with a specific function determined by its unique amino acid sequence. A small change in the amino acid sequence of a protein can potentially destroy that protein or change the way it functions.
FIGURE 4 General structure of an amino acid
protein a macromolecule consisting of one or more polypeptide chains; may be folded, branched and/or crosslinked at intervals amino acid a building block of protein; consists of an amino group (NH2), a carboxyl (acid) group (COOH), a variable (R) group and a hydrogen atom attached to a carbon atom
peptide bond
a bond formed from condensation between two amino acids, where hydrogen (H) is lost from the amino group and a hydroxyl group (OH) from the carboxyl group
dipeptide
a molecule formed by the bonding of two amino acids
primary structure
the first level of structure of protein molecules; a chained linear sequence of amino acids
secondary structure the second level of structure of protein molecules; the local arrangement of a protein backbone that has been stabilised by intramolecular hydrogen bonding
The bond that links amino acids is called a peptide bond . A dipeptide is formed when two amino acids bond together, and a polypeptide is formed when multiple amino acids bond together. Every protein consists of one or more polypeptide chains. These chains may be folded, branched and/or cross-linked at intervals, depending on their structure.
Proteins have four levels of structural configuration: primary, secondary, tertiary and quaternary. The primary structure of a protein is its linear polypeptide chain, which consists of 50 to 1000 linked amino acids (Figure 5). As a polypeptide chain is assembled, interactions between the amino acids along the chain and hydrogen bonding cause the chain to fold. This folding is the secondary structure , and it forms one of two shapes: α -helix or β -pleated sheet (Figure 6). Fibrous proteins are proteins whose structure is mainly secondary, forming either sheets or long strands. They often have a structural or mechanical function (e.g. spider webs consist of fibroin, which contains many β -pleated sheets).
Primary
Secondary
Sequence of amino acids a-helix
Folding of amino acid chains into a-helixes and b-pleated sheets
Polypeptide chain
FIGURE 5 Summary of the four levels of protein structure
Tertiary
Three-dimensional interactions between secondary structures
Quaternary
Several polypeptides combined
FIGURE 6 Secondary protein structures: α -helix and β -pleated sheet
Proteins with a tertiary structure are polypeptide chains that have folded into a three-dimensional, globular shape. This occurs when the R groups of amino acids along a polypeptide chain interact with each other. Proteins with a quaternary structure consist of two or more polypeptide chains that have folded in together to form a three-dimensional structure.
Proteins are not indestructible. They can undergo denaturation (the breaking down and loss of their shape and therefore functionality) when exposed to high heat, strong acids or bases, organic solvents or heavy metals. The types of proteins and their functions in living organisms are summarised in Table 1.
TABLE 1 Types of proteins and their functions in living organisms
Category
Example
Type
Occurrence/function
Structural Keratin Fibrous Skin, feathers, nails, hair, horn, silk
Sclerotin Fibrous Exoskeleton of insects
Mechanical Collagen Fibrous Tendons, cartilage, bones – resists stretching
Elastin Fibrous Ligaments
Enzyme Amylase Globular Catalyses hydrolysis of starch to maltose
Trypsin Globular Catalyses hydrolysis of protein
Hormone Insulin Globular Involved in glucose metabolism
Transport Haemoglobin Globular + iron group Transports oxygen in vertebrates’ blood
Protective Antibodies Globular Form complexes with foreign proteins to neutralise them
Contractile Myosin Fibrous Moving filaments involved in muscle contraction
Actin Fibrous Stationary filaments involved in muscle contraction
Storage Egg albumin
Casein
Toxins Snake venom (enzymes)
Globular + nonprotein group Egg white protein
Globular + nonprotein group Milk protein
Globular Paralyse/kill prey
tertiary structure the third level of structure of a protein molecule; exists when a polypeptide chain is folded into a threedimensional molecule quaternary structure the fourth level of structure of a protein molecule; exists when more than one polypeptide chain is folded into a threedimensional molecule denaturation the process in which the weak links or bonds in a biological molecule (i.e. proteins, carbohydrates) break down
Haemoglobin is a pigment carried in red blood cells. It has the special property of being able to combine loosely with oxygen, picking it up from areas where oxygen levels are high (e.g. the lungs) and depositing it in areas where it is low (e.g. active cells).
The haemoglobin molecule consists of two pairs of polypeptide chains, each of which is combined with an iron-containing group. Each type of chain contains about 150 amino acids. The entire haemoglobin molecule consists of 600 amino acids and four iron groups.
In the hereditary disease sickle-cell anaemia, one amino acid (glutamic acid) in each chain of one of the pairs is replaced by a molecule of a
different amino acid, valine. The two substituted valines create two ‘sticky’ areas on the surface of the haemoglobin molecule. These areas are attracted to each other and distort the shape of the entire molecule into a stiffened rod.
Red blood cells containing large proportions of these altered molecules become stiff and deformed, taking on a characteristic sickle shape. These cells are much more fragile than normal red blood cells and rupture easily. Because of their shape, they tend to clog small blood vessels, creating blood clots that prevent a full supply of blood to vital organs. This results in pain, intermittent illness and often a shortened life span.

Apply your understanding
Normal red blood cells are compact and flexible, enabling them to squeeze through small capillaries.
Sickled red blood cells are sti and angular, causing them to become stuck in small capillaries.

1 Contrast normal haemoglobin structure with the altered haemoglobin structure in sickle-cell anaemia. (2 marks)
2 Describe how the altered structure of sickle cell haemoglobin affects its function. (1 mark)
Lipids are fats, oils and waxes. Fats and waxes are solid, whereas oils are liquid at room temperature. Lipids contain carbon, hydrogen and oxygen but, unlike carbohydrates, there is no set ratio of these elements. Lipids are composed of two basic monomers: fatty acids and glycerol
lipid a macromolecule made up of fatty acids and glycerol
fatty acid a compound (RCOOH) formed between a carboxyl (COOH) group and a chain of hydrocarbons of variable length (R) glycerol a structural component of lipids
Fatty acid and glycerol molecules
FIGURE 8 Lipids are made from fatty acids (blue) and glycerol (grey).
Lipid molecules
Fatty acids have the general formula RCOOH, where R is a variable group consisting of a hydrocarbon chain (Figure 9). This chain or “tail” is non-polar (does not carry an electric charge) and hydrophobic (water repellent). The carboxyl (acid) group (–COOH) is polar and hydrophilic (water loving). Lipids are formed when fatty acids and glycerol bond together. This bond, known as an ester bond , removes an –OH from the fatty acid and a –H from the glycerol and forms water as a byproduct.
Carboxyl group acid head (polar and hydrophilic)
R group = hydrocarbon tail (non-polar and hydrophobic)
hydrophobic describes substances that are insoluble in water
hydrophilic describes substances that dissolve readily in water ester bond a bond formed by condensation between a fatty acid (removal of OH) and glycerol (removal of H)
9 Basic structure of a fatty acid
The most common lipids are triglycerides, which are formed when three fatty acids bond with a single glycerol molecule (Figure 10). The three fatty acids that bond to glycerol may be all the same or a combination of different fatty acids.
The term “phobic” comes from the Latin for “fear” and the term “philic” comes from the Latin for “love”. You can use this to help remember that hydrophobic means “water fearing” and hydrophilic means “water loving”.
triglyceride a lipid formed from one molecule of glycerol and three molecules of one or more types of fatty acids
saturated describes a lipid in which the carbon atoms are linked by single bonds only (C–C)
unsaturated describes a lipid in which the carbon atoms are linked by one or more double bonds (C=C)
FIGURE 10 A triglyceride molecule
Stearate (saturated)
Oleate (mono-unsaturated)
Linoleate (poly-unsaturated)
The physical nature of a lipid is determined by the length of the carbon chains in the fatty acids, and whether these chains are saturated (consist of only single bonds between carbon atoms) or unsaturated (consist of one or more double bonds between the carbon atoms). Lipids formed from saturated fatty acids are more compact, and therefore form solid fats and waxes (e.g. butter and lard). Lipids with one or more unsaturated fatty acid chain do not pack as closely together and therefore tend to form liquid oils (e.g. olive oil, eucalyptus oil).
Lipids are non-polar, so they are relatively insoluble in water. They play an important role in the control of water balance in the organism, and are therefore an important component of the membranes surrounding cells. Waxes form protective waterproof coatings on the external surface of the exoskeleton of insects, the feathers of birds and the hair of mammals. Many plant surfaces, such as leaves and fruit skins, are coated with a lipid cuticle that reduces evaporative water loss.
In terms of energy content, lipids can store up to twice the amount of energy that a carbohydrate of the same mass can store. This makes lipids an important energy reserve in living organisms. In animals, fat is stored in special cells, which in vertebrates are commonly found under the skin. These fat layers can be especially important to animals that live in cold environments. In seals and whales, “blubber” acts as an insulator and contributes to buoyancy. Hibernating animals like bears build up large fat reserves during summer, to provide them with energy over the cold winter months. Fat also surrounds and protects vital organs such as heart and kidneys. Plants store oils rather than fats. Plant oils can help provide energy for germination and can play a role in plant defence mechanisms.
Phospholipids are similar to triglycerides, except that rather than containing three fatty acids, one fatty acid is replaced by a phosphate group plus an organic base (Figure 11).
Phospholipids are an important component of cell membranes. In Module 2 you learnt that the cell membrane of eukaryotic cells is made from a phospholipid bilayer.
phospholipid a lipid in which a polar phosphate group has replaced one fatty acid
Phosphorus-containing group (polar end)
This part of the molecule is very soluble in water.
organic base Tail
backbone 2 fatty acid hydrocarbon chains (non-polar end)
These parts of the molecule are very insoluble in water.
Head phosphate Polar hydrophilic head
11 Structure of a phospholipid
Non-polar hydrophobic tail
Steroids have a ring-like chemical structure that differs from all other lipids. However, they are still classified as lipids, because they are insoluble in water and soluble in fat solvents. Steroids include sex hormones, adrenal cortex hormones and cholesterol. They are abundant in both plants and animals, where they have many important biochemical and physiological roles. Cholesterol is a steroid found throughout the human body. It is an important component of cell membranes and a constituent of bile, which emulsifies fats.
TABLE 3 Summary of the structure and function of carbohydrates, proteins and lipids
Macromolecule Elements
Carbohydrate (e.g. glycogen, starch)
Protein (e.g. enzymes)
Lipid (e.g. fats, oils, waxes)
C, H, O
C, H, O, N
C, H, O ( + P in phospholipids)
Smaller molecules (monomers, building blocks)
Monosaccharides – single simple sugar (e.g. glucose)
Dissacharides – 2 simple sugars bonded together (e.g. sucrose)
Amino acids – 20 common types; all may be present in one molecule
Fatty acids and glycerol –may also contain phosphate
steroids a class of lipid molecules that have a distinct chemical structure that contains four fused carbon rings
Macromolecules (polymers) Type of bonding
Polysaccharides
Glycosidic
Polypeptides, proteins Peptide
Lipids (e.g. phospholipids, triglycerides, waxes and steroids) Ester
Check Your Learning 4.1: Complete these questions online or in your workbook.
Retrieval and comprehension
1 Identify the monomers for:
a carbohydrates (1 mark)
b proteins (1 mark)
c lipids. (1 mark)
2 Define a macromolecule. (1 mark)
3 Describe the general structure of carbohydrates. (3 marks)
4 Explain why polysaccharides make good storage molecules. (3 marks)
5 Describe the formation of a polypeptide chain, including the type of bond. (2 marks)
6 Identify the structural components of a phospholipid molecule. (1 mark)
Learning intentions and success criteria
chemical energy the energy stored within molecular bonds that is released during a chemical reaction metabolism chemical reactions occurring within a cell activation energy the energy needed to start a chemical reaction
7 Describe three functions of lipids in living organisms. (3 marks)
8 Describe the secondary structure of a protein. (2 marks)
Analytical processes
9 C ompare triglycerides and phospholipids. (3 marks)
10 Distinguish between tertiary and quaternary protein structure. (2 marks)
Knowledge utilisation
11 Determine whether the triglyceride shown in Figure 10 would be solid or liquid at room temperature. Justify your answer. (2 marks)
→ All metabolic reactions require activation energy, a specific initial input of energy, to proceed.
→ Enzymes are biological catalysts that lower the activation energy needed for a chemical reaction to occur.
→ There are two models for understanding how enzyme action works: the lock-and-key model and the induced-fit model.
→ Temperature, pH, substrate concentration and inhibitors are all factors that can influence enzyme activity.
Energy is the ability to do work. All living cells require energy so they can grow, reproduce and perform tasks that help them stay alive. Cells primarily use chemical energy (energy that is stored within chemical bonds between the atoms of molecules) to store energy for later use and to release energy to power cellular processes. You will learn more about how cells use energy in Module 7. Cellular metabolism is the complete set of chemical reactions that occur for a cell to function. All reactions, including those needed to form and break down molecules, require a specific amount of energy to “jump-start” the reaction – this is known as activation energy
All cellular reactions require activation energy, which is the initial input of energy required to start a reaction, before they can proceed. Activation energy helps prevent reactions from occurring spontaneously, at unwanted times or in an uncontrolled manner. For example, the breaking down of the sugar molecule glucose is an important metabolic reaction that yields energy for the cell. Glucose contains potential energy, which can only be released when glucose is broken down into smaller molecules after an oxidation reaction.
Mixing glucose and oxygen does not automatically ensure that the oxidation process will proceed. The reaction must be activated. For this to occur, activation energy is needed. An example is the burning of wood. Wood will not just burn spontaneously. It requires the addition of heat from fire for the bonds between the cellulose molecules in the wood to be broken. Once the added energy reaches the activation energy required, the wood will burn and release the large amount of energy stored in its bonds. Regardless of whether a reaction gives off or absorbs energy, some energy is required initially to start the reaction.
The molecules of reactants in any chemical reaction are in continual random motion.
These molecules can only react after they have successfully collided with each other. Therefore, any factor that increases the frequency of successful collisions will also increase the rate at which the reaction occurs. Two factors that can influence the frequency of successful collisions are:
Increase concentration of reactants

FIGURE 1 The carbon in wood requires activation energy from heat to react with oxygen and create carbon dioxide.
2 The rate of a reaction can be increased by increasing the concentration of reactants.
1 the concentration of reactants – the greater the concentration of reactants (i.e. the more densely they are packed), the more likely they are to collide and react
2 temperature – raising the temperature speeds up the random motion of the molecules, thereby increasing the probability of their colliding.
While these two factors can be used to increase reaction rate, their use is sometimes limited in cells. For example, a cell might not always have the resources needed to increase the concentration of reactants. Additionally, while many biological reactions can be made to occur more quickly by heating, cells cannot tolerate too much heat, because biological compounds can decompose at high temperatures. Because of this, sometimes cells need to rely on other mechanisms to increase the rate of a reaction.
reactant a substance that is present at the start of a reaction and changes as the reaction proceeds Before
The temperature of the system increases.
Heat is applied.
Heat increases the energy and speed at which molecules move.
FIGURE 3 The rate of a reaction can be increased by increasing the temperature.
Catalysts are molecules that lower the activation energy of a reaction, so the reaction can reach completion more quickly. When a catalyst is present, each reactant is drawn to the surface of the catalyst where, once they are in close enough proximity, they can react. The new product then detaches from the catalyst, which remains unchanged by the process and can be used again. Biological catalysts that speed up the rate of a reaction without being consumed in the reaction are called enzymes. Enzymes are tertiary proteins that
enzyme a biological catalyst, produced by living cells, that changes the rate of chemical reactions in living organisms
intracellular located within the cell
extracellular located outside the cell substrate the molecule(s) that an enzyme reacts with to form an enzyme–substrate complex
active site the portion of an enzyme in contact with the substrate; at this stage it has a specific shape that corresponds to the shape of at least a portion of the substrate molecule
regulate the rate of metabolic processes inside and outside cells. Enzymes can be classified into two main groups: intracellular and extracellular. Intracellular enzymes occur within the cell, where they control metabolism. Extracellular enzymes are catalytic proteins produced by cells, but they work outside the cell. Normally an enzyme is named by adding the suffix “-ase” to the name of the substrate on which it acts. So, for example, maltase acts on maltose and lipase acts on lipids.
A cell can contain thousands of types of enzymes, each interacting only with a specific molecule or set of molecules, called a substrate(s). Enzymes bind with their substrate(s) at a region on the enzyme known as the active site (Figure 4). Some enzymes orientate the reacting particles to increase the chance of successful collisions. Other enzymes can form enzyme–substrate complexes that requires less energy for the reaction to proceed. The enzyme–substrate complex can bend the substrate molecule in a way that helps to break the chemical bonds to reach the transition state. Regardless of how an enzyme acts, they produce the same product that the uncatalysed reaction would have, but at a lower net activation energy. Because the enzyme does not react and is left relatively unchanged, it can be reused.
lock-and-key model
a model that suggests that the substrate and active site of an enzyme are complementary in shape and fit together like a lock and key
induced-fit model
a model that suggests that the active site of an enzyme, after initially attracting a specific substrate, changes to suit the substrate’s shape, which in turn also affects the shape of the substrate
Energy of reactants
FIGURE 4 Substrates bind to the active site of an enzyme.
Each enzyme controls only one (or one type of) reaction. This enzyme specificity occurs because the active site of any particular enzyme can accommodate only a certain shape of substrate molecule. Therefore, many different enzymes may be required in a multi-step reaction (e.g. respiration, photosynthesis, synthesis or hydrolysis of organic molecules).
Key:
EA = activation energy
EA1 = no enzyme
EA2 = with enzyme
= non-catalysed reaction = enzyme-catalysed reaction
EA1
EA2
Overall energy change of the reaction
Energy of products
FIGURE 5 This energy diagram shows that the presence of an enzyme lowers the activation energy of a reaction.
While enzymes may differ in function, they share the following properties.
• Their structure is tertiary and globular in shape.
• They increase the rate of reaction without being used up.
• Their presence does not alter the nature of the end products of the reaction.
• A small amount of enzyme catalyses a large quantity of substrate.
• They are specific in action, generally catalysing one specific reaction or part of a reaction.
Various models have been proposed to explain how enzymes lower the activation energy of a reaction. Different reactions may use one or more of the following methods.
• When bound to the substrate, the enzyme may change shape. This may place stress on some substrate bonds, making them more easily broken.
• Substrates may form weak bonds with their specific enzymes, resulting in the redistribution of electrons within the substrate molecule, making it more reactive.
• The binding of the substrate to the enzyme may orientate the substrate molecules in a way that maximises reactivity.
Two models that can explain the overall action of enzymes are the lock-and-key model and the induced-fit model
The lock-and-key model proposes that an enzyme’s function depends on its shape. According to the lock-and-key hypothesis, a substrate will attach to the active site of an enzyme in much the same way as a key fits into a lock. The shape of the enzyme’s active site is complementary to the shape of the substrate. Because of this, the substrate molecule fits almost perfectly into the enzyme. The portion of the enzyme that is in contact with the substrate (active site) is very small compared with the total size of the enzyme molecule. When the substrate binds to the active site, it forms an enzyme–substrate complex, which triggers the formation of products. Once formed, the product molecules no longer fit into the active site and escape into the surrounding medium, leaving the active site free to interact with other substrate molecules.
Substrates
Active site
Sometimes a substrate does not have a complementary shape that fits precisely into the active site of the enzyme. The induced-fit model proposes that the shapes of both the enzyme and the substrate change after they make contact, to induce a better fit between the substrate and the active site. The substrate and active site change in conformation (arrangement) until the substrate is fully bound to the enzyme, forming the enzyme–substrate complex. Once bound, strong bonds form between the substrate and the enzyme that lower the activation energy of the reaction. The product(s) then detach from the enzyme and the enzyme can be reused.
Substrates
Active site undergoes conformational change
catalyst a substance that increases reaction rate without being consumed or changed by the reaction
The metabolism of chemical compounds in the cell usually involves several separate reactions, each mediated by a specific enzyme. If an enzyme in a metabolic pathway is absent or faulty, the correct sequence of chemical reactions might not occur. Different products would form, and some of these could be dangerous to the health of the cell.
When excess proteins are taken into the body, they are not stored but are broken down in a series of steps. Each step requires an energy input, but energy is also released as a product. In the normal course of events, a protein will undergo a series of hydrolysis reactions to release the component amino acids, one of which is phenylalanine. The liver produces the enzyme phenylalanine hydrogenase, which brings about the conversion of phenylalanine to another amino acid, called tyrosine. If this enzyme is faulty, phenylpyruvic acid is formed instead of tyrosine. This can lead to a disease called phenylketonuria (PKU) which, when untreated, can result in symptoms including intellectual disability, musty body odour and seizures.
Tyrosine can be used in two other series of reactions – one that results in the formation of the growth hormone thyroxin and the other producing the skin pigment melanin. Each set of reactions has its own series of enzymes. Absence of any of these enzymes can produce chemicals that may have adverse effects on the body. The figure illustrates the products that can result from enzyme failure at various points along the catabolic pathway of phenylalanine.
Protein
Proteins are broken down (hydrolysed) to release free amino acids (e.g. phenylalanine).
A series of enzymes convert tyrosine to thyroxine.
Thyroxine
Congenital hypothyroidism –if untreated, causes mental disabilities, lethargy, jaundice (yellowing of skin), physical disability
CO2 + H2 O
If enzymes are faulty, results in:
Phenylalanine hydroxylase
Phenylalanine Tyrosine
Trans-aminase
A fault in the enzyme causes build-up of:
Tyrosinase
A fault in the enzyme results in:
Hydroxyphenylpyruvic acid
Hydroxyphenylpyruvic acid oxidase
Homegentistic acid
Homegentistic acid oxidase
Maleylacetoacetic acid
A fault in the enzyme results in:
A fault in the enzyme results in:
Apply your understanding
Phenylketonuria –intellectual disabilities, excessive muscular tension and activity, musty body odour, light skin colour, eczema
Phenylpyruvic acid which causes Melanin
Albinism –lack of pigment melanin in body tissues (e.g. skin, hair, eyes)
Tyrosinemia –chronic liver and kidney disease, or death from liver failure
Alkaptonuria –dark urine, pigmentation of cartilage and other connective tissues; eventually arthritis
1 Identify which enzyme is required for the appropriate breaking down of phenylalanine. (1 mark)
2 Describe the process of breaking down phenylalanine in a person with phenylketonuria (PKU). (1 mark)
Enzyme activity can be influenced by several factors, including temperature, pH, substrate concentration and the presence of inhibitors.
Enzymes are heat-sensitive – that is, each enzyme has an optimum temperature at which it functions best (approximately 30°C in plants and 37°C in humans). Enzymes may still function outside their optimal temperature (or tolerance range), at reduced efficiency. If the temperature is far above what enzymes can tolerate (e.g. 50°C in humans), they are destroyed by denaturation, which involves a change in the shape of the enzyme protein. Although the action of enzymes may be inhibited at low temperatures (e.g. freezing), their protein structure remains unaltered.
8 The effect of temperature on rate of enzyme activity
Enzymes are pH sensitive. This means each enzyme has a specific optimum pH and will only work within a narrow range of its optimum pH. If the pH surrounding an enzyme is higher or lower than the enzyme’s pH tolerance range, the bonds within the enzyme can break down. This can cause the enzyme to lose its shape and function.
Enzymes are influenced by the concentration of substrates. As the concentration of substrate increases, the rate of enzyme action increases to a maximum value, known as the limiting value, and then plateaus. This maximum rate is reached when the enzyme is being used at maximum efficiency. Any substrate added after this point will not increase the reaction rate, because the enzyme is already working as efficiently as possible.
Enzyme inhibitors are molecules that bind to an enzyme to reduce or prevent its activity. There are two main types of inhibitors.
• Competitive inhibitors compete with the normal substrate molecules for the active site.
• Non-competitive inhibitors bind to a different site on the enzyme, called the allosteric site, causing a change in the enzyme that reduces or completely blocks its activity.
enzyme inhibitor a molecule that binds to an enzyme and blocks its activity competitive inhibitor a substance that occupies the active site of an enzyme and prevents the normal substrate from binding non-competitive inhibitor a substance that binds to the allosteric site of an enzyme and permanently reduces or blocks an enzyme’s activity
allosteric site a region on an enzyme, separate from the active site, where a molecule may bind, altering the shape of the active site
Optimum pH range
Rate of enzyme activity
FIGURE 9 The effect of pH on rate of enzyme activity
Normal binding
Substrate
Active site
Enzyme
Rate of enzyme activity
Limiting value
Substrate concentration
FIGURE 10 The effect of substrate concentration on rate of enzyme activity
Competitive inhibitionNon-competitive inhibition
Competitive inhibitor
FIGURE 11 How competitive and non-competitive inhibitors bind to enzymes
FIGURE 12 The effect of inhibitors on reaction rate pH
Allosteric site
Non-competitive inhibitor
Competitive and non-competitive inhibitors both decrease enzyme activity and therefore the rate at which a reaction occurs. A competitive inhibitor will initially lower the rate of reaction, but the rate of reaction can return to that of a normal enzyme with increasing substrate concentration. A non-competitive inhibitor decreases the rate of reaction even with increasing substrate concentration, because it alters the way in which the enzyme functions.
Rate of reaction
Normal enzyme
Competitive inhibitor
Non-competitive inhibitor
Substrate concentration
A student wants to investigate how enzyme concentration influences the rate of a reaction.
They run two conditions of an experiment.
• In condition A they track the progress of an enzyme-catalysed reaction by monitoring reaction rate in response to a steady increase of both substrate concentration and enzyme concentration.
• In condition B they track the progress of an enzyme-catalysed reaction by monitoring reaction rate in response to a steady increase of enzyme concentration and a constant substrate concentration.
1 Predict the impact on reaction rate you would expect the student to see in experiment A.
Justify your prediction. (2 marks)
2 Predict the impact on reaction rate you would expect the student to see in experiment B.
Justify your prediction. (2 marks)
The pancreas produces enzymes that are used in the digestion of proteins, lipids and carbohydrates (proteases, lipases and amylases). For people suffering from cystic fibrosis, pancreatitis and other conditions of the pancreas, pancreatic enzymes are available in tablet form and are taken orally. However, the tablet dosage must be increased gradually from the lowest dose. The dosage instructions are as follows:
• 500 lipase units/kg of body weight/meal for 2 months, then:
• 1000 lipase units/kg of body weight/meal for 2 months, then:
• 1500 lipase units/kg of body weight/meal for 2 months, then:
• 2000 lipase units/kg of body weight/meal for 2 months, then:
• 2500 lipase units/kg of body weight/meal until a 1 ye ar review appointment. Tablets are colour coded and available in 5000 (red), 10,000 (green), 15,000 (blue) and 20,000 (yellow) lipase units.
Practise your skills
1 Determine for a 110 kg patient:
a the starting dose (1 mark)
b the combination of coloured tablets for the starting dose. (1 mark)
2 A 60 kg elderly patient with pancreatitis requires pancreatic enzymes. Use the colour code of the tablets to structure a set of instructions for the patient and their carer, from the start of treatment until the 1 ye ar review. Try to keep the same colour for each dose. Remember, the doses are per meal, not per day. Use the least number of tablets possible.
Need help communicating information to different audiences? Go to Lesson 1.X in your biology toolkit.
Check Your Learning 4.2: Complete these questions online or in your workbook.
Retrieval and comprehension
1 Define activation energy. (1 mark)
2 Describe the function of enzymes, with reference to activation energy. (1 mark)
3 Describe the role of the active site in enzyme function. (2 mark)
4 Explain how each of the factors below influences the rate of enzyme activity.
a temperature (1 mark)
b substrate concentration (1 mark)
c inhibitors (1 mark)
d pH (1 mark)
Analytical processes
5 Compare the lock-and-key and induced-fit models of enzyme function. (4 marks)
6 D istinguish between a competitive inhibitor and a non-competitive inhibitor. (2 marks)
Knowledge utilisation
7 A student monitoring an enzyme-catalysed reaction collected the data shown in the table.
a Graph the data in the table. (3 marks)
b Identify the substrate concentration at which the reaction reached its limiting value. (1 mark)
c Explain why the reaction rate plateaued (rather than increasing) after reaching the limiting value. (1 mark)
Practical Lesson 4.3
This lesson is available exclusively on Oxford Digital.
• Matter can be divided into two categories: inorganic compounds (non-living) and organic compounds (living substances).
• The three main types of organic compounds are carbohydrates, proteins and lipids.
• Carbohydrates, proteins and lipids are large “macromolecules” that are made up of smaller subunits.
• All metabolic reactions require activation energy, a specific initial input of energy, to proceed.
• Enzymes are biological catalysts that lower the activation energy needed for a chemical reaction to occur.
• Two models for understanding how enzyme action works are the lock-and-key model and the induced-fit model.
• Temperature, pH, substrate concentration and inhibitors are all factors that can influence enzyme activity.
• Practical: The effect of enzyme concentration on the rate of reaction.
Review questions: Complete these questions online or in your workbook.
1 A protein that consists of two polypeptide chains folded together into a three-dimensional shape would be considered as having
A primary structure.
B secondary structure.
C tertiary structure.
D quaternary structure.
2 Simple proteins are composed of
A fatty acids.
B monosaccharides.
C glycerol.
D amino acids.
3 Phospholipids are an important structural macromolecule in
A cell walls.
B collagen.
C cell membranes.
D oils.
4 Enzymes are essential for biochemical reactions because they
A regulate the rate of reaction.
B work best at temperatures over 50°C.
C are not sensitive to pH changes.
D are used up in chemical reactions.
5 Saccharides are the monomers of
A proteins.
B carbohydrates.
C lipids.
D phospholipids.
Use the following information to answer questions 6 to 8.
Scientists studied an enzyme called enzymase. They tested the amount of product formed at different temperatures and pH levels, and their results are shown here.
6 The enzyme functions best at which of the following temperature ranges (in °C)?
A 10 to 20
B 20 to 30
C 30 to 40
D 40 to 50
7 At what pH does the enzyme function best?
A acidic
B basic
C neutral
D The pH does not affect the reaction.
8 The enzyme probably does not function at 70°C because
A the enzyme denatures at that temperature.
B there is too little substrate at that temperature.
C the amount of product increases at a higher temperature.
D the pH is not favourable.
9 Which of the following best summarises the lock-and-key model?
A The enzyme and substrate are modified to fit together.
B The enzyme is used up during the reaction.
C The enzyme and substrate fit together almost perfectly with no modifications.
D The activity of an enzyme increases with temperature.
10 The dotted vertical line (A) in the graph below represents
A the optimal substrate level for enzyme function.
B the optimal temperature for enzyme function.
C the tolerance temperature for enzyme function.
D the tolerance substrate level for enzyme function. Temperature
Rate of enzyme action as temperature increases
Review questions: Complete these questions online or in your workbook.
Retrieval
11 Identify and describe the monomer of carbohydrates. (2 marks)
12 Define activation energy. (1 mark)
13 Describe the structure and function of lipid macromolecules. (4 marks)
14 Describe the induced-fit model of enzyme function. (2 marks)
15 Phosphatase is an enzyme that will release phosphate groups from certain substrates.
When phenylphosphate is acted on by phosphatase, phenol is formed and its presence can be detected by a colour reaction. A student used this test to look for the presence of phosphatase in a variety of substances. Reactions included the following:
++ strong reaction; + weak reaction; – no reaction; NT not tested
No reaction occurred with any of the substances after the material had been boiled. The student concluded that this is due to the phosphatase denaturing. Explain this conclusion, with reference to optimal temperature. (3 marks)
16 Folate synthesis in cells relies on the activity of two enzymes: dihydrofolate reductase (DHFR) and dihydrofolate synthase (DHFS). Because cancer cells require large amounts of folate to support their prolific growth, inhibiting the action of DHFR can reduce folate synthesis, resulting in the death of the cancerous cells. Methotrexate is an enzyme inhibitor that does this, by competing with DHFR’s substrate and binding to the active site of DHFR, reducing folate synthesis. Because of this, methotrexate is often used as a chemotherapy drug in cancer treatments.
a Identify which type of inhibitor methotrexate is an example of. Justify your answer. (2 marks)
b Folate synthesis is also important for the growth of other cells in the body (not just cancerous cells). Predict one negative sideeffect that could result from treatment with methotrexate. (1 mark)
17 The figure below shows the biochemical process of the breaking down of lactose, the sugar in cow milk products.
The biochemical process of breaking down lactose
a Identify the enzyme that regulates the breaking down of lactose in cow milk products. (1 mark)
b Describe the structure and role of the active site of an enzyme. (2 marks)
c Lactose-intolerant individuals are not able to digest lactose in dairy products. Propose what may cause lactose intolerance. (2 marks)
18 Fatty acids are saturated or unsaturated. Unsaturated fatty acids (e.g. oleic acid, the chief constituent of olive oil) contain one or more double carbon bonds (C=C), allowing each carbon to react with another element or group of elements. These fatty acids melt at much lower temperatures (approximately 13oC) than saturated fatty acids (approximately 63oC).
In saturated fatty acids there are only single bonds between the carbons (e.g. stearic acid in lamb and beef fat).
Cells of ectothermic animals (animals that use behavioural means to partially control their body temperature, which varies with that of the environment) have a higher proportion of unsaturated fatty acids than endothermic animals (which control their body temperature by physiological means).
Propose a reason for this, justifying your response. (3 marks)
Enzymes in milk
Rennin is an enzyme that curdles milk and is found in the stomachs of mammals. An experiment is conducted in which rennin is added to milk at different temperatures. The results are shown in the table below.
Weight of curdled product at 4°C, 37°C and 80°C Temperature
Apply understanding
1 Calculate the average weight of curdled product at 4°C. (1 mark)
Analyse data
2 Identify the optimal temperature for the enzyme rennin to function, giving evidence to support your response. (2 marks)
3 Comment on the accuracy of the collected data. (1 mark)
Interpret evidence
4 A statistical test for the difference in mean weight of curdled product at 4°C and 37°C gave a P -value of P = 0.03. Use this information to draw a conclusion about the effect of temperature on the reaction rate of rennin, giving reasons for your response. (2 marks)

The cells of multicellular organisms extract nutrients from their environment, exchange respiratory gases and eliminate wastes. In multicellular organisms, the larger the organism, the further their internal cells are from the surface where this exchange take place. Therefore, specialised systems are needed to transport materials to and from cells. In mammals, the main transport system is the closed circulatory system, which includes the heart, blood vessels and blood.
Check your understanding of concepts related to transport of materials in animals before you start.
→ Explain how structural features of exchange surfaces in the digestive and circulatory systems of mammals (e.g. villi and capillaries) allow for efficient nutrient exchange.
→ Describe how closed circulatory systems facilitate the efficient transport of materials to and from all cells in the body.
Science as a human endeavour
→ Appreciate how understanding the anatomy and physiology of different body systems allows medical professionals to predict, diagnose, monitor and treat disease. Biology 2025 v1.0 General Senior Syllabus © State of Queensland (QCAA) 2025
Learning intentions and success criteria
transport system
a system of vessels responsible for the movement of materials throughout an organism
tissue fluid (extracellular fluid)
fluid formed from plasma that has been pushed out through the walls of capillaries under arterial pressure; surrounds the cells, providing a medium for exchange between blood and the cells
lymph
tissue fluid that has been taken up by lymphatic vessels to be returned to the blood (vascular system); contains a high volume of white blood cells
→ Large animals, such as humans, require a specialised transport system to deliver needed nutrients, facilitate gas exchange and remove wastes.
→ In mammals, three fluids are involved in transport systems: tissue fluid, lymph and blood.
→ The structure of red blood cells (erythrocytes) is highly specialised to facilitate their function of transporting oxygen around the body.
All multicellular organisms have the same basic requirements. They need to take in nutrients, exchange gases and remove wastes. While all organisms share these essential needs, the way in which each organism carries out these functions varies due to differences in their mode of nutrition, level of mobility, structure and physiology. Most animals have evolved specialised transport systems to meet these basic needs. In some small animals (e.g. flatworms), the transport of materials involves diffusion only. Larger animals (e.g. humans) have a dedicated transport system to move materials around the body. In mammals, materials are transported throughout the body in a liquid medium. Three fluids are involved: tissue fluid (or extracellular fluid), lymph and blood .


blood the transporting medium in animal bodies; in mammals, it is composed of plasma, platelets, and red and white blood cells
Tissue fluid is the liquid medium that surrounds individual cells. It is the main source of nutrients and gases from the blood, and it carries wastes from a cell to the blood or lymph. A cell’s plasma membrane controls the passage of molecules into and out of the cell through diffusion, facilitated diffusion or active transport.
Lymph is a clear liquid that consists of lipids and white blood cells (leucocytes). Lymph is carried in lymphatic vessels. It picks up tissue fluid and particles and returns these to the blood system. Lymph plays an important role in the body’s immune response. You will learn more about the immune response in Module 12.
Human blood is composed of red blood cells (erythrocytes), white blood cells ( leucocytes), plasma proteins and platelets suspended in a straw-coloured fluid called plasma . Plasma carries many important substances, including:
• proteins (e.g. enzymes, hormones and enzyme-coated lipids)
• specific plasma proteins involved in water balance, immunity and blood clotting
• carbon dioxide and nitrogenous wastes
• ions (salts)
• vitamins
• nutrients from digestion.
lymphatic vessel a tubular structure that carries lymph from tissues to the blood circulatory system
erythrocyte a red blood cell
leucocyte a white blood cell
plasma the liquid component of blood; contains water, salts, hormones and waste materials such as carbon dioxide
A comparison of the composition and function of transporting fluids in mammals is given in Table 1.
TABLE 1 Composition and function of transporting fluids in mammals
Fluid
Plasma (55% of blood)
92% water
Composition
7% proteins
Serum and fibrinogen
Tissue fluid (bathes living cells) Similar to plasma but has less protein
Lymph (inside lymph vessels) No protein
Rich in lipids
Contains lymphocytes
Functions
Transport of nutrients, waste products, hormones and heat
Cell homeostasis
Transport
Transport to veins
Phagocytosis of bacteria
Blood moves through a series of tubular vessels. These vessels, including arteries, veins and capillaries, vary in size, structure and function (Figure 2). The pumping action of the muscular heart moves blood through the vessels.
artery a thick-walled blood vessel that carries blood away from the heart; the main artery leaving the heart is the aorta; the smallest arteries are arterioles, which lead to capillaries vein a thin-walled blood vessel that carries blood towards the heart; the smallest veins begin at the capillaries; the largest vein in animals is the vena cava, which enters the heart
capillary a fine blood vessel with walls only one cell thick; capillaries permeate the body tissues and pressure causes plasma to pass out into the tissue fluid
Study tip
“erythr-” is derived from Ancient Greek and means red.
“leuco-“ means white.
Capillaries
haemoglobin the pigment molecule in red blood cells; contains four ironcontaining (haem) groups, each of which can combine with one oxygen molecule; has a high affinity for oxygen
FIGURE 2 Arteries, veins and capillaries are vessels that transport materials in the human body.
The main function of red blood cells is to transport oxygen from the respiratory surfaces to the tissues. Mature red blood cells have no nucleus and therefore cannot replicate, so they must therefore be constantly produced in the bone marrow. This occurs at a rate of about 1.5 million per second. Their biconcave shape (concave on both sides) ensures a maximum ratio of surface area to volume for the uptake and release of respiratory gases (oxygen). The shape also ensures smooth flow through the smallest blood vessels, as the diameter of a red blood cell is about the same as that of the finest capillaries.
Concave surface
Top view
FIGURE 3 Red blood cells have a biconcave shape.
Side view
A red blood cell is packed with the red pigment haemoglobin. A haemoglobin molecule consists of two pairs of polypeptide chains, and each chain is combined with an ironcontaining (haem) group. Each haem group can carry one oxygen molecule. Because the cell has no nucleus, it can carry m ore haemoglobin (and therefore more oxygen). A single red blood cell can carry 1000 million oxygen molecules.
One of the most common plasma proteins is albumin, which is involved in regulating the water content of cells and tissues through osmosis.
Plasma also contains globulin proteins. Two important groups of globulins are:
• gamma globulins, which are rich in antibodies and are produced by white blood cells. They play a significant role in the immune response (covered in Module 12)
• fibrinogens, which are essential in blood clotting. These and all other plasma proteins are formed in the liver.
Elaborate mechanisms have evolved to prevent the accidental loss of blood when a vessel is damaged. One of these mechanisms is to form a solid clot to plug the broken vessel. Clotting involves the conversion of soluble fibrinogen to insoluble fibrin. When a tissue is damaged, it releases a specific protein called thromboplastin. This protein sets off a series of complex chemical reactions that allow fibrinogen to be converted into fibrin. Because fibrin is insoluble, it forms a complex web that can bind platelets together and seal the damaged site of a transport vessel.


chain



































Heparin is an anticoagulant (sometimes called a blood thinner) produced in the liver and lung cells that decreases the clotting ability of blood. Explain what would happen if too much, or too little, heparin was produced in the human body.
Phlebotomy is the collection of a blood sample from a vein using a needle. Taking a sample allows a doctor to examine the blood for causes of disease. Blood tests can be used to give information about a wide range of health indicators, including cell counts, enzyme and hormone levels, blood glucose levels and cholesterol levels. Understanding the anatomy and components of blood allows medical professionals to diagnose diseases, infections and deficiencies, depending on the results of a blood test. This allows the monitoring and potential treatment of illnesses. Apply your understanding
1 A patient presenting with fatigue (low energy levels) returns a blood test indicating low iron levels. Explain why low iron in the blood may
Check your learning 5.1

cause fatigue for the patient, with reference to red blood cell function. (2 marks)
Check Your Learning 5.1: Complete these questions online or in your workbook.
Retrieval and comprehension
1 Describe the role of tissue fluid, blood and lymph in the transportation of materials around the human body. (2 marks)
Learning intentions and success criteria
2 Identify the constituents of blood. For each, describe its function. (4 marks)
3 Describe the structure of a red blood cell (erythrocyte) and how its structure aids its function. (3 marks)
→ The circulatory system facilitates movement of materials around the body. It varies in structure between different organisms.
→ Mammals have a closed double circulatory system, with blood travelling around the body within blood vessels and passing through the heart twice to complete a full circuit.
→ Blood vessels have specialised structures to assist with their function of transporting blood around the body. There are three types of blood vessels: arteries, veins and capillaries.
The circulatory system is network of organs that includes the heart, blood vessels and blood. In multicellular organisms, the circulatory system facilitates the movement of nutrients, gases and waste materials throughout the body via blood. Circulatory systems vary between different organisms. Some organisms, such as jellyfish and coral, do not have a “true” circulatory system. They do not have a pump organ or transport vessels to carry fluids. Instead, they exchange nutrients, gases and wastes with the water that surrounds them, via diffusion.
More complex organisms, such as mammals, have a true circulatory system, which has three key features:
• a muscular pump (e.g. the heart) to propel circulatory fluid through the system
• circulatory fluid (e.g. blood) that acts as the medium for transporting materials to the cells in the organism
• pipes or vessels (e.g. veins, arteries, capillaries) to carry the circulatory fluid.

FIGURE 1 Some organisms, such as jellyfish, do not have a circulatory system. Instead, they rely on diffusion for transport of materials.
Most invertebrates have an open circulatory system. In an open circulatory system, the circulatory fluid ( haemolymph) is not always contained in vessels. Instead, the fluid is pumped by the heart into vessels that are open at one end, with the fluid passing into an open cavity in the body, where exchange of nutrients and wastes takes place. In this open cavity, cells are bathed with haemolymph before the haemolymph is taken back, via vessels, to the heart to be pumped again.
All vertebrates (such as mammals, fish, reptiles, birds, amphibians) and some invertebrates (such as octopi), have a closed circulatory system to facilitate the transport of nutrients and wastes within the body. In a closed circulatory system, circulatory fluid (blood) is always contained within vessels during circulation. Circulation in a closed system is in one direction, with blood being pumped from the heart, through blood vessels, and back to the heart in a cycle. This enables a much larger volume of circulatory fluid to move through the body and makes closed circulatory systems more efficient at exchanging nutrients and wastes than open systems. The efficiency of the closed circulatory system is one of the contributing factors that allows organisms with closed systems to be more metabolically active. Artery
circulatory system the body system including the heart and blood vessels that is involved in transporting circulatory fluid, such as blood, around the body
open circulatory system a circulatory system where the circulatory fluid is not entirely contained within vessels but is pumped into a body cavity haemolymph the circulatory fluid in organisms that have an open circulatory system; is a mixture of blood and extracellular fluid
closed circulatory system a circulatory system where blood is always contained within blood vessels and the heart
double circulatory system
a system of blood vessels where the blood passes through the heart twice in a single circuit around the body
pulmonary circulation
the circulation of deoxygenated blood from the right side of the heart to the lungs, and the return of oxygenated blood from the lungs to the left side of the heart
ventricle
one of two muscular chambers of the heart that blood out of the heart into the arteries
systemic circulation
the circulation of oxygenated blood from the left side of the heart to the body cells, and the return of deoxygenated blood from the body cells to the right side of the heart
The mammalian circulatory system is made up of a series of vessels through which blood is pumped around the body by the rhythmic contractions of the heart. The mammalian circulatory system is known as a double circulatory system , because blood passes through the heart twice during one complete circuit.
Pulmonary circulation is the first passage of blood through the heart: when deoxygenated blood returns from the body to the heart, it is pumped by the right ventricle in the heart to the lungs. Gas exchange takes place on the surfaces of the alveoli in the lungs, and the oxygenated blood is then pumped back to the heart. Systemic circulation is the second passage of blood through the heart: when the oxygenated blood returns from the lungs to the heart, it is pumped by the left ventricle in the heart to the body tissues. The cells of the body tissues use the oxygen from this blood for aerobic cellular respiration, and then the deoxygenated blood is pumped back to the heart.
Capillary bed of lungs, where gas exchange occurs
Pulmonary veins
Oxygen-poor, CO2-rich blood
Oxygen-rich, CO2-poor blood
Capillary bed of all body tissues, where gas exchange occurs
In Lesson 5.1, you learnt that blood is transported through three types of vessels: the arteries, veins and capillaries.
Arteries are blood vessels that carry blood away from the pumping heart. Large arteries that are close to the heart are subject to blood flowing at high pressure and so they have thick muscular walls, to prevent the vessel from bursting. Exchange of material cannot occur between the arteries (or veins) and tissues due to the thickness of their walls, which consist of several layers of tissue.
The middle layers of the arteries are composed mainly of elastic fibres that enable them to dilate (expand) during ventricular contraction. When the ventricles of the heart relax, the muscles in the artery walls contract. This produces an even flow of blood along the length of the arteries.
As blood flows through the vessels, it loses energy due to friction between the plasma and the artery walls, and so pressure reduces. Further away from the heart, where blood pressure is lower, the artery walls contain more smooth muscle fibres that are served by nerves.
Nervous stimulation controls the diameter (or size) of these vessels and therefore blood flow. As the diameter decreases, blood pressure increases.
Blood passes from the arteries into smaller branches called arterioles, which become finer and finer, eventually leading into capillaries. Capillaries form a vast network of capillary beds pervading all parts of the body.
Capillaries are the smallest blood vessels in the body. No cell in the body is more than 0.5 mm away from a capillary. The diameter of a capillary is approximately that of a red blood cell. Capillary walls are composed of a single layer of thin flat cells (with a large surface area-tovolume ratio) that are permeable to all blood components except red blood cells and plasma proteins. This structure enables the efficient delivery of gases, nutrients and wastes between the blood in the capillaries and the surrounding body cells and tissues.
arteriole a small branch of an artery that breaks up into capillaries
Blood from the arteries enters the capillaries. Blood pressure forces the fluid, ions, gases and nutrients (other than red blood cells and plasma proteins) through the minute spaces between the cells of the capillary wall. These forced-out substances form the tissue fluid that surrounds cells. It is in this tissue fluid that materials are exchanged between the cells and blood. Eventually the concentration of large proteins left behind in the capillaries at the venous end becomes large enough to form an osmotic gradient, encouraging the movement of water back into the capillary. This fluid has negligible pressure. Excess tissue fluid not returned to the capillary vessels is taken up by the lymphatic vessels, while blood in the capillaries flows through to the veins.
Blood flow
Tissue fluid surrounds cells
Lymphatic system
Arteries carry blood
Away from the heart.
Capillaries Connect the arteries and the veins.
Veins have Valves and carry blood back to the heart.
venule
a thin-walled vessel that directly connects capillaries to veins
Excess tissue fluid is taken up by lymphatic system
Plasma forced out of capillary becomes tissue fluid
Body cells
Capillary
Tissue fluid returns to capillary vessels
FIGURE 5 A capillary bed, where materials are exchanged between blood and body cells
Capillaries unite to form fine venules that increase in size to form veins. Veins have thinner walls than arteries and are surrounded by skeletal muscle. Blood is returned to the heart due to the muscular contractions of the skeletal muscles surrounding the veins. Valves along the length of the veins prevent backflow of blood when these muscles relax. If a person is sitting still on an aeroplane or in front of a computer for a long time, their leg muscles are not contracting, and the blood is not being pushed through the veins. This causes the fluid to accumulate in the tissue, increasing the number of blood cells bumping against each other in the veins. As a result, blood clots can form, in a process called deep vein thrombosis. If parts of this blood clot travel to the heart, lungs or brain, it can result in death.
TABLE 1 Comparison of the structure and function of arteries, veins and capillaries
Arteries
Transport blood away from the heart
Capillaries
Link arteries to veins
Thick muscular walls Walls one cell thick, no muscle
Elastic tissue
Can contract
No valves
Circular cross-section
Not permeable
High blood pressure
Rapid flow
Pulse
Direction of flow
No elastic tissue
Cannot contract
No valves
Circular cross-section
Permeable to tissue fluid and white blood cells
Intermediate blood pressure
Slow flow
No pulse
Artery
Vein
Capillary
Veins
Transport blood towards the heart
Thinner, less muscular walls
Less elastic tissue than arteries
Cannot contract
Valves present
Oval cross-section
Not permeable
Low blood pressure
Slow flow
No pulse
Valves in the veins open to permit movement of blood towards the heart, but close to prevent back-flow.
Connective tissue
Elastic fibres and smooth muscle
Endothelium
Endothelium (one cell thick)
Connective tissue
Elastic fibres and smooth muscle
Endothelium
Check Your Learning 5.2: Complete these questions online or in your workbook.
Retrieval and comprehension
1 Identify the main structural components of all true circulatory systems. (3 marks)
2 Describe the structure of a closed circulatory system. (3 marks)
3 Describe the movement of blood through a closed double circulatory system, starting at the heart. (5 marks)
4 E xplain how the structural features of capillaries enable efficient exchange of nutrients, gases and wastes. (4 marks)
Analytical processes
5 C ompare the structure of arteries, veins and capillaries. (4 marks)
6 Contrast blood pressure in the arteries and the veins. Explain what causes the differences in blood pressure for each structure. (4 marks)
Skill drill
Anabolic steroids and atherosclerosis
Science inquiry skill: Identify, research and construct questions for investigation
Anabolic steroids are a group of synthetic (human-made) drugs that imitate testosterone, the male sex hormone that is important in the production of muscle mass. The use of anabolic steroids is banned in many sporting competitions, due to the advantage they may give competitors. There are several side-effects associated with their usage, including the potential for increased risk of heart diseases, such as atherosclerosis. Atherosclerosis is the narrowing of the arteries, the blood vessels responsible for carrying blood away from the heart under high pressure due to a buildup of plaque (fats, cholesterol and other substances) on the inner walls of the arteries.
Practise your skills
1 Design a research question to investigate the link between anabolic steroid use and atherosclerosis.
2 Identify the independent and dependent variables in the research question.
3 Suggest the types of evidence that could be researched for the investigation, and justify your choice(s).
4 Identify limitations of evidence that may affect the ability to draw a confident conclusion about a link between anabolic steroid use and increased risk of atherosclerosis.
Need help designing a research question? Go to Lesson 1.X in your biology toolkit.
• Large animals, such as humans, require a specialised transport system to deliver needed nutrients, facilitate gas exchange and remove wastes.
• In mammals, three fluids are involved in transport systems: tissue fluid, lymph and blood.
• The structure of red blood cells (erythrocytes) is highly specialised to facilitate their function of transporting oxygen around the body.
• The circulatory system facilitates movement of materials around the body. It varies in structure between different organisms.
• Mammals have a closed double circulatory system, with blood travelling around the body within blood vessels and passing through the heart twice to complete a full circuit.
• Blood vessels have specialised structures to assist with their function of transporting blood around the body. There are three types of blood vessels: arteries, veins and capillaries.
Review questions: Complete these questions online or in your workbook.
1 The human red blood cell is structurally suited to its function because it
A contains haemoglobin, which can reversibly form a complex with oxygen.
B is disc-shaped to increase surface area.
C contains enzymes to digest foreign bodies that enter the blood.
D contains a nucleus to ensure a long and active life.
2 Capillaries of the body are
A thin-walled blood vessels.
B tiny veins leading towards the heart.
C vessels that carry deoxygenated blood.
D tiny structures in the heart that help to operate the valves directing blood flow.
3 Valves, which prevent backflow of blood, are found in
A arteries.
B capillaries.
C veins.
D all blood vessels.
4 The flow of blood to the lungs and back to the heart is called
A arterial circulation.
B pulmonary circulation.
C systemic circulation.
D lung circulation.
5 The clotting of blood occurs when insoluble fibrin forms a web to bind together
A platelets.
B red blood cells.
C white blood cells.
D plasma.
6 The percentage of blood made up of plasma in humans is
A 20%.
B 45%.
C 55%.
D 85%.
7 Simple organisms such as jellyfish exchange nutrients and wastes with their surroundings via A their circulatory system.
B active transport.
C interstitial fluid.
D diffusion.
Use the following information to answer questions 8 to 10.
Direction of blood flow
Y Z Capillary wall Tissue cells
8 X is connected to
A an artery.
B a venule.
C an arteriole.
D a vein.
9 The fluid filling the space labelled Z is the A plasma.
B tissue (extracellular) fluid.
C blood.
D intracellular fluid.
10 The process in which materials are exchanged through Z is
A diffusion.
B osmosis.
C hydrolysis.
D haemolysis.
Review questions: Complete these questions online or in your workbook.
Retrieval and comprehension
11 Identify the features of a capillary that allow it to exchange materials with the extracellular fluid. (2 marks)
12 Describe the movement of materials between the capillaries and extracellular fluid. (1 mark)
13 For blood vessels that are not capillaries, explain why exchange of matter cannot occur between the blood vessel and the extracellular fluid. (2 marks)
14 Describe a closed circulatory system. (2 marks)
15 Humans have a double circulatory system. Describe the movement of blood through this system. (2 marks)
16 Identify five components of human blood, and the function of each. (5 marks)
Microscopy: red blood cells
Science inquiry skill: Use a light microscope to calculate total magnification and field of view.
The figure shows the field of view of human erythrocytes (red blood cells) seen through a light microscope with an eyepiece magnification of ×10 and using the ×40 objective lens.
Table 1 provides a summary of the magnifications and field of view (mm) of the light microscope.
TABLE 1 Magnifications and field of view (mm) of the light microscope
Red blood cells viewed through a light microscope
Table 2 provides the average diameter of some of the different types of blood cells in the human body.
TABLE 2 Average diameter of some types of human blood cells
Red
Apply understanding
1 Calculate the total magnification used to view the cells. (1 mark)
2 Calculate the field of view at the ×40 objective lens magnification. (1 mark)
3 Calculate the approximate diameter of the red blood cells (in µm) shown in the figure. (1 mark)
Analyse data
4 Identify which type of blood cell has smallest diameter, based on the values in Table 2. (1 mark) Interpret evidence
5 Infer why the type of blood cell you identified in Question 4 is smaller than other types of blood cells in the human body. (2 marks)
Animals are heterotrophs, organisms that are not able to synthesise their own food. Instead, they take in nutrients in organic form. Large macromolecules are chemically digested by enzymes into monomers, which can pass across exchange surfaces into the bloodstream and into cells. In the cell, these monomers are reconfigured, providing the cell with energy and nutrients. Waste materials resulting from cellular activities are removed from bodily fluids via the excretory system.
Prior knowledge quiz

Check your understanding of concepts related to exchange of nutrients and waste in animals before you start.
→ Describe the role of amylase, protease and lipase in chemical digestion.
→ Explain how metabolic processes, such as digestion, are controlled and regulated by enzymes.
→ Explain how structural features of exchange surfaces in the digestive and circulatory systems of mammals (e.g. villi and capillaries) allow for efficient nutrient exchange
→ Identify the parts of a nephron and their functions in the production of urine, i.e. glomerulus, Bowman’s capsule, proximal tubules, Loop of Henle, distal tubules and collecting duct.
→ Explain how glomerular filtration, selective reabsorption and secretion across nephron membranes contribute to the removal of waste.
→ Appreciate how understanding the anatomy and physiology of different body systems allows medical professionals to predict, diagnose, monitor and treat disease.

→ Investigate the effect of temperature/pH/substrate concentration on the reaction rate of different enzymes
→ Explore how understanding enzymes, and their roles in metabolism, can be used to diagnose and treat metabolic disease.
Biology 2025 v1.0 General Senior Syllabus © State of Queensland (QCAA) 2025

These lessons are available exclusively on Oxford Digital.
Lesson 6.3 The effect of temperature on the rate of reactions of an enzyme
Lesson 6.4 The effect of pH on the rate of enzyme reactions
nutrient
any substance used as food by an organism Learning intentions and success criteria non-essential nutrient
a nutrient that can be synthesised by an organism
essential nutrient a nutrient that must be ingested and absorbed because it cannot be synthesised by the organism
heterotroph literally, “otherfeeder”; an organism that derives its energy by consuming other living organisms
digestion the process of physically and chemically breaking down food into smaller, usable substances that can be absorbed into the bloodstream
alimentary canal
a continuous tubular pathway of the digestive system by which food enters the body via the mouth and unused materials are expelled through the anus
mouth
the opening of the anterior region of the alimentary canal, through which food is ingested
anus the end of the alimentary canal, through which faeces (undigested food) are egested
ingestion consumption of materials by an organism
→ A nutrient is a substance that an organism uses for maintenance, growth or repair.
→ Heterotrophs acquire nutrients by ingesting food and digesting the nutrients from food.
→ Physical digestion is the breaking down of food into smaller units by the crushing or cutting action of the mouth and other body parts.
→ Chemical digestion is the process in which food is broken down by digestive enzymes.
A nutrient is any substance used by an organism for maintenance, growth, repair or reproduction. There are two broad categories of nutrients.
• Non-essential nutrients can be synthesised by the organism from basic materials.
• Essential nutrients cannot be synthesised by the organism and therefore must come from an outside source.
All animals are heterotrophs, meaning they are unable to synthesise organic compounds from inorganic matter and must obtain nutrients by consuming other organisms as food. The process in which this food is broken down into nutrients that an organism can use is called digestion

Most animals have an alimentary canal , a muscular tube that runs through the centre of the animal and has two openings to the outside. Food enters by one opening, the mouth, and is processed as it passes through the canal. Nutrients released by digestive actions are transported from the alimentary canal to body cells via the circulatory system. Any material that is not processed is expelled out of the organism through the other opening, the anus. Matter in the alimentary canal flows in one direction. Once food has entered via the mouth (ingestion), it flows through to the anus, where it can be removed (egestion). Absorption of nutrients from food that enters the body is made possible by two processes: physical digestion and chemical digestion.
Physical digestion is the breaking down of food into smaller units by the crushing or cutting actions of the mouth and other body parts. Organisms that digest large pieces of food must have a means of breaking down the food into molecules small enough to pass across cell membranes. A variety of structures that aid in obtaining food and breaking it down have evolved for this purpose. For example, teeth, tentacles, claws and other appendages have evolved to aid in collecting food to enter via the mouth. Special structures, such as the rasp-like tongue of the snail and the teeth and tongues of vertebrates, help to physically break down food in the mouth into smaller pieces.
Once food has been ingested, muscular contractions move the food mass through the system as well as physically breaking and churning it. Most animals have a body cavity, which separates the alimentary canal from the body wall. The body can be thought of as consisting of two tubes, one inside the other. The outer tube, which is in contact with the external environment, protects the inner organs and provides a framework for support and movement. The outer tube is connected to the inner tube only at the two openings to the external environment: the mouth and the anus. For the rest of its length, the outer tube is separated from the inner tube by a space in which many organs lie, such as the heart, liver, lungs and kidneys. The inner tube, the alimentary canal, can act independently of the outer tube because it has its own muscular system. This arrangement is shown in Figure 3.


2 The teeth and mouth aid in physically breaking down food during ingestion.
Outer body tube: muscular and skeletal support; protection
Inner body tube: muscular alimentary canal
Body cavity: contains organs
3 In animals with a true body cavity, the body can be thought of as comprising two tubes, one inside the other.
The movement of the muscles of the alimentary canal play a major role in physical digestion. Two muscle layers line the alimentary canal. One layer, the circular muscle, travels in rings around the circumference. When these muscles contract, the internal diameter of the tube becomes smaller. The second layer, the longitudinal muscle, is oriented along the entire length of the tube. When this muscle layer contracts, the tube becomes shorter.
physical digestion the breaking down of food into small units by the crushing or cutting actions of mouthparts (in invertebrates), teeth, muscles and so on.
peristalsis
waves of contraction and relaxation in the muscular walls of the alimentary canal, aiding in mechanical digestion and moving food along its length
Waves of contraction and relaxation of these muscle layers move the food through the canal, in a process called peristalsis. The muscles just in front of the food relax, providing an enlarged area into which the food can pass. The muscles just behind the food contract and push the food forward. As the food moves, the muscles behind it then contract, so a region of contraction follows the food and constantly pushes it forward (Figure 4). Food
chemical digestion the hydrolysis of complex organic molecules into smaller units that are small enough to pass through cell membranes; mediated by enzymes specific to each chemical
amylase an enzyme that stimulates the conversion of polysaccharides to disaccharides
protease the general term for an enzyme involved in the hydrolysis of proteins
lipase the general term for an enzyme involved in the hydrolysis of lipids
FIGURE 4 Peristalsis moves food along the alimentary canal.
The separation of the alimentary canal from the body wall has allowed the development of specialisation of parts of this canal for different functions. Some parts of the gut have developed into storage areas, others relate to digestion, absorption and elimination. Bile, a substance made in the liver and released from the gall bladder, is an emulsifier (a mixture of chemical substances that act like a detergent) that physically breaks down large fat particles in the small intestine into small droplets. Within the alimentary canal, solid food is subjected to a variety of actions that convert it into smaller, soluble compounds. As the pieces of food become smaller, their ratio of surface area to volume increases. This gives a greater surface area for the enzymes to attach to during chemical digestion of the food. Physically breaking up the food makes digestion more efficient.
Chemical digestion is the process in which food is broken down by digestive enzymes. These enzymes facilitate the decomposition of large organic molecules, by speeding up hydrolysis reactions that help break down the chemical bonds holding molecules together. Chemical digestion breaks down complex carbohydrates into saccharides (such as glucose), proteins into amino acids, and lipids into fatty acids and glycerol.
As enzymes are highly specific to the substrates they can bind, different enzymes mediate the chemical digestion of different macromolecules. Three types of digestive enzyme play an important role in chemical digestion.
• Amylase breaks down complex carbohydrates such as starch (in foods such as pasta and potato) into simpler sugar molecules, such as disaccharides. Amylase is secreted by salivary glands and the pancreas, and is present in saliva and pancreatic juice.
• Protease breaks down proteins into smaller molecules, such as peptides or their amino acid monomers. Proteases are secreted by the pancreas and are in pancreatic juice.
• Lipase breaks down lipids by catalysing the hydrolysis of larger fat molecules into their smaller fatty acid and glycerol monomers. Lipases are secreted by the pancreas and are in pancreatic juice.



Enzyme activity can be regulated by factors such pH, and therefore certain enzymes are found in different parts of the digestive system. For example, the enzyme pepsin, a type of protease, thrives in the acidic conditions of the stomach because its optimal pH is 1 to 2, whereas salivary amylase functions better in the more neutral pH within the mouth. After food molecules have been chemically digested into usable nutrients, they are ready to be absorbed by the body.
If the name of a molecule has “-ase” at the end, it is probably an enzyme. The rest of the name is often a hint of its function. For example, proteases digest protein, and lipases digest lipids.
Most nutrient molecules produced by digestion are small enough to pass through cell membranes by simple diffusion. Other molecules, such as glucose, require facilitated diffusion. Active transport is used if a substance must be absorbed against a concentration gradient. In larger animals, these nutrient molecules generally pass from the alimentary canal to a circulatory system, which transports them to the appropriate cells.
Once in the cells, digested nutrients are assimilated. The monomers are built up into complex compounds required by the body, converted into other forms as storage products for later use, or broken down for energy release during cellular respiration.
Egestion is the process of removing food that was never part of the organism. Any undigested food is eliminated from the gut as faeces in the process of egestion. This is different from excretion, which is the removal of the waste products of the chemical reactions in a cell.
Large complex insoluble organic molecules of food
Mouthparts (physical and chemical digestion)
Hydrolysing enzymes (chemical digestion)
Peristalsis (physical digestion)
Movement of food
Small simple molecules absorbed
Used in metabolism (respiration and production of complex organic molecules)
Water absorbed
Egestion of faeces (undigested food)
Ingestion
Digestion
Absorption
faeces a compacted, undigested food mass that is voided from an animal excretion the removal of metabolic wastes from the body
Assimilation
FIGURE 6 Stages in acquiring nutriets
Check Your Learning 6.1: Complete these questions online or in your workbook.
Retrieval and comprehension
1 Identify one physical structure in humans that aids physical digestion. (1 mark)
2 Describe the role of each of the following in chemical digestion: (3 marks)
a amylase
b protease
5 Summarise the movement of food through the alimentary canal, from ingestion to egestion. (5 marks) Check your learning 6.1
c lipase.
3 Describe the role of physical digestion in the digestive system, providing examples of the organs or structures involved. (4 marks)
4 Describe the concept of enzyme specificity, using an example to support your response. (2 marks)
Learning intentions and success criteria
chunk feeder
an animal that ingests large pieces of food digestive system the body system involved in physically and chemically breaking down food into smaller molecules able to pass into the bloodstream
Key ideas
→ The human digestive system is made up of an alimentary canal and associated organs that help to break food down physically and chemically.
→ The human digestive system functions so that the body can obtain nutrients and remove waste.
Humans feed on large chunks of solid organic material derived from plant and animal organisms. Like other chunk feeders, they must be able to:
• obtain and ingest food
• physically and chemically digest the food
• absorb the digested molecules and transport them to the cells for assimilation
• egest undigested food.
These tasks are facilitated by the human digestive system
The human digestive system consists of an alimentary canal and associated organs. Throughout the length of the alimentary canal, each part is modified for a specific function. Other organs, such as the liver and pancreas, are linked for its support and function. The overall structure of the digestive system (Figure 1), and the functions performed at each specialised part, are summarised here.
• Mouth, tongue and teeth – in the mouth, food is digested physically and chemically. Biting, chewing and grinding by teeth increase the surface area of the food for the action of digestive enzymes. The tongue mixes food with saliva and forms it into a ball, called a bolus.
• Palate – this structure separates the mouth and nose, which allows a person to eat and breath at the same time.
• Salivary glands – secrete saliva into the mouth. Saliva contains amylase, which breaks down complex carbohydrates into smaller disaccharides.
• Oesophagus – food passes along this muscular tube to the stomach.
• Stomach – a J-shaped sac in which some of the proteins in food are chemically digested by proteases activated by hydrochloric acid. Food is also broken down into fine particles by contractions of the muscles of the stomach walls. This increases the surface area of the food for contact with digestive enzymes in the intestine.
• Liver – makes bile, which is used to digest fat and neutralise stomach acid.
• Gall bladder – stores bile until the food reaches the small intestine, then releases the bile into the small intestine via a small tube called the bile duct.
• Pancreas – produces pancreatic juice, which contains a mixture of digestive enzymes (e.g. proteases and amylase) and can help neutralise stomach acid.
• Small intestine – absorbs nutrients from food that has flowed on from the stomach. It consists of the duodenum (the first part of the small intestine) and receives secretions from the gall bladder and pancreas. The small intestine also produces its own digestive enzymes from the glands in the walls of the intestine. As food passes through the small intestine, it breaks down into molecules small enough to pass through the intestinal walls into the blood.
• Ileum – the coiled long section of the small intestine. It follows on from the duodenum. Digested food molecules are absorbed across the walls into blood capillaries. The walls of

duodenum first section of the small intestine; receives partially digested materials from the stomach
ileum the last and largest section of the small intestine
the ileum have projections, called villi, which increases the surface area available to absorb food.
• Large intestine – also known as the colon; absorbs water from undigested food that passes from the small intestine. Most of the undigested food is fibre, which consists mostly of cellulose from plant cell walls. Fibre in the diet is necessary as it helps waste products to retain some water and move through the large intestine faster.
• Rectum and anus – the rectum stores waste products of digestion (faeces), which are passed out through the anus.
In the abdominal region, there are thin membranes with blood and lymph vessels running through them, connecting the alimentary canal to the body wall. The mesentery membranes also hold the loops of the alimentary canal in the correct position.
The inner layer of the human alimentary tract differs along its length, reflecting its function at any point. However, the general structure is the same and consists of four basic layers.
• The outer layer is connective tissue and is continuous with the thin supporting membrane (mesentery).
• Inside the connective tissue is an external muscle layer, usually consisting of an outer layer of longitudinally oriented cells and an inner circular layer. These are smooth (involuntary) muscle cells. The muscles are not consciously controlled and are responsible for peristalsis.
• The third layer contains the major blood and lymphatic vessels, nerves and stretch receptors, connected by strong fibres of connective tissue.
• The innermost layer consists of more smooth muscle fibres and loose connective tissue that supports the lining or epithelium. All glands of the alimentary tract are derived from this epithelium.
The chemical digestion of each food type is controlled by specific enzymes, each of which works at an optimal pH. If the acid levels surrounding the enzyme are too high or too low, the enzyme becomes deformed and unable to catalyse the digestion reaction. Different parts of the alimentary canal therefore have closely controlled pH levels.
Chemical digestion of complex carbohydrates begins in the mouth, where the pH is about 7.5 (slightly basic/alkaline). The salivary glands secrete a juice containing mucus and the enzyme salivary amylase. The mucus moistens the food, and the salivary amylase starts the digestion of starch to a disaccharide (maltose).
When the food reaches the stomach, gastric juice is secreted by glands in the stomach wall. This very acidic solution (pH 2) immediately stops the action of salivary amylase. Gastric juice contains the protein-digesting enzyme called pepsin (a protease), which breaks complex proteins into smaller polypeptide chains and dipeptides. Pepsin is produced by the stomach gland cells in an inactive form; it only becomes active when mixed with the stomach contents. Other proteases are also released. Some glands in the lining secrete mucus, which protects the stomach wall from being digested. If this protective mucus is not produced in sufficient amounts, the stomach walls may become damaged by the acid and ulcers may form.
In the first part of the small intestine (the duodenum), secretions from the liver (via the gall bladder) and the pancreas are introduced through the bile and pancreatic ducts to the acidic food mass that leaves the stomach. Bile (pH 7 to 8) contains waste materials from metabolism and the breaking down of old red blood cells by the liver. One of these products (bile salts) physically breaks up (emulsifies) lipids into small droplets. This increases
the surface area available for lipases to act on during chemical digestion. Pancreatic juice (pH 7 to 8.8) contains amylases, proteases and lipases, which chemically digest complex carbohydrates, proteins and lipids, respectively. The pH of both secretions neutralises the stomach acid to provide optimal pH for the pancreatic enzymes to act.
Other secretions from glands in the walls of the small intestine (intestinal juice, pH 7.5 to 8.5) provide further proteases and lipases to complete the chemical digestion of polymers into monomers that can be absorbed. Mucus is also secreted, to protect the cells lining the small intestine.
Lumen
Connective tissue
Circular muscle
Inner epithelial layer
Oesophagus Longitudinal layer
Longitudinal muscle
Connective tissue
Science inquiry skill: Evaluating claims
Enzymes are proteins that act as catalysts in biochemical reactions, speeding up the conversion of substrates into products. Metabolism involves a complex network of enzymatic reactions that regulate the synthesis and breaking down of molecules essential for the proper functioning of cells and organisms. Deficiencies in specific enzymes can result in metabolic diseases. In cases where a metabolic disease is caused by a deficiency of a specific enzyme, enzyme replacement therapy (ERT) can be employed. Enzyme replacement therapy involves administering the missing or defective enzyme, to restore normal metabolic function. It is used in therapy for Gaucher disease, a rare disease where an enzyme that assists in breaking down lipids is missing.
Lesser curvature
Oesophageal sphincter
Circular layer
Oblique layer
Greater curvature
1 “Enzyme replacement therapy (ERT) has the potential to significantly enhance the quality of life of individuals with metabolic disorders.”
Research the above claim to determine:
a the cause of Gaucher disease in affected individuals
b a current ERT used in the treatment of Gaucher disease
c how ERT improves outcomes for patients with Gaucher disease.
2 Propose a possible research question to investigate the claim in Question 1.
Need help researching claims? Go to Lesson 1.X in your Biology toolkit.
villus
a finger-like projection of the lining of the small intestine; increases the surface area available for absorption; plural “villi” microvillus a projection from the surface of cells; forms a brush border that increases the surface area of the cell membrane; plural “microvilli”
hepatic portal vein
the vein that transports absorbed food molecules directly from the small intestine to the liver
Absorption of nutrients involves osmosis, diffusion and active transport. Diffusion of the nutrients depends on a concentration gradient and the length of the diffusion pathway. For this reason, there is a large capillary network immediately below the lining cells of the intestinal cavity, to remove the diffused nutrients. This maintains the steep concentration gradient necessary for effective diffusion.
Some absorption of water and glucose occurs across the lining of the stomach wall into the underlying capillaries. Most absorption of the small molecules resulting from chemical digestion occurs in the very long, coiled, second part of the small intestine, the ileum. The inner surface of the ileum has folds from which small finger-like villi project. These folds help to slow down the passage of food, and the villi increase the surface area for digestion and absorption. By contraction and swaying, the villi also circulate the contents.
chylomicron
small droplets of lipids, glycerol and fatty acids enclosed in a protein coat; involved in the absorption of products of fat digestion in the alimentary canal directly into the lymphatic system
The surface area is further increased in this area by hair-like extensions of the epithelial cells of the villi, called microvilli. As absorption proceeds, there is a rapid build-up of nutrients in epithelial cells. Monosaccharides, nucleotides and amino acids are removed from these cells into the bloodstream by the capillaries of the villi. Transport away from the cells is not always rapid enough and a concentration barrier may build up. It is only by active transport across the cell membranes that this can be overcome.
GLUCOSE AND galactose are absorbed more rapidly than the other monosaccharides. This is possibly because they undergo a chemical conversion when they first enter the epithelial cells, ensuring the maintenance of a steep concentration gradient. These sugars then pass by diffusion into the capillaries that drain into the hepatic portal vein. This blood vessel acts as a short circuit, carrying the absorbed food molecules directly to the liver.
Small droplets of lipids, and their subunits, glycerol and fatty acids, are absorbed into the epithelial cells of the villi. There they are assembled into fatstorage molecules (triglycerides), phospholipids and cholesterol (part of cell membranes) and packaged in a protein coat by the cells’ Golgi bodies into structures called chylomicrons. They are released into the tissue fluid and taken up by lacteals (of the lymphatic system) in the villi. The lacteals lead to lymphatic vessels, which enter the blood supply just before its return to the heart. Small amounts of fatty acids and glycerol may also enter the capillaries of the villi.
Epithelial cells lining the small intestine –chylomicrons are formed.
Triglycerides, phospholipids and cholesterol
FIGURE 5 Transport of fat storage molecules via chylomicrons
Chylomicrons move into lacteals.
Vein
Absorption of vitamins, inorganic salts and water also occurs in the small intestine. Water absorption takes place by osmosis, as the gut contents develop a lower solute concentration (i.e. become hypotonic) compared to the blood.
The main function of the large intestine is the absorption of water. About 7 L of water enters the alimentary canal each day as a solvent for the digestive juices. Although most of this is reclaimed by absorption in the small intestine, the remainder must be removed in the colon, the largest part of the large intestine. This results in the compaction of solid, insoluble undigested material, known as faeces. If the lining of the colon is irritated – for example, by an infection – the undigested material moves too quickly, less water than normal is reabsorbed, and diarrhoea results. If the material passes through the colon too slowly, an excess of water is removed. The result is a faecal blockage, called constipation.
In addition to the waste materials secreted in the bile from the liver, excess mineral salts may be secreted into the colon of the large intestine from blood vessels in its walls.
Normally there is a large bacterial community in the large intestine. These bacteria obtain their nourishment from undigested food. In return for this continual supply of nutrients, they release byproducts of their metabolism, vitamin K and several of the B group vitamins. These vitamins are absorbed through the large intestinal epithelium. This is virtually the body’s only source of vitamin K, which is essential in blood-clotting reactions in humans. Therefore, there is a mutualistic relationship (where both organisms benefit) between these bacteria and the human organism harbouring them.
Assimilation is the incorporation of nutrients into the body. These chemicals are carried from the intestine to the liver by the hepatic portal vein. In the liver they are stored, changed or redirected to other organs.
Amino acids are needed for growth, maintenance, repair and secretion, but they cannot be stored within cells. Excess amino acids taken into the body must be changed in one of three ways:
• conversion to urea for removal by the kidneys
• transfer of amino groups to carbohydrates to produce glycoproteins, which are needed by the body
• conversion to glucose and other carbohydrates.
The term “lipids” includes all fats and oils. At room temperature, fats are solid and oils are liquid. assimilation the incorporation of simple organic molecules, or products of digestion, into complex constituents of the organism
Ethyl alcohol (“ethanol”), the active component of alcoholic beverages, is a small molecule that is readily absorbed by the stomach and small intestine. The rate at which this molecule is absorbed is increased if there is no food present, particularly fats and proteins. Absorption is also increased if the alcohol is mixed with carbonated fluid. Carbon dioxide stimulates movement of alcohol through the stomach, passing it rapidly to the intestine, where the absorption rate is higher. In this way alcohol is rapidly absorbed into the bloodstream. The blood distributes the alcohol to the body tissues, where it is slowly absorbed. Alcohol may therefore be present in the blood up to 18 hours after it was ingested.
As alcohol concentration in the blood rises to between 0.05% and 0.1%, areas of the brain that control judgement, self-criticism and learnt inhibitions do not operate effectively. Between 0.1% and 0.3%, depression of brain activity causes the person to be less alert, have a hazy awareness of their surroundings, lose coordination and become sleepy. At blood alcohol levels greater than 0.3%, brain function becomes significantly impaired. This may lead to respiratory failure and/or shock associated with low blood pressure. At blood alcohol levels of approximately 0.5%, coma and death usually result. For alcoholics (people who have an addiction to alcohol), alcohol assumes the characteristics of food. The body cells become so adapted to alcohol that they operate poorly in its absence. Continued excessive drinking causes inflammation of the stomach lining and poor digestion of food. Nausea makes food unpalatable. These factors result in loss of essential nutrients. Nerves, particularly in the legs, begin to degenerate and the excessive drinker experiences pain and weakness. Liver degeneration, caused by a number of changes to the cells, collectively termed cirrhosis, usually results in death.

Apply your understanding
1 Identify how alcoholism affects the body's cells and their adaptation to alcohol.
2 Describe the impact of continued excessive drinking on the stomach lining and digestion of food.
Check Your Learning 6.2: Complete these questions online or in your workbook.
Retrieval and comprehension
1 E xplain why protein-digesting enzymes are produced and secreted in an inactive form in the stomach. (3 marks)
2 Describe features of the small intestine that make it an efficient organ for the absorption of digested food. (4 marks)
3 Describe the digestion and absorption of fats in humans. (2 marks)
4 Explain how the structural features of villi assist in the absorption of nutrients into the bloodstream. (5 marks)
Analytical processes
5 Read the following passage carefully and apply your knowledge to answer the questions.
Peristaltic contractions of the stomach keep the partly digested food moving towards the duodenum, the first loop of the small intestine. The duodenum is the main site of digestion in the gut. The agents of digestion come from three sources: the liver, the pancreas and the wall of the intestine. The liver produces bile, a mixture of substances. Not all of these substances are involved in digestion. The digestive components are bile salts, which emulsify fats. Bile salts are not enzymes. Bile is also rich in sodium bicarbonate, which neutralises acid from the stomach. The pH of the small intestine is therefore distinctly basic (alkaline), which favours the action of the various enzymes. Some of these enzymes are constituents of the pancreatic juice that flows into the duodenum from the pancreas via the pancreatic duct. The main enzymes flowing into the small intestine are amylases, proteases and lipases.
a Describe peristaltic contractions and what causes them. (2 marks)
b Define the term “emulsify”. (1 mark)
c Explain why bile salts are not classed as enzymes. (2 marks)
d Deduce why the stomach contents are acidic. (1 mark)
e Determine the function of each of the enzymes in the small intestine. (3 marks)
This lesson is available exclusively on Oxford Digital.
Learning intentions and success criteria
This lesson is available exclusively on Oxford Digital.
Learning intentions and success criteria
excretion the removal of metabolic wastes from the body osmoregulation the physiological regulation of water and salt concentrations in the body
ureter
a duct that leads from the kidney to the bladder
bladder a storage organ for urine in vertebrate animals
urine
the excretory fluid produced in the kidney; contains metabolic wastes (urea, salts) in a watery solution
urethra a tube running from the bladder to the body’s exterior; in human females, it eliminates urine; in human males, it is joined by the vas deferens, so it eliminates semen as well as urine
→ The excretory system removes wastes from the body.
→ Major organs involved in the excretory system are the kidneys, ureters, bladder and urethra.
All organisms produce wastes. Because a build-up of wastes in an organism can be toxic, organisms need to have processes or systems in place to remove wastes from the body. In mammals, wastes are removed from the body by excretion. The main function of the excretory system is to allow the body to remove wastes in the form of urine (waste materials dissolved in water) and sweat. It is also important in facilitating osmoregulation (maintaining a balance of water and salt in the body), which you will learn more about in Module 11.
The main organs in the excretory system are:
• kidneys – filter blood and produce urine
• ureters – a pair of ducts that move urine from the kidneys to the bladder
• bladder – a membranous sac that stores urine
• urethra – a duct the transports urine from the bladder to outside the body.
FIGURE 1 Mammals expel urine via the excretory system to remove wastes from the body.

















FIGURE 2 The human excretory system
In humans, proteins are broken down into a nitrogenous compound called ammonia in nearly all tissues of the body, and is transported in the blood to the liver. Because ammonia is toxic, the liver converts ammonia to urea , a less harmful compound. Because urea is less toxic than ammonia, it can be retained in the body for a limited period before being removed as a waste substance via the excretory system. In the mammalian excretory system, the separation of excretory substances from blood and the conservation of water occur in a pair of kidneys. Urine passes from the kidneys through the ureters to be stored in the bladder. The urine eventually passes to the external environment through the urethra.
The kidney is the main organ of the excretory system. A kidney is located on each side of the vertebral column in the abdominal cavity, between the lowest rib and the top of the hip bone. The kidneys remove excretory products from the blood plasma and produce urine. As shown in Figure 3, each kidney is bean-shaped. It is enclosed by a capsule of connective tissue and composed of two layers of tissue: an outer, darker-coloured cortex and an inner, lightercoloured medulla , surrounding a central cavity.
ammonia an inorganic nitrogen compound; in animals, a toxic product of the breaking down of excess amino acids
urea a water-soluble nitrogenous excretory product of protein breakdown cortex the outer part of a vertebrate kidney; contains the Bowman’s capsule, glomerulus and convoluted tubules of the nephron medulla the inner layer of a vertebrate kidney; contains loops of Henle and collecting tubules
renal artery
the blood vessel entering the kidney
renal vein the blood vessel leaving the kidney
renal pelvis
a funnel-shaped expanded area where the ureter leaves the kidney
pyramid the bundle of collecting ducts in the mammalian kidney
nephron
the functional unit of the vertebrate kidney
The kidney medulla is in the middle of the kidney. The cortex is just under the capsule of the kidney.
glomerulus
a capillary knot in the Bowman’s capsule through which ultrafiltration of blood (plasma minus protein) into the nephron of the mammalian kidney occurs
Bowman’s capsule the area of the mammalian kidney nephron in which ultrafiltration of the blood occurs
collecting duct
a duct into which waste materials from each nephron in the kidney drain
Renal artery
Renal vein
Typical position of a kidney tubule (nephron)
Collecting ducts
Cortex

Flow of urine

Ureter
FIGURE 3 The structure of a kidney
Medulla
Fibrous capsule
Pelvis of ureter
Kidney pyramids
The kidneys are connected to the circulatory system via the renal arteries, which carry blood to the kidneys, and the renal veins, which return the ‘cleaned blood’ to the heart and to the bladder via the ureters. Within the central cavity of the kidney, the top of the ureter expands to form the renal pelvis. The inner medulla of the kidney is divided into lobes of approximately conical shape, called pyramids. The renal artery forms branches between the pyramids that deliver blood to the outer cortical region containing nephrons. These are drained by branches of the renal vein.
The nephron is the functional unit of the kidney. Each kidney contains approximately one to two million nephrons embedded in loose connective tissue that is richly supplied with blood. Each nephron consists of an elongated tubule with many distinct sections. Figure 3 shows the key sections of the nephron, which include the:
• glomerulus – a network of capillaries
• Bowman’s capsule – a cup-shaped section that wraps around the glomerulus
• proximal convoluted tubule – a highly coiled section of tubule next to the Bowman’s capsule
• loop of Henle – a U-shaped stretch of tubule
• distal convoluted tubule – a section of coiled tubule that runs on from the loop of Henle
• collecting duct – an extension of the tubule that drains urine into the pelvis so it can be removed via the ureter.
Only the loop of Henle and the collecting duct are located in the medulla. The rest of the nephron is contained within the cortex of the kidney.
Branch of renal artery
Branch of renal vein A erent arteriole E erent arteriole
Pressure filtration
Bowman’s capsule
Glomerulus
Proximal convoluted tubule
Flow of filtrate
Blood flow
Loop of Henle
Descending limb
Ascending limb
Blood capillary network
a nephron
Distal convoluted tubule
Collecting duct
Urine passes to tip of kidney pyramid
In the nephron and its structures, three main processes help form urine and allow wastes to be removed from the body: 1 glomerular filtration 2 selective reabsorption 3 secretion.
Glomerular filtration
The first step in urine production is glomerular filtration. Blood enters the capillaries of the glomerulus under high pressure from the afferent arteriole, a branch of the renal artery. Water, ions and small molecules such as glucose, amino acids and urea are forced through the capillary walls into the Bowman’s capsule. This filtered fluid in the Bowman’s capsule is called filtrate and is similar to plasma in composition but without the larger protein molecules. Blood cells normally do not leave the blood vessels because they are too large to cross the cell wall.
The second step in the formation of urine for removal of wastes is selective reabsorption. As filtrate leaves the Bowman’s capsule, it passes into the proximal convoluted tubule, where many useful substances are reabsorbed into the surrounding capillaries. The proximal convoluted tubule is the site where most water reabsorption in the nephron takes place. The afferent arteriole the arteriole leading into a structure, e.g. the glomerulus of the kidney filtrate the fluid that is left after water, ions and small molecules have been filtered out of the blood into the glomerulus of the kidney
proximal convoluted tubule the tubule of the kidney nephron arising from the Bowman’s capsule and leading to the loop of Henle; responsible for the reabsorption of glucose, sodium chloride and water loop of Henle an area between the proximal and distal convoluted tubules of the nephron in the mammalian kidney; a counter-current multiplier whereby high salt concentration in the tissue fluid is maintained, resulting in diffusion of water from the filtrate to the surrounding blood capillaries
cells lining the inside of the tubule have microvilli to increase surface area for absorption and are heavily loaded with mitochondria for energy production. Glucose and amino acids are absorbed via active transport into the cells that line the proximal convoluted tubule. Sodium ions are also absorbed via active transport in the proximal tubule. This creates an osmotic gradient that results in the passive diffusion of the negative chloride ions.
Filtrate continues to move through to the loop of Henle, where reabsorption of water and salts takes place. In the loop of Henle, the walls lining the descending limb are permeable to water but impermeable to sodium chloride and urea. As filtrate passes through the descending limb, water diffuses out of the loop and the concentration of salt and urea in the filtrate increases towards the base of the loop. The lining of the ascending limb is impermeable to water and urea but permeable to sodium ions. This means that, as filtrate moves up the ascending limb, the body reabsorbs any useful salts into the surrounding tissue fluid in the medulla.
At any given level of the loop, the concentration of sodium in the descending limb is slightly above that in the ascending limb. Because the salt concentration in the descending limb is always just below that of the fluid surrounding it, it facilitates the passive removal of water. This also maintains a large concentration gradient along the whole depth of the loop. This concentrating effect is multiplied along the length of the loop from top to bottom, so that the longer the loop, the greater the concentration that can be reached, enabling mammals to reabsorb very large quantities of water from the filtrate and resulting in urine that is hypertonic to blood.
Secretion is the movement of waste products from cells of the tubule walls into the filtrate. It occurs when substances such as ammonium, potassium, hydrogen ions, dyes and drugs get secreted into the convoluted tubule during reabsorption. As these substances are added to the filtrate, the filtrate continues to become more concentrated. Eventually the filtrate is moved to the collecting duct, so it can be either stored or passed as urine.
1. Filtration
2. Reabsoption
3. Secretion
Excretion
FIGURE 5 Urine formation involves filtration, reabsorption and secretion
distal convoluted tubule the part of the nephron that joins the loop of Henle to the collecting duct; responsible for the reabsorption of sodium, potassium, phosphate and calcium ions under the control of hormones
Antidiuretic hormone (ADH) is a chemical that, when released, influences the kidney’s ability to reabsorb water. Specifically, when released, ADH acts on a nephron’s distal convoluted tubule and collecting duct to making both sections of tubule more permeable to water.
1 Use your understanding of the nephron and the effect that ADH has on sections of the nephron to determine whether ADH would be released during times of dehydration or when the body is overhydrated. (2 marks)
Diabetes is a medical condition that can occur in two forms: diabetes mellitus and diabetes insipidus. Diabetes mellitus results from an inability to control blood sugar levels. Normally the pancreas secretes the hormone insulin, which converts excess blood glucose to glycogen for storage. A person’s pancreas may not be able to produce enough insulin (Type 1 diabetes) or their cells may develop insulin resistance (Type 2 diabetes). In both cases, there is an excess of glucose in the blood. The proximal convoluted tubule of the nephron can remove only a limited amount of glucose from the glomerular filtrate. When this threshold is reached, the glucose is excreted in the urine. This affects the ability of the nephron to reabsorb water.
Diabetes insipidus is another form of diabetes. It results from either an inability to produce ADH or the kidneys being unable to respond to ADH. This results in the body releasing large amounts of dilute urine.
Both diabetes mellitus and diabetes insipidus result in symptoms including excessive urination, dehydration of the body and extreme thirst. Diabetic nephropathy is a complication of diabetes that affects the kidneys. It is a progressive kidney disease that develops over time because of prolonged high blood sugar levels, a common feature of diabetes. Diabetic nephropathy can affect people with Type 1 or Type 2 diabetes mellitus and is a leading cause of chronic kidney disease and end-stage renal disease, ultimately requiring dialysis or kidney transplantation.
APPLY YOUR UNDERSTANDING
1 Differentiate between diabetes mellitus (Type 1) and diabetes mellitus (Type 2). (2 marks)
2 Identify the common symptoms shared by diabetes mellitus and diabetes insipidus, including the relationship between excessive urination, dehydration and extreme thirst. (2 marks)
3 Describe how diabetic nephropathy affects people with diabetes. (2 marks)
Che
ck Your Learning 6.5: Complete these questions online or in your workbook.
Retrieval and comprehension
1 Describe the role of the excretory system in animals. (1 mark)
2 Identify the organs of the human excretory system. (4 marks)
3 For each of the following parts of the nephron, identify its function in the production of urine.
a glomerulus (1 mark)
b Bowman’s capsule (1 mark)
c proximal convoluted tubule (1 mark)
d loop of Henle (1 mark)
e distal convoluted tubule (1 mark)
f collecting duct (1 mark)
4 Summarise the movement of glomerular filtrate through the nephron. (5 marks)
5 E xplain how selective reabsorption and secretion across nephron membranes assists the removal of wastes in urine. In your answer, provide examples of substances that are secreted in this process. (6 marks)
6 E xplain how the urinary system works in coordination with the circulatory system to regulate waste elimination. (4 marks)
• A nutrient is a substance that an organism uses for maintenance, growth or repair.
• Heterotrophs acquire nutrients by ingesting food and digesting the nutrients from food.
• Physical digestion is the breaking down of food into smaller units by the crushing or cutting actions of the mouth and other body parts.
• Chemical digestion is the process in which food is broken down by digestive enzymes.
• The human digestive system is made up of an alimentary canal and associated organs that help to break food down physically and chemically.
• The human digestive system functions so that the body can obtain nutrients and remove waste.
• Practical: The effect of temperature on the rate of reactions of an enzyme.
• Practical: The effect of pH on the rate of enzyme reaction.
• The excretory system removes wastes from the body.
• Major organs of the excretory system are the kidneys, ureters, bladder and urethra.
Review questions: Complete these questions online or in your workbook.
1 In mammals, the structure that takes urine from the bladder to the exterior is the
A urethra.
B ureter.
C uriniferous tubule.
D anus.
2 The Bowman’s capsule is located in the region of the kidney called the
A pelvis.
C cortex.
B pyramid.
D medulla.
3 Which is the best description of digestion?
A Digestion is the action of enzymes on food in the digestive tract.
B Digestion is the breaking down of complex organic molecules into small molecules that can be used by the body.
C Digestion is the dissolving of food and its absorption into the blood.
D Digestion is the breaking up of food into soluble molecules that can diffuse through cell membranes.
4 Which one of the following does NOT aid the transfer of certain substances from the bloodstream to the tubules of the mammalian kidney?
A the large surface area of the capillaries of the glomerulus
B the relatively small sizes of the molecules (or ions) of these substances
C the larger diameter of the arteriole leaving Bowman’s capsule compared with the diameter of the arteriole entering the capsule
D the relatively great length of each of the tubules
5 Most of the nutrient absorption that takes place in the digestive system occurs in the
A stomach.
B oesophagus
C small intestine.
D large intestine.
6 Which of the following types of enzyme is responsible for breaking down proteins in the stomach?
A amylase
B lipase
C protease
D lactase
7 The primary waste product excreted by the kidneys is
A urea.
B carbon dioxide.
C ammonia.
D lactic acid.
0 8 In which system does peristalsis occur?
A digestive system
B nervous system
C circulatory system
D respiratory system
9 The role of amylase in the body is to catalyse the breaking down of
A protein.
B carbohydrates. C lipids.
D nucleic acids.
10 Which is the correct order of travel through the alimentary canal?
A mouth → oesophagus → stomach → caecum
→ ileum → duodenum → large intestine
→ rectum
B mouth → oesophagus → stomach → ileum
→ duodenum → large intestine → caecum
→ rectum
C mouth → oesophagus → stomach → duodenum
→ ileum → large intestine → caecum → rectum
D mouth → oesophagus → stomach → duodenum
→ ileum → caecum → large intestine → rectum
11 Identify the graph that correctly represents the changes in pH as food travels from the mouth to the duodenum.
12 In the nephron, most water reabsorption occurs in the
A glomerulus.
B Bowman’s capsule.
C loop of Henle.
D proximal convoluted tubule.
13 The primary function of the glomerulus is
A reabsorption of water.
B filtration of blood.
C secretion of waste products.
D concentration of urine.
14 The primary function of microvilli is to
A increase surface area.
B increase removal of waste.
C protect internal capillaries.
D decrease nutrient absorption.
15 Which is the correct order of travel of glomerular filtrate, starting from the Bowman’s capsule?
A proximal convoluted tubule → descending limb → ascending limp → distal convoluted tubule → collecting duct
B proximal convoluted tubule → ascending limp → descending limb → distal convoluted tubule → collecting duct
C distal convoluted tubule → descending limb → ascending limp → proximal convoluted tubule → collecting duct
D distal convoluted tubule → ascending limp → descending limb → proximal convoluted tubule → collecting duct
Review questions: Complete these questions online or in your workbook.
16 Describe the process of nutrient absorption in the small intestine, including the role of villi. (3 marks)
17 E xplain how the structure of villi assists with efficient nutrient absorption. (4 marks)
18 Describe the function of the loop of Henle in the nephron and its contribution to urine concentration. (4 marks)
19 Describe the role of lipase in chemical digestion. (2 marks)
20 E xplain how nephron structure contributes to the removal of waste, with reference to glomerular filtration, selective reabsorption and secretion. (4 marks)
21 Describe the role of the convoluted tubules in the nephron, focusing on their role in selective reabsorption. (2 marks)
22 Identify which factors contribute to the movement of substances out of the blood at the glomerulus and into the Bowman’s capsule. (2 marks)
Analytical processes
23 Compare chemical digestion and physical digestion. (3 marks)
24 Differentiate between the functions of the small intestine and the large intestine in the digestive system. (2 marks)
Knowledge utilisation
25 Orlistat is a prescription medication that acts as a lipase inhibitor and is marketed as a weightloss treatment. Evaluate whether you believe a medicine like Orlistat could assist patients with weight loss. (2 marks)
26 The table below gives information about substances filtered from blood in normal human kidneys and excreted as urine. Substance
Dialysis tubing is a semi-permeable membrane used during the process of kidney dialysis. It works on the principles of diffusion and filtration. An experiment was conducted using dialysis tubing to investigate the movement of molecules across the tubing by placing dialysis tubing filled with sucrose solutions of increasing concentrations into distilled water. The table shows the change in mass of the dialysis tubing over time for the varying concentrations of sucrose. The figure depicts the mass of the tubing at varying sucrose concentrations after being in distilled water for 60 minutes.
Change in mass of dialysis tubing filled with varying concentrations of sucrose solution in distilled water
Excreted in urine
Of the filtered water, 80% is reabsorbed in the proximal convoluted tubule and in the descending loop of Henle. Using this information, propose a reason for the differences in quantities for each of these substances. (5 marks)
Mass of dialysis tubing filled with varying concentrations of sucrose solution after 60 minutes in distilled water
concentration withing tubing (%)
1 Calculate the percentage change in mass over 60 minutes for the 40% sucrose concentration. (1 mark)
Analyse data
2 C ontrast the change in mass between the 0% and 20% sucrose solution tests. (1 mark)
3 An unpaired student t -test was conducted to compare results between the 20% and 40% sucrose solutions, and a P -value of 0.6 was returned. Comment on the statistical significance of the comparative data. (1 mark)
Interpret evidence
4 Draw a conclusion about how sucrose concentration affects the diffusion of water into the dialysis tube. (1 mark)
5 Draw a conclusion about the statistical accuracy of the data. (1 mark)
Question 1
The monomers of proteins are called
A amino acids.
B carbon.
C monosaccharides.
D tertiary structures.
Question 2
A change in the physical structure of an enzyme preventing its active site binding with substrates is called
A activation energy.
B competitive inhibition.
C denaturation.
D melting.
Question 3
Enzyme rate of reaction is increased by
A decreasing the temperature.
B decreasing the volume of the enzyme.
C increasing the volume of both the enzyme and the substrate.
D increasing the volume of the substrate.
Question 4
The induced-fit model describes binding between an enzyme and the substrate, where
A a different molecule binds to the enzyme active site, preventing the enzyme binding with the substrate.
B a different molecule binds to a non-active part of the enzyme, which changes the shape of the active site, preventing the enzyme binding with the substrate.
C the active site of the enzyme and the substrate both change shape to fit together.
D the active site of the enzyme fits perfectly with the substrate.
Question 5
The graph shows the rate of reaction of an enzyme as an unknown independent variable is increased.
Rate of reaction
The most likely independent variable is
A pH.
B substrate concentration.
C temperature.
D volume of solution.
Question 6
The term “hydrophilic” means
A attracted to hydrogen.
B attracted to water.
C hydrogen repelling.
D water repelling.
Question 7
Lymph is a liquid carried in lymphatic vessels and is made up of
A erythrocytes and platelets.
B erythrocytes and leucocytes.
C lipids and leucocytes.
D lipids and plasma.
Question 8
Haemoglobin carries oxygen and is found in
A erythrocytes.
B lipids.
C plasma.
D platelets.
Question 9
What is the role of enzymes in digestion?
A They chemically break macromolecules into smaller components.
B They direct macromolecules to be absorbed through the stomach wall.
C They physically break monomers into polymers.
D They physically break food into smaller components.
Question 10
The enzyme responsible for breaking down fats is called
A amylase.
B catalase.
C lipase.
D pepsin.
Question 11
Step 2 in the image below is showing
A competitive inhibition.
B denaturation.
C the enzyme/substrate complex.
D the lock-and-key model.
Question 12
Veins are vessels in the circulatory system that
A carry blood away from the heart.
B contain valves.
C contract to move blood through the body.
D have walls that are one cell thick.
Substrate binds to active site of enzyme
Question 13
Temperature increases enzyme rate of reaction by
A denaturing enzymes.
B improving enzyme active site/substrate fit.
C increasing collision rate.
D lowering activation energy.
Question 14
The graph shows the rate of reaction of an enzyme as an unknown independent variable is increased.
Rate of reaction
The most likely independent variable is
A enzyme concentration.
B pH.
C substrate concentration.
D temperature.
Question 15
Nutrients and gases diffuse between the bloodstream and the cells at the juncture between cells and
A arteries.
B capillaries.
C valves.
D veins. Substrates
Enzyme changes shape slightly as substrate binds
Substrate is converted to products
leave active site of enzyme
Question 1 (4 marks)
The graph shows the relationship between temperature and rate of reaction of an enzyme.
a Identify the optimal temperature of this enzyme. (1 mark)
b Explain why the rate of reaction increases slowly before reaching the optimal rate and decreases quickly after reaching the optimal rate. (2 marks)
c Predict the rate of reaction if the experiment was extended to 70°C. (1 mark)
Question 2 (4 marks)
Contrast essential and non-essential nutrients, and provide an example of each.
Question 3 (3 marks)
Identify three components of blood plasma.
Question 4 (3 marks)
Describe the advantages of a closed circulatory system over an open circulatory system.
Question 5 (4 marks)
Describe the molecular structure of fatty acids and their interactions with water molecules.
Question 9 (4 marks)
Contrast arteries and veins with respect to their structure and function.
Question 10 (2 marks)
Explain the importance of red blood cells’ small size.
Question 11 (4 marks)
Describe the progression of a protein through primary, secondary, tertiary and quaternary structures.
Question 12 (4 marks)
Explain the process of peristalsis, including the structures involved.
Question 6 (3 marks)
Explain the importance of valves in veins.
Question 7 (3 marks)
Compare the pulmonary and systemic circuits in the circulatory system.
Question 8 (4 marks)
Describe the elements and monomers that make up proteins.
Question 13 (3 marks)
The image shows an experiment on enzyme rate of reaction.

a Suggest a possible independent variable that would result in different rates of reaction in each beaker. (1 mark)
b Identify one controlled variable that is apparent in the two beakers. (1 mark)
c If the liquid contains the enzyme amylase, infer the substrate contained in the solid component. (1 mark)
TOTAL MARKS /60 marks

All organisms require energy to drive the chemical reactions necessary for their survival. Metabolism is the total sum of chemical reactions that occur inside cells, to help the cells survive. There are two types of metabolic reactions: catabolic reactions, which produce energy, and anabolic reactions, which require energy. Cellular respiration is a key catabolic reaction that occurs in all living things. In cellular respiration, glucose is broken down, producing chemical energy in the form of ATP. This process is more efficient when it occurs in the presence of oxygen. When it occurs in the absence of oxygen, unwanted chemicals are produced.
→ Distinguish between catabolism and anabolism.
→ Explain how ATP allows energy from catabolic reactions to be used in anabolic reactions.
→ Describe the process of aerobic respiration, identifying the location in the cell and net inputs and outputs of
→ glycolysis
→ Krebs cycle and electron transfer chain
→ the overall reaction (C6 H12O6 + 6O2 → 6CO2 + 6H 2O + 36–38 ATP).
→ Compare aerobic and anaerobic respiration.
→ Appreciate that scientists can use their understanding of natural systems to develop new technologies.
Source: Biology 2025 v1.0 General Senior Syllabus © State of Queensland (QCAA) 2025
Check your understanding of cellular reactions before you start. If you need to revise, you’ll be assigned a helpful resource.

Learning intentions and success criteria
energy the capacity to do work
kinetic energy the energy of motion
potential energy stored energy
chemosynthesis
the process in which reactions of inorganic substances are used to provide energy for the synthesis of organic compounds
photosynthesis the process in which light energy is converted to the chemical energy of glucose; requires chlorophyll, carbon dioxide, water and a suitable temperature; occurs in green plants, algae and some bacteria
→ Energy is the ability to do work or to cause a change.
→ Metabolism is all the chemical reactions that take place inside a cell or an organism.
→ There are two types of metabolic reactions. In anabolic reactions, new larger molecules are synthesised and energy is consumed. In catabolic reactions, large molecules are broken down, releasing energy.
Energy is the ability to do work or to cause a change. Energy is required for all the chemical reactions that occur within cells. All cells need a constant supply of energy to grow, reproduce and stay alive. Cells mostly use chemical energy, and many organisms obtain chemical energy from their food. For some types of cells, light is an important source of energy. There are two main types of energy: kinetic energy (the energy of motion) and potential energy (energy that is stored).
The compounds that make up living cells are highly complex. Some are composed of thousands of atoms bonded together. Many of these bonds, particularly carbon-tohydrogen or “C–H” bonds, have relatively large amounts of chemical energy stored within them. This means that each living organism has a “storehouse” of potential chemical energy that can be harnessed when necessary to do work. Each time this stored energy is converted to other forms for use, less energy remains in reserve. Therefore, each organism needs an external source of energy that can be used to replenish its supply of chemical-bond energy. For organisms that cannot create their own food (heterotrophs), this outside energy source is other organisms. For organisms that can produce their own food (autotrophs), the source may be inorganic molecules (chemosynthesis) or sunlight ( photosynthesis).


Metabolism is all the chemical reactions that take place inside a cell or an organism. Metabolic processes proceed in small steps, the sum of which is called a metabolic pathway. There are two types of metabolic reactions.
• Anabolism describes the reactions that synthesise new larger molecules. Anabolic reactions tend to absorb energy (endergonic), as energy is used to form new bonds.
• Catabolism describes the reactions that break down large molecules into smaller ones. Catabolic reactions tend to release energy (exergonic), as bonds are broken between atoms.
All the catabolic and anabolic reactions occurring at any time in a cell constitute its metabolism.
anabolism + catabolism = metabolism
The energy released in catabolic reactions is used to drive anabolic reactions, for work (e.g. muscular contractions) and for maintenance. Some energy is lost as heat energy.
Anabolism
Metabolic pathway
Metabolic pathway simple molecules + energy large complex molecules
2 Anabolic and catabolic reaction pathways
Catabolism
To remember the difference between anabolism and catabolism, think of “ABCD”: anabolism builds, catabolism destroys.
metabolism all the chemical reactions occurring within a cell
anabolism
chemical reactions in which large molecules are built up, usually with a net input of energy
endergonic describes a chemical reaction involving the absorption of energy
catabolism
chemical reactions in which large molecules are broken down into smaller ones, usually with the release of energy
One of the most important metabolic pathways yielding energy is the breaking down of sugar. This is an oxidation process. As sugar is broken down, energy is released and carbon dioxide and water are formed. The process, called cellular respiration, can be shown in simplified form by the following:
C6 H12O6 + 6O2 → 6CO2 + 6H
The sugar molecule, C6 H12O6 or glucose, contains potential energy, which is freed only when the bonds holding the atoms in the molecule together are broken and new, lower-energy molecules are formed.
Anabolic reaction
molecules
molecule Catabolic reaction
FIGURE 3 Visual summary of anabolic and catabolic reactions
molecules
molecule
exergonic describes a chemical reaction in which energy is released
Check your learning 7.1
Check your learning 7.1: Complete these questions online or in your workbook.
Retrieval and comprehension
1 Define metabolism. (1 mark)
2 E xplain why cells require a constant input of energy. (1 mark)
3 Explain what happens to energy when a chemical bond is broken and when a chemical bond is formed. (2 marks)
Analytical processes
4 D istinguish between anabolism and catabolism. (2 marks)
5 Classify each of following reactions as anabolic or catabolic. Justify your answer.
a 6CO2 + 6H 2O + sunlight → C6H12O6 + 6O2 (2 marks)
b C6H12O6 + 6O2 → 6CO2 + 6H 2O + energy (2 marks)
→ Adenosine triphosphate (ATP) is an important molecule in living organisms. In ATP, energy is stored in a readily available form and can be transferred from one site to another.
→ An ATP molecule consists of the nitrogen base adenine, a ribose sugar and three phosphate groups arranged in sequence.
→ When ATP loses a phosphate, it becomes adenosine diphosphate (ADP). Energy is released by the breaking of the high-energy bond.
Learning intentions and success criteria
adenosine triphosphate (ATP)
an organic chemical able to store and release large amounts of energy; consists of the nitrogen base adenine bound to three phosphate groups
Energy released at one site of a cell is often required at another site. This is important in all metabolic reactions. In biological systems, some molecules are used to transport energy molecules from place to place, or simply to store energy in a readily accessible form.
Adenosine triphosphate (ATP) is the major molecule involved in this process. ATP is in all living things.
An ATP molecule is composed of an adenine unit, a ribose (five-carbon sugar) and three phosphate groups in sequence (Figure 1).
1 An ATP molecule consists of an adenine base (blue), a ribose sugar (pink) and a chain of three phosphate groups.
The bonds between the phosphate groups are high-energy bonds, often represented by the symbol “ ~ ”. These high-energy phosphate bonds are weak and unstable, and therefore can be readily broken. Usually, it is the phosphate bond furthest from the adenine that is broken to provide energy for metabolic reactions. The breaking of this phosphate bond produces a lower-energy, more stable compound called adenosine diphosphate (ADP). ADP consists of an adenine base, a ribose sugar and only two phosphate groups. The conversion of ATP to ADP releases a phosphate group and energy (Figure 2).
FIGURE 2 When an ATP molecule is broken down into ADP, one phosphate is removed and energy is released.
When a phosphate bond is broken in this reaction, the energy stored within the bond is released. This energy can then be used to fuel other metabolic reactions. The detached phosphate molecule will often attach to other molecules, in a reaction called phosphorylation. New ATP can be synthesised from ADP and a phosphate if there is enough energy available to bind a third phosphate group to the ADP.
The phosphate-bond energy of ATP is used to do cellular work. Metabolism therefore involves enzymes and the transfer of energy. Figure 3 summarises these reactions.
Anabolic reactions in cells build complex molecules from simpler molecules. These reactions usually involve specific enzymes and use energy.
Catabolic reactions in cells break down complex molecules into simpler molecules. These reactions usually involve specific enzymes and release energy.
A substrate is a substance acted upon by enzymes. Products are substances produced in chemical reactions.
FIGURE 3 The relationship between metabolism, enzymes and energy. These diagrams represent very simple metabolic pathways.
adenosine diphosphate (ADP) the nitrogen base adenine bound to two phosphate groups, each bond requiring an input of energy phosphorylation the addition of a phosphate group to a molecule; can be noncyclic (e.g. formation of ATP) or cyclic (e.g. the cyclic flow of electrons along the electron transfer chain from chlorophyll, the released energy being used in the formation of ATP)
Other organic carrier molecules are also important in energy transfer in metabolic pathways.
• NAD+ (nicotinamide adenine dinucleotide) receives electrons from other molecules and reacts with hydrogen ions to form NADH, which donates electrons for other reactions.
• FAD (flavin adenine dinucleotide) reacts with electrons and hydrogen ions in a similar way, to form FADH 2 .
It takes energy for the hydrogen ions and electrons to bond with the carrier molecules. Therefore, when the hydrogen ions are released from the carrier molecule, energy is also released. The NADH and FADH 2 molecules are important in the carriage of hydrogen in metabolic pathways.
Check your learning 7.2
Check your learning 7.2: Complete these questions online or in your workbook.
Retrieval and comprehension
1 Describe the features of the ATP molecule that enable it to function as an energy carrier in biological systems. (2 marks)
2 Explain how ATP provides energy for metabolic reactions. (2 marks)
Learning intentions and success criteria
cellular respiration the breaking down of glucose in cells to release energy; may occur with oxygen (aerobic) or without oxygen (anaerobic)
Analytical processes
3 C ompare ATP and ADP. (3 marks)
4 D istinguish between a metabolic reaction and a metabolic pathway. Suggest a reason for the occurrence of metabolic pathways. (3 marks)
→ Cellular respiration is a process in which glucose is changed into a usable form of energy. It can be summarised by the reaction: C6H12O6 + 6O2 → 6CO2 + 6H2O + 36–38 ATP.
→ Aerobic cellular respiration takes place in the presence of oxygen. It has three stages: glycolysis, the Krebs cycle and the electron transfer chain.
→ Glycolysis occurs in the cytoplasm. All other stages of aerobic respiration take place in the mitochondria.
Some autotrophs, such as plants and some bacteria, convert light energy into chemical energy in the form of glucose, through photosynthesis. Heterotrophs, such as humans and other animals, need to consume other organisms to acquire chemical energy in the form of glucose. All cells, whether heterotrophic or autotrophic, must convert glucose (C6 H12O6 ) into the energy ‘currency’ molecule, ATP.
Cellular respiration is the process in which glucose is converted into a usable form of energy. All cells, including the cells of autotrophs, must carry out cellular respiration to survive.
The process generally involves the oxidation of sugar in a series of small steps, each controlled by an enzyme. The energy released is stored in the ATP molecule for further use by the cell and can be transported to other cells or other sections of the cell within an organism.
Some steps in cellular respiration are endergonic (energy consuming), but most are exergonic (energy releasing). The overall reaction is exergonic and leads to the production of ATP. Each step in cellular respiration is controlled by a specific enzyme. Cellular respiration can occur two ways: aerobically (in the presence of oxygen) or anaerobically (in the absence of oxygen). In this lesson you will learn about aerobic respiration.
Cellular respiration begins with the breaking down of glucose into two molecules of pyruvate. Pyruvate and oxygen then enter the mitochondrion, where the pyruvate is broken down to release carbon dioxide, water and ATP molecules in the Krebs cycle and the electron transfer chain. Oxygen is needed to remove hydrogen released in the Krebs cycle, so that this cycle can continue.
The mitochondrion (plural “mitochondria”) is a double-membraned cell organelle. Its inner membrane is deeply folded, forming a series of cristae (shelves), which increase the surface area of this membrane. The whole structure is either spherical (e.g. in liver cells) or cigar-shaped, providing a high surface area-to-volume ratio for the efficient uptake and release of materials.
aerobically occurring in the presence of oxygen anaerobically occurring in the absence of oxygen
aerobic respiration the complete conversion of glucose to carbon dioxide and water in the mitochondria of cells with oxygen present, resulting in the release of a large amount of energy (net gain of 36 AT P)
glycolysis the first stage in cellular respiration; occurs in the cytoplasm and results in the gain of 2 AT P and 2 pyruvate molecules; does not require oxygen
acetyl-CoA a biomolecule involved in metabolism; the substrate that enters the Krebs cycle
1 The structure of a mitochondrion:
The outer membrane controls the passage of materials into and out of the mitochondrion. The inner membrane contains the enzymes responsible for ATP production.
The matrix within the mitochondrion contains ribosomes, circular DNA molecules and the enzymes required for many of the steps in aerobic cellular respiration.
Aerobic cellular respiration has three stages:
1 glycolysis, followed by acetyl-CoA formation
2 the Krebs cycle
3 the electron transfer chain
Aerobic cellular respiration begins in the cytoplasm with glycolysis, a process in which a glucose molecule is broken down into two smaller molecules of a compound called pyruvate Glycolysis occurs in all living organisms. It is an anaerobic process – it does not require oxygen.
Krebs cycle
a cyclic series of chemical reactions in the mitochondria of cells: two acetyl-CoA molecules are converted to citric acid; with the addition of six water molecules, the citric acid releases six carbon dioxide molecules as waste and 16 hydrogen atoms; the hydrogen atoms are transferred to carrier molecules; two ATP are formed
electron transfer chain a series of coenzymes along which highenergy electrons pass, releasing energy to form ATP at each step in the chain; the final stage in aerobic cellular respiration in which most ATP molecules are formed pyruvate the product of glycolysis; used to synthesise many metabolic pathways
coenzyme A a coenzyme in biochemical reactions; reacts with pyruvate to form acetyl-CoA
It takes place in the cytoplasm of the cell, not the mitochondrion, because glucose molecules are too large to pass through the outer membrane of the mitochondrion. The glycolysis reaction is initiated when one glucose molecule reacts with two ATP molecules. The reaction (Figure 2) can be written as:
glucose + 2ATP + 2ADP + 2~P → 2 pyruvate + 4ATP
The glycolysis reaction results in:
• conversion of a six-carbon glucose molecule to two three-carbon pyruvate molecules
• formation of four ATP molecules, resulting in a net gain of two ATP molecules (four ATP molecules are produced, but two are initially needed as activation energy)
• formation of two hydrogen carriers (NADH).
TABLE 1 Summary of the location, inputs and outputs of glycolysis
Glycolysis Cytoplasm 2 AT P
Glucose (C6H12O6)
2 A DP
2 NAD+

2
If oxygen is present (aerobic respiration), the pyruvate molecules formed by glycolysis leave the cytoplasm and enter the mitochondrion by passing through the mitochondrion’s outer and inner membranes. Then, in the mitochondrial matrix, each pyruvate molecule reacts in the presence of a carrier molecule called coenzyme A . Pyruvate must be converted into acetyl-CoA before it can enter the Krebs cycle.
In this reaction (Figure 3), for each pyruvate molecule:
• a carbon dioxide molecule is released from the pyruvate as a waste product
• the two-carbon molecule that is left from the first step attaches to a coenzyme A molecule, forming acetyl-CoA and a hydrogen ion
• NAD+ gains two electrons and a hydrogen ion to form the hydrogen carrier NADH.
TABLE 2 Summary of the location, inputs and outputs of acetyl-CoA formation Process
The Krebs cycle is a series of chemical reactions in the mitochondrial matrix that start and finish with the same four-carbon molecules. Two acetyl-CoA molecules enter the cycle separately by combining with these four-carbon compounds to form two molecules of citric acid. Each step in the cycle is enzyme driven. For the cycle to proceed, it requires an input of six water molecules for each citric acid molecule, which releases:
• 16 hydrogen ions and electrons that are passed to hydrogen carriers (6 NA DH and 2 FA DH 2)
• another two ATP molecules
• four carbon dioxide molecules as a waste product
• a molecule that reacts with water to re-form the original four-carbon molecule.
Hydrogen carriers NADH Hydrogen ions and 6NADH Hydrogen ions and 2 FADH2
FIGURE 4 Glycolysis produces two three-carbon pyruvate molecules. If oxygen is present, the pyruvate moves into the mitochondria. Each pyruvate loses carbon dioxide and becomes acetyl-CoA. The acetyl-CoA then enters the Krebs cycle, resulting in the formation of carbon dioxide, ATP, and hydrogen ions and electrons on their hydrogen carriers.
TABLE 3 Summary of the location, inputs and outputs of the Krebs cycle
The inner membrane of the mitochondrion has many deep folds, known as cristae, to increase its surface area for the chemical reactions. A series of specialised enzymes associated with these reactions are embedded in this inner membrane. Hydrogen ions formed in the previous steps are released from their carriers to the electron transfer chain, along with high-energy electrons. At each step in the chain, energy is released from the electrons and used in the formation of ATP. At the end of the chain, the low-energy electrons combine with the hydrogen ions and, with an input of six oxygen molecules, form water. Overall, this step produces:
• 32 to 34 ATP molecules
• 12 water molecules, so there is a net of 6 molecules as a waste product. The overall equation for aerobic cellular respiration is often written as: glucose + 6 oxygen + 6 water + ADP + ~P → 6 carbon dioxide + 12 water + energy (ATP)
C6 H12O6 + 6O2 + 6H 2O + 36–38 ADP + 36–38~P → 6CO2 + 12H 2O + 36–38 AT P
It can be summarised as:
C6 H12O6 + 6O2 → 6CO2 + 6H 2O + 36–38 AT P
Depending on certain conditions, either 32 or 34 ATP molecules are produced during electron transfer chain reactions. There is a net gain of either 36 or 38 ATP molecules for every glucose molecule aerobically respired. For each glucose molecule, 6 CO2 and 6 H 2O are released (as waste), and 36 AT P molecules are released (as a chemical energy transfer molecule).

+ ½ O2
FIGURE 5 Enzymes embedded in the inner membrane of the mitochondrion carry electrons to the final electron acceptor, which produces ATP molecules.
TABLE 4 Summary of the location, inputs and outputs of the electron transfer chain
All laboratory experiments carry a level of risk. Each lab should have a folder of material safety data sheets (MSDS), which are often managed by a laboratory technician. Each MSDS contains information on a particular chemical, such as:
• chemical formula
• melting point
• boiling point
• alternative names
• handling and storage methods
• first aid support in case of exposure to the chemical
• disposal methods.
Before running any experiment, it is important to review the MSDS for the chemicals you will be using. You can then fill out a risk assessment.
1 The reactants and products of cellular respiration are listed in the table. Conduct an online search of MSDS and use the information in them to complete the table. (16 marks)
Danger to human health
Flammability
Boiling point
Melting point
Need help identifying and implementing strategies to manage risks? Go to Lesson 1.4 in your biology toolkit.
Check your learning 7.3: Complete these questions online or in your workbook.
Retrieval and comprehension
1 C onstruct a worded equation and a balanced chemical equation to describe aerobic cellular respiration. (2 marks)
2 Summarise aerobic cellular respiration by copying and completing the table. (16 marks)
Check your learning 7.3 Glycolysis
Location
Input(s)
Output(s)
Number of ATP formed
Learning intentions and success criteria
Practical
Lesson 7.4
3 E xplain why the folded inner membrane (cristae) of a mitochondrion is important for aerobic cellular respiration. (1 mark)
Analytical processes
4 Use the information in Question 2 to deduce which part of aerobic cellular respiration would be most affected by a lack of oxygen. (2 marks)
Learning intentions and success criteria
Key ideas
→ Anaerobic respiration occurs in the absence of oxygen.
→ There are two types of anaerobes: complete anaerobes, which respire using anaerobic respiration only, and partial anaerobes, which can switch between aerobic and anaerobic respiration depending on oxygen availability.
→ Anaerobic respiration in animals is facilitated through lactic acid fermentation.
→ Anaerobic respiration in plants, fungi and bacteria is facilitated through ethanol fermentation.
In all chemical pathways driven by enzymes, many factors can affect the rate of cellular respiration. The absence of oxygen is one such factor. Oxygen is required in the electron transfer chain; if oxygen is limited, this series of reactions cannot occur. This means that in the absence of oxygen, a cell will not be able to produce as much ATP. In such conditions, organisms produce ATP through anaerobic respiration.
In all organisms that respire, glycolysis occurs outside the mitochondria to break down glucose molecules into pyruvate and produce a net of two ATP molecules. If oxygen is present, respiration proceeds with the electron transfer chain to produce more ATP. However, oxygen is not always freely available. When this is the case, organisms generate additional ATP through anaerobic respiration. Some organisms can generate enough energy from anaerobic respiration alone. These organisms are known as anaerobes. In general, there are two types of anaerobes: complete anaerobes and partial anaerobes
Complete anaerobes live permanently in oxygen-deficient conditions and therefore only carry out anaerobic respiration. Some of these anaerobes (including certain bacteria and some parasites) may be poisoned by even low concentrations of oxygen.


Partial anaerobes thrive in the presence of oxygen but will resort to anaerobic respiration if oxygen is absent or in short supply. Examples of partial anaerobes are worms living in the mud at the bottom of stagnant pools or oceans and diving mammals such as whales that can stay under water for long periods. The length of time an organism can survive without oxygen varies. Humans can survive without oxygen for only minutes, whereas some simpler organisms and plants can respire anaerobically for much longer periods.
anaerobic respiration
cellular respiration in the absence of oxygen, resulting in a net gain of 2 ATP and lactic acid (in animals), or ethyl alcohol and carbon dioxide (in plants, fungi and bacteria)
complete anaerobe an organism that does not need oxygen for cellular respiration
partial anaerobe an organism that can undergo a period of anaerobic cellular respiration when oxygen is at low levels or in short supply
Fermentation is an anaerobic process in which glucose is broken down in the absence of oxygen. After pyruvate is formed by glycolysis, it enters one of two fermentation pathways, depending on the type of organism. In animals, lactic acid fermentation occurs, while in plants, fungi and bacteria, ethanol fermentation occurs. fermentation the anaerobic breaking down of sugar by bacteria and yeasts to form ethyl alcohol, carbon dioxide and two ATP
lactic acid fermentation a biological process in which glucose is converted into cellular energy, with lactate as a byproduct
ethanol fermentation a biological process in which glucose is converted into cellular energy, with ethanol and carbon dioxide as byproducts
Undergoes glycolysis (anaerobic process)
to produce two molecules of pyruvate, a 3-carbon compound.
If no oxygen is present, anaerobic respiration occurs.
Animals
Lactic acid in muscles is a product.
2 pyruvate produced Undergoes glycolysis Undergoes fermentation
2 lactate produced
myoglobin a protein in the muscles that can bind to oxygen
lactic acid an organic acid with the formula C 3H6O3 formed by the breaking down of glucose during anaerobic cellular respiration in animals oxygen debt the amount of oxygen required to convert the lactic acid produced during anaerobic respiration to pyruvate
If oxygen is present, pyruvate and oxygen move into the mitochondrion and aerobic cellular respiration produces carbon dioxide, water and energy
Plants + yeasts
Ethanol and carbon dioxide are products.
Anaerobic respiration in animals occurs through lactic acid fermentation. This can be represented by the following equation: glucose (C6 H12O6 ) → 2 lactic acid + 2ATP
As you learnt in Lesson 7.3, the glycolysis reaction produces two pyruvate molecules, two NADH and a net of two ATP molecules. When oxygen is not present, the two pyruvate molecules produced by glycolysis do not move into the mitochondria. Instead, they are converted into two lactate molecules in the cytoplasm of the cell.
When a person exercises vigorously, their body requires more energy than can be supplied aerobically. This is because their respiratory and circulatory systems cannot operate fast enough to sustain an adequate supply of oxygen. When oxygen levels in the blood begin to run low, oxygen is released from myoglobin, an oxygen-storing molecule in muscles. The levels of oxygen attached to the myoglobin are limited and eventually they become too low to sustain aerobic cellular respiration. The muscle fibres then provide energy anaerobically, producing lactate (which can become lactic acid). Like all acids, lactic acid is a metabolic poison and can cause damage if too much accumulates in the body. To prevent this, it is often rapidly transported to the liver, where it can be converted back into pyruvate and then glucose. Lactate that has been converted back to pyruvate can then re-enter the aerobic cellular respiration pathway if oxygen becomes available. The amount of oxygen needed to get rid of the lactic acid is called the oxygen debt . ‘Stiffness’ of muscles occurs when lactic acid accumulates and causes muscle fibre damage before it is broken down.

FIGURE 4 During vigorous exercise, lactic acid can build up in the muscles.
Anaerobic respiration in plants, fungi and bacteria occurs through ethanol fermentation. This can be represented by the equation:
glucose (C6 H12O6 ) → 2 ethanol ( C2 H 5OH) + 2CO2 + 2ATP
This process begins after glycolysis has occurred in the cytoplasm of the plant, fungal or bacterial cell that lacks oxygen. When oxygen is not present, the two pyruvate molecules produced stay in the cytoplasm and are converted into two acetaldehyde molecules and two carbon dioxide molecules. The acetaldehyde molecules are then converted into two ethanol molecules via NADH.
Because ethanol cannot be broken down by plants, a build-up of too much ethanol can be toxic to the organism. This means that, while plants can resort to anaerobic respiration for a short period (e.g. germinating seeds or roots in waterlogged soil), they must revert to aerobic respiration before ethanol levels reach toxic levels and cause death. Natural fermentation of yeasts (single-celled fungi) and bacteria has been used by humans for thousands of years.
During the breeding season of the “spring peeper” frog, Hyla crucifer, males let out a loud mating call to attract a female mate. Researchers studying male spring peepers have found that vocalising this call consumes large amounts of energy. When male spring peepers call, their concentration of lactic acid doubles compared to when they are in a resting state.
Undergoes glycolysis
Undergoes alcoholic fermentation
in plants, fungi and bacteria

1 Explain why a higher concentration of lactic acid builds up in spring peepers during a mating call. (1 mark)
Researchers have been developing biomolecules that enhance the performance and prolong the life of metal–air batteries, basing their design on cellular respiration. Metal–air batteries are still in development, but they have the potential to effectively replace petroleum-based fuel, instead using oxygen gas and metals such as sodium or zinc. Just as cells use oxygen to generate energy through metabolic pathways, metal–air batteries “breathe in” oxygen to generate electrochemical energy.
ethanol an alcohol with the formula C2H 5OH formed from the breaking down of glucose in plants, yeasts and bacteria acetaldehyde an organic compound that forms as an intermediate compound between pyruvate and ethanol during alcoholic fermentation
Metal–air batteries are still currently limited in their rechargeability, due to inefficient reactions. To overcome this, scientists have created synthetic molecules that mimic catalysts and other chemicals in mitochondria, to enable the metal to react more efficiently with oxygen during discharge. The metal oxides produced during discharge then decompose during the charging phase, “exhaling” oxygen gas. These batteries use graphene sheets, which provide a large surface area, enabling reactions to occur faster, just like the cristae within mitochondria. This research holds promise for the development of high-capacity, reversible, efficient and eco-friendly batteries. Understanding the links between the structure and function of biomolecules involved in cellular respiration will enable scientists to manufacture advanced energy-storage devices for the future.
Apply your understanding

1 Identify two similarities between cellular respiration and metal–air batteries. (2 marks)
2 E xplain the importance of developing synthetic molecules that mimic mitochondrial catalysts. (1 mark)
3 P ropose a research question that could address an aspect of the following claim: “Understanding the links between the structure and function of biomolecules involved in cellular respiration will enable scientists to develop advanced energy-storage devices for our future.” (1 mark)
Check your learning 7.5
Check your learning 7.5: Complete these questions online or in your workbook.
Retrieval and comprehension
1 Identify the site where anaerobic cellular respiration occurs. (1 mark)
2 Identify the type of fermentation in which the following substances are the end products.
a carbon dioxide (1 mark)
b ethanol (1 mark)
c lactate (lactic acid) (1 mark)
3 Red blood cells do not contain mitochondria. Explain why these cells can only obtain energy through anaerobic respiration. (1 mark)
4 Construct a word equation for each of the following types of cellular respiration.
a aerobic respiration (1 mark)
b lactic acid fermentation (1 mark)
c ethanol fermentation (1 mark)
Analytical processes
5 D istinguish between a complete anaerobe and a partial anaerobe. (2 marks)
6 C ompare aerobic and anaerobic cellular respiration. (3 marks)
• Energy is the ability to do work or to cause a change.
• Metabolism is all the chemical reactions that take place inside a cell or an organism.
• There are two types of metabolic reactions. In anabolic reactions, new larger molecules are synthesised and energy is consumed. In catabolic reactions, large molecules are broken down, releasing energy.
• Adenosine triphosphate (ATP) is an important molecule in living organisms. In ATP, energy is stored in a readily available form and can be transferred from one site to another.
• An ATP molecule consists of the nitrogen base adenine, a ribose sugar and three phosphate groups arranged in sequence.
• When ATP loses a phosphate, it becomes adenosine diphosphate (ADP). Energy is released by the breaking of a high-energy bond.
• Cellular respiration is a process in which glucose is changed into a usable form of energy. It can be summarised by the reaction: C6H12O6 + 6O2 → 6CO2 + 6H 2O + 36–38 AT P.
• Aerobic cellular respiration takes place in the presence of oxygen. It has three stages: glycolysis, the Krebs cycle and the electron transfer chain.
• Glycolysis occurs in the cytoplasm. All other stages of aerobic respiration take place in the mitochondria.
• Practical: Investigating respiration
• Anaerobic respiration occurs in the absence of oxygen.
• There are two types of anaerobes: complete anaerobes, which respire using anaerobic respiration only, and partial anaerobes, which can switch between aerobic and anaerobic respiration depending on oxygen availability.
• Anaerobic respiration in animals is facilitated through lactic acid fermentation.
• Anaerobic respiration in plants, fungi and bacteria is facilitated through ethanol fermentation.
Review questions: Complete these questions online or in your workbook.
1 A catabolic reaction is
A the process of building up complex molecules from simpler ones.
B the breaking down of complex molecules into simpler ones.
C the synthesis of ATP from ADP and a phosphate group.
D the sum of all chemical reactions in the body.
2 Protein synthesis is the process of creating a large protein chain from many smaller amino acids. This is an example of
A a catabolic reaction.
B phosphorylation.
C cellular respiration.
B an anabolic reaction.
3
Adenosine triphosphate is a high-energy molecule composed of
A an adenine molecule and two phosphate groups, joined by a high-energy bond.
B a guanine molecule and three phosphate groups.
C an adenine molecule and three phosphate groups, joined by low-energy bonds.
D an adenine moclecule and three phosphate groups, joined by high-energy bonds.
4 The conversion of ADP into ATP is an example of
A a catabolic, exergonic reaction.
B a catabolic, endergonic reaction.
C an anabolic, exergonic reaction.
D an anabolic, endergonic reaction.
5 How many ATP molecules are produced during aerobic cellular respiration?
A 2
B 36 to 38
C 4
D 30 to 32
6 Which molecule is formed as the product of glycolysis?
A pyruvate
B acetyl-CoA
C lactic acid
D carbon dioxide
7 In which phase of aerobic cellular respiration is oxygen required?
A the Krebs cycle
B glycolysis
C the electron transfer chain
D acetyl-CoA formation
8 Anaerobic cellular respiration is a chemical reaction that
A occurs in the mitochondria of cells.
B forms lactate (lactic acid) and a large amount of ATP in plants and yeasts.
C occurs in the cytoplasm and releases small amounts of ATP.
D forms ethyl alcohol and a small amount of ATP in animals.
9 Which phase of cellular respiration can occur in the absence of oxygen?
A glycolysis
B the Krebs cycle
C the electron transfer chain
D all three of the above phases
10 Fermentation occurs in plant cells in a low-oxygen environment. The products of fermentation in plants are
A lactate and 2 ATP.
B lactate, CO2 and 2 ATP.
C ethyl alcohol and 2 ATP
D ethyl alcohol, CO2 and 2 ATP.
Review questions: Complete these questions online or in your workbook.
Retrieval and comprehension
11 Describe the role of ATP in metabolism. (1 mark)
12 Recall the balanced chemical equation for aerobic cellular respiration. (1 mark)
13 Summarise the phases of aerobic respiration by creating a table that outlines the location, reactants, products and net ATP produced in glycolysis, the Krebs cycle and the electron transfer chain. (12 marks)
14 Explain the different number of ATP molecules that may be formed through aerobic cellular respiration. (1 mark)
15 ADP and ATP are often referred to as a chemical energy shuttle. Using the last phase of aerobic
respiration as an example, explain how this shuttle analogy is appropriate. (2 marks)
16 Explain the advantages to the cell of having a cyclical metabolic system, such as the Krebs cycle. (2 marks)
17 Distinguish between catabolic and anabolic reactions and explain the relationship between these reactions within a cell. (3 marks).
18 Several jars of strawberry jam were made and stored in a cupboard. When opened several months later, they were frothy and smelled of alcohol.
a Deduce what has happened. (2 marks)
b Explain how this could have been prevented. (1 mark)
19 The table shows the energy contribution of anaerobic and aerobic respiration in an athlete doing high-intensity exercise.
6
0–20
0–30
0–60
18
27
45
a Use the data in the table to discuss the importance of anaerobic respiration for a person doing high-intensity exercise. (3 marks)
b Explain the trend seen in the contribution of aerobic respiration as the duration of the highintensity exercise increases. (1 mark)
20 When the body runs out of readily available glucose molecules, it will turn to stored glycogen, then fats and finally proteins as an energy source.
To investigate the rate of fermentation of sugars, activated Saccharomyces cerevisiae yeast was placed into a test tube containing 100 mL of a 10% sugar solution. Five solutions were tested: two monosaccharides (glucose and fructose), two disaccharides (sucrose and maltose) and one control, which did not contain sugar. The experiment was carried out in a hot bath set to 40°C. The amount of CO2 produced per minute for total of 10 mi nutes was used as an indicator of reaction rate.
Apply understanding
1 Determine the mean rate of fermentation of glucose. (1 mark)
Analyse data
2 Identify which sugar is least efficiently fermented by S. cerevisiae. (1 mark)
Glycogen is the molecule formed when glucose is stored, particularly in the muscles and liver. Fat is stored in fat tissues and is used for energy storage and protection. Proteins are important for the growth and repair of muscles.
a Determine the stage of cellular respiration in which the products from the following molecules would enter: (3 marks)
i glycogen → glucose ii fat → acetyl-CoA iii protein → pyruvate.
b Discuss the implications of this process for an individual whose energy demand is greater than their intake of simple carbohydrates such as glucose. (3 marks)
c A camel stores fat in its hump primarily as a water source rather than an energy source. Evaluate which metabolic process would make water available from fat. (3 marks)
3 Draw a conclusion about whether there is a statistical difference between the rates of reaction of these four sugars. (2 marks)
Rate of fermentation of sugar by Saccharomyces cerevisiae , measured by the rate of CO2 produced in 10 minutes. Error bars show standard deviation of the data.

In multicellular organisms, nutrients are transported from the external environment to the organism’s cells for metabolic processes. These metabolic processes produce waste, which must be transported to the external environment for removal. In larger organisms, the cells of the organism’s internal organs are further from the surface of the body where this exchange occurs. Specialised transport systems have evolved to enable the movement of nutrients and waste into and out of large multicellular organisms. One such system is the respiratory system, which enables the exchange of gases such as oxygen and carbon dioxide.
Check your understanding of concepts related to gas exchange in humans before you start.
→ Explain how structural features of exchange surfaces in the respiratory and circulatory systems of mammals (alveoli and capillaries) allow for efficient gas exchange.
→ Analyse data to predict the direction that materials will be exchanged between – alveoli and capillaries
– capillaries and muscle tissue.
→ Investigate – adaptations that allow for efficient nutrient and/or gas exchange in plants or animals.

Learning intentions and success criteria
→ The main organs of the mammalian gas exchange system are the nose, mouth, pharynx, trachea, bronchi and lungs.
→ Inhalation and exhalation of air into and out of the lungs is controlled by movement of the diaphragm.
→ Alveoli allow the passage of gases between the bloodstream and inhaled air because alveoli are thin and moist, and have a large surface area.
respiratory system
the body system that delivers oxygen to the body and expels gaseous wastes such as carbon dioxide lungs a pair of organs in the body that enable gas exchange, to supply the body with oxygen and remove carbon dioxide




FIGURE 1 Structures of the human respiratory system


Most mammals live on land, where gas is exchanged through the air. To protect their delicate gas exchange surfaces from drying out, mammals have developed an internal respiratory system containing lungs. Aquatic mammals also use lungs for gas exchange but have adaptations to protect them from drowning. In mammalian respiratory systems, the lungs are located within the chest cavity and are connected to the air in the external environment by
specialised tube-like structures. The location of the heart directly between the lungs allows these organs to work together to exchange gas efficiently – the heart pumps deoxygenated blood (carrying carbon dioxide waste) to the lungs, and also pumps freshly oxygenated blood to the body. The thoracic cavity, which contains the lungs and heart, is separated from the abdomen by a sheet-like muscle called the diaphragm
The primary functions of the respiratory system are to:
• transport oxygen from the lungs to the cells of the body for cellular respiration
• transport waste products of cellular respiration (e.g. carbon dioxide) from the cells to the lungs so they can be removed through exhalation.
When we breathe in, the air moves from our mouth and nose through the trachea into the two bronchi of the lungs. The bronchi branch into smaller bronchioles, which continue to branch into increasingly smaller tubes until the air reaches the alveoli, the site of gas exchange with the bloodstream. Alveoli have features that allow rapid exchange of large volumes of gas, to maintain homeostasis in the body.
• The lining of alveoli is only one cell thick, so diffusion of oxygen into the bloodstream and carbon dioxide out of the bloodstream can occur across this membrane.
• The alveoli secrete a moist substance that allows gases to dissolve and move between capillaries and the air in the alveoli.
• The alveoli of human lungs have an extremely large surface area, which enables more gas to diffuse simultaneously. The volume of the lungs of an adult human is approximately 4 lit res, and the surface area is around 100 square metres, about the size of two classrooms or a small Australian house. The very high surface area-to-volume ratio of the lungs allows enough gas exchange to occur to support the growth of a large body in mammals.
Air drawn in
Ribs raised Rib Trachea
Lungs expand
Diaphragm depressed
Contracted muscle of diaphragm Inhalation
Ribs return
Air expelled
Spine
Lungs return to original volume
Diaphragm relaxes and returns to its domed shape
Relaxed muscle of diaphragm
Exhalation
FIGURE 2 Ventilation of the lungs is controlled by contraction and relaxation of the diaphragm, which changes lung volume and pressure.
An inhalation of air is caused by the contraction and flattening of the muscle of the diaphragm, which increases the volume of the ribcage. The increase in volume reduces the pressure within the lungs compared to the external air pressure, which causes air to flow into the lungs. Air in the inhaled breath brings oxygen to the alveoli for diffusion into the bloodstream.
An exhalation occurs when the muscles of the diaphragm relax, causing it to return to its resting dome-shaped position, which reduces the volume of the ribcage, forcing air out of the lungs. Carbon dioxide in the blood diffuses from the capillaries surrounding the alveoli into the lungs and is removed from the body with the exhaled air.
diaphragm
a sheet-like structure of muscle and connective tissue located between the lungs and the abdomen
trachea a tube that moves air from the mouth and nose to the lungs; also known as the windpipe bronchi the branches of the trachea that direct air to each lung; singular “bronchus”
bronchioles the branches of tube between the bronchi and alveoli in the lungs alveoli
small, thin-walled air sacs in the lungs that allow inhaled oxygen to enter the bloodstream and carbon dioxide to leave the bloodstream; singular “alveolus”
inhalation the movement of air into the lungs, caused by contraction of the diaphragm
exhalation the movement of air out of the lungs, caused by relaxation of the diaphragm
Most people can hold their breath for around 15 seconds before feeling a strong urge to take a breath. This urge is the brain’s response to rising carbon dioxide levels in the bloodstream, which, if allowed to build up, would cause the blood to become dangerously acidic. Interestingly, after 15 seconds, there is still sufficient oxygen in the bloodstream to supply the cells of the body, and carbon dioxide concentrations have not yet reached a dangerous level. To hold their breath for long periods, free-divers practise ignoring the urge to take a breath. They spend many months increasing their tolerance of the discomfort of this urge, until they are able to hold their breath for up to several minutes. The current record for the longest time under water after taking only one breath is 24 mi nutes and 37 seconds. Extended breath holding and free-diving are extreme sports, with participants risking side-effects such as collapsed lungs and blackouts under water, which can cause death by drowning.
Apply your understanding
1 Describe the process that causes a decrease in oxygen and an increase in carbon dioxide concentrations in the bloodstream of a free-diver. (1 mark)
2 P redict the changes in gas concentration gradients between the alveoli and the bloodstream in the lungs during a free-dive. (2 marks)

Check your learning 8.1
Check Your Learning 8.1: Complete these questions online or in your workbook.
Retrieval and comprehension
1 Identify the two main functions of the respiratory system. (2 marks)
2 Describe three characteristics of the alveoli that allow efficient gas exchange. (3 marks)
3 E xplain how the diaphragm controls inhalation and exhalation of air by the lungs. (4 marks)
4 E xplain how the position of the heart between the lungs improves the efficiency of gas exchange. (2 marks)
→ Oxygen is transported from the lungs to the body’s cells for aerobic respiration, primarily by binding to haemoglobin in red blood cells.
→ The concentration gradient of oxygen between oxygenated blood and respiring cells that are using oxygen causes the oxygen to be released from the haemoglobin and used by the cell.
→ Aerobic and anaerobic respiration in cells produce carbon dioxide as waste. The carbon dioxide is transported to the lungs in the bloodstream, dissolved in water and in plasma, and bound to haemoglobin.
→ The concentration gradient of carbon dioxide between deoxygenated blood and the alveoli in the lungs causes the carbon dioxide to diffuse across the thin membrane for removal from the body.
Cells require oxygen and glucose to produce energy in the form of ATP through aerobic respiration. When oxygen is limited, cells revert to anaerobic respiration, which is a much less efficient means of producing ATP.
Oxygen diffuses from the alveoli into capillaries, where it binds with haemoglobin proteins in red blood cells. Haemoglobin has a high affinity for oxygen, binding more readily to oxygen in higher concentrations and then releasing the bond when surrounding oxygen concentrations are low. This allows haemoglobin to transport oxygen from the lungs where oxygen concentration is high, to respiring cells where oxygen concentrations are low. Haemoglobin in red blood cells effectively “picks up” oxygen in the lungs, where it is plentiful, and “drops it off” to cells that are rapidly using oxygen for aerobic respiration.
Carbon dioxide is a waste product of aerobic and anaerobic respiration in cells. If carbon dioxide builds up in the body, it creates an acidic environment that disrupts homeostasis and normal metabolic function. Therefore, it is essential that carbon dioxide waste is efficiently transported to the lungs and removed via exhalation. Carbon dioxide is transported in the bloodstream primarily dissolved in water as carbonic acid , with small amounts transported in plasma and bound to haemoglobin. When deoxygenated blood with high levels of carbon dioxide reaches the lungs, the carbon dioxide diffuses from the bloodstream into the alveoli and haemoglobin becomes available for binding to oxygen. Increases in carbon dioxide concentration in the blood are detected by the medulla in the brain, which then triggers the diaphragm to contract, causing an inhalation so that gas exchange can continue and maintain homeostasis.
Learning intentions and success criteria
haemoglobin a protein in red blood cells that binds to oxygen for transport around the body affinity the extent to which a substance tends to bind or attach to another homeostasis the process by which living organisms maintain an internally stable environment
carbonic acid a type of acid produced when carbon dioxide is dissolved in a solution; lowers the pH of the blood
medulla the part of the brain that coordinates aspects of respiration
Figure 1 shows how gas exchange occurs between the bloodstream and the alveoli. Practise drawing a simplified diagram of this process. Include the names and direction of movement of the gases and blood flow.

Bronchiole Pulmonary artery
Pulmonary vein




Alveoli



Capillary and alveolar lining is only one cell thick to allow di usion of gases.
Moist inner lining allows gases to dissolve.
O2 di uses from the lungs into the bloodstream.
Oxygen binds to haemoglobin molecules in red blood cells.
































Deoxygenated blood from pulmonary artery enters.
Haemoglobin in red blood cells releases carbon dioxide.






















Air flow























Terminal bronchiole









Respiratory bronchiole









Capillary network around alveolus






Oxygenated blood is sent to the pulmonary vein.
CO2 di uses from the bloodstream to the lungs.







Science inquiry skill: identify the types of errors, extraneous variables or confounding factors that are likely to influence results and implement strategies to minimise systematic and random error
Biology 2025 v1.0 General Senior Syllabus © State of Queensland (QCAA) 2025
A medical scientist is measuring the lung capacity of several patients from a local doctor’s clinic. Some are heavy smokers, and some have never smoked. Two measurements are taken: the forced vital capacity (FVC) and the forced expiratory volume over 1 second (FEV1).
• FVC is the amount of air that can be forcibly exhaled from the lungs after a deep breath. This is close to the capacity of the lungs.
• FEV1 is the volume of air that can be forcibly blown out in the first 1 second, after a deep breath. The results are shown in Table 1. Patient
#1
1 The medical scientist is surprised to find that some non-smoking patients’ FVC and FEV1 measurements are lower than those of the smoking patients. Describe two extraneous variables that are likely to have affected the validity of the results in this study. (2 marks)
2 Based on your answer to Question 1, suggest one thing the doctor should specify to improve the experimental design when recruiting patients to join the study. (1 mark)
3 Suggest what steps could be taken during the analysis of the data to clarify any trends for smokers/non-smokers. (2 marks)
Need help identifying extraneous variables? Go to Lesson 1.X in your biology toolkit.
Male, 36 yo #2
Male, 41 yo
Female, 19 yo
Female, 35 yo
Babies use their lungs for the first time after taking their first breath. Before this, all the oxygen required by a baby’s cells for rapid growth and development must come from their mother. The placenta is the structure where the blood vessels of the mother and the developing foetus meet and exchange nutrients and gases, including oxygen and carbon dioxide, by diffusion. Foetal red blood cells have a special type of haemoglobin, called foetal haemoglobin, that is only produced during development in utero. Foetal haemoglobin has an even higher affinity for oxygen
than the haemoglobin of the mother, allowing it to “pull” oxygen away from the mother’s bloodstream to that of the foetus.
1 Muscle cells also contain slightly different haemoglobin, called myoglobin. Myoglobin has a higher affinity for oxygen. Using your knowledge of the function of foetal haemoglobin, infer why muscle cells produce this type of haemoglobin. (1 mark)
P redict the changes that would occur in the body of a pregnant female to support the increased demand for production of oxygen and elimination of carbon dioxide waste during pregnancy. (2 marks)
Challenge
Ain’t no mountain high enough
Humans are adapted to survive above sea level, where oxygen in the air is just over 20%. However, in high-altitude areas like the Andes Mountains in South America or the Plateau of Tibet in Asia, the oxygen concentration in the air is as low as 13%. Mountaineers from lowland areas venturing into these terrains often experience the effects of hypoxia (oxygen deprivation). Amazingly, Andean and Tibetan highlanders have adapted to live and thrive in these conditions. For example, Andean highlanders have, on average, much higher concentrations of haemoglobin in their blood. Additionally, Tibetan highlanders and some Andeans possess the EPAS1 gene, which improves the
Check your learning 8.2


efficiency of haemoglobin use in the body.
1 Use your understanding of the respiratory system to explain how adaptations in Andean and Tibetan highlanders have enabled them to avoid hypoxia in high-altitude conditions. (2 marks)
Check Your Learning 8.2: Complete these questions online or in your workbook.
Retrieval and comprehension
1 E xplain how each of the following is carried in red blood cells:
a oxygen (2 marks)
b carbon dioxide. (2 marks)
2 Identify the factors contributing to the following:
a loss of carbon dioxide and uptake of oxygen at the capillary beds of the lungs (2 marks)
b release of oxygen from haemoglobin at the tissues. (2 marks)
3 E xplain why it is important for oxygen to be transported around the body. (4 marks)
4 E xplain why the average person cannot hold their breath under water for more than 2 mi nutes. (3 marks)
Knowledge utilisation
5 Discuss why it is essential that foetal haemoglobin has a higher affinity for oxygen than adult haemoglobin. (3 marks)
• The main organs of the mammalian gas exchange system are the nose, mouth, pharynx, trachea, bronchi and lungs.
• Inhalation and exhalation of air into and out of the lungs is controlled by movement of the diaphragm.
• Alveoli allow passage of gases between the bloodstream and inhaled air because alveoli are thin and moist, and have a large surface area.
• Oxygen is transported from the lungs to the body’s cells for aerobic respiration primarily by binding to haemoglobin in red blood cells.
• The concentration gradient of oxygen between oxygenated blood and respiring cells that are using oxygen causes the oxygen to be released from the haemoglobin and used by the cell.
• Aerobic and anaerobic respiration in cells produces carbon dioxide as waste. The carbon dioxide is transported to the lungs in the bloodstream dissolved in water and in plasma, and bound to haemoglobin.
• The concentration gradient of carbon dioxide between deoxygenated blood and the alveoli in the lungs causes the carbon dioxide to diffuse across the thin membrane for removal from the body.
Review questions: Complete these questions online or in your workbook.
1 Alveoli exchange gas efficiently because they have
A a large surface area, thin walls and high oxygen levels.
B a small surface area, thin walls and high oxygen levels.
C a small surface area, moist lining and high oxygen levels.
D a large surface area, thin walls and a moist lining.
2 The structure responsible for changing the pressure in the lungs, allowing ventilation, is the
A diaphragm.
B lungs. C trachea. D alveoli.
3 The structure that allows passage of inhaled air into the lungs is the
A diaphragm.
B bronchi. C trachea. D alveoli.
4 Anaerobic respiration
A is more efficient than aerobic respiration.
B is less efficient than aerobic respiration.
C occurs only in plants.
D produces oxygen as a waste product.
5 Select the correct pathway of air from the external environment to the lungs.
A mouth/nose → pharynx → larynx → trachea → bronchioles → bronchus → alveoli
B mouth/nose → larynx → pharynx → trachea → bronchus → bronchioles → alveoli
C mouth/nose → pharynx → larynx → trachea → bronchus → bronchioles → alveoli
D mouth/nose → trachea → pharynx → larynx → bronchus → bronchioles → alveoli
Review questions: Complete these questions online or in your workbook.
Retrieval and comprehension
6 E xplain how oxygen is transported from the alveoli to respiring cells. (4 marks)
7 E xplain how carbon dioxide is transported from respiring cells to the alveoli. (4 marks)
Predicting direction and speed of gas exchange
Tables 1 and 2 show concentrations of gases in different locations within the body, with partial pressure (mmHg) as the unit of measurement. Using this information, it is possible to determine the concentration gradient of each gas and therefore predict its direction of movement. Remember: movement of gas occurs from an area of high concentration to an area of low concentration until equilibrium is reached.
TABLE 1
Analytical processes
8 Babies growing in the womb have a different type of haemoglobin, called foetal hemoglobin, which has a higher affinity for oxygen than the haemoglobin of the mother. Infer why babies might need this different type of haemoglobin before they are born. (3 marks)
understanding
1 Identify whether the information in Table 2 represents gas exchange at an aerobically respiring cell or in the lungs. Use the data to support your response. (2 marks)
Analyse data
2 Infer the relative rates of oxygen and carbon dioxide diffusion in Table 1. (2 marks)
Interpret evidence
3 Use the data in Table 1 to predict the direction of movement of oxygen and carbon dioxide between the respiring cell and the capillary. (1 mark)
4 Use your knowledge of gas exchange within the body to infer which parts of the body are represented by Site A and Site B in Table 2. (2 marks)
TABLE 2

Plants are the most abundant life forms on Earth, making up 80% of all biomass. All other multicellular organisms rely on plants directly or indirectly as a source of energy and oxygen. Through photosynthesis, plants use carbon dioxide and water to produce energy stored in the bonds of glucose, and oxygen gas as waste. Because plants are largely immobile, they must adapt to the conditions of their environment to obtain sufficient water and nutrients to photosynthesise, grow and reproduce. The transport systems of plants include xylem to transport water from roots to leaves, and phloem to transport organic molecules such as glucose around the plant. Plants have specialised leaf structures, called stomata, that allow exchange of gases and movement of water into the surrounding air.
Check your understanding of concepts related to plant physiology before you start. Prior knowledge quiz
→ Describe the process of photosynthesis, identifying the location in the cell and net inputs and outputs of – light-dependent reactions – light-independent reactions – the overall reaction (6CO2 + 6H 2O + light energy → C6 H12O6 + 6O2).
→ Compare the structure and function of xylem and phloem tissues.
→ Explain how stomata and guard cells facilitate gas exchange in plants.
→ Interpret and explain data from an experiment investigating the effect of light intensity, temperature, wind or humidity on the rate of transpiration.
→ Investigate
– factors affecting the rate of transpiration in different plants. – adaptations that allow for efficient nutrient and/or gas exchange in plants or animals.
Modified from Biology 2025 v1.0 General Senior Syllabus © State of Queensland (QCAA) 2025

These lessons are available exclusively on Oxford Digital.
Lesson 9.3 Stomatal function
Lesson 9.5 The passage of water through flowering plants
Lesson 9.6 Factors affecting the rate of transpiration
→ Photosynthesis can be simply expressed in a chemical equation, with carbon dioxide and water as reactants and glucose and oxygen as products.
→ Chloroplasts are organelles in which photosynthesis occurs, allowing energy from sunlight to be stored in the bonds of glucose.
→ Photosynthesis has two stages: a light-dependent stage and a light-independent stage.
→ The rate of photosynthesis is affected by the availability of reactants and the intensity of sunlight.
Learning intentions and success criteria
photosynthesis the series of reactions that converts light energy into chemical energy in the form of glucose; summarised as 6CO2 + 6H 2O + light energy →
C6H12O6 + 6O2
Photosynthesis is a series of enzyme-mediated chemical reactions that plants, algae and some bacteria use to produce glucose. Photosynthetic organisms are autotrophs because they make their own food, whereas heterotrophs obtain their food by consuming other organisms. Photosynthesis occurs in specialised organelles called chloroplasts, which use carbon dioxide and water to produce glucose for respiration, and release oxygen gas as a waste product. Photosynthesis occurs in a series of separate reactions but the overall reaction showing reactants and products can be given as a balanced chemical equation:
producer an organism that produces its own energy by absorbing light energy and converting it into a usable form; also known as an autotroph consumer (heterotroph) an organism that must consume other living organisms for energy; also known as a heterotroph
Through photosynthesis, the inorganic compounds of carbon dioxide and water are used to make glucose, the organic molecule required for cellular respiration, which produces energy for living organisms. During photosynthesis, light energy is converted to chemical energy (glucose molecules) by producers. Other metabolic processes convert these simple carbohydrates to all the other organic compounds required by living organisms. These organic compounds are then passed on to consumers and decomposers through the food web. The raw materials for photosynthesis are carbon dioxide and water.

Chloroplasts are membrane-bound organelles in photosynthetic cells. Within each chloroplast, a liquid solution called the stroma encloses stacks of flattened, coin-shaped discs called grana (singular “granum”). An individual disc is called a thylakoid . Chloroplasts also
decomposer an organism that breaks down dead and decaying matter for energy
stroma the colourless fluid contained within a chloroplast that surrounds the grana and contains enzymes used in the lightdependent reaction of photosynthesis
grana a stack of thylakoids found within chloroplasts; surrounded by the stroma; a single stack is a “granum”
thylakoid membrane-bound, disc-shaped structures found in chloroplasts; the site of the lightdependent reactions of photosynthesis
chlorophyll
a pigment molecule that allows plants to convert radiation in sunlight to glucose as an energy source
photosystem I
a structure made of proteins containing chlorophyll; located in the thylakoid membrane in chloroplasts; facilitates production of NADPH from NADP+
photosystem II
a structure made of proteins containing chlorophyll; located in the thylakoid membrane in chloroplasts; facilitates photolysis of water to produce oxygen gas and hydrogen ions
light-dependent reactions
the first stage of photosynthesis, in which light energy is converted into ATP and NADPH
light-independent reactions the second stage of photosynthesis, in which ATP and NADPH are used to convert CO2 into glucose
photon a packet of energy in sunlight that can excite electrons
photolysis the process of light energy breaking the bonds between atoms in molecules
contain chlorophyll , a pigment necessary for the energy transformations of photosynthesis, although it is not used up in the process. Organisms that have chlorophyll in their cells include green plants, algae, cyanobacteria and some bacteria. In plants, most photosynthesis occurs in leaf cells that are exposed to light. Depending on the environment in which the plant lives, different adaptations of leaf structure and their arrangement on stems have evolved to maximise their ability to “capture” light.
Outer membrane of chloroplast
Inner membrane
Stacks of thylakoids containing chlorophyll (grana) Interconnected grana
FIGURE 2 The structure of a chloroplast: (A) cut-away view (B) transverse section
grain
Certain sites within the chloroplast also contain integral membrane protein complexes, such as photosystem I and photosystem II. These protein complexes play specific roles in facilitating parts of the overall photosynthesis reaction. Photosystem I is located on the outer surface of the thylakoid membrane, and photosystem II on the inner surface of the membrane. Photosystems I and II contain chlorophyll molecules, which allow energy from sunlight to be accessed and used in reactions. The grana are connected by structures called stromal lamellae, which ensure that the stacks of thylakoids do not clump together, maximising the rate of photosynthesis. Glucose produced by photosynthesis is stored as starch in the stroma of the chloroplasts.
Because the reactions of photosynthesis are enzyme-mediated, the rate of these reactions is influenced by temperature. Carbon dioxide is readily available in most terrestrial and aquatic environments on Earth, and so carbon dioxide concentration does not usually limit the rate of photosynthesis. The most important factor affecting the rate of photosynthesis in most environments is light intensity and availability. Photosynthesis consists of two stages: the light-dependent reactions and the light-independent reactions
Light-dependent reactions
The light-dependent reactions are the first stage of photosynthesis. They can only occur in the presence of sunlight, and they take place in the thylakoid. They are triggered when ultraviolet radiation in the form of sunlight penetrates the plant’s cells and interacts with chlorophyll-containing proteins in the thylakoid membrane. This sets off a series of reactions, which can be summarised as follows:
1 Photons from sunlight excite electrons in the chlorophyll molecules of photosystem II.
2 These excited electrons have enough energy to split water molecules into molecules of oxygen (O2) and hydrogen ions (H+), in a process called photolysis
3 The oxygen molecules produced are either used in aerobic respiration or released through stomata into the environment as waste.
4 Photons from sunlight excite electrons in the chlorophyll molecules of photosystem I.
5 Some of these excited electrons allow NADP+ to bond with hydrogen ions to form NADPH for use in the light-independent reaction, while some move into the thylakoid membrane.
6 Hydrogen ions that move into the thylakoid membrane build up to form a concentration gradient, which allows ATP to be produced from ADP.
TABLE 1 Summary of light-dependent reactions
Stage
reactions
membranes of chloroplast
Light-independent reactions
After the light-dependent reactions have occurred, their products, ATP and NADPH, are used as inputs to trigger a series of light-independent reactions. Light-independent reactions enable the breaking down of carbon dioxide molecules, which are then used to construct glucose molecules. These reactions, also known as the Calvin cycle, occur in chloroplasts, in the stroma surrounding the thylakoids. They do not require light as an input. They can be summarised as follows:
1 ATP and NADPH molecules produced by the light-dependent reaction are released from the thylakoid membrane into the stroma of the chloroplast.
2 Enzymes floating in the stroma, such as RuBisCO, break carbon dioxide into carbon and oxygen and reassemble the carbon atoms in several stages to produce glucose.
3 The enzymes that construct glucose from carbon, hydrogen and oxygen use energy from ATP and NADPH, allowing them to occur without energy from sunlight.
TABLE 2 Summary of light-independent reactions




RuBisCO an essential enzyme in photosynthesis; catalyses carbon fixation and oxygenation
The reactants in the chemical reaction of photosynthesis are carbon dioxide and water; the products are glucose and oxygen. Chlorophyll and sunlight are often represented in the word equation; however, they are not reactants or products. Sunlight is the source of energy for the reaction, and chlorophylls are pigments that facilitate the reaction but are not used up in the process.
abiotic factors
non-living environmental factors, such as sunlight, temperature and water availability
Photosynthesis is a series of reactions that require a variety of reactants and abiotic factors to complete its processes optimally. Carbon dioxide gas and liquid water must be present, as they are the reactants for the chemical reactions. The carbon dioxide concentration of Earth’s atmosphere is more than sufficient for photosynthesis. Because of its abundance, carbon dioxide is not considered a factor that affects the rate of photosynthesis. The availability of water, on the other hand, varies over time and in different areas on Earth.
Photosynthetic organisms that live in dry environments are adapted to low water availability and have specialised structures that allow them to produce glucose through photosynthesis with limited water. Species that are not adapted to dry conditions struggle to produce sufficient glucose for their metabolic needs during times of drought, resulting in slow growth, reduced reproduction, or death of the organism.
xylem vessels that transport water and dissolved minerals from the roots of a plant to the leaves, allowing the passage of water upwards through the plant in the transpiration stream
transpiration stream the stream of water that enters the plant from the soil into the roots and travels through the xylem before evaporating through the stomata
stomata openings created by guard cells in the leaf of a plant; allow gas exchange and water evaporation from the transpiration stream; singular “stoma”
The temperature of air, water and soil influences the rate of photosynthesis in a variety of ways. In plants, water to be transported in the xylem must be in a liquid state. This means that temperatures below freezing or above boiling will prevent photosynthesis. Water at the top of the transpiration stream evaporates through the stomata , and this exerts a transpirational pull. Higher temperatures cause the water to evaporate faster through the stomata, and so the volume of water moving through the xylem increases. This increases the availability of water to chloroplasts for photolysis and increases the rate of photosynthesis. Because photosynthesis is a series of enzyme-mediated reactions, temperatures that exceed the maximum tolerance of the enzymes will cause the rate of photosynthesis to slow and eventually stop, if the high temperatures cause the enzymes to denature.
Energy travelling into chloroplasts in the form of photons allows the light-dependent reactions to occur. Therefore, when light intensity is low, the rate of the light-dependent reactions is lower. When light intensity is high, the rate of the light-dependent reactions is higher. Photosynthetic organisms that live in low-light environments, such as the deep ocean and the rainforest floor, have adapted by developing more chloroplasts in their cells. This allows them to produce sufficient glucose for their metabolic needs in areas where little energy from the Sun’s radiation is available.
Chlorophylls are pigment molecules that allow plants to transform radiation in sunlight to energy stored in the bonds of glucose, which can then be used as an energy source. There are several types of chlorophyll. Each type absorbs and reflects different wavelengths of light, which determines the colour that the leaves of plants appear to the human eye. The wavelengths absorbed by the chlorophyll pigments chlorophyll a, chlorophyll b, beta-carotene and xanthophyll are shown in Figure 4. Wavelengths absorbed by the pigments show a higher absorption, while wavelengths reflected by the pigments show low absorption.
spectra of chloroplast pigments
FIGURE 4 Absorption spectra of chloroplast pigments
1 Determine which pigment would appear most red in colour. (1 mark)
2 P redict which pigment would appear darkest green in colour. Justify your prediction, using wavelength absorption. (2 marks)
3 The leaves of plants come in many shades of green. Use your knowledge of chlorophyll pigments to suggest why there is so much variation in colour between plants. (2 marks)
Most chlorophyll molecules absorb red and blue wavelengths of light and reflect green wavelengths, giving plants their green appearance. On the rainforest floor, not only is there little light available but light wavelengths are predominantly green, having been filtered through many layers of the rainforest already. Some plants have evolved with a solution that allows them to photosynthesise enough glucose to grow and reproduce. Some begonias living in extreme shade on the floor of rainforests have modified thylakoids that maximise light absorption and are able to absorb green wavelengths. This structural adaptation also gives the leaves a beautiful iridescent blue colour.
Apply your understanding
1 I nfer why plants with blue leaves do not grow in arid environments.

5 An iridescent blue begonia leaf
2 P redict what would happen to a begonia with blue leaves if it was moved from the rainforest floor to a suburban Australian backyard. Check Your Learning 9.1: Complete these questions online or in your workbook.
Retrieval and comprehension
1 Describe the light-independent reaction of photosynthesis, including detail on the structures involved and their locations within the chloroplast. (4 marks)
2 Identify the site, inputs and outputs of lightindependent reactions. (3 marks)
3 Identify three abiotic factors that affect the rate of photosynthesis. Explain one way each factor slows or accelerates photosynthesis. (6 marks)
Analytical processes
4 Roberto is revising for a biology test and has written the equation below to summarise the process of photosynthesis. Identify the errors in Roberto’s equation and write the correct equation for photosynthesis. (2 marks) 6CO 2 + 12HO ⟶ chlorophyll sunlight 2C 6 H 12 O 6 + 6H 2 O
Knowledge utilisation
5 P redict what would happen to a plant that floats on the surface of water, such as a lily, if it had stomata on the underside of its leaves. (2 marks)
Learning intentions and success criteria
→ Plants take in carbon dioxide and release oxygen through the stomata in their leaves.
→ Guard cells respond to environmental conditions to control the opening and closing of stomata.
→ Adaptations for improving the efficiency of gas exchange and minimising water loss allow plants to thrive in a variety of extreme environmental conditions.
Plants produce energy for cellular growth and maintenance through cellular respiration. Like animals, plants yield more ATP through aerobic respiration than anaerobic respiration. Because oxygen is a product of photosynthesis, plants have a ready supply of oxygen available for aerobic respiration. The volume of gas exchange by plants during respiration is much smaller than that exchanged by animals. Because the volume of gas to be exchanged is smaller, plants can meet their respiration needs through direct diffusion with the surrounding air, avoiding the need for a specialised respiratory system like that of animals. The site of gas exchange in plants is the leaves, specifically in structures called stomata.
guard cells
a pair of specialised cells in the epidermis of leaves that control gas exchange in plants by opening and closing stomata
abscisic acid
a plant hormone that regulates plant growth, development and stress responses
Stomata (singular “stoma”) are openings in the epidermal layers of leaves. They are created by specialised cells, called guard cells, which work together to open and close the stomata. When stomata are open, gases can diffuse freely between the environment and the inside of the leaf. Open stomata also allow water to evaporate out from the plant, which continues the transpiration stream and promotes the movement of water through the xylem. When stomata are closed, water is retained in the plant but carbon dioxide can no longer move in and oxygen can no longer move out. In this way, the opening and closing of stomata allows the plant to respond to environmental pressures such as low water availability.

Guard cells differ from the surrounding leaf epidermal cells because they contain a high number of chloroplasts. This allows them to rapidly photosynthesise and produce large amounts of glucose. Guard cells require a high concentration of chloroplasts to facilitate the opening and closing of stomata in response to water availability. When the sun rises, chloroplasts start producing glucose via photosynthesis. The guard cells then become concentrated in glucose, which triggers responses by enzymes and molecules, such as abscisic acid , to open and close ion channels that mediate the balance between carbon dioxide intake and water loss. When water flows into guard cells, they inflate and bend, which causes the stomata to open.
When stomata are open, carbon dioxide can diffuse into chloroplasts and sunlight can power the light-dependent reactions of photosynthesis. As sunlight intensity decreases in the afternoon, the rate of photosynthesis slows, until it stops at sunset. While photosynthesis stops overnight, cellular respiration must continue, to allow the cells of the plant to survive. Therefore, the net products of gas exchange are reversed at night: the plant continues to take in oxygen for cellular respiration and release carbon dioxide as waste through the stomata. It does not produce oxygen, because photosynthesis is not occurring. Because plants are mostly stationary, they do not require energy to move, in the way that animals do. Therefore, their demands for gas exchange are lower and can be met solely through stomatal diffusion.
FIGURE 2 (A) The structure of guard cells (B) Open and closed guard cells on a leaf surface. The stoma opens when the guard cells are filled with water and rigid. The stoma closes when the guard cells do not contain much water and are flaccid.
Stomata are sensitive to water availability. They open when there is enough water available for the guard cells to be turgid (swollen) and close when the guard cells lose water and become flaccid (soft and limp). This means that when outside temperatures are high and cause water in the external environment and on the surface of a plant’s leaves to evaporate, the guard cells lose water and the stomata close. This opening and closing mechanism ensures that when water availability is low (e.g. during high temperatures or dry conditions), the closing of the stomata prevents water loss.
All plants need reliable gas exchange for growth, maintenance and reproduction. However, the gas exchange structures of plants can vary greatly between species. This is because plants have developed adaptations to survive the environmental conditions of their specific habitats. For example, plants that float on the surface of water, such as water lilies, have a constant supply of water but all their stomata must be located on the upper surface of their leaves to allow gaseous carbon dioxide to enter the leaf.
Arid environments are sparsely vegetated, allowing sunlight to bring an unlimited source of energy to plants for photosynthesis. The heat accompanying the sunlight increases the rate of transpiration in plants, leading to water loss. Because arid plants are not limited by light availability or intensity, they have smaller leaves with fewer stomata, to reduce water loss. Rainforest ecosystems have abundant water and carbon dioxide but light intensity is limited in the shady understorey, so the plants need adaptations that will enable them to capture light to power photosynthesis. Plants living in low-light conditions have large leaves to increase the sunlight absorbed, to facilitate photosynthesis.



3 Environmental conditions vary greatly in Australia and plants have adapted to survive these conditions. (A) Stomata in the gigantic water lily are only on the upper surface of leaves. (B) Sturt’s desert pea has smaller leaves with fewer stomata, so the plant can survive in arid environments. (C) The spoon lily has large leaves, to capture light in rainforests.
Cacti, pineapples and other xerophytes have adapted their photosynthetic cycles using a process called crassulacean acid metabolism (CAM). CAM plants live in extreme environmental conditions that place them under water stress. To minimise water loss, CAM plants have several interesting mechanisms. While the opening of stomata is essential for carbon dioxide intake, it also allows water to evaporate from the transpiration stream. CAM plants overcome this problem by fixing carbon dioxide from the environment at night, when the stomata are open and cooler conditions reduce water loss. The carbon dioxide is dissolved in water and stored within the leaves until morning, when sunlight can facilitate the rest of the light-dependent reaction. As xerophyte a plant with adaptations that allow it to function with little water
a result of this delayed cycle, CAM plants are often smaller and grow more slowly than plants that do not delay any stage of photosynthesis. The fruit of CAM plants, such as pineapples, taste more acidic at night due to the storage of carbon dioxide, and sweeter during the day when more glucose is produced.
1 I nfer which organelle in a plant cell would be suitable for carbon dioxide storage overnight in CAM plants.
2 E xplain the challenges for a cactus that is used as an indoor plant in a northern European climate. Suggest how humans could change the environment of the cactus to overcome these challenges.

4 A pineapple picked at night will taste sourer than one picked during the day.
Retrieval and comprehension
1 Identify which gases are exchanged by plants. Describe the direction of movement of each type of gas through the stomata of plants. (4 marks)
2 Describe the processes that cause the opening and closing of stomata. (4 marks)
3 E xplain how plants can survive without complex respiratory structures like lungs for gas exchange. (4 marks)
Knowledge utilisation
4 Construct a labelled diagram of an open and closed stoma. (4 marks)
5 The mulga tree (Acacia aneura) is common in the hot, dry Australian outback. Its stomata sit slightly lower than the surrounding epidermal cells on its leaves. Infer why sunken stomata allow Acacia aneura to thrive in these harsh conditions. (2 marks)
9.3
This lesson is available exclusively on Oxford Digital. Learning intentions and success criteria
Learning intentions and success criteria
vessel element
pitted, narrow tubes for transporting small amounts of water within the xylem; reinforced with lignin to provide strength
tracheid
the thinnest tubes of xylem for transporting very small amounts of water; unperforated and lignified
lignin
a polymer produced by plant cells to provide strength to xylem cells
xylem fibre
non-living xylem cells that provide strength and support to watercarrying xylem vessels and tracheids; do not transport water themselves
xylem parenchyma
the only living cells of the xylem tissue in plants; transport water and nutrients and store carbohydrates, oils and tannins
Xylem parenchyma
→ Water is transported through plants in one direction, from the roots to the leaves, in a process called transpiration.
→ Transpiration occurs in the xylem vessels, due to root pressure, cohesive forces, adhesive forces and transpiration pull; no ATP energy is required.
Most vascular plants obtain water from the soil and transport it from the roots to other parts of the plant. As most plant structures are located above ground, the plants must work against gravity to transport water to where it is needed – in the leaves and reproductive structures. The transpiration stream is the stream of water and solutes taken up from the roots to the leaves of a plant, where the water will evaporate. The structures that plants use to transport water from their roots to other locations are made up of xylem cells.
A combination of living and dead xylem cells form straw-like tubular structures that allow water to move upwards from the roots to different parts of the plant. This combination of cell types makes the structures robust, which contributes to the structural integrity of the plant as well as acting as a passage for the transport of water.
The hollow tube-like shape of xylem is formed from two cell types: vessel elements and tracheids. Vessel elements are elongated, pipe-shaped cells that stack together to form a tube through which water can flow. The cell walls of vessel elements contain a complex called lignin that improves the structural integrity of the cell. Tracheids are thin, hollow cells that have more lignified cell walls than vessel elements. Tracheids provide sturdiness to a plant’s overall structure and aid in the transport of water and inorganic salts. Vessel elements and tracheids have pitted walls that allow water to diffuse into adjacent cells. Vessel elements are wider than tracheids, and can therefore move more water when it is abundant. Tracheids can move small amounts of water during times of drought. Both cell types, vessel element and tracheid, are dead cells.
Other cell types that make up the xylem are xylem fibres and xylem parenchyma. Xylem fibres are long, lignified fibres found between tracheids and vessel elements. They are made up of dead sclerenchyma cells (cells that provide a plant with stiffness and strength).
Xylem fibres provide support and protection to tracheids and vessel elements, and can transport some water. Xylem parenchyma are the only living cells that make up the xylem. These cells contain a nucleus and cytoplasm, and have thin cell walls so substances can quickly diffuse in and out of cells.
Xylem parenchyma store water and nutrients such as carbohydrates, proteins and oils. They are also able to regenerate in the event of damage to the xylem. Table 1 provides a summary of the cell types that make up the xylem.
TABLE
Cell name
Living/dead Characteristics Function Diagram
Tracheid Dead Lignified, hollow cells with pointed ends Transport small amounts of water
Vessel element Dead Hollow, cylindrical lignified cells stacked on top of each other Transport large amounts of water when available
Xylem fibre Dead Long narrow cells located between tracheids and xylem vessels Provide structure and support; transport some water
Xylem parenchyma
Living Contains a nucleus and cytoplasm; has a thin cell wall to facilitate diffusion
Storage of nutrients and water; can replicate to repair damage to xylem
Cytoplasm
In the xylem, water molecules are attracted to each other through cohesive forces (forces that attract molecules of the same type together). This cohesion between molecules ensures that, when water is pushed by root pressure or pulled by the transpiration stream, the water molecules will pull each other to move in the same direction. Water molecules are also attracted to the walls of xylem through adhesive forces (forces that attract molecules of different types together). The adhesive forces between water molecules and the xylem vessels work to resist the downward pull of gravity and support the continuous upward movement of water in the xylem. Cell types that make up the walls of the xylem (such as vessel elements and tracheids) are elongated and have a large surface area to maximise contact with water. This helps increase the adhesion of water to the xylem walls. Tracheids in particular are very narrow in diameter and allow cohesive and adhesive forces to facilitate transpiration in low water conditions. When water molecules reach the stomatal pores at the top of the transpiration stream, the water evaporates out due to energy from the sun and the diffusion gradient with the outside
cohesive forces the attractive force between molecules allowing them to clump together; in this context the attractive forces between water molecules adhesive forces the attractive force between molecules that are different to each other; in this context the attractive forces between water molecules and the xylem cell walls
air. As the water molecules evaporate and detach from each other, cohesive forces between them exert a pull on the transpiration stream, contributing to the upward movement of water through the xylem.
Cohesion and adhesion in the xylem Transpiration
Water uptake from soil
In summary, water movement through the xylem is driven by:
hair Water molecule
FIGURE 2 Transpiration stream of water in a tree: water moves from the soil into the roots, through the xylem and out through the stomata in the leaves.
• root pressure – pressure from water in the roots prevents the downward movement of water due to gravity
• adhesive forces – adhesion between water molecules and the surfaces of the xylem vessels assists in the upward pull of water against gravity
• cohesive forces – water molecules are attracted to each other, creating a continuous upward stream through the xylem
• stomatal evaporation – at the top of the transpiration stream, water molecules evaporate from liquid water to water vapour in the surrounding air.
Movement of water through the transpiration stream occurs by passive transport, requiring no ATP energy. Water molecules absorb energy from the sun, which causes evaporation. This in combination with cohesive forces, adhesive forces and root pressure allows the water molecules to move through the plant in a constant stream against gravity.
The rate of transpiration, or how quickly water molecules move through the transpiration stream and evaporate from the stomata to the environment, is affected by the level of light, temperature, humidity, wind, and the water content of the soil.
Radiation from sunlight triggers the opening of stomata in most plants, allowing evaporation of water from the top of the transpiration stream.
As temperature increases, the energy of water molecules increases, accelerating evaporation from the top of the transpiration stream.
The diffusion gradient between the water within the intracellular spaces of a leaf and the outside humidity determines the speed of evaporation. Low humidity increases the rate at which water evaporates, while high humidity decreases the diffusion gradient and therefore the rate of evaporation.
Wind increases transpiration by blowing away water vapor from the stomata. This maintains drier air around the stomata, creating a diffusion gradient where water moves from high water concentration in the transpiration stream to the low water concentration of the air in the stomata.
The higher the diffusion gradient between the water in the soil and the roots of a plant, the faster water diffuses across the root membrane. When soil water is low, diffusion to the root slows. Water may even diffuse from the roots to the soil in times of drought. Low soil water reduces root pressure and slows the movement of water through the transpiration stream.
Heat increases transpiration rate
Wind increases transpiration rate
Humidity reduces transpiration rate

Larger leaf surface area and number of stomata increases transpiration rate
Skill drill
Graphing transpiration data
Science inquiry skill: Presenting and analysing data
A researcher wants to determine which of two species of plants has a rate higher of transpiration. They measure the amount of water lost in 100 g of plant tissue from each species each minute for 10 minutes. Their results are given in Table 1.
TABLE 1 Water loss over time for two plant species
Practise your skills
1 Use data from the results table to graph the rate of transpiration of Species A and Species B.
2 Determine which species of plant had a higher rate of transpiration.
3 One of the plant species had a larger number of stomata on its leaves than the other. Infer which plant species this would be and why.
Need help graphing data? Go to Section 1.6 in your psychology toolkit.
Check Your Learning 9.3: Complete these questions online or in your workbook.
Retrieval and comprehension
1 List the factors that affect transpiration of water through xylem vessels. (3 marks)
2 List two abiotic factors that affect the rate of photosynthesis. Explain the way each factor slows or accelerates the rate of photosynthesis. (4 marks)
Check your learning 9.3 Practical Lesson 9.5 The passage of water through
Learning intentions and success criteria
Analytical processes
3 C ompare adhesive forces and cohesive forces. (3 marks)
This lesson is available exclusively on Oxford Digital.
This lesson is available exclusively on Oxford Digital.
→ Phloem is made up of different cell types, each with a specialised structure and function, that all work together.
→ Translocation is the movement of organic substances around a plant according to the needs of each of the plant’s structures.
→ Translocation is a form of active transport, as organic substances can move in any direction including against gravity and concentration gradients.
Phloem is the transport system for organic molecules including glucose, amino acids, and hormones around a plant. Phloem vessels are made up of different specialised cells: sieve elements, phloem fibres and companion cells. These cells have different functions but work together to move organic molecules from the area of production or storage in a plant to the structure that requires them.
Sieve element cells attach to each other end-to-end, forming a long tube that transports cytoplasm containing dissolved organic molecules around the plant. At maturity, sieve elements lose their nucleus and some organelles, but retain their mitochondria, endoplasmic reticulum and starch-storing plastids. This provides space for the flow of large volumes of cytoplasm through the sieve tubes. Phloem fibre cells provide structure and strength to phloem vessels. Their thick cell walls and long, narrow structure allow them to align vertically alongside sieve elements to prevent collapse or damage to the phloem vessel. Companion cells have a high concentration of mitochondria and ribosomes to supplement the sieve elements with ATP energy and proteins required.
Learning intentions and success criteria
Learning intentions and success criteria
phloem vessels within a plant that transport sugar produced by photosynthesis to other parts of the plant; phloem vessels may carry dissolved sugars in any direction within the plant, by active transport (ATP energy)
sieve tube
a transport vessel made up a long chain of sieve elements attached end-to-end at the sieve plate; allows passage of cytoplasm carrying dissolved organic molecules around the plant
phloem fibre a long, thin cell that gives strength and flexibility to phloem companion cell a phloem cell that contains mitochondria to produce ATP energy to supply phloem vessels with energy
Cell name Living/dead Characteristics Function Diagram
Sieve elements Living but without nucleus
Perforated plate at top and bottom; join together to form sieve tube
Transport organic molecules (e.g. sugars) around plant
Sieve plate
Phloem fibres Dead Long, narrow cells with thick cell walls
Companion cells Living Large number of mitochondria and ribosomes
Longitudinal section
Phloem parenchyma cell
Sieve tube
Provide structural strength
Supply sieve elements with ATP energy and proteins
Sieve element
Sieve plate
Transverse section
Glucose moves up to the growing bud.
Water and minerals from soil
Glucose made by photosynthesis
Glucose moves down to the growing root.
cell
Water and minerals are taken up by roots.
FIGURE 2 In the xylem, water moves in one direction, from the roots to the leaves. In the phloem, organic molecules (e.g. glucose) can move in any direction.
Translocation is the movement of organic molecules such as glucose, amino acids and hormones through a plant’s phloem vessels. Unlike the unidirectional movement of water through the xylem, organic molecules in the phloem must be transported in all directions, and this requires ATP energy. Glucose must sometimes be moved against the concentration gradient from where it is produced in the leaves, into phloem vessels that already contain a high concentration of glucose. This movement of molecules from an area low concentration to an area of high concentration against the concentration gradient requires active transport, and therefore uses ATP energy. Once the glucose has moved into the phloem, water moves along the concentration gradient from the xylem to the phloem, creating pressure to allow the flow of dissolved sugars through the phloem to areas of need. Because the leaves of most plants are the primary location of photosynthesis and are at the top of the plant, glucose produced in the leaves must be transported to non-photosynthetic plant structures. Cells in the roots, leaf tips and reproductive structures grow quickly and have a constant demand for the products of photosynthesis delivered through the phloem. Plants also store glucose as starch for future demands, when resources may be limited. For example, potato plants store starch in tubers attached to roots below the ground (Figure 3).

translocation the movement of organic materials around a plant in phloem vessels by active transport
Retrieval and comprehension
1 Describe the structure and function of the three different phloem cell types.
• Photosynthesis can be simply expressed in a chemical equation, with carbon dioxide and water as reactants and glucose and oxygen as products.
• Chloroplasts allow energy from sunlight to be stored in the bonds of glucose via photosynthesis.
• Photosynthesis occurs in two stages: a light-dependent stage and light-independent stage.
• The rate of photosynthesis is affected by the availability of reactants and the intensity of sunlight.
• Plants take in carbon dioxide and release oxygen through the stomata in their leaves.
• Guard cells respond to environmental conditions to control the opening and closing of stomata.
• Adaptations for improving efficiency of gas exchange and minimising water loss allow plants to thrive in a variety of extreme environmental conditions.
• Water is transported through plants in one direction, from the roots to the leaves in a process called transpiration.
• Transpiration occurs in the xylem vessels, due to root pressure, cohesive forces, adhesive forces and transpiration pull; no ATP energy is required.
• Phloem is made up of different cell types, each with a specialised structure and function, that all work together.
• Translocation is the movement of organic substances around a plant according to the needs of each of the plant’s structures.
• Translocation is a form of active transport, as organic substances can move in any direction including against gravity and concentration gradients.
Review questions: Complete these questions online or in your workbook.
1 Autotrophs are
A able to produce their own food.
B always plants.
C consumers.
D the food source for all living things.
2 Photosynthesis occurs in two parts, called
A aerobic and anaerobic reactions.
B light-dependent and light-independent reactions.
C transpiration and translocation.
D xylem and phloem.
3 The reactants of photosynthesis are
A glucose and oxygen.
B carbon dioxide and chlorophyll.
C carbon dioxide and water.
D carbon, oxygen and hydrogen.
4 Guard cells in plants
A join together to form phloem.
B support phloem vessels by providing ATP energy.
C swell and shrink to open and close stomata.
D transport water from the roots to the leaves.
5 Xylem vessels transport
A carbon dioxide out of the plant.
B glucose.
C oxygen out of the plant.
D water.
6 The movement of glucose from the leaves of a plant to the roots for storage is called
A active transport.
B translocation.
C transpiration.
D photosynthesis.
7 Sieve tubes are
A a type of phloem cell.
B a type of xylem cell.
C found in the leaves of plants.
D found in both plants and animals.
8 The rate of transpiration is reduced by
A high humidity.
B low humidity.
C phloem size.
D rate of photosynthesis.
9 Liquid in the xylem vessels can move
A from leaves to the roots only.
B from roots to leaves only.
C in any direction.
D only in the presence of sunlight.
10 Active transport can be used to
A close stomata.
B increase cohesive forces between water molecules.
C increase the rate of transpiration.
D move molecules against a concentration gradient.
11 Xylem cells are able to transport water because
A some xylem cells create the stomatal opening.
B some xylem cells have small hairs.
C some xylem cells are dead and hollow.
D some xylem cells have a high number of mitochondria to produce energy.
Review questions: Complete these questions online or in your workbook.
Retrieval and comprehension
12 Describe the movement of water through the transpiration stream from the soil to evaporation from the leaves. (6 marks)
13 Explain how adhesive and cohesive forces contribute to movement of water through plants. (4 marks)
14 Explain how translocation allows plants to store glucose for long periods of time. (3 marks)
15 Explain why stomata usually close at night. (4 marks)
Analytical processes
16 Contrast xylem and phloem. (4 marks)
Transpiration rate
A researcher conducts a transpiration experiment to compare the rate of transpiration in two plant species. The results of the experiment are shown in the graph.
1 Calculate the rate of transpiration for each plant species. Rate of transpiration can be calculated using the formula: rate of transpiration (mL H 2 O / 50 g / min) = volume of water lost (mL) time taken (min)
Analyse data
2 Identify which plant species had the greater rate of transpiration.
Interpret evidence
3 Infer which plant species is likely to have a greater concentration of stomata.
Question 1
Reactions in which energy is absorbed, new bonds are formed and larger molecules are synthesised can be described as
A anabolic.
B catabolic.
C metabolic.
D photosynthetic.
Question 2
Glycolysis is a stage of cellular respiration that occurs in the
A bloodstream.
B cell cytoplasm.
C Krebs cycle.
D mitochondria.
Question 3
Blood vessels that are permeable to white blood cells and tissue fluid are known as
A arteries.
B capillaries.
C valves.
D veins.
Question 4
Diffusion of gas between the alveoli and the bloodstream relies on
A blood pressure.
B a concentration gradient of gases.
C heart rate.
D red blood cells.
Question 5
The liquid solution inside chloroplasts is known as
A chlorophyll.
B grana.
C stroma.
D thylakoids.
Question 6
The chemical responsible for triggering the closing of stomata is called
A abscisic acid.
B adenosine triphosphate.
C chlorophyll.
D RuBisCO.
Question 7
The only living cell type in the xylem of plants is called a
A tracheid.
B vessel element.
C xylem fibre.
D xylem parenchyma.
Question 8
The cells that provide ATP energy and proteins to other phloem cells are called
A companion cells.
B phloem fibres.
C sieve elements.
D sieve plates.
Question 9
During inhalation, air moves into the lungs while
A the diaphragm contracts and the ribs lower.
B the diaphragm contracts and the ribs raise.
C the diaphragm relaxes and the ribs lower.
D the diaphragm relaxes and the ribs raise.
Which combination of processes demonstrates gas exchange in the lungs?
A Carbon dioxide and oxygen diffuse from the alveoli to the bloodstream.
B Carbon dioxide and oxygen diffuse from the bloodstream to the alveoli.
C Carbon dioxide diffuses from the alveoli to the bloodstream, and oxygen diffuses from the bloodstream to the alveoli.
D Carbon dioxide diffuses from the bloodstream to the alveoli, and oxygen diffuses from the alveoli to the bloodstream.
11
Phosphorylation, the addition of a phosphate group to a molecule, occurs during
A glycolysis.
B photosynthesis.
C the conversion of ADP to ATP.
D the conversion of ATP to ADP.
Question 12
The stage of aerobic respiration that produces the highest yield of ATP is called
A the electron transfer chain.
B lactic acid fermentation.
C glycolysis.
D the Krebs cycle.
Question 1 (6 marks)
The table shows the stages involved in aerobic and anaerobic respiration, and their net ATP production.
13
Which combination of reactants and products represents photosynthesis?
Reactants Products
A carbon dioxide + glucose oxygen + water
B carbon dioxide + water oxygen + glucose
C oxygen + water carbon dioxide + glucose
D oxygen + carbon dioxide glucose + water
Question 14
Photosynthesis is a series of reactions that can best be described as
A anabolic and endothermic.
B anabolic and exothermic.
C catabolic and endothermic.
D catabolic and exothermic.
Glycolysis 2 ATP Krebs cycle 2 ATP
Electron transfer chain 34 ATP
Aerobic respiration Yes Yes Yes
Anaerobic respiration Yes No No
a Calculate the net output of ATP in aerobic respiration. Show your working. (2 marks)
b Contrast the net output of anaerobic and aerobic respiration. (2 marks)
Question 15
Which of the following is an example of an organelle?
A autotroph
B chloroplast
C photosystem II
D thylakoid
c Explain what is meant by “net output of ATP” and what happens to the ATP produced that is not included in this amount. (2 marks)
Question 2 (2 marks)
Identify the reactants and products of photosynthesis.
Question 3 (3 marks)
Describe how the internal membrane of mitochondria is suited to its function.
Question 4 (3 marks)
Explain how adenosine triphosphate transforms into another molecule to produce energy for cells to use.
Question 5 (4 marks)
Describe how haemoglobin’s affinity for oxygen allows it to transfer oxygen from one area of the body to another.
Question 6 (2 marks)
Contrast endothermic and exothermic reactions.
Question 7 (4 marks)
Explain the transformation of energy through photosynthesis.
Question 8 (4 marks)
Describe the process of fermentation.
Question 9 (6 marks)
Compare aerobic respiration and anaerobic respiration, with reference to the type and location of reactions and their inputs and outputs.
Question 10 (5 marks)
Explain the process of human ventilation, with reference to the main organs involved.
Question 11 (5 marks)
Contrast anabolic and catabolic reactions in living organisms, using glucose as an example.
Question 12 (4 marks)
Explain the role of abscisic acid in plants.
Question 13 (3 marks)
Describe the role of thylakoids in photosynthesis.
TOTAL MARKS /66 marks
Part A of the Unit review asks you to reflect on your learning and identify areas in which you need more work.
Module 3: From cell to multicellular organism
Now that you’ve completed your revision for Unit 1, it’s time to learn and practise some of the skills you’ll need to answer exam questions like a pro! To help you, our expert authors have created the following advice and tips to help you maximise your results on the end-of-year examination.
All exam questions have a mark allocation, which can be useful for determining how much detail you need to provide in your responses. This is particularly helpful for “explain” and “describe” questions. Typically, one mark is awarded for each new piece of information that addresses the question. Therefore, an explain question worth 3 marks will require three pieces of information, while an explain question worth 2 marks will only require two pieces of information.
Read the exam question below and see how the tip has made a difference between a response that has scored full marks and a response where marks have been lost.
Mitochondria are organelles that produce energy in the form of ATP using glucose and oxygen through a process called cellular respiration. The inner membrane of the mitochondria is called the cristae and is highly folded. Explain how this feature increases the efficiency of the mitochondria in producing ATP. (3 marks)
1 mark awarded for describing how the folded nature of cristae increases surface area available for movement of reactions.
The folded membrane of the cristae increases the surface area available for movement of reactants across the membrane. The more reactants (oxygen and glucose) that can move into the cristae, the more reactions can occur, increasing the efficiency of the mitochondria in producing ATP for energy.
1 mark for linking explanation of how it increases the e ciency of the mitochondria in producing ATP.
Incomplete response
1 mark awarded for explaining that more reactions can occur if an increased number of reactants enter the cristae.
3 pieces of information have been provided to appropriately address the detail indicated by the mark allocation.
1 mark awarded for describing how the folded nature of cristae increases surface area available for movement of reactants.
Cristae are highly folded, which increases the surface area available for movement of reactants across the membrane.
Only 1 mark awarded as only one piece of information is provided. Information about how increased reactants allow for more reactions and how this improves e ciency is missing.
To maximise your marks on an exam, it can help to think like a QCAA assessor. Consider how many marks each question is worth and what information the assessor is looking for.
A student has given the following response in a practice exam. Imagine you are a QCAA assessor and use the marking guide below to mark the response.
QUESTION 1 (3 marks)
Some animals adapted to life in arid environments have a longer than usual loop of Henle in the kidney. Explain how this
The loop of Henle is the location of water reabsorption from filtrate into the bloodstream. By increasing the distance travelled through the loop of Henle, more water can be reabsorbed from the filtrate into the bloodstream. allows them to minimise water loss while still excreting waste through urine.
Question 1
• Identifies reabsorption of water from the loop of Henle to the bloodstream [1 mark]
• Explains that increased distance travelled by filtrate through the loop of Henle allows for more reabsorption of water into the bloodstream [1 mark]
• Explains how water loss is minimised through retention of water. [1 mark]
Consider where you did and did not award marks in the above response. How could the response be improved? Write your own response to the same question to receive full marks from a QCAA assessor.
The terms “compare” and “contrast” are often used synonymously in everyday language. However, in QCAA exams and assessments, each of these cognitive verbs requires different tasks. Compare questions require you to identify both similarities and differences, while contrast questions require just differences. A compare question that does not identify similarities will result in one mark being lost.
Read the exam question below and see how the tip has made a difference between a response that has scored full marks and a response where marks have been lost.
Compare prokaryotic and eukaryotic cells. (2 marks)
response
1 mark for identifying a similarity.
Both prokaryotic and eukaryotic cells contain ribosomes, genetic material, cytoplasm and plasma membrane. However, eukaryotic cells have membrane-bound organelles, which prokaryotic cells lack.
1 mark for identifying a di erence.
Incomplete response
Response is not awarded full marks, as a similarity has not been identified.
1 mark for identifying a di erence.
Eukaryotic cells have membrane-bound organelles while prokaryotic cells do not.
To maximise your marks on an exam, it can help to think like a QCAA assessor. Consider how many marks each question is worth and what information the assessor is looking for.
A student has given the following response in a practice exam. Imagine you are a QCAA assessor and use the marking guide below to mark the response.
QUESTION 2 (2 marks)
Compare aerobic and anaerobic respiration.
Aerobic respiration occurs in the presence of oxygen while anaerobic respiration occurs in the absence of oxygen.
Marking guide
Question 2
• Identifies a similarity [1 mark]
• Identifies a difference [1 mark]
Consider where you did and did not award marks in the above response. How could the response be improved? Write your own response to the same question to receive full marks from a QCAA assessor.
Students often write responses that contain the correct information and use the right scientific terminology, but they don’t connect concepts together to provide an explanation. If an “explain” question is followed by the word “why” or “how”, your response will need to include a statement that details the specific way in which the thing you are describing results in an outcome or event.
Read the exam question below and see how the tip has made a difference between a response that has scored full marks and a response where marks have been lost. Explain how temperature influences enzyme rate of reaction. (3 marks)
Complete response
1 mark for stating that an increase in temperature increases movement of molecules.
As temperature increases, molecules have more kinetic energy, allowing them to move faster. Faster movement increases the collision rate between enzyme active sites and substrates, allowing for more reactions to occur and increasing the rate of reaction.
1 mark for stating that increased connections between active site and substrate increases rate of reaction.
Incomplete response
1 mark for stating that an increase in temperature increases movement of molecules.
1 mark for making connection between increased movement and collision rate of active site and substrate.
As temperature increases, molecules have more kinetic energy, allowing them to move faster, which increases the rate of the reaction.
Answer not awarded full marks as it does not connect how the faster movement of molecules leads to an increased frequency of collisions between enzyme and substrate and how this results in more reactions taking place, increasing the overall rate of reaction.
To maximise your marks on an exam, it can help to think like a QCAA assessor. Consider how many marks each question is worth and what information the assessor is looking for.
A student has given the following response in a practice exam. Imagine you are a QCAA assessor and use the marking guide below to mark the response.
A researcher was investigating if the presence of oxygen a ects the metabolism of glucose in red blood cells at 37°C. Their results are shown in the table below.
Explain why the results are the same in both conditions (oxygen present and oxygen absent).
Red blood cells can only undergo anaerobic respiration. This means that both conditions will use anaerobic respiration and covert glucose/pyruvate to lactate at the same rate, producing the same result.
Marking guide
Question 3
• Identifies that red blood cells lack mitochondria [1 mark]
• Explains that due to their lack of mitochondria, which is the site of aerobic respiration, red blood cells only use anaerobic respiration [1 mark]
• Explains that both conditions will convert glucose to lactic acid at the same rate, due to red blood cells using anaerobic respiration [1 mark]
Consider where you did and did not award marks in the above response. How could the response be improved? Write your own response to the same question to receive full marks from a QCAA assessor.
Now that you know all these tips, it’s time for you to move on to Part C – Practice exam questions to put them into practice.
Now it’s time to put the tips and advice you’ve learned into practice while you complete these exam-style questions! You will complete two papers as part of your external examination: Paper 1 tests you on multiple-choice and shortresponse questions, and Paper 2 tests you on more complex, multi-part short-response questions.
Multiple-choice
1 What do all living cells have in common?
A All cells have mitochondria.
B All cells have a cell wall.
C All cells have DNA.
D All cells have chloroplasts.
2 A cube-shaped bacterial cell with sides that are 2 µm long would have a simplified surface area-tovolume ratio of
A 3:1.
B 1:3.
C 24:8.
D 3%.
3 What stage of mitosis is shown in the figure below?

A anaphase
B metaphase
C prophase
D telophase
4 Water can be lost from a plant via the stomata on its leaves. To combat loss of water, the guard cells
A fill with water, which cause the stomata to close.
B lose water, which cause the stomata to open.
5 What is the role of amylase in the body?
A to catalyse the breakdown of proteins
B to catalyse the breakdown of carbohydrates
C to catalyse the breakdown of lipids
D to catalyse to breakdown of nucleic acids
6 What is the correct order of processes that take place during aerobic respiration?
A Krebs cycle → glycolysis → electron transport chain
B glycolysis → electron transport chain → Krebs cycle
C glycolysis → Krebs cycle → electron transport chain
D electron transport chain → glycolysis → Krebs cycle
C fill with water, which cause the stomata to open.
D lose water, which cause the stomata to close.
7 What is the product of anaerobic respiration in yeasts and plants?
A ethanol
B carbon dioxide
C ATP
D glucose
8 Identify how the size of a cell typically affects its surface area-to-volume ratio (SA:V).
A The larger the cell, the smaller the SA:V ratio.
B The smaller the cell, the smaller the SA:V ratio.
C The SA:V ratio is not affected by the size of the cell.
D The SA:V ratio is only relevant to prokaryotic cells.
9 Identify the correct structure of a phospholipid molecule.
Polar hydrophilic head
Non-polar hydrophobic tail
Polar hydrophobic head
Non-polar hydrophilic tail
Non-polar hydrophilic head
Polar hydrophobic tail D
Polar hydrophilic tail
Non-polar hydrophobic head
10 Choose the correct terms to complete this statement: “Water and minerals travel through the of a plant, while glucose travels through the .”
A phloem, xylem
B stoma, xylem
C xylem, phloem
D sieve tube, support cells
11 Which of the following best describes the lockand-key model?
A The enzyme and substrate are modified to fit together.
B The enzyme is used up during the reaction.
C The enzyme and substrate fit together almost perfectly with no modifications.
D The activity of an enzyme increases with temperature.
12 Identify the term used for the transport of water across a membrane.
A facilitated diffusion
B osmosis
C active transport
D phagocytosis
13 Tissue culture is a laboratory technique in which cells from living things are grown artificially in a nutrient medium (a solution containing all the nutrients cells need to survive). In plant tissue culture, stem tissue from a plant can be placed into a nutrient medium and grows into a new plant, with the cells of the plant multiplying and differentiating into the various tissue types. Identify the term used to describe this form of development.
A totipotent
B pluripotent
C unipotent
D embryonic
14 Which one of the following statements is true?
A Arteries have valves to prevent blood flowing backwards.
B Veins are highly muscular.
C Arteries and veins are both permeable to tissue fluids and white blood cells.
D Blood in arteries is under very high pressure, having just left the heart.
15 Determine the correct pathway of air from the external environment to the lungs.
A mouth/nose → pharynx → larynx → trachea → bronchioles → bronchus → alveoli
B mouth/nose → larynx → pharynx → trachea → bronchus → bronchioles → alveoli
C mouth/nose → pharynx → larynx → trachea → bronchus → bronchioles → alveoli
D mouth/nose → trachea → pharynx → larynx → bronchus → bronchioles → alveoli
16 The enzyme amylase is produced by salivary glands and breaks down
A glucose.
B lipids.
C protein.
D starch.
17 Proteins are polypeptides made from chains of
A amino acids.
B glucose.
C lipids.
D sugars.
18 Animal and plant cells share many common features. However, only plant cells have a
A cell membrane.
B cell wall.
C golgi apparatus.
D vacuole.
19 Peripheral proteins are
A attached to or partially embedded in the cell membrane.
B found within the structure of the cell membrane.
C steroids found in animals.
D the major unit of the phospholipid bilayer.
20 The fluid mosaic model describes the
A arrangement of phospholipids in the cell membrane, where hydrophilic heads are attracted to the water and hydrophobic tails repel the water.
B dynamic structure of the cell membrane, which is embedded with a range of molecules.
C movement of molecules down a concentration gradient from high to low concentration.
D surface area-to-volume ratio that allows organelles to maximise movement of molecules across the membrane.
Question 21 (4 marks)
Photosynthesis occurs in two major sets of reactions. Identify these two stages and state specifically where each occurs in a plant cell.
Question 22 (2 marks)
The plasma membrane of each cell surrounds the cytoplasm, protecting and separating it from the extracellular fluid. The plasma membrane is semipermeable, with the structure and composition being
described by the fluid mosaic model. Define the following terms with respect to the plasma membrane: a semi-permeable (1 mark) b fluid. (1 mark)
Question 23 (3 marks)
Compare endocytosis with exocytosis.
Question 24 (2 marks)
Explain why animals need to “eat” food while plants do not.
Question 25 (6 marks)
The diagram below shows the fluid mosaic model of cell membrane structure.


a Identify the molecules labelled A and B. (2 marks)
b Explain why A is present as a double layer. (2 marks)
c Deduce whether the cytoplasm would be on side X or side Y. Justify your answer using evidence from the diagram. (2 marks)
Question 26 (3 marks)
Compare anabolism and catabolism.
Question 27 (2 marks)
Explain how the presence of wind affects the rate of transpiration.
Question 28 (6 marks)
The figure below shows a diagram of the nephron.
a Identify each of the structures labelled A, B, C and D. (4 marks)
b The excretion of urine from the collecting duct can be summarised by the following equation:
Urinary excretion rate = filtration rate –reabsorption rate + secretion rate
If the filtration rate remained constant, describe how the reabsorption rate and secretion rate may change to cause the following outcomes:
i high urinary output (1 mark)
ii low urinary output. (1 mark)
Question 29 (3 marks)
Compare villi and capillaries with respect to their roles in nutrient exchange in biological systems.
Question 30 (2 marks)
The graph below shows the rate of enzyme action against increasing substrate concentration. Use your understanding of enzymes to explain why the graph first increases before plateauing. Substrate
Question 31 (6 marks)
The diagram below shows the structures involved in gaseous exchange in humans.
a Identify the structure labelled X. [1 mark]
b Identify the process by which gases cross the exchange surface. [1 mark]
c Using the labelling on the diagram, describe gas exchange between the capillary and X. [4 marks]
Question 32 (6 marks)
Seeds use cellular respiration to germinate. Germination occurs in the presence of water, and carbon dioxide is produced as a by-product. This process can be affected by temperature, which is why some seeds stay in the ground over winter (regardless of the amount of soil moisture) and begin growing when the soil warms up. An experiment was conducted using germinating peas, which were placed in sealed flasks under the following conditions.
1 + 5
2 + 10
3 + 15
4 + 20
5 (control) Dry (nongerminating) 15
At 5 minute intervals, the amount of carbon dioxide in each flask was measured to indicate the effectiveness of cellular respiration. The results were plotted and are shown below.
a State what happened to the rate of carbon dioxide production when the temperature was increased from 5°C to 10°C, and propose a reason for this trend. [2 marks]
b State what happened to the rate of carbon dioxide production when the temperature was increased from 15°C to 20°C, and propose a reason for this trend. [2 marks]
c Identify the optimum temperature for germinating pea seeds. Use evidence from the graph to support your answer. [2 marks]
Question 33 (10 marks)
The apparatus shown in the figure below is called a potometer and is used to measure transpiration in plants. A tight seal between the base of the plant and the tubing means that when water is lost from the plant, the water level in the calibrated tube decreases.
FIGURE 6 A potometer.
a Define transpiration. [1 mark]
b Explain what would happen if the plant shown in the figure did not transpire. [3 marks]
c Explain why there is an airtight rubber tube sealing the connection between the water-filled tube and the plant cutting. [2 marks]
d Describe the pathway the water takes from the water-filled tube, through the plant to the air. [4 marks]
Question 34 (7 marks)
Rennin is a digestive enzyme that acts on the milk protein casein, causing milk to curdle in the stomachs of mammals such as cattle and sheep. Rennin works by clumping proteins in milk together, so that they stay longer in the intestines, aiding in absorption of nutrients and minerals. An experiment was conducted where rennin was added to milk at different temperatures. Observations were made after 5 mi nutes and are recorded in the table below.
Question 35 (12 marks)
An endophyte is an organism, such as a fungus or a bacterium, that lives inside the tissues of plants. An example of this is the ryegrass endophyte Epichloë sp., which can be found within the base of ryegrass plants. Because it is a fungus, this endophyte does not photosynthesise. Instead, it takes a portion of the sugars and oxygen produced by the ryegrass to survive. In return, the endophyte increases uptake of water in these plants. Also, its respiratory mechanism increases the amount of CO2 available to the plant, raising the ryegrass’s chance of survival.
a Identify what type of digestive enzyme rennin is. Justify your answer. [2 marks]
b Propose why the milk did not curdle at 4°C. [1 mark]
c Predict whether you would expect the milk to be curdled after 2 hours at 4°C. Justify your answer. [2 marks]
d Explain why the milk did not curdle at 80°C. [2 marks]
a In the table below, identify whether each input or output of photosynthesis increases, decreases or remains the same in the presence or absence of an endophyte.
Input/output
Water
Carbon dioxide
Sunlight
Sugars
Oxygen [10 marks]
Increases / decreases / stays the same With endophyte Without endophyte
b Explain what effect an endophyte would have on the growth of ryegrass. [2 marks]

FIGURE 1 Sweating is a thermoregulatory mechanism the body uses to cool down when overheated.
In Unit 2, students explore the ways biology is used to describe and explain the responses of homeostatic mechanisms to stimuli and the human immune system. An understanding of personal and communal responses is essential to appreciate personal lifestyle choices and community health. Students develop scientific skills and conceptual understanding in homeostasis, the immune system and the relationships between global, community and individual immunity. They examine geographical and population data to analyse strategies that may have personal and communal consequences
Source: Biology 2025 v1.0 General Senior Syllabus © State of Queensland (QCAA) 2025
Topic Chapter Pages
Topic 1
Homeostasis — thermoregulation and osmoregulation
Topic 2 Infectious disease and epidemiology

Chapters 10 and 11
Chapters 12 and 13
1 Describe ideas and findings about homeostasis, thermoregulation and osmoregulation, infectious disease and epidemiology.
2 Apply understanding of homeostasis, thermoregulation and osmoregulation, infectious disease and epidemiology.
3 Analyse data about homeostasis, thermoregulation and osmoregulation, infectious disease and transmission and epidemiology.
4 Interpret evidence about homeostasis, thermoregulation and osmoregulation, infectious disease and epidemiology.
5 Evaluate processes, claims and conclusions about homeostasis, thermoregulation and osmoregulation, infectious disease and epidemiology.
6 Investigate phenomena associated with homeostasis, thermoregulation and osmoregulation, infectious disease and epidemiology.

Each living species has a unique tolerance range of internal factors such as temperature, pH and hydration. The maintenance of the internal environment within these tolerance ranges is called homeostasis. The endocrine and nervous systems of animals respond constantly to internal and external changes to maintain this balance.
Feedback loops within and between organs in the body allow continual adjustments to be made to maintain homeostasis.
Check your understanding of concepts related to control and coordination before you start.
→ Explain how the nervous and endocrine systems use negative feedback to coordinate responses to internal/external stimuli and maintain homeostasis (stimulus-response model).
→ Identify the different types of sensory receptors and their stimuli, including chemoreceptors, thermoreceptors, mechanoreceptors, photoreceptors and nociceptors.
→ Describe the structure and function of nerve cells, including dendrites, soma, body, axon, myelin sheath, nodes of Ranvier, axon terminal and synapse.
→ Distinguish between sensory neurons, interneurons and motor neurons.
→ Explain the passage of a nerve impulse in terms of transmission of an action potential and synaptic transmission, referring to neurotransmitters, receptors, synaptic cleft, vesicles, postsynaptic and presynaptic neurons and signal transduction.
→ Describe how hormones relay messages to cells displaying specific receptors via the circulatory or lymphatic system.
→ Explain how receptor binding alters cellular activity, recognising that a cell’s sensitivity to a specific hormone is directly related to the number of receptors it displays for that hormone.
→ Analyse feedback-control diagrams to identify the stimulus, receptor/s, control centre, effector/s and communication pathway/s in different scenarios.
Biology 2025 v1.0 General Senior Syllabus © State of Queensland (QCAA) 2025

These lessons are available exclusively on Oxford Digital.
Lesson 10.4 The reflex arc
Learning intentions and success criteria
→ Organisms must regulate their body systems by monitoring their internal and external environments.
→ Organisms maintain homeostasis according to their tolerance ranges for a variety of abiotic conditions.
→ Homeostasis describes the maintenance of an organism’s body systems through positive and negative feedback loops.
→ The stimulus–response model allows organisms to detect environmental changes and respond, to maintain homeostasis.
Organisms must be able to monitor changes their environment so they can respond in a way that enhances their chance of survival. This includes monitoring and responding appropriately to changes in the external environment, such as temperature, intensity and direction of sunlight, humidity and food availability. Organisms must also be able to monitor their internal environment for factors including hydration, temperature, and concentration of gases and wastes in the bloodstream.

tolerance range the range of an environmental factor of an organism from the lowest level to the highest level it can tolerate for survival homeostasis the self-regulation of a stable internal environment regardless of external environmental conditions
FIGURE 1 Sunflowers move their flowerheads to follow the movement of the sun, which maximises their exposure to sunlight.
Because an organism’s external and internal environments are always changing, the abiotic and biotic factors that influence the organism’s survival are constantly fluctuating. Metabolic reactions change the concentration of both essential and waste molecules in the cell and the bloodstream. If the concentrations of these molecules are not kept within an organism’s tolerance range, it can be harmful to the organism. To survive these continual fluctuations, organisms have developed behavioural, physiological and structural adaptations to keep their internal environment within its tolerance range. Homeostasis is the maintenance of a stable internal environment in response to changing internal and external factors. Metabolic reactions occur constantly in cells to maintain homeostasis and enable survival.
A stimulus is any change to the internal or external environment of an organism that triggers a response in the organism. Stimuli are detected by receptors, which are molecules that monitor the internal and external environments. Receptors that monitor internal environments are located throughout the cells, tissues and organs of the body and can detect changes to factors such as pH, temperature, pressure and gas concentration. Receptors that monitor the external environment are located throughout the skin and organs on the outside of the body, such as the eyes and the ears. These receptors interpret information about the organism’s surroundings by detecting changes to factors such as temperature, pressure, light, smell and taste. The continual monitoring of the internal and external environments by receptors allows the central nervous system (CNS) to respond to changes and maintain homeostasis.
information sent to control centre, e.g. brain
e.g. skin
e.g. environment
FIGURE 2 The stimulus–response model
stimulus a change in the internal or external environment that can be detected by receptors response an organism’s reaction to a stimulus
receptor molecules that monitor internal and external stimuli
Output: information sent to e ectors, e.g. muscles
central nervous system (CNS) the body’s processing centre consisting of the brain and spinal cord
E ector responds, homeostasis returned
When a stimulus is detected, changes to the receptor molecule occur, initiating a signal, which is then sent to the regulator in the CNS. The regulator processes the information from the stimulus and sends a response to the appropriate effector cells or organs. In animals, effectors are often glands that respond by releasing hormones, or muscles that respond by moving. In plants, responses usually involve the release of hormones produced by cells all around the plant, rather than from a gland.
Stimulus
Receptor E ector Response
FIGURE 3 Basic components of the stimulus–response model
Regulator in CNS
regulator the part of the central nervous system that receives a stimulus signal and responds by sending a signal to an effector
effector the cell or organ (e.g. a gland or a muscle) that responds to a stimulus
feedback a process in which the end product or event of a system influences the operation of that system to regulate its activity
negative feedback
a form of feedback in which a signal triggers a process to stop when the optimal range of a factor has been reached
positive feedback a form of feedback in which a signal triggers the amplification of a process to bring about change in the body
Changes in a particular factor activate the regulator, which directs the effector to initiate a response that will help return the factor to its optimal range.
This response may then act as another stimulus that either stops or maintains the factor, a homeostatic process called feedback . Feedback links the parts of the control system, allowing the output of the effector to be regulated by the input to the regulator. There are two types of feedback:
• negative feedback , in which the response is slowed or stopped

• positive feedback , in which the same response is maintained or amplified.
In many stimulus–response processes, the result of the effector’s response opposes the original stimulus. For example, if core body temperature is too high (stimulus), it will trigger a response of vasodilation (widening of blood vessels), which allows the body to lose heat and lower core body temperature. Once core temperature has lowered and returned to normal, this change is detected and acts as a new stimulus that triggers vasodilation to stop (response).
This is an example of a negative feedback system: the stimulus (high core temperature) triggers a response (vasodilation) that changes the stimulus (lowered core temperature) and subsequently stops the response (vasodilation), to maintain homeostasis (normal core temperature).
Thermoregulation centre in brain is activated.

Temperature rises above normal.
Sweat glands secrete sweat, which evaporates, cooling the body.

Vasodilation occurs so heat can escape and body can cool down.
Homeostasis
Internal body temperature 36–38°C (approx.)
Vasoconstriction occurs to minimise heat loss.
Skeletal muscles contract rapidly (shivering), which generates heat.
Temperature falls below normal.

Thermoregulation centre in brain is activated.
5 Regulation of body temperature is an example of negative feedback.
Homeostasis in vertebrates is controlled mostly through negative feedback systems. Fluctuations above or below the optimal level of a factor trigger a corrective response, allowing the system to self-adjust to changing conditions. When the stimulus detected indicates that a level is too high, the response of the effector lowers the level. When the stimulus detected indicates that a level is too low, the response of the effector raises the level. Levels of any factor fluctuate slightly above or below the optimal point until they stabilise, and these control systems are managed by the nervous and endocrine systems.
Positive feedback occurs when the effect of an effector’s response amplifies or promotes the original stimulus. An example in human bodies is when a cut or a scratch causes bleeding through a break in the skin. The damaged cells release a chemical that causes platelets to become activated. These platelets release more chemicals that signal for further platelets to be produced and move to the site, resulting in a blood clot that prevents bleeding. Another example of a positive feedback system is the release of hormones that induce labour during childbirth. The presence of the hormones triggers the release of more hormones, and the labour increases in intensity until the baby is born.

6 Production of
during childbirth is an example of a positive feedback loop.
The two systems responsible for coordinating responses in animals are the endocrine and nervous systems. These systems maintain homeostasis and survival of organisms through the process of stimulus and response. The stimulus is a detectable change in the external or internal environment, and the response is an appropriate and targeted action. Plants coordinate homeostatic changes either through a direct cellular response to chemical change or the release of hormones that act on target cells or organs.
Check your learning 10.1
Check Your Learning 10.1: Complete these questions online or in your workbook.
Retrieval and comprehension
1 Define homeostasis. (3 marks)
2 List three stimuli that may trigger a response to maintain homeostasis. (3 marks)
Learning intentions and success criteria
neuron a nerve cell action potential
an electrical signal that flows from the soma of a neuron along the axon to the axon terminal, passing information to the next neuron
dendrite segments branching from the soma of a neuron that detect a stimulus from the environment or other cells
soma (cell body) the main body of a cell, containing the cytoplasm and nucleus
axon
a long thin projection from the soma of a neuron (nerve cell) that conducts electrical impulses, called action potentials
axon terminal a projection at the end of an axon that releases neurotransmitters into the synaptic cleft
Schwann cell
a cell that produces fatty myelin, which makes up the myelin sheath of a neuron
Analytical processes
3 C ontrast receptors and effectors of the nervous system. (2 marks)
4 C ompare positive feedback loops and negative feedback loops. (3 marks)
→ The structure and distribution of the nervous system within an organism allows communication between organs and response to stimuli.
→ The structure and function of neurons enable a variety of signals to be transported between and within body systems.
→ The generation and propagation of an impulse within a neuron determines how, when and whether a signal is sent through the nervous system.
→ Neurons transmit signals to each other and to other cell types, such as muscle cells.
The nervous system is a coordinating system that detects stimuli and initiates an appropriate response. It is made up of nerve cells, called neurons, which have a specialised structure that allows electrical impulses to rapidly transmit information around the body. Ion concentrations across the cell membrane of the neuron facilitate the movement of an electrical signal through the neuron, taking information from one neuron and passing it to the next. This process is called an action potential and is triggered by stimulation of dendrites by surrounding neurons.
The specialised structure of neurons allows the transmission of electrical impulses around the body. Neurons vary slightly in structure according to their purpose but they are typically made up of a soma (cell body), dendrites, an axon, and axon terminals. Neurons share some common features but different types are specialised for their unique purpose within the body.
The soma or cell body of a neuron contains the nucleus, large organelles and proteins. Two types of long, thin, cytoplasmic branches extend from the soma: dendrites and axons. Dendrites are often shorter and have many branches, and their main function is to receive input from surrounding cells and molecules. Axons are usually long, and branch into axon terminals at the very end. The role of the axon is to carry electrical impulses from the soma to the cell’s axon terminals, where the signal is passed on to adjacent cells.
Most axons are covered by specialised Schwann cells, which produce a protective substance called myelin to create a myelin sheath. The myelin sheath contains a high concentration of lipids, which provide protection for the axon and insulation of the electrical signal as it passes along the axon. Gaps between Schwann cells expose the axon and allow acceleration of the electrical impulse – these gaps are called nodes of Ranvier
Neurons that detect stimuli are called afferent (sensory) neurons. They send information in the form of electrical impulses towards the central nervous system. Neurons that bring about a response by effectors are called efferent (motor) neurons. They send information in the form of electrical impulses away from the central nervous system. Interneurons in the central nervous system connect afferent and efferent neurons to each other, allowing a stimulus to trigger a response.
Electron micrograph of a neuron
Dendrites
Signal
Nucleus
Cell body

Synaptic knob
Axon branches
Like all animal cells, neurons have a phospholipid bilayer cell membrane. Chemical and electrical changes along the cell membrane of the neuron allow the conduction of a nerve impulse. Sodium ions (Na+) and potassium ions (K+) are present both inside the neuron and surrounding the neuron, with sodium ions slightly more abundant outside the cell and potassium ions slightly more abundant inside the cell. Because sodium ions have a higher electronegativity than potassium ions, the outside of the cell has a positive charge relative to the negative charge inside the cell. This causes the cell to become polarised across its cell membrane. In this resting state, the voltage across the cell membrane of the neuron is 70 mV (millivolts). The polarisation of the cell membrane of a neuron at rest is maintained by an integral protein called a sodium–potassium pump Sodium–potassium pumps use energy in the form of ATP to pump sodium ions from the inside to the outside of the cell against the concentration gradient, to maintain the –70 mV voltage across the cell membrane. For every three sodium ions pumped out of the cell by the sodium–potassium pump, two potassium ions are brought into the cell. Neurons in this inactive, polarised state are at their resting potential
myelin a lipid-rich substance that coats the axons of neurons
myelin sheath a layer of myelin that wraps around the axon of a neuron to insulate electrical impulses nodes of Ranvier spaces between Schwann cells where the axon is not covered by the myelin sheath; allows acceleration of the action potential along the neuron
afferent (sensory) neuron
a nerve cell that relays signals from sensory receptors to the central nervous system (sometimes referred to as sensory neurons)
efferent (motor) neuron
a nerve cell that relays signals from the central nervous system to effectors such as muscle cells and endocrine glands
interneuron
a type of nerve cell in the central nervous system that relays signals from afferent neurons to efferent neurons in the peripheral nervous system electronegativity the tendency of an atom to attract electrons
nervous system a biological system made up of the brain, spinal cord and nerves; sends messages and coordinates actions nerve a bundle of dendrites and axons wrapped in connective tissue; transmits information between the peripheral and central nervous systems
polarised the state of a cell when the electrical charge on the inside of the cell membrane is different than that of the extracellular environment
sodium pump an integral protein in the cell membrane of animal cells that pumps sodium ions across the cell membrane against the concentration gradient
Nerve impulses in neurons are generated by sensory cells or the activity of an adjacent neuron. The impulse begins when the dendrites are stimulated and send a chemical signal to the soma of the neuron. The stimulus received by the dendrites causes a change in the electrical potential of the soma and the attached axon. When the change in the electrical potential reaches a critical point, an electrical signal passes along the membrane of the axon to the synapse, where neurotransmitters are released to stimulate the next cell. This process of changes in electrical potential allowing an electrical signal to pass along a neuron is called an action potential.
1
In response to a signal, the soma end of the axon becomes depolarised.
2
The depolarisation spreads down the axon. Meanwhile, the first part of the membrane repolarises. Because Na+ channels are inactivated and additional K+ channels have opened, the membrane cannot depolarise again.
3
The action potential continues to travel down the axon.
resting potential a polarised state of the cell membrane of a neuron when the inside of the membrane is more negative than the outside; the resting state of a neuron when it is not actively sending a signal
resting potential a polarised state of the cell membrane of a neuron when the inside of the membrane is more negative than the outside; the resting state of a neuron when it is not actively sending a signal
Initiation and conduction of nerve impulses are the result of changes to the electrical potential difference (voltage) across the cell membrane in the axon of a neuron. These changes in one section of the axon membrane trigger a change in the adjacent section, and so on down the axon until the signal reaches the axon terminals. Immediately following the change in voltage of a section of the membrane, it returns to resting potential. The entire process of a nerve impulse travelling through a neuron via action potential takes approximately six milliseconds. The conduction of a nerve impulse through the axon of a neuron is like a wave of electrical changes, which we call an action potential, and is summarised as follows:
1 A neuron at rest (not conducting a signal) exists in a polarised state with a negative charge of –70 mV maintained by the sodium–potassium pumps in the cell membrane.
2 A stimulus received by the dendrites depolarises a section of the neuron membrane. Sodium channels in the cell membrane open in response and sodium ions flow into the
cytoplasm of the neuron. The increased concentration of sodium ions causes the inside of the neuron to have a more positive charge. The influx of sodium ions triggers more sodium channels to open, causing a greater influx of sodium ions and raising the voltage to +40 mV. This depolarisation of the cell membrane allows electrical energy to travel down the axon, creating an action potential.
3 The depolarisation of the membrane moves to the adjacent section of the axon, allowing the signal to move in one direction along the neuron from soma to axon terminals.
4 Following the peak of the action potential voltage (+40 mV ), potassium channels open, allowing potassium ions to pass through to the outside of the membrane, restoring its positive charge. Sodium channels close, to prevent sodium entering the cell. Repolarisation of the cell membrane occurs, returning it to resting potential.
5 Immediately following the action potential, a temporary undershoot of electrical potential difference across the membrane of the axon is caused by the movement of potassium ions. This causes the inside of the cell to be more negative than resting potential, and is called the refractory period . Subsequent action potentials cannot occur during the refractory period, until repolarisation is complete and the electrical potential difference returns to –70 mV.
neurotransmitter a chemical that passes across the synapse between the axon terminal of one neuron to the dendrites of another
potassium channel a transmembrane protein that allows the selective flow of potassium ions into and out of the cell membrane
sodium channel a transmembrane protein that allows the selective flow of sodium ions into and out of the cell membrane
6 Sodium pump function is restored and sodium ions are pumped out of the cytoplasm until resting potential is restored.
The threshold potential is the change in electrical potential required across the membrane to trigger an action potential. An action potential will occur in neurons when the voltage across the cell membrane of an axon changes from –70 mV to –55 mV. Changes to voltage that do not reach –55 mV do not trigger an action potential and no signal is sent to the next neuron. An action potential is an all-or-nothing response. This means that even if a stimulus generates a greater voltage change than –55 mV, it will produce no greater response in the electrical signal. The threshold potential is either reached and the action potential occurs, or it is not reached and no signal is sent.
The influx of sodium ions in one section of the membrane influences the voltage of adjacent sections of the axon, triggering the movement of the action potential and signal along the axon in a wave-like motion.
Sodium channels close. Potassium channels open. Potassium ions rush from cytoplasm to extracellular fluid. Repolarisation begins.
Stimulus causes sodium channels to open, allowing sodium ions to enter cytoplasm of the neurons –depolarisation starts.
Sodium pump actively removes sodium ions to extracellular fluid. Potassium ions enter cytoplasm. The resting potential is restored.
repolarisation the change in membrane potential that occurs after the depolarisation phase of an action potential
undershoot when a membrane potential briefly becomes more negative than its resting potential
refractory period a period of time in which the neuron cannot fire another action potential threshold potential the level of depolarisation across the cell membrane required to initiate an action potential
all-or-nothing response describes an action potential, which will occur (neurons will fire at full strength) if the threshold potential is met, or not occur (neurons will not fire) if the threshold is not met
pre-synaptic terminal
a specialised area at the end of an axon; contains synaptic vesicles that store neurotransmitters
synaptic cleft the space between the axon terminals of one neuron and the dendrites of another; the space where neurotransmitter molecules move between neurons
Neurons transmit information to each other by releasing neurotransmitters across the junction between them, called a synapse. The synapse extends from the ends of the axon terminal of one neuron, where information is released, to the tips of the dendrites of an adjacent neuron, where information is received. This includes transmission from neuron axon terminals to effectors such as glands and muscles.
The main parts of the synapse are:
• the pre-synaptic terminal , which is located at the end of an axon and is the area that releases neurotransmitters into the space between the two neurons
• the synaptic cleft , which is the small gap between neurons that the neurotransmitters must cross
• the post-synaptic membrane, which is located at the dendrites of another neuron or an effector (e.g. gland or muscle tissue) and is the site that receives the information in the form of neurotransmitters.
1

Action potential arrives.
2
Vesicle fuses with the membrane of the synaptic knob (axon terminal).
3
Neurotransmitter is released into the synaptic cleft.
Note 1:
A vesicle is a small ‘package’, surrounded by a membrane, that contains chemicals, in this case neurotransmitters.
post-synaptic terminal
a section on the membrane of a post-synaptic neuron that contains areas adapted to receive neurotransmitters vesicle a membrane-bound structure that, in neurons, stores neurotransmitters before they are released into the synaptic cleft
Note 2:
Sometimes less, rather than more, neurotransmitter may be produced to cause a stimulus. Another possibility is that some neurotransmitters cause inhibition of nerve impulses in the next neuron (rather than a stimulus).
Note 3: When the neurotransmitter is broken down (by an enzyme), it is removed from the receptor so that the ion channel closes again – after the action potential has passed.
4
Neurotransmitter binds to a receptor on the ion channel. The ion channel opens so that Na+ di use in, setting up an action potential in the next neuron.
Most connections between neurons have a wide synaptic cleft that does not allow the direct electrical flow of an action potential between adjacent neurons. In these synaptic connections, chemical substances called neurotransmitters are released from synaptic vesicles, which are membrane-bound structures in the pre-synaptic neuron that store neurotransmitters and release them close to the synaptic cleft. Neurotransmitters released from the pre-synaptic terminal into the synaptic cleft are received by receptors on the post-synaptic terminal of the
next neuron. The neurotransmitters create a change in the permeability of the cell membrane of the receiving neuron, contributing to its depolarisation and the triggering of an action potential. Receptors are only present on the post-synaptic terminal and so electrical impulses in neurons can flow in only one direction: from dendritic receptors, through the soma and along the axon to the axon terminals. A few different molecules act as neurotransmitters, with two of the most common being acetylcholine (ACh) and noradrenaline
Check your learning 10.2
Check Your Learning 10.2: Complete these questions online or in your workbook.
Retrieval and comprehension
1 Identify the integral protein responsible for maintenance of resting potential in a neuron. (1 mark)
2 Describe the resting potential of a neuron in relation to charge across the cell membrane and concentration of sodium and potassium ions.
neurotransmitter a chemical secreted by neurons that passes across the synapse between the axon terminal of one neuron to the dendrites of another
acetylcholine (ACh) a neurotransmitter involved in many functions in the body, including brain function and muscle movement
(3 marks)
3 E xplain how signals move between adjacent neurons, if the neurons are not in physical contact. (4 marks)
Analytical processes
4 C ontrast the role of the pre-synaptic terminal and the post-synaptic membrane. (2 marks)
Key ideas
→ The mammalian nervous system is organised into the central and peripheral nervous systems.
→ The brain is part of the central nervous system and communicates with the rest of the body through the brainstem.
→ Sensory pathways between the peripheral nervous system and the central nervous system are made up of afferent neurons, interneurons and efferent neurons.
→ Reflex arcs, or reflexes, are the fastest neural pathways and are an evolutionary adaptation for survival.
The nervous system of mammals, including humans, is made up of:
• the brain and the spinal cord, which together are known as the central nervous system (CNS)
• all the nerves and ganglia outside the CNS, which together are known as the peripheral nervous system (PNS).
Learning intentions and success criteria
noradrenaline a neurotransmitter involved in arousal and the ‘fight-or-flight’ response
central nervous system (CNS) the coordination centre of vertebrates; made up of the brain and the spinal cord ganglia clusters of nerve cells peripheral nervous system (PNS) the system of nerves that carries stimulus information from receptors to the CNS, and nerves that carry responses from the CNS to effectors
The CNS consists of the brain and the spinal cord. The spinal cord attaches at the bottom of the brain and is protected by the bones of the vertebral column (spine). The brain controls almost everything in our body, including our thoughts, emotions, hunger, thirst, breathing, temperature and the way we move our muscles. The primary purpose of the spinal cord is to connect the peripheral nervous system with the brain and, at times, to connect sensory neurons directly to motor neurons to produce reflexes.
Neurons in the PNS are bundled together into nerves and ganglia. Nerves are bundles of axons or dendrites wrapped in a sheath of connective tissue and myelin. They contain both sensory and motor neurons to transmit signals to and from the CNS. The connective tissue and myelin sheath insulate the nerve impulses, to prevent them from moving between nerves or weakening. Ganglia are bundles of somas (cell bodies) at the beginning of a nerve that receive a stimulus to trigger the action potential.
Behavioural, motor and chemical responses are brought about by signals sent from receptors in the PNS to the CNS, where a response is coordinated and sent back to the PNS to act on effectors. The three types of neurons involved in neural pathways are afferent (sensory) neurons, interneurons and efferent (motor) neurons.
Neurons that detect stimuli from the external environment and send the information to the CNS are called afferent or sensory neurons. Afferent neurons detect stimuli such as temperature, pressure, taste, hearing and vision.
Interneurons are located in the CNS and link afferent to efferent neurons, or neurons within the CNS to each other.
Efferent or motor neurons send signals from the CNS to effectors to bring about a response, such as muscle movement or the release of hormones from glands.
1
Reflex arcs, or reflexes, are the fastest neural pathways and are an evolutionary adaptation for survival. A reflex is a signal that passes from an afferent neuron that has detected a dangerous stimulus almost directly to an efferent neuron to trigger a life-saving response. Because the signal goes through the CNS, it may pass through an interneuron but is not processed by the brain, and the brain may become aware of the stimulus at the same time as the motor response. Examples of reflex arcs are: instantly moving a body part away from burning heat, blinking when something enters the eye, and gagging when choking on food.
Activation of a sensory neuron
Sensory neuron
Arrival of stimulus and activation of receptor
Stimulus



Receptor Reflex arc
Dorsal root
reflex arc (reflex) a neural pathway connecting sensory neurons to interneurons in the spinal cord and directly to motor neurons, to enable a rapid response without processing by the brain, e.g movement of a limb away from extreme heat
Sensation relayed to the brain
5 Response by e ector

Activation of a motor neuron
Ventral root Information processing in CNS by interneuron
FIGURE 2 A reflex arc. The immediate response is to pull away from the stimulus (pinprick). After the reflex action has occurred, information is also sent to the brain.
Palmar grasp reflex
Have you ever noticed that if you put your finger into a newborn baby’s hand, they will grab your finger tightly? This is a reflex arc known as the palmar grasp reflex. The reflex develops while the baby is still developing in the womb and is replaced at 3 to 6 months of age by voluntary movement of the hands to hold objects. This reflex arc begins when

mechanoreceptors in the palm of the baby’s hand detect touch or pressure. A signal from the mechanoreceptor is sent along the sensory neuron to the spinal cord, where the CNS immediately sends a signal through a motor neuron to contract the hand muscles. This results in the baby immediately grasping anything that comes into contact with their hand. The palmar grasp reflex is thought to be an evolutionary leftover from one of our arboreal (tree-dwelling) ancestors. The ability to grasp an object as a very fast reflex would have allowed babies to hold onto the hair or skin of their parents and stopped them falling out of trees. Nowadays, this interesting reflex arc is mostly used to assess the development of babies.
1 Identify the three types of neurons involved in the palmar grasp reflex. (1 mark)
2 I nfer the outcome for the babies of our arboreal ancestors the palmar grasp reflex had been a conscious movement rather than a reflex. (2 marks)
Science inquiry skill: Designing investigations
A person’s reaction time refers to how long it takes them to respond to a stimulus. The nervous system can respond to stimuli within a fraction of a second, and in some cases that reaction time can be improved. Athletes are often trained to sharpen their reflexes by decreasing their reaction time to different stimuli.
Reaction timers are devices that test hand–eye coordination and can be used to improve a person’s reaction time. One form of reaction timer is a reaction wall – a large panel mounted on a wall with lights that have to be touched as soon as they light up. Figure 4 shows a reaction wall where eight lights in a circle randomly switch on, and the user needs to switch them off by quickly hitting the lit-up circle.
Practise your skills
1 Design an experiment that uses a reaction wall to test your classmate’s reaction times and monitor whether their performance changes after repeated practice. In the design of your experiment, include:
• an aim
• a hypothesis
• a method. (3 marks)
2 Predict whether the results of this experiment will show an increase, decrease or no change in reaction time. Justify your prediction. (2 marks) Need help designing investigations? Go to Lesson 1.X in your biology toolkit.
Check Your Learning 10.3: Complete these questions online or in your workbook.
Retrieval and comprehension
1 Identify the two components of the central nervous system. (2 marks)
2 E xplain what a reflex arc is, including the neuron types involved. (4 marks)
Analytical processes
3 D istinguish between sensory neurons, motor neurons and interneurons. (3 marks)
4 C ompare the central nervous system and the peripheral nervous system. (3 marks)
Lesson 10.4
This lesson is available exclusively on Oxford Digital.
Key ideas
→ Internal and external environmental changes are detected by sensory receptors in the PNS.
→ Sensory receptors send signals through the PNS to the CNS for processing and to coordinate a response.
→ Sensory receptors are specialised for the different types of information they detect, including pressure, temperature, smell, taste, light and movement.
→ Types of sensory receptors are chemoreceptors (taste and smell), mechanoreceptors (movement), thermoreceptors (heat), photoreceptors (light) and nociceptors (pain).
Sensory organs such as the eyes, ears, nose, mouth and skin contain specialised neurons known as sensory receptors, which detect changes in our external environment. Our internal organs and systems are also monitored by sensory receptors, which relay information about our internal environment to the CNS for interpretation. Sensory receptors are sensory neurons that are specialised to detect particular types of information to be sent as an action potential to the CNS. Sensory neurons are triggered by the stimulus they are specifically
Learning intentions and success criteria
Learning intentions and success criteria
chemoreceptor
a sensory receptor that detects changes in chemicals
adapted to detect. For example, sensory receptors in the human eye detect light stimuli, including changes in light intensity and colour, interpreted by our brain as our vision. Sensory stimuli are converted to action potentials in the sensory neurons; the stronger the stimulus, the more action potential signals are sent to the CNS.
There are many types of sensory receptors, each specialised to detect specific stimuli. In the human body, sensory receptors include (but are not limited to): chemoreceptors, thermoreceptors, mechanoreceptors, photoreceptors and nociceptors.
Chemoreceptors are sensory receptors that detect chemical information and send signals along afferent neurons to the CNS. Chemoreceptors may detect chemical stimuli from outside the body, including smell and taste, or from within the body, such as gas (carbon dioxide and oxygen) concentration in the blood. Chemoreceptors that detect taste and smell can help organisms find food and determine whether food is edible. The chemoreceptors responsible for monitoring blood gas concentrations allow the CNS to maintain homeostasis by responding to low oxygen levels by increasing respiratory rate and heart rate.
“Taste












nerve fibres
FIGURE 1 Distribution of chemoreceptors on the tongue. The number of receptors and the combination of different types of receptors activated can determine the “taste” a person perceives.
Thermoreceptors are sensory receptors that detect temperature changes, either in the external environment or within the body. In mammals, one type of thermoreceptor detects an increase in temperature, while another detects a decrease in temperature. Once information is sent from thermoreceptors to the CNS, physiological and behavioural responses are triggered by effectors to return the organism’s core temperature to its optimal range. For example, if a thermoreceptor detects a drop in temperature due to a cool breeze at the beach, the CNS may signal erector muscles on the hair shafts to contract, causing goosebumps to form and the hairs on the skin to stand on end.
Heat receptorCold receptor
thermoreceptor a sensory receptor that detects changes in temperature























Thermoreceptors in the body detect fluctuations in external and internal temperature.










Mechanoreceptors are predominantly located in the skin, and respond to pressure and touch. Signals sent to the CNS from mechanoreceptors aid in movement and interaction with the physical environment. Some specialised mechanoreceptors are located in the hair and the ears, and translate information about subtle movements and vibrations in mediums such as air.
mechanoreceptor a sensory receptor that detects changes in pressure and touch
Node of Ranvier
Nerve ending
FIGURE 3 A pacinian receptor is a type of mechanoreceptor that detects vibrations.
photoreceptor a sensory receptor that detects changes in light wavelength and intensity
nociceptor a sensory receptor that detects signals from damaged tissue
Photoreceptors detect details of light wavelength and intensity entering the eye and send this information, in the form of action potentials in neurons, to the brain where it is interpreted as vision. Variations in the types and number of photoreceptors present in the eyes of an animal determine how much detail and which colours it sees.
Photoreceptors
Rod
Cone

FIGURE 4 Rods and cones at the back of the eye are photoreceptors, able to detect dim and bright light conditions.
Nociceptors are sensory receptors that respond to damage to cells and tissue by sending a signal that is interpreted by the CNS as pain. Nociceptors are in most parts of the body, as damage may occur anywhere, internally or externally. Many types of stimuli can trigger a response in nociceptors, including extremely high or low temperatures, excessive pressure, and some chemicals that can cause tissue damage. For example, a build-up of lactic acid in muscles due to excessive exercise causes the perception of pain, due to signals from nociceptors.
Challenge
Congenital insensitivity to pain and anhidrosis (CIPA) is a rare and dangerous condition in which a person is unable to perceive pain. The nociceptors of people afflicted with this condition are unable to signal or connect to the central nervous system. This means that when a person with CIPA is exposed to a damaging stimulus, they do not register that they are experiencing pain and are likely to remain exposed to the painful stimulus, risking further damage to the affected site of the body.
1 Explain how CIPA might impact a person’s ability to produce a reflex arc. (2 marks)
2 Use your knowledge of reflex arcs to contrast how a person unaffected by CIPA and a person affected by CIPA might respond to touching a boiling hot saucepan. (2 marks)
Check your learning 10.5
Check Your Learning 10.5: Complete these questions online or in your workbook.
Retrieval and comprehension
1 Describe the direction of the signal that moves between the central nervous system and sensory receptors. (2 marks)
2 Identify the name of the receptor that receives information about light. (1 mark)
3 Describe the response of the CNS when it receives a signal from a sensory receptor. (4 marks)
4 Identify the sensory receptors in the nose and mouth. (1 marks)
Lesson 10.6
Key ideas
5 Describe the function of each of the following sensory receptors:
a chemoreceptors (1 mark)
b mechanoreceptors (1 mark)
c nociceptors (1 mark)
d photoreceptors (1 mark)
e thermoreceptors. (1 mark)
Knowledge utilisation
6 I nfer why sensory receptors within the ear are classified as mechanoreceptors. (2 marks)
→ Hormones are chemical messengers produced by an organism to regulate the activity of cells and organs.
→ Each hormone regulates and controls the activity of specific target cells and tissues.
→ Hormone activity is slow-acting and long-lasting.
→ Signal transduction is a set of chemical reactions in a cell that occurs when a molecule, such as a hormone, attaches to a receptor on the cell membrane.
Learning intentions and success criteria
signal transduction a set of chemical reactions in a cell that occurs when a molecule, such as a hormone, attaches to a receptor on the cell membrane
In each living cell, a vast number of chemical reactions are occurring at any given moment. Because some substances are synthesised and others are used, destroyed or removed, the chemical environment in each part of the cell constantly undergoes slight changes. Any change in the chemical environment will affect subsequent chemical reactions and thereby exert some control over them. This simple relationship, which regulates most cellular reactions, forms the basis of more complex chemical regulatory mechanisms.
Cells have special receptor molecules embedded in their membranes and in their cytoplasm. Different types of cells have different types of receptors and so will only respond to specific chemical messages in their environment. For a cell to respond to a stimulus, signal transduction must occur. This is when changes occur in a receptor molecule that allow molecular signals from the cell’s exterior to be transmitted to its interior. Once this signal is received, an appropriate response can then be made by the cell. Hormone systems are thought to have evolved from this mechanism, where certain cells have become specialised to produce and secrete specific regulatory chemicals.
molecule
Signal molecule arrives at the target cell.
Signal molecule binds to a receptor protein in the cell surface or inside the cytoplasm.
Signal binding changes the three-dimensional shape of the receptor and exposes its active site. The activated receptor activates a signal transduction pathway to bring about cellular changes.
Short-term responses: enzyme activation, cell movement Inactive signal transduction molecule Activated signal transduction molecule
Long-term responses: altered gene expression
FIGURE 1 The process of signal transduction
Hormones are chemical messengers produced by an organism to regulate the activity of cells and organs. They are produced by cells in very small quantities and transported to cells in other parts of the body. Each hormone regulates and controls the activity of a specific target structure. This may be an individual cell, a muscle or another gland.
There are three ways a hormone may effect a change.
• Autocrine hormones bind to receptors in the same cell that produced them. An example is a white blood cell (T lymphocyte) activating itself with an autocrine hormone (IL-2) during an infection.
• Paracrine hormones bind to receptors on neighbouring cells. Infected plant cells use paracrine hormones to warn neighbouring cells to protect themselves.
• Endocrine hormones travel long distances through the blood supply of animals to reach target cells that have receptors complementary to the shape of the hormone. Other hormones that act at a distance are pheromones. These are released from the body and act as a species-specific signal to other members of the species. Female dogs and insects release sex pheromones into the air when they are ready to mate. The chemical molecules released can be detected at very small concentrations over large distances by the males of their species. Other pheromones are released in urine or specialised glands to mark out territories. Some plants also produce pheromones. For example, the growing tip of the primary shoot of the red cedar (Toona ciliata) releases a pheromone that attracts the tip moth. The tip moth lays its eggs in the tissues and the emerging larvae feed on them. This prevents further growth from the apex of the plant but stimulates the growth of lateral branches.
The action of hormones tends to be slow, because hormones travel long distances to their complementary receptors. Also, because some of the released hormone remains even after hormone production has been “switched off”, hormone action tends to be long-lasting. A stimulus causes production and secretion of a hormone appropriate to that stimulus.
• Information about the external environment is relayed to hormonesecreting cells via the nervous system in most animal groups. In plants, cells are directly stimulated by an external cue (e.g. the direction of light).
• Hormone-secreting cells respond directly to changes in their immediate internal environment, often via a circulating fluid (in animals) or diffusion (in plants).

hormone a regulatory chemical of the control and coordination system; capable of bringing about a specific response to a particular stimulus pheromone a hormone released as an external signal to other members of the species
The hormone is then carried throughout the body. It does not initiate any unique cellular activities, but instead modifies the rates of existing activities. There are two main types of hormones: water-soluble and fat-soluble.
When a water-soluble hormone (proteins or amino acid derivatives) reaches the target organ receptors, glycoprotein molecules on the cell membranes “capture” the hormones. This binding between the receptor molecule and the hormone can:
• couple directly with an ion channel to influence the passage of specific ions into or out of the cell (i.e. they influence the permeability of the cells to particular solutes)
• allow the hormone-receptor molecule to pass across the membrane, where it can be linked to a specific protein or become associated with a particular enzyme to induce or repress their action and, therefore, specific chemical reactions.
Fat-soluble hormones (such as steroids) can pass directly through the cell membrane. In the cytoplasm, they bind with their complementary receptors, allowing them to pass through the pores of the nuclear membrane. The linked hormone and receptor have a particular shape that has an affinity with a specific nucleotide sequence in the DNA. This interaction changes the gene expression of the cell so that specific enzymes are either produced or their synthesis is inhibited; that is, they affect the function of specific genes.
Hormones are often referred to as ‘chemical signals’, because they cause a change in activity of the target cells. Hormones differ in their molecular structure. Some are proteins and others are steroids. Therefore, different hormones are recognised by different target sites and bring about different chemical reactions.
Many types of signals are received by cells. These include neurotransmitters (chemical messengers released from the nervous system), messages from the immune system, growth factors and toxins. As with hormones, only cells with a complementary receptor for that chemical messenger will be influenced by it. The more receptors present for that chemical, the more actively the cell responds to the message.
• opening or closing protein channels. signal transduction pathway a cascade of biochemical reactions inside a cell that eventually reach the target molecule or reaction; initiated when a molecule (e.g. a hormone) attaches to a receptor on the cell membrane
For a cell to respond to a stimulus, a signal transduction pathway must be activated. When a hormone binds to its specific receptor, the receptor rearranges its shape. This change in conformation can signal to other molecules (called secondary messengers) in the cell to change their function. Like a line of falling dominoes, each affecting the next one, the secondary messenger molecules cause changes in the chemical pathways throughout the cell until it results in a final response to the hormone message. These responses include:
• activating or inactivating enzymes
• exocytosis (release) of molecules
• switching genes on or off
3 Signal transduction of a hormone acting on its target plant cell
The types of receptors on a cell’s surface or in its cytoplasm are determined by the DNA of the cell. DNA molecules contain genes that code for specific receptors (each receptor molecule is a protein). These receptors are either embedded in the cell membrane or are in the cytoplasm. Many types of cell receptors are present in a cell at any one time, and each of these receptor types responds to a different signal. The cell constantly monitors the signals that come in contact with its receptors and adjusts the quantities of each receptor type accordingly.
Membrane receptors can be removed or recycled. When this occurs and there is a reduced presence of a specific receptor type able to detect a certain signal, the cell’s sensitivity to that signal will also reduce. This process is termed down-regulation. One example of downregulation in humans is when the body is exposed to high insulin levels in the blood. The number of insulin receptors is down-regulated, reducing the body’s sensitivity to the insulin hormone.
If the cell receives a weak signal, more receptors can be synthesised to increase the cell’s sensitivity to the message. The increase in the number of those receptors is termed upregulation. For example, during pregnancy, the uterus up-regulates oxytocin receptors. When childbirth starts, the uterus is more sensitive to oxytocin released from the brain.
down-regulation the process of reducing or suppressing a response to a stimulus by reducing the number of receptors on the cell surface up-regulation the process of increasing the response to a stimulus due to an increase in the number of receptors on the cell surface
Check your learning 10.6
Check Your Learning 10.6: Complete these questions online or in your workbook.
Retrieval and comprehension
1 Describe what happens during a signal transduction pathway. (3 marks)
2 Define hormone. (1 mark)
3 E xplain why only certain target cells are affected by each type of hormone. (2 marks)
4 E xplain how a cell can change in response to a hormone. (3 marks)
5 Hormones are not the only chemical signals in a multicellular organism. Identify one other type of chemical signal. (1 mark)
6 Describe a pheromone. Give an example of an animal pheromone and a plant pheromone. (3 marks)
Analytical processes
7 D istinguish between up-regulation and downregulation of cell membrane receptors. How is each process achieved? (4 marks)
Learning intentions and success criteria
endocrine system a system of glands that secrete hormones into the bloodstream to regulate body function and homeostasis
→ The endocrine system consists of glands that secrete hormones to regulate body functions and maintain homeostasis.
→ Hormones are secreted by glands and act on the recognition sites of specific tissues and cells.
→ The hypothalamus is known as the “control centre” of the endocrine system because it releases hormones that stimulate or suppress the release of hormones from the pituitary gland.
→ The pituitary gland is known as the “master gland” of the endocrine system because it produces hormones that control the functions of other endocrine glands.
The endocrine system is the body’s messenger system that controls feedback loops through the release of hormones. The endocrine system works alongside the nervous system to coordinate and maintain homeostasis. It is thought that these two systems originated and developed side by side, as the increasing size and complexity of organisms made intercellular communication more important.
Pituitary
Adrenal gland

Pineal gland
Hypothalamus
Thyroid and parathyroid
Pancreas
FIGURE 1 Positions of the main endocrine organs. Females have ovaries and males have testes as part of their endocrine system.
In mammals, hormones are produced in ductless endocrine glands. These glands pass their secretions directly into the blood vessels until the hormones reach their target tissue or target cells.
The main glands of the endocrine system are the hypothalamus, pituitary gland , thyroid, adrenal gland, pineal gland, pancreas and reproductive organs (testes and ovaries). Despite their physical separation from each other, endocrine glands do not work in isolation. Many hormones interact with each other to bring about a particular response. Stimuli that may trigger the release of a hormone include:
endocrine glands glands in animals that respond to signals from the CNS to release hormones into the bloodstream
hypothalamus a gland in the brain that maintains homeostasis of several factors and influences some social and reproductive behaviours
pituitary gland a gland in the brain that controls growth, metabolism and the activity of other endocrine glands
• the presence of a specific metabolite in the blood
• the presence of another hormone in the blood
• stimulation by the autonomic nervous system.
Each hormone brings about an effect only on specific body cells. These target cells have recognition sites for specific hormones. A hormone can influence a target cell by:
• changing the permeability of the membrane to specific chemicals
• influencing enzymes located in the membrane
• influencing cell organelles
• activating genes to bring about specific protein production.
Hormones are slow acting compared to the rapid electrical signals of the nervous system. The process of stimulating the release of a hormone into the bloodstream, the hormone travelling through the bloodstream to the target cell, and the response of the target cell, all take time. Because hormones are molecules that travel in the bloodstream until they bind to a target cell, their effect is relatively long-lasting compared to the effect of signals in the nervous system. Some hormones are self-regulating and respond directly to changes in chemicals in the bloodstream. For example, blood sugar levels are detected directly from the bloodstream by the pancreas, which responds by secreting either insulin or glucagon.
Hypothalamus
Anterior pituitary

The hypothalamus is an important part of the human brain. In humans it is located at the base of the brain, roughly behind the nose. It has direct roles in homeostasis and the release of hormones, and it signals to other glands to release hormones. The hypothalamus monitors factors in the brain and other locations in the body by interpreting chemical signals in the bloodstream. It is often referred to as the “control centre” of the endocrine system. The hypothalamus coordinates a response with the pituitary gland to respond to changes detected. Responses triggered by the hypothalamus may be part of a negative or positive feedback system.
The pituitary gland is located just below the hypothalamus. It has two lobes.
• The anterior pituitary lobe accounts for 80% of the pituitary gland and functions to produce and release hormones.
• The posterior pituitary lobe stores and releases neurohormones produced in the hypothalamus.
The pituitary gland is known as the “master gland” of the body, because it produces hormones that can act all around the body and control the function of other glands in the endocrine system. For example, the anterior pituitary gland releases antidiuretic hormone, which acts on the kidneys to influence osmoregulation and stimulates oxytocin to induce the contractions of childbirth in women. The pituitary gland also distributes some hormones synthesised by the hypothalamus, including follicle-stimulating hormone, thyroid-stimulating hormone and human growth hormone. Hormones released by the pituitary gland can regulate growth and metabolism and can also switch many other glands on or off, including the thyroid, mammary glands, ovaries and testes.
Ovaries
Kidneys
Uterus smooth muscle
Anterior pituitary lobe
Posterior pituitary lobe
Testes
Bones, tissues
Mammary glands
Mammary glands
Thyroid gland
Adrenal cortex
Anterior pituitary lobe
3 Hormones released from the anterior and posterior lobes of the pituitary gland
TABLE 1 The major human endocrine glands, the hormones they produce and their functions
Endocrine gland Hormone produced Major function
Hypothalamus Releasing and release-inhibiting hormones Control release of hormones from adenohypophysis (anterior pituitary)
Hypothalamus via neurohypophysis (posterior pituitary)
Oxytocin
Antidiuretic hormone
Stimulates release of milk and uterine contractions
Stimulates reabsorption of water in kidney
Endocrine gland Hormone produced
Adenohypophysis (anterior pituitary)
Adrenocorticotropic hormone
Major function
Stimulates adrenal cortex
Follicle-stimulating hormone (FSH) Stimulates development of ovarian follicles and seminiferous tubules
Luteinising hormone (LH) Stimulates ovulation and progesterone and testosterone production
Melanocyte-stimulating hormone
Prolactin
Stimulates dispersion of pigment (melanin) in the skin of amphibians; stimulates melanin production in humans
Maintains lactation after pregnancy; maintains secretion of progesterone during pregnancy
Thyroid-stimulating hormone (TSH) Stimulates thyroid gland
Growth hormone
Thyroid Thyroxine and tri-iodothyronine
Calcitonin
Parathyroid Parathyroid hormone
Adrenal cortex
Glucocorticoids, e.g. cortisone
Mineral steroids, e.g. aldosterone
Adrenal medulla Adrenalin, noradrenalin
Pancreas Glucagon
Insulin
Glands in stomach lining Gastrin
Glands in duodenum lining Secretin
Pancreozymin
Cholecystokinin
Ovary Oestrogens
Progesterone
Promotes growth
Increase metabolic rate by stimulating cellular respiration; important role in growth, tissue development and differentiation
Acts in opposition to calcitonin – brings about removal of calcium from bone; increases reabsorption of calcium in the kidney, raising blood calcium level
Regulate carbohydrate metabolism
Regulate salt and water metabolism
Prepare animal to meet emergency conditions, e.g. fight, flight or shock, by increasing heart rate and blood supply to skeletal muscles, lungs and liver, and raising blood sugar level
Increases blood sugar level by converting glycogen to glucose
Decreases blood sugar level by stimulating formation of glycogen
Maintains flow of gastric juice
Stimulates secretion of intestinal juices
Stimulates secretion of pancreatic juice
Stimulates release of bile from gall bladder
Initiate and maintain female secondary sexual characteristics; initiate thickening of uterus lining; control FSH and LH secretions
Maintains thickening of uterus lining; inhibits FSH and LH
Testis Testosterone Initiates and maintains male secondary sexual characteristics
Check your learning 10.7
Check Your Learning 10.7: Complete these questions online or in your workbook.
Retrieval and comprehension
1 Describe the role of endocrine glands in bringing about change in the body. (x marks)
2 Describe the function of the pituitary gland. (1 marks)
3 Identify two of the endocrine glands controlled by the pituitary gland. (2 marks)
4 Identify three hormones are secreted by the posterior pitutary lobe and describe which structures they act on in the body. (6 marks)
5 Explain what is meant by the endocrine system being “long-lasting” and “slow acting”. (2 marks)
Knowledge utilisation
6 “A hormone can act on every cell in the body.”
Evaluate this statement. (3 marks)
• Organisms must regulate their body systems by monitoring their internal and external environments.
• Organisms maintain homeostasis according to their tolerance ranges for a variety of abiotic conditions.
• Homeostasis describes the maintenance of an organism’s body systems through positive and negative feedback loops.
• The stimulus–response model allows organisms to detect environmental changes and respond to maintain homeostasis.
• The structure and distribution of the nervous system within an organism allows for communication between organs and response to stimuli.
• The structure and function of neurons enable a variety of signals to be transported between and within body systems.
• The generation and propagation of an impulse within a neuron determines how, when, and whether a signal is sent through the nervous system.
• Neurons transmit signals to each other and to other cell types, such as muscle cells.
• The mammalian nervous system is organised into central and peripheral nervous systems.
• The brain is part of the central nervous system and communicates with the rest of the body through the brainstem.
• Sensory pathways between the peripheral nervous system and the central nervous system are made of afferent neurons, interneurons and efferent neurons.
• Reflex arcs, or reflexes, are the fastest neural pathways and are an evolutionary adaptation for survival.
• Practical: The reflex arc
• Internal and external environmental changes are detected by sensory receptors in the PNS
• Sensory receptors send signals through the PNS to the CNS for processing and to coordinate a response.
• Sensory receptors are specialised for the different types of information they detect, including pressure, temperature, smell, taste, light and movement.
• Types of sensory receptors are chemoreceptors (taste and smell), mechanoreceptors (movement), thermoreceptors (heat), photoreceptors (light) and nociceptors (pain).
• Hormones are chemical messengers produced by an organism to regulate the activity of cells and organs.
• Each hormone regulates and controls the activity of specific target cells and tissues.
• Hormone activity is slow-acting and long-lasting.
• Signal transduction is a set of chemical reactions in a cell that occurs when a molecule, such as a hormone, attaches to a receptor on the cell membrane.
• The endocrine system consists of glands that secrete hormones to regulate body functions and maintain homeostasis.
• Hormones are secreted by glands and act on the recognition sites of specific tissues and cells.
• The hypothalamus is known as the “control centre” of the endocrine system because it releases hormones that stimulate or suppress the release of hormones from the pituitary gland.
• The pituitary gland is known as the “master gland” of the endocrine system as it produces hormones that control the functions of other endocrine glands.
Review questions: Complete these questions online or in your workbook.
1 Homeostasis can be defined as
A a self-regulating process to maintain balance in the body of an organism.
B the release of hormones from a gland to act on a target cell.
C an adaptation that allows endotherms to maintain a constant body temperature.
D the control of water in the body through signals from the hypothalamus to the kidneys.
2 Hormones
A are sent through neurons between the peripheral and central nervous systems.
B are produced by the endocrine system.
C are only produced by the brain.
D act faster than signals in the nervous system.
3 Chemoreceptors are sensory receptors that detect
A chemicals.
B pressure.
C temperature.
D light.
4 An example of a positive feedback loop is
A the balance of glucose in the bloodstream.
B vasodilation and vasoconstriction.
C release of ADH.
D the hormonal triggers of childbirth.
5 Which of the following statements concerning feedback mechanisms is correct?
A Positive feedback results in the reversal of an existing condition.
B Positive and negative feedback result in further change in the direction of an existing condition.
C Negative feedback results in the reversal of an existing condition.
D Positive feedback reinforces negative feedback.
6 The function of the pituitary gland is to
A regulate the uptake and use of carbohydrates.
B stimulate the body into a state of readiness for physical exertion.
C regulate growth and influence the activities of the other endocrine glands.
D control the rate of mental and physical development.
7 Look at the diagrams of four types of nerve cells.
8 A nociceptor responds to
A mechanical forces such as pressure or distortion.
B extremes in temperature.
C relatively short wavelengths of light.
D signals from damaged tissue or cells.
Review questions: Complete these questions online or in your workbook.
9 D escribe the mechanism of a nerve impulse moving along a neuron, from the arrival of the neurotransmitter at the receptor to the release of the cell’s own neurotransmitter. Include the following words in your description: signal transduction, ion channels, action potential, dendrites, axon, synapse, vesicle. (4 marks)
10 Identify two advantages in the body of controlling physiological processes by the action of hormones compared with nervous control. (2 marks)
11 A nalyse which one of the three species (A, B or C) is most likely to possess myelinated nerve fibres, based on the data provided in Table 1. Give a reason for your answer. (3 marks)
12 D iscuss how living organisms detect changes in their environment. (4 marks)
A teacher is measuring the reaction time of students in a series of ruler drop tests. They want to establish whether reaction time will decrease after practice. In the ruler drop test, each student is given a 30 cm r uler, which is held directly above their open hand. The teacher then instructs the students so that when they see the ruler drop, they must try to catch it as quickly as possible. The teacher starts a stopwatch as soon as the ruler is dropped, and times when the ruler is caught. They also measure the distance that each ruler drops, in cm. The greater the number, the further the ruler has passed through the student’s hand.




Results of ruler drop test over five trials
Apply understanding
1 Identify the stimulus and the response in this experiment. (2 marks)
2 Calculate the average reaction time for each trial. (5 marks)
Analyse data
3 The data table shows that Student 10 took 400 ms to catch a ruler that had a drop distance of 20 cm
Explain why this data point may be classed as an outlier and identify a possible reason for this outlier occurring in the experiment. (2 marks)
Interpret evidence
4 Based on the average reaction time you calculated for each trial, draw a conclusion about what the data suggests about average reaction time in response to practice. (2 marks).

Living things have adapted to Earth’s wide range of ecosystems with varying water availability and temperature ranges. Plants and animals have different strategies for adjusting to the abiotic pressures of their environment. Plants rely primarily on structural adaptations controlled by concentration gradients and hormones to maintain water balance and protect themselves from extremes of temperatures. While animals also benefit from structural adaptations and hormonal signals, they have the additional advantage of a nervous system and the ability to move. This means that animals can change their behaviour to help them survive in their environment.
knowledge quiz
Check your understanding of concepts related to thermoregulation and osmoregulation before you start.
→ Explain thermoregulatory mechanisms of endotherms, including – structural features: brown adipose tissue, insulation – behavioural responses: kleptothermy, hibernation, aestivation and torpor – physiological mechanisms: evaporative heat loss, thermogenesis and vasomotor control.
→ Explain thermoregulation in humans, including the role of sweating, shivering, vasodilation and vasoconstriction using feedback control diagrams.
→ Explain osmoregulation in humans, including the role antidiuretic hormone (ADH) and the kidney using feedback control diagrams.
→ Explain how structural and homeostatic mechanisms maintain water balance in plants, including the roles of stomata, vacuoles, cuticle and abscisic acid.
→ Interpret data from an experiment comparing the number and distribution of stomata in plants adapted to different environments.

→ Appreciate that – understanding natural systems can lead to advances in technology and engineering. For example, computer models of human thermoregulation responses, including heat transfer, perspiration, respiration and blood flows, have been developed for use in the design of clothing and environments that aim to protect humans from hyper- and hypothermia.
Science inquiry
→ Investigate – tolerance limits for water or salt balance on plant growth – structural, behavioural, physiological and/or homeostatic mechanisms used by different species to control heat exchange/metabolic activity/water balance – the use of hormones in agriculture.
→ Compare the number and distribution of stomata in plants adapted to different environments.
Biology 2025 v1.0
Lesson 11.6 The role of the leaf in plant osmoregulation
Lesson 11.7 Investigating tolerance limits for water or salt balance in plant growth
→ Thermoregulation allows organisms to maintain their body temperature within its tolerance range for survival.
→ Metabolic processes produce heat that is lost to the environment; organisms have behavioural strategies and physical features to reduce or increase this heat loss, to maintain homeostasis.
→ Ectotherms gain heat from their environment, while endotherms maintain a stable body temperature by generating heat through metabolic processes.
Thermoregulation is the set of processes that maintains an optimal body temperature for the survival of an organism. Different species have varying optimal temperatures and temperature tolerance ranges, depending on their adaptations to the environment.
Thermoregulation in warm-blooded animals, such as humans, requires the coordination of the nervous and endocrine systems to exert control over a variety of processes and functions within the body. Maintenance of an optimal body temperature through thermoregulation allows efficient cellular functions and enzymatic reactions. The thermoregulatory strategies of animals can be categorised as behavioural, physiological or structural. Organisms can also be grouped into one of two categories of thermoregulation:
• ectotherms, which absorb heat from their external surroundings
• endotherms, which generate most of their heat through internal processes.
Ectotherms obtain most of their heat by absorbing it from their surroundings. Ectotherms are sometimes referred to as coldblooded. However, their blood is rarely cold. It is, in fact, a similar temperature to that of the surrounding environment. Ectotherms still have an optimal temperature and temperature tolerance range, so they modify their behaviour to maintain an ideal temperature. On a cold morning, for example, a snake might lie on a rock in an open area to absorb as much heat from the sun and the rock as possible. As the sun rises and the temperature increases, the snake’s body may approach its maximum tolerable temperature, so the snake will move to a shadier location to increase heat loss. All ectotherms maintain homeostasis of temperature in this way, by balancing heat gained with heat lost to the surroundings.

Learning intentions and success criteria
thermoregulation the maintenance of internal body temperature within a tolerable range for an individual; may be achieved through behavioural or physiological processes ectotherm an animal that maintains its internal body temperature by gaining heat from, and losing heat to, the external environment endotherm an animal that maintains a constant internal body temperature in fluctuating environmental temperatures


Endotherms are often referred to as warm-blooded. They generate most of their heat through internal metabolic processes, which allows them to survive in a wide range of climatic conditions. They have a variety of physiological strategies to maintain their core temperature within a narrow range. Physiological strategies include coordination between the nervous and endocrine systems to produce responses such as sweating, shivering, vasodilation and vasoconstriction. You will learn more about these strategies in Lesson 11.2.
The best of both worlds
Dinosaurs are considered mesotherms (“meso” means half), because they had characteristics of both ectotherms and endotherms. Endotherms grow 10 times faster than ectotherms and their metabolism is 10 times faster. Dinosaurs, however, had a metabolic rate halfway between endotherms and ectotherms.

1 In Table 1, identify which characteristics of dinosaurs are similar to those of ectotherms and which are similar to those of endotherms. (2 marks)
TABLE 1 Characteristics of dinosaurs
Characteristic of mesotherm
Doesn’t raise metabolism to keep warm by shivering
Doesn’t maintain a constant temperature
Ectothermic or endothermic characteristic?
Check your learning 11.1: Complete these questions online or in your workbook.
Retrieval and comprehension
1 E xplain one advantage and one disadvantage of ectothermic thermoregulation. (2 marks)
2 Define the term “thermoregulation”. (1 mark)
3 Describe one example of an endotherm and list two physiological responses to cold temperatures. (3 marks)
Analytical processes
4 C ompare the thermoregulatory responses of ectotherms and endotherms to high environmental temperature. (3 marks)
→ Endotherms have many thermoregulatory mechanisms to maintain their core temperature within a narrow range.
→ Structural features that aid in thermoregulation include:
– insulating layers of fat (e.g. blubber), which allow some animals to retain heat in very cold or aquatic environments
– brown adipose tissue, which contains a high concentration of mitochondria to increase heat generation.
→ Behavioural responses that aid in thermoregulation include:
– torpor, a short-term behaviour characterised by daily periods of inactivity
– extended periods of torpor, such as aestivation in high temperatures and hibernation in low temperatures
– kleptothermy.
→ Physiological mechanisms that aid in thermoregulation include:
– evaporative heat loss
– thermogenesis
– vasomotor control.
The core temperature of endotherms is maintained within a narrow but constant range, allowing reliable functioning of essential enzymes. The movement of muscles requires production of ATP through cellular respiration, which also generates heat. Retention of generated heat allows animals to survive in lower environmental temperatures. Loss of heat allows animals to survive in higher environmental temperatures. To survive in a variety of climates, endotherms have evolved advantageous thermoregulatory mechanisms.
Learning intentions and success criteria core temperature the temperature of the internal organs in the body
insulator
a structure used to prevent heat loss to the environment
blubber
a thick layer of fat directly beneath the skin of marine animals
Two structural features of endotherms that act as thermoregulatory mechanisms are insulation and brown adipose tissue.
An insulator is a material or substance that covers something and prevents it from losing heat. Many animals have a layer of fat under their skin to add a layer of insulation. This fat layer builds up in the approach to winter, to minimise heat lost by radiation from the skin to the surrounding air or water. Marine mammals rely heavily on this adaptation and have an extremely thick layer of fat under the skin, called blubber. Blubber is advantageous compared to a thicker layer of fur on the outside of the skin, because it allows the skin surface to remain smooth for ease of movement through water. Additionally, marine mammals, such as whales, can draw on this high-energy resource when food is limited. Other animals have layers covering their skin, such as fur or feathers. These additional layers help trap heat close to the body and prevent excess heat from being lost to the external environment.



brown adipose tissue
a type of body fat containing a high concentration of mitochondria to generate energy and heat
Some animals, including humans, have a special type of fat, called brown adipose tissue, that can rapidly produce heat. Brown adipose cells have a high concentration of mitochondria, which allows them to produce large amounts of ATP and generate heat. This is gives endotherms an advantage over ectotherms, as they can remain active when external temperatures drop. However, they must consume more food to meet the glucose demands of the mitochondria.

Human babies are particularly vulnerable to heat loss, because of their small size and high skin surface area. They are also unable to communicate that they are cold or perform actions such as putting on a jumper. In their first months of life, human babies are also unable to shiver to stay warm. During pregnancy, the body temperature of a baby is maintained by the mother, but after birth babies must thermoregulate themselves to survive their environment. To increase their chances of survival until they develop the ability to shiver in response to cold temperatures, babies are born with deposits of mitochondria-dense brown adipose tissue on their back and chest. The brown adipose cells are dense in mitochondria and generate energy and heat to assist in maintaining the baby’s core temperature. It is not only human babies that have brown adipose tissue to assist in thermoregulation; many small mammals also use this physiological strategy to inhabit cold climates.
Apply your understanding
1 E xplain why being small in size makes a baby vulnerable to heat loss.
2 Determine why adults do not need large amounts of brown adipose tissue.
3 Suggest three other small mammals that are likely to have brown adipose tissue to support thermoregulation.
Animals have a variety of behaviours to regulate their body temperature according to the pressures of their environment. In environments where daytime temperatures are too hot for activity, animals may be active only at night; in colder environments, animals may be more active during daylight hours when it is slightly warmer. Some endothermic behavioural responses that aid in thermoregulation are kleptothermy, torpor, hibernation and aestivation.
Kleptothermy is a behaviour seen in many species, including bats and penguins. It involves individuals huddling together to share body heat and reduce heat loss from the group. An example is emperor penguins huddling together on an ice shelf in an Antarctic winter. In these group huddles, the penguins also rotate position from the inside to the outside of the group, to reduce the risk of hypothermia for any one individual.
kleptothermy the sharing of heat between individual animals to maintain thermoregulation
You might have heard of “kleptomania”, a psychological condition that causes people to compulsively steal things they don’t need. The prefix “klepto-” means to steal and “thermo-” means heat, so kleptothermy means to steal heat.

torpor
a short-term state of reduced activity in an animal, including metabolic rate and movement, triggered by shortterm fluctuations in temperature
hibernation
a long-term state of reduced activity in an animal, including metabolic rate, movement and changes to blood flow, triggered by seasonal drops in temperature
Some animals respond to short periods of limited resources or inhospitable conditions by entering a state of torpor. Torpor is a state of slowed breathing and heart rate, reduced physical activity and minimal response to external stimuli. This allows the animal to conserve energy for a short period of time (hours or days) until environmental conditions or food availability improve.
Hibernation is an extended period of torpor, usually over a winter season, characterised by animals sleeping and reducing their body temperature and metabolic activity. During a state of hibernation, the animal’s energy expenditure and temperature are reduced, which reduces demand on its body, allowing the animal’s energy reserves to keep it alive for up to six months. In the lead-up to hibernation, animals produce and store large amounts of brown adipose tissue, as this can be used to produce energy and heat at low temperatures. The brain, heart and other essential organs are prioritised, as vasoconstriction draws warm blood away from the extremities to the torso.
Many hibernating animals wake periodically rather than remaining asleep for the duration of their hibernation. This waking is thought to be triggered by the animal’s core temperature falling too low, allowing thermoregulation strategies to raise the core temperature to within the tolerance range before the animal goes back to sleep. The main difference between torpor and hibernation is the length of time: torpor is a short-term state (hours or days), while hibernation is a long-term state (months).

Aestivation is the term for an extended period of torpor in conditions of extreme heat and/or low water availability. Species of amphibians, fish, mammals and reptiles use aestivation to survive hot, dry summers in arid environments, such as deserts and seasonal water bodies. In aestivation, an animal will usually find a cooler or wet spot and enter an extended period of torpor. This avoids the expenditure of energy that would have been needed to cool the animal or to prevent loss of water.
Ranoidea platycephala, also known as the water-holding frog, enters a state of aestivation during periods of drought or dry summers. It stores a large amount of water under its skin and buries itself in the ground. These frogs can stay buried and in a state of aestivation for up to three years.

5 The Australian water-holding frog will enter a period of aestivation when temperatures are too high, or when water availability is too low.
Physiological mechanisms that aid in thermoregulation include evaporative heat loss, thermogenesis and vasomotor control.
Evaporation is the process in which molecules of water change from liquid to gaseous state. To change from liquid to gas, water molecules must absorb heat energy from the surrounding environment; in turn, this cools the surface from which the liquid has evaporated. Evaporative heat loss occurs when water or liquid from an organism is brought to an external surface by panting, sweating or licking of limbs. When liquid is brought to the surface, it evaporates, moving heat energy away from the body to the surrounding environment, cooling the organism.

In extremely low temperatures, preventing heat loss may be insufficient to maintain an optimal body temperature. Endotherms produce additional heat in a process called thermogenesis. Heat production can be increased by raising the metabolic rate through rapid muscle contraction (moving around or shivering) and through production of hormones that stimulate metabolic activity.
Research hibernation and torpor and find some examples of animals that use each of these strategies. Having examples of real animals that use these strategies will provide context to help you remember the difference between them.
aestivation an extended period of torpor in conditions of high temperature and/or low water availability
evaporative heat loss the process in which heat is lost when a liquid is converted to gas
thermogenesis the internal generation of heat by an organism
Remember that ‘constrict’ means to squeeze and get smaller, like a boa constrictor squeezing its prey. Remember that ‘dilate’ means to open up and get bigger, the way your pupils dilate to let more light in when you walk into a dark room.
vasodilation the widening of blood vessels close to the surface of the skin, to increase heat loss to the environment through radiation
vasoconstriction the narrowing of blood vessels close to the surface of the skin, to reduce heat loss to the environment through radiation
Small animals lose heat faster than large animals, due to their high body surface area to volume ratio. The more an animal’s body surface is exposed to air, the faster it will lose heat. Animals can minimise heat loss by vasomotor control, which is the ability to control the opening of blood vessels (vasodilation) or constriction of blood vessels (vasoconstriction). For example, the arms and legs of animals tend to have a high surface area available to lose heat to the surrounding environment. Vasoconstriction in the body’s extremities, such as arms and legs, decreases the blood flow to these areas, reducing the temperature gradient between the skin and environment and slowing the rate of heat loss. Additionally, some animals have a counter-current heat exchange system in their blood vessels. This involves the intertwining of arteries and veins to reduce the temperature of blood moving through the arteries to the extremities as it is transferred to the veins returning to the heart.
Check your learning 11.2
Check your learning 11.2: Complete these questions online or in your workbook.
Retrieval and comprehension
1 Describe kleptothermy and provide an example. (2 marks)
2 Define torpor. (1 mark)
3 E xplain why brown adipose tissue is helpful in thermoregulation. (2 marks)
Learning intentions and success criteria
4 E xplain what happens if the body temperature of a hibernating animal drops too low. (2 marks).
5 E xplain evaporative heat loss as a thermoregulatory strategy of animals. (3 marks)
Analytical processes
6 C ontrast hibernation and aestivation. (2 marks)
→ The human body uses negative feedback systems to respond to temperatures outside its optimal range and maintain a constant temperature.
→ The hypothalamus in the brain receives information from thermoreceptors and responds by triggering the release of hormones to adjust heat generation and heat loss accordingly.
→ Sweating and vasodilation are mechanisms that are triggered to promote heat loss.
→ Shivering and vasoconstriction are mechanisms that are triggered to generate and conserve heat.
Like other endotherms, humans maintain a constant body temperature through negative feedback systems. When the brain detects that the temperature of the body is rising above optimal, it responds by triggering actions that promote heat loss and reduce heat production.
If the brain detects that body temperature is too low, it responds by triggering actions that conserve and generate heat.
Thermoreceptors that detect heat and cold are spread throughout the skin, the veins and the hypothalamus in the brain. The hypothalamus receives information from thermoreceptors around the body and acts as a thermostat, responding appropriately to drops and spikes in body temperature. As these signals pass through the brain, a person becomes aware of the change in temperature and can also respond by changing their behaviour (e.g. putting on or taking off a jumper).


In humans, when body temperature is detected as being higher than usual, thermoregulatory mechanisms such as sweating and vasodilation help return the body to an optimal temperature. These actions are controlled by the heat-loss centre in the hypothalamus.
Sweating is the secretion of water and salt by sweat glands in the skin. It cools the body by evaporative heat loss as the sweat evaporates. Because a large amount of energy is needed to cause sweat to evaporate (from liquid to gas), sweating is an effective method of cooling the body. It is particularly effective for humans, who have little hair and many sweat glands in their skin. Sweating is a less effective method of heat loss in humid conditions, because the reduced diffusion gradient slows the rate of evaporation from the skin.

sweating a thermoregulatory response that releases liquid from the body’s sweat glands
shivering an involuntary motor response that causes muscle contractions to generate heat
As you learnt in Lesson 11.2, vasodilation is the widening of blood vessels. The hypothalamus triggers vasodilation to move blood closer to the skin of the organism. Increasing the amount of blood circulating closer to the skin allows more heat to be lost to the environment through radiation, and through evaporative heat loss in combination with sweating.
FIGURE 3 Vasodilation and vasoconstriction.
The hypothalamus responds to cold temperatures by stimulating the pituitary gland to produce thyroid-stimulating hormone (TSH). TSH triggers the thyroid to release the hormone thyroxine, which acts on various organs and cells to increase the rate of metabolism and heat production. This coordinated response between the nervous and endocrine systems allows endotherms to survive in climates colder than their optimal core temperature. To reach an optimal body temperature, the hypothalamus will also activate its heat-promoting centre to trigger the thermoregulatory mechanisms of shivering and vasoconstriction.
Shivering is an involuntary muscular response controlled by the central nervous system that causes muscles in the body to contract and shake. Like all muscle movement, this forced movement of muscles generates heat, which helps to raise the core body temperature.
As you learnt in Lesson 11.2, vasoconstriction is the constriction or tightening of blood vessels. Blood that flows closest to the skin of a human is the most susceptible to losing heat, particularly in cold climates. When the body detects a drop in core temperature, the hypothalamus triggers vasoconstriction to reduce the amount of blood flowing close to the skin. This prevents excessive heat from being lost to the environment.
Activates heat-loss centre in hypothalamus.
Vasodilation causes blood to flow closer to the skin, allowing increasing heat loss from skin surface.



Stimulus: Increased body temperature
Sweat glands secrete sweat on the surface of skin to allow the body to cool down via evaporative heat loss.
Homeostasis = normal body temperature
Body temperature increases and hypothalamus shuts o heat-promoting centre.
Vasoconstriction diverts blood away from surface of skin to prevent excess heat loss.
Body temperature decreases and hypothalamus shuts o heat-loss centre.
Skeletal muscles contract to generate heat via shivering.
Stimulus: Decreased body temperature



Activates heat-promoting centre in hypothalamus.
Study tip
Practise drawing flowcharts of feedback loops to help you remember the relationships between receptors, effectors and the control centre.
can save
Intentionally reducing body temperature to treat injury has been recorded as far back as 3000 BCE in Ancient Egypt. While induced hypothermia has been a topic of great scientific debate, it is currently used by medical professionals in some situations, including treatment of heart attack patients. When the heart suddenly stops pumping blood, the available oxygen and waste products in the blood become out of balance. Dangerous levels of waste
products may build up even after the heart has been restarted, potentially causing irreversible damage to the brain and other vital organs. When emergency doctors induce hypothermia by cooling the body to between 32 and 34 degrees Celsius, the heart slows and this slows the body’s metabolic rate. With less waste produced and less oxygen demanded by metabolism, the body can gradually return to homeostasis before being safely warmed again.
Body temperature will slowly decrease to 32.8 to 33.3 degrees Celsius. The patient can then be transferred to another part of the hospital.
Water hoses connected to pads carry water heated to a specific temperature.
Special pads are fitted around the patient’s thighs and chest.
Apply your understanding
1 E xplain why slowing the heart rate reduces metabolic rate. (3 marks)
Specialised pads
The patient’s body returns to a normal temperature after 12 to 24 hours.
2 Identify one example of a waste product that may build up in the bloodstream if the metabolic rate is not slowed. (1 mark)
Check your learning 11.3
Check your learning 11.3: Complete these questions online or in your workbook.
Retrieval and comprehension
1 Identify the part of the brain that receives information about temperature. (1 mark)
2 Summarise the thermoregulatory mechanisms in humans that cool the body in response to an increase in body temperature. (2 marks)
3 Summarise the thermoregulatory mechanisms in humans that warm the body in response to a
decline in body temperature. (2 marks)
Knowledge utilisation
4 Draw a conclusion about the effect of high temperatures on enzymes in the body if thermoregulation did not occur. (2 marks)
5 Evaluate whether the feedback diagram in Figure 4 is an example of a positive or negative feedback loop. (2 marks)
→ Osmoregulation is the process of regulating the balance of water and salts (osmotic balance) in the body.
→ Osmoregulation in humans is controlled primarily through promotion or inhibition of water loss from the kidneys in urine production to remove waste.
→ Nephrons are the main structure of waste removal in the kidneys and allow waste such as urea to be filtered from the blood to produce urine, which collects in the bladder and is excreted through the urethra.
→ The hypothalamus in the brain detects hydration in the bloodstream and produces the hormone ADH to signal to the nephrons whether to retain or release water, to maintain optimal water levels in the body.
Learning intentions and success criteria
Water and salts are essential for many cellular processes. However, like many substances in the human body, the ideal balance of water and salt in the body, also known as osmotic balance, lies within a narrow range. If the concentration of water or salts is too low or too high, it can disrupt normal body functioning.
Salts are important for maintaining water balance, which is needed for the functioning of muscles and nerves. When there is too much water in the body, the concentration of salts in the blood can become too low. This is known as low osmolality. Excess water can cause cells in the body to swell, and reduced levels of salts can interfere with the functioning of muscles and nerves. Symptoms of hyponatraemia , which is when the amount of sodium in the blood is below the optimal level, include headaches, nausea, muscular problems and low blood pressure.

osmotic balance the balance of water and salt concentrations in the body
osmolality the concentration of particles dissolved in a fluid
hyponatraemia a condition that results from low levels of sodium in the blood
osmoregulation the process by which an organism maintains an internal balance between water and dissolved materials
antidiuretic hormone (ADH) a hormone that triggers the kidneys to release less water, reducing the amount of urine produced
When there is insufficient water in the body, osmolality increases and the concentration of salt in the blood may exceed optimal levels. This imbalance can cause water to be drawn out of cells, causing the cells to shrink and become dehydrated. High osmolality can impair cellular function, and cause symptoms such as dry mouth, weakness and mental confusion. High osmolality can also result in dehydration, electrolyte imbalance and organ dysfunction. Osmoregulation is the process of regulating the balance of water and salts (osmotic balance) in the body. In humans, osmoregulation is facilitated by the kidneys and antidiuretic hormone (ADH)
Remember from Lesson 6.3 that the excretory system facilitates the reabsorption of water and salts back into the bloodstream during excretion of liquid waste. Blood enters the kidneys through the renal arteries, which divide into several arterioles that deliver blood to a collection of capillaries, called the glomerulus, at the beginning of each nephron in the kidney. Water, dissolved waste and ions, and a small amount of protein diffuse from the capillaries in the glomerulus into the space of Bowman’s capsule, where the solution begins its passage through the nephron. This solution that passes through the nephron is referred to as the filtrate. Red blood cells and most of the proteins in the blood plasma are retained in the capillaries and do not pass through the nephron.
The filtrate moves through the proximal convoluted tubule, where some proteins, glucose, ions and water are reabsorbed into the bloodstream. As the filtrate moves down the loop of Henle, water and sodium ions are absorbed back into the interstitial fluid and bloodstream. As the filtrate moves around the bend at the bottom and moves back up the loop of Henle, sodium ions are pumped out into the interstitial fluid and bloodstream. Finally, the filtrate reaches the distal convoluted tubule and collecting duct, where more water is reabsorbed before the filtrate moves to the bladder to be excreted as urine.
Bowman’s capsule
Glomerulus
Proximal convoluted tubule
Distal convoluted tubule

Collecting duct
The amount of water reabsorbed from filtrate at the distal convoluted tubule and collecting duct is controlled by the production of ADH. ADH is produced within the hypothalamus (in the brain) when osmoreceptors, receptors that detect changes in osmotic balance, detect low concentrations of water in the bloodstream. The production of ADH triggers the sensation of thirst, and ADH is transferred to the pituitary gland, where it is released into the bloodstream. Once ADH in the bloodstream reaches the kidney, it increases the permeability of the distal convoluted tubule and collecting duct, allowing more water to be reabsorbed by the body. When water is reabsorbed into the bloodstream, the filtrate becomes more concentrated, resulting in darker, more concentrated urine leaving the body. When the osmoreceptors detect that the water concentration in the blood has returned to a normal level in the bloodstream, ADH production is reduced, and water reabsorption in the nephron and the colour of the urine return to normal.
Increased water intake
Normal water level (in blood)
Osmoregulators in hypothalamus of brain
ADH secretion inhibited, decreased ADH
Increased ADH secretion Rises
Decreased water intake
osmoreceptor a sensory receptor that detects changes in osmotic pressure
Science inquiry skill: Recording data
Antidiuretic hormone (ADH), also known as vasopressin, controls the amount of water in the blood. Osmoreceptor cells in the hypothalamus detect a drop in water levels in the blood, and trigger the pituitary gland to excrete ADH. ADH acts by increasing reabsorption of water in the kidneys.
Reduced reabsorption of water in kidney as permeability of distal convoluted tubule and collecting ducts decreases
Increased reabsorption of water in kidney as permeability of distal convoluted tubule and collecting ducts increases
Copious, dilute urine flow
Relative water level in blood
Low
1 Copy the graph below and identify the following events, by labelling each event along the line.
a ADH is released. (1 mark)
b ADH is supressed. (1 mark)
c Osmoreceptors detect a drop in water levels. (1 mark)
Scant urine flow
Decreased water level
Normal water level (in blood)
Increased water level
High Hours
024681012
Relative water level in blood over time (12 hours)
d Osmoreceptors detect a rise in water levels. (1 mark)
e Urine is dilute. (1 mark)
f Urine is concentrated. (1 mark)
Need help using graphs to represent information? Go to Lesson 1.6 in your biology toolkit (page xx).
Check your learning 11.4
Check your learning 11.4: Complete these questions online or in your workbook.
Retrieval and comprehension
1 Explain the role of the kidneys in osmoregulation. (1 mark)
2 Identify the components of blood that do not diffuse from the glomerulus into the nephron. (2 marks)
3 Describe the locations of ADH production, distribution and action on the body in osmoregulation. (3 marks)
4 Describe how waste products in the bloodstream are removed from the body. (3 marks)
Learning intentions and success criteria
mesophyte
a plant adapted to a habitat that has a frequent and reliable source of fresh water
hydrophyte
a plant adapted to a habitat that is partially or completely submerged in water
→ Plants require a reliable source of sufficient fresh water to maintain their transpiration stream and support photosynthesis for energy production.
→ Plants adapted for different water availability can be categorised as mesophytes, hydrophytes, xerophytes or halophytes.
→ Structural mechanisms that aid in maintaining water balance in plants include stomata, vacuoles and cuticle.
→ Homeostatic mechanisms that aid in maintaining water balance in plants include the production of abscisic acid (ABA).
Most plants are fixed in soil, sand or rock, and are therefore unable to move to find water. Instead, they must rely on the water available in the surrounding substrate to be sufficient for transpiration through the xylem. Because the cell wall of plant cells helps prevent the cells from bursting, they are less vulnerable to inundation with water than animal cells. However, plant cells are vulnerable to dehydration, which can cause the cell membrane to retract away from the cell wall, leading to a highly concentrated cytoplasm and cell death. Plants grow in aquatic and terrestrial environments and in a wide range of temperatures, including those where water can be scarce, due to drought, or inaccessible in its solid form as ice. The Earth’s water ranges from fresh or brackish (slightly salty) in intertidal regions, to highly salty in the oceans. Plants can be grouped according to the environments they live in and the adaptations they have developed to survive different environments.
• Mesophytes have adapted to habitats with a reliable and regular source of fresh water. Mesophytes have no specialised adaptations for obtaining water or preventing water loss, as a constant supply of water is always available.
• Hydrophytes can live partially or fully submerged in water where sunlight penetrates enough for them to photosynthesise.
• Xerophytes have adapted to extremely dry conditions. Xerophytes can be found in areas of extreme heat with little rainfall or in areas of extreme cold where temperatures are rarely high enough for water stored in ice to melt.
• Halophytes have adaptations that allow them to survive in water or soil with high salt concentrations. Some halophytes can only live in saline environments. For example, mangroves are obligate halophytes – their adaptations are so specialised to salty water that they are unable to survive if moved to a freshwater environment. In this lesson you will learn about the different structural and homeostatic mechanisms for maintaining water balance in plants.


xerophyte a plant adapted to a dry habitat
halophyte a plant that has adaptations allowing it to obtain sufficient water in a salty environment

Structural mechanisms to regulate water balance in plants include the stomata, vacuoles and the cuticle
Stomata
As you learnt in Lesson 9.2, a stoma consists of two guard cells, and acts as an entry/exit point for water to transpire out of the plant and CO2 to enter the plant. Changing osmotic pressure in the guard cells opens and closes the stoma. When a plant has excess water, the guard cells swell, causing the stoma to open and water to transpire out from the plant. When a plant is dehydrated, the guard cells shrink, causing the stoma to close, reducing the amount of water lost by transpiration.
Stomatal number and density (number of stomata per unit area of leaf) vary, depending on the environment and conditions a plant is adapted to live in. Table 1 summarises stomatal number and density in plants adapted to different environments.
cuticle a protective film made of cutin that covers the outer layer (epidermis) of leaves
TABLE 1 Summary of stomatal number and density in plants adapted to different environments
Type of plant Number of stomata
Density of stomata
Mesophyte Average Average
Hydrophyte Variable (can be low to high) Variable (can be low to high)
Explanation
Mesophytes have a readily available supply of water.
Stomatal number and density depend on adaptations to aquatic environments and whether leaves are fully or partially submerged in water. For example, water lilies have numerous stomata on the upper surface of their leaves and no stomata on the underside. Fully submerged leaves of hydrophytes can have no stomata.
Xerophyte Low Low Due to dry conditions, xerophytes have fewer stomata, to prevent water loss. Stomata can also be “sunken” into the epidermis to prevent excess water loss in response to heat. Some xerophytes only open their stomata at night when the external environment is cool, to prevent water loss.
Halophyte Low to average Low to average to high

turgor pressure
the pressure exerted by fluid in a cell that presses the plasma membrane against the cell wall
Halophytes grow in saline environments where water availability can be variable. High salt concentrations around a plant can range from scarce to high
B

Recall from Lesson 2.2 that compared to animal cells, plant cells have a large central vacuole in the centre of the cell. The central vacuole in a plant has two major functions.
• It maintains turgor pressure (pressure from fluid within a cell that presses the cell membrane against the cell wall).
• It stores water and nutrients.
Both these functions of the central vacuole are important for plants to maintain water balance. Because vacuoles control turgor pressure, they are important in providing the plant with rigidity, and they regulate the swelling or shrinking of cells (including guard cells, which control the opening and closing of stomata). Vacuoles also act as “storage tanks” for water, for when the plant needs it.
The outermost layer of a plant’s leaf is called the leaf cuticle. The leaf cuticle plays an important role in plant osmoregulation. It provides a protective barrier to prevent the plant from losing water. The cuticle is made of cutin, a polymer that consists of fatty acids and glycerol, which provides structural integrity to the leaf. The permeability of the leaf cuticle influences how much water is lost in dry or hot conditions. Plants with a highly permeable leaf cuticle are more vulnerable to losing water in arid conditions, and plants with low leaf cuticle permeability are less susceptible to losing excess water.
Some plants have an extra layer of wax on top of the cuticle. Because wax is hydrophobic, this waxy cuticle acts as an extra barrier preventing water from passing easily through the leaf. Additionally, a waxy cuticle can help to reflect light and heat away from the plant, helping reduce the rate of transpiration.
Homeostatic mechanisms
All living organisms, including plants, have homeostatic mechanisms to maintain balance in their internal environment. An example of a homeostatic mechanism in plants that aids osmoregulation is the regulation of the plant hormone abscisic acid (ABA)
Abscisic acid

Some plants produce ABA, a plant hormone that regulates several processes including stomatal opening and closing. When these plants experience heat stress or dehydration, ABA is released and acts on ion channels in the leaf guard cells, causing the guard cells to release water and lose turgidity, which closes the stomatal pores. This helps to reduce the rate of transpiration, so the plant can conserve water in times of water stress. When plants are relieved of water stress and rehydrated, production of ABA decreases, allowing regular stomatal opening and closing.
Check your learning 11.5: Complete these questions online or in your workbook.
Retrieval and comprehension
1 E xplain why plants must be so highly adapted to efficiently using water compared to animals. (1 mark)
2 Explain why xerophytes are likely to have fewer stomata than mesophytes. (1 mark)
3 Describe two ways in which a waxy cuticle helps to conserve water in plants. (2 marks)
4 Describe two ways in which the vacuole plays a role in maintaining water balance in plants. (2 marks)
5 E xplain the role of abscisic acid in allowing plants to survive in arid environments. (2 marks)
Analytical processes
abscisic acid (ABA) a plant hormone that regulates numerous aspects of plant growth, development and stress responses
6 Compare hydrophytes and xerophytes. (3 marks) Knowledge utilisation
7 A researcher is investigating the number of stomata on the leaves of two hydrophyte species. They notice that one species only has stomata on the lower surface of the leaves, while the other species has no stomata at all on the leaves. Propose a reason for this difference in stomatal number. (2 marks)
Learning intentions and success criteria
This lesson is available exclusively on Oxford Digital.
Learning intentions and success criteria
11.7
This lesson is available exclusively on Oxford Digital.
Summar y
• Thermoregulation allows organisms to maintain their body temperature within its tolerance range for survival.
• Metabolic processes produce heat that is lost to the environment; organisms have behavioural strategies and physical features to reduce or increase this heat loss, to maintain homeostasis.
• Ectotherms gain heat from their environment, while endotherms maintain a stable body temperature by generating heat through metabolic processes.
• Endotherms have many thermoregulatory mechanisms to maintain their core temperature within a narrow range.
• Structural features that aid in thermoregulation include:
• insulating layers of fat (e.g. blubber), which allow some animals to retain heat in very cold or aquatic environments
• brown adipose tissue, which contains a high concentration of mitochondria to increase heat generation.
• Behavioural responses that aid in thermoregulation include:
• torpor, a short-term behaviour characterised by daily periods of inactivity
• extended periods of torpor, such as aestivation in high temperatures and hibernation in low temperatures
• kleptothermy.
• Physiological mechanisms that aid in thermoregulation include:
• evaporative heat loss
• thermogenesis
• vasomotor control.
• The human body uses negative feedback systems to respond to temperatures outside its optimal range and maintain a constant temperature.
• The hypothalamus in the brain receives information from thermoreceptors and responds by triggering the release of hormones to adjust heat generation and heat loss accordingly.
• Sweating and vasodilation are mechanisms that are triggered to promote heat loss.
• Shivering and vasoconstriction are mechanisms that are triggered to generate and conserve heat.
• Osmoregulation is the process of regulating the balance of water and salts (osmotic balance) in the body.
• Osmoregulation in humans is controlled primarily through promotion or inhibition of water loss from the kidneys in urine production to remove waste.
• Nephrons are the main structure of waste removal in the kidneys and allow waste such as urea to be filtered from the blood to produce urine, which collects in the bladder and is excreted through the urethra.
• The hypothalamus in the brain detects hydration in the bloodstream and produces the hormone ADH to signal to the nephrons whether to retain or release water, to maintain optimal water levels in the body.
• Plants require a reliable source of sufficient fresh water to maintain their transpiration stream and support photosynthesis for energy production.
• Plants adapted for different water availability can be categorised as mesophytes, hydrophytes, xerophytes or halophytes.
• Structural mechanisms that aid in maintaining water balance include stomata, vacuoles and cuticle.
• Homeostatic mechanisms that aid in maintaining water balance include the production of abscisic acid (ABA).
Review questions: Complete these questions online or in your workbook.
1 Organisms that are able to maintain a stable internal temperature are called
A animals.
B ectotherms.
C endotherms.
D mammals.
2 Animals that slow their breathing, heart rate and physical activity for short periods of time to conserve energy in extreme environments are said to be in a state of
A kleptothermy.
B hibernation.
C homeostasis.
D torpor.
3 Strategies for increasing heat loss in high temperatures include
A aestivation, nocturnal activity and vasodilation.
B kleptothermy, nocturnal activity and sweating.
C aestivation, sweating and vasoconstriction.
D aestivation, kleptothermy and vasodilation.
4 The main organ for osmoregulation in humans is
A the bloodstream.
B the kidney.
C antidiuretic hormone (ADH).
D the glomerulus.
5 The component of blood that is unable to pass from the bloodstream into the nephron is
A filtrate.
B ions.
C plasma.
D red blood cells.
6 The structure that detects the amount of water in the bloodstream is the
A glomerulus.
B hypothalamus.
C kidney.
D nephron.
7 Halophytes are plants that are suited to living
A in cold conditions.
B in dry conditions.
C in salty conditions.
D submerged in fresh water.
8 Plants that do not have a waxy cuticle on the surface of their leaves are likely to be
A halophytes.
B hydrophytes.
C mesophytes.
D xerophytes.
Review questions: Complete these questions online or in your workbook.
9 E xplain the function of the nephron in the kidneys, from the glomerulus through the loop of Henle to the collecting duct and the bladder. (4 marks)
10 E xplain the role of antidiuretic hormone in maintaining homeostasis in the human body. (3 marks)
11 Kleptothermy is a strategy used by penguins to stay warm on the ice in Antarctica. Infer why this would not be an effective strategy for reptiles, such as lizards. (2 marks)
Comparing stomatal density in plants adapted to different environments
Stomatal density is the number of stomata per unit area of leaf. It is calculated by counting the number of stomata visible in a microscope’s field of view and then dividing this number by the area of the field of view. A researcher is comparing the stomatal density of two plant species adapted to different environments. What they see in the microscope under ×400 magnification is shown below.
Apply understanding
1 Identify the number of stomata for Species A and Species B. (2 marks)
2 If the radius (r) of the field of view is 0.24 mm, calculate the stomatal density for Species A and Species B using the following:
• Area = πr 2
• Stomatal density = number of stomata ÷ area. (4 marks)
Analyse data
3 Identify which species had the lowest stomatal density. (1 mark)
Interpret evidence
4 Deduce which of Species A or Species B is likely to be a xerophyte (a plant adapted to drier conditions). Justify your answer. (3 marks)
Question 1
Negative feedback describes a process that occurs
A along a concentration gradient.
B to slow or stop a response.
C only in the central nervous system.
D within neurons.
Question 2
The fatty layer that surrounds the axon of a neuron to insulate the electrical signal is called the
A axon terminal.
B dendrite.
C myelin sheath.
D Schwann cell.
Question 3
The solution of water, ions and dissolved waste products that moves through the nephron is called
A blood.
B filtrate.
C plasma.
D urine.
Question 4
Neurons with a voltage of –70 mV across their cell membrane are said to be
A at resting potential.
B depolarised.
C firing an action potential.
D repolarising.
Question 5
Efferent neurons are nerve cells that
A are also known as sensory neurons.
B are found only in the central nervous system.
C detect changes in the external environment.
D relay signals from the central nervous system to muscles and glands.
Question 6
Vasodilation is one of the body’s responses to
A high temperatures.
B low temperatures.
C pain.
D pressure.
Question 7
Reflex arcs are
A an evolutionary adaptation for survival.
B signals sent through afferent neurons to the central nervous system.
C signals sent from the central nervous system through efferent neurons.
D the signal sent along a neuron.
Question 8
Osmolarity refers to the balance of
A hydration in the body.
B nutrients in the body.
C osmosis.
D water and salt concentrations in the body.
Question 9
Antidiuretic hormone (ADH) is involved in
A egg release from the ovaries of female humans.
B osmoregulation.
C transmission of signals between neurons at the synapse.
D vasodilation for the purpose of thermoregulation.
Question 10
Molecules that cross the synaptic cleft from the axon terminals of one neuron to the dendrites of another are called
A electrons.
B ions.
C neurotransmitters.
D vesicles.
11
The change in electrical potential energy across the cell membrane that is required to trigger an action potential is called
A the absolute refractory period.
B repolarisation.
C resting potential.
D threshold potential.
Question 12
Brown adipose tissue
A covers the body of marine mammals to keep them warm in the water.
B has more mitochondria than other types of adipose tissue.
C is the scientific term for a collection of fat cells.
D is found only in adults.
Question 13
An animal that maintains a constant internal temperature in fluctuating environmental temperatures is known as
Question 1 (7 marks)
The graph shows the membrane potential of the axon of a neuron throughout an action potential.
A an endotherm.
B an ectotherm.
C cold-blooded.
D a eukaryote.
Question 14
The tube that excretes urine to the outside of the body is called the
A bladder.
B nephron.
C ureter.
D urethra.
Question 15
Motor neurons are
A also known as efferent neurons.
a Determine whether a membrane potential of –60 mV is sufficient to trigger an action potential. Justify your response, using information from the graph. (3 marks)
b Identify the time (in milliseconds) when another action potential may occur. (1 mark)
c Explain why the membrane potential is a negative value during resting potential. (3 marks)
B connectors between afferent and efferent neurons.
C found only in the brain.
D the types of nerve cells responsible for detecting movement.
Question 2 (2 marks)
Identify the location of electrical and chemical signals within and between neurons.
Question 3 (3 marks)
Describe the function of the loop of Henle in the kidney.
Question 4 (3 marks)
Explain how ectotherms maintain their body temperature when temperatures drop below their ideal temperature.
The graph shows the relative water level in blood over a 12-hour period.
Explain how shivering is an example of a thermoregulatory process.
Question 13 (4 marks)
Explain the role of ADH in osmoregulation.
TOTAL MARKS /66 marks
a Identify how many hours have passed when the water level in the blood is at its peak and at its lowest. (2 marks)
b Suggest which mechanisms may be occuring to maintain osmoregulation in this organism. Refer to the graph to justify your response. (4 marks)
c Explain why the relative water level in the blood does not remain steady throughout the day. (3 marks)
Question 6 (3 marks)
Describe the stimulus–response model.
Question 7 (4 marks)
Explain how brown adipose tissue is advantageous to animals that live in cold climates.
Question 8 (2 marks)
Contrast torpor and aestivation.
Question 9 (3 marks)
Describe how a negative feedback loop works, and provide one example.
Question 10 (2 marks)
Contrast vasodilation and vasoconstriction.
Question 11 (5 marks)
Explain how the body maintains homeostasis, using one example of a negative feedback loop.

Disease is a physiological abnormality or significant disruption to the health of an individual. It can be caused by a variety of factors, such as genetic predisposition, environmental conditions, poor nutrition and pathogens. Diseases caused by pathogens are termed ‘infectious diseases’ and these can be non-contagious or contagious, depending on the causative agent and its mode of transmission. Pathogens are parasitic organisms. Some infectious diseases are caused by non-living organic particles, such as prions and viruses.
Plants and animals have a number of natural defence mechanisms against pathogens. These are both physical and chemical in nature. In vertebrates, the immune response is composed of: the innate (non-specific) response, which includes barriers to prevent pathogen entry; the inflammatory response; and adaptive (specific) immune responses to specific pathogens that result in the production of antibodies and memory cells. Immunity can be passive or acquired, and acquired either naturally or artificially.
Check your understanding of concepts related to disease before you start. Prior knowledge quiz
→ Distinguish between infectious and non-infectious disease.
→ Identify key features of prions, viruses, bacteria, fungi, protists and parasites.
→ Explain how adherence factors, invasion factors, capsules and toxins affect pathogenesis.
→ Explain how host cells recognise self from non-self.
→ Identify the three lines of defence in vertebrates
– the innate immune response: skin and mucous membranes (non-specific) – inflammatory response and complement system (non-specific) – adaptive immune response (specific).

→ Describe the inflammatory response, including the role of – prostaglandins and vasodilation – neutrophils and macrophages – natural killer cells.
→ Explain the adaptive immune response, including the – humoral response (B lymphocytes, antibodies) – cell-mediated response (T lymphocytes) – role of memory cells.
→ Compare active and passive immunity, both naturally acquired and artificially acquired.
→ Interpret long-term immune response data.
→ Describe the innate immune responses in plants, including – physical defence strategies: barriers and leaf structures – chemical defence strategies: plant defensins and production of toxins.
Biology 2025 v1.0
→ Disease is any physiological abnormality or significant disruption in the “normal” health of an organism.
→ Non-infectious diseases cannot be spread from an affected individual to another individual.
→ Infectious diseases are caused by invasion by a pathogen, and can be spread from one host to another either directly or indirectly
→ Pathogens are biological agents that spread disease.
→ Parasites are cellular organisms that obtain nutrients from a host and rely on a host for survival.
→ An endemic disease is one that exists in a population at regular low levels. An epidemic occurs when a larger than normal number of individuals in a particular locality are infected by a disease at a particular time. If the disease spreads to other countries, it is termed a pandemic.
A healthy individual is one that can function well physically, mentally and socially. What is considered healthy depends on age, vulnerability to disease, sensitivity to pain, physical activity and emotional state. Maintenance of health is aided by the following:
• genes, which control the process of protein synthesis and contain instructions for maintaining normal body functioning
• mitosis, which is regulated by genes and produces identical cells as part of the cell cycle, allowing dead cells to be replaced
• cell differentiation, which follows mitosis and switches certain genes on or off so that a cell can specialise in a certain function
• cell specialisation, which ensures that all the functions of a multicellular organism are carried out efficiently and that all cell types work together to maintain a healthy organism. Factors that disrupt the regular functioning of these processes can lead to a significant disruption of health, also known as disease. Disease can be broadly defined as any physiological abnormality or significant disruption to the ‘normal’ health of an organism. Onset of disease will often result in the dysfunction of a part or parts of the body. Disease can result from non-living (abiotic) environmental factors, such as mineral nutrient deficiency, drought, lack of oxygen, extreme temperatures and pollution. It can also result from living (biotic) factors that may be present within an individual organism or caused by another organism. Diseases can be classified into one of two categories:
Learning intentions and success criteria
disease an abnormal condition of an organism or part of an organism in which the normal functions of the body are disrupted
non-infectious disease disease that cannot be passed from one individual to another
infectious disease disease that can be passed from one individual to another
Disease is the result of disruption of homeostasis – body function is disrupted, leading to illness.
• non-infectious – not caused by infectious agents, and cannot be spread from one individual to another
• infectious – caused by invasion of the body by another organism or biological agent and can be passed, directly or indirectly, from one individual to another.


malfunctioning not functioning correctly
genetic disease
a disease that results from a change in a gene and may be inherited
environmental condition
a factor in the external surroundings (biotic and abiotic) that surrounds and affects the survival and development of an organism or population
inherited condition
a condition that can be passed from parent to offspring
Non-infectious diseases are not caused by infectious agents and so cannot be spread from the affected individual to another. They stem from malfunctioning of cellular processes that disrupt homeostatic mechanisms or the structure and function of body parts. Causes of noninfectious diseases include genetic diseases, environmental conditions and nutrition.
Genetic diseases are inherited conditions that have been passed on to offspring through genes inherited from the DNA of their parents. Examples of genetic diseases are some cancers, autoimmune diseases, cardiovascular disease, diabetes, sickle-cell anaemia and cystic fibrosis. Inheriting the specific genes linked to a disease can increase the likelihood of offspring developing that condition – this is called genetic predisposition. However, being genetically predisposed to a disease or condition does not guarantee that an individual will be affected by that disease.
Environmental conditions are factors in the external surroundings that can affect the survival and development of an organism or population. Examples are heavy metal poisoning, electromagnetic radiation, industrial pollution and drug use. Lead and mercury are heavy metals that are particularly dangerous when consumed. Mercury poisoning usually results from industrial waste washing into the sea, where it is taken up in the food web. People who experience mercury poisoning from regularly eating contaminated seafood may suffer from paralysis, brain damage and widespread neurological effects. Lead poisoning can come from a variety of sources and results in vomiting, cramps, paralysis and brain damage. Other types of industrial pollution can result in carbon dioxide or carbon monoxide poisoning, or mesothelioma caused by inhalation of asbestos dust. Increased exposure to high levels of electromagnetic radiation has been linked to the development of certain forms of cancer.
Cerebral cortex
Hippocampus
Extreme shrinkage of cerebral cortex
Severely enlarged ventricles
Extreme shrinkage of hippocampus
FIGURE 2 Brain sections (A) Normal (B) With mercury poisoning
Drug use can also disrupt the normal functioning of cellular and metabolic processes. Alcohol can potentially lead to death due to liver damage. It has been shown that babies born to women who over-consumed alcohol during pregnancy are at risk of developing a range of conditions including foetal alcohol syndrome, which may contribute to developmental and learning problems. Tobacco consumption is also linked to a higher incidence of lung cancer. Use of other drugs, such as amphetamines and opioids, can affect the regular functioning of the brain.

Nutritional diseases
Nutritional diseases are caused by an inadequate diet. Undernutrition occurs when there is an insufficient amount of one or more essential nutrients in an individual’s diet, or when the amount of food a person consumes is insufficient. For example, scurvy is caused by a lack of vitamin C in a person’s diet. Scurvy can result in weakness, fatigue, increased risk of bleeding and swelling of gums. Table 1 lists some essential nutrients, their functions and deficiency diseases.
nutritional disease a disease resulting from deficiencies or excesses in the diet undernutrition a diet in which the individual is not getting enough calories, protein or micronutrients

malnutrition health problems caused by a poor diet where nutrients are either deficient or excessive
TABLE 1 Human nutrient requirements
Nutrient Function Source Deficiency disease
Carbohydrate Energy source
Protein Formation of cell membrane, antibodies, enzymes, growth, energy source
Fat Energy source, insulation
Vitamin A Pigment production in retina of eye, healthy cells lining respiratory tract
Vitamin B group (up to 12 vitamins)
Involved in many chemical reactions (e.g. respiration)
Vitamin C Keeps tissues in good repair
Vitamin K Blood clotting
Calcium Bone and teeth formation, blood clotting, nerve conduction, muscle contraction
Phosphorus
overnutrition
a form of malnutrition in which one or more nutrients is oversupplied
pathogen a biological agent that causes disease or illness contagious describes an infectious disease that is transmitted between individuals by physical contact with a diseased individual or by casual contact with their secretions or objects touched by them, or by an airborne route non-contagious describes an infectious disease that is not able to be transmitted directly between individuals of the same species; rather, it is spread by exposure to pathogens in the environment, vectors, infected animals or uncontrolled microbe growth
Bone and teeth formation
Iodine Thyroxine production (hormone that controls metabolic rate)
Iron Haemoglobin production
Sodium Osmotic balance, nerve conduction
Potassium Muscle contraction, nerve conduction, osmotic balance
Grains, fruits, vegetables, dairy, legumes Malnutrition
Meat, fish, milk, beans Kwashiorkor; degeneration of liver and pancreas
Butter, oils, nuts
Malnutrition
Egg yolk, fish oil, carrot Night blindness, infections of respiratory lining
Whole grain, cereals, liver Beriberi; muscular weakness and paralysis
Citrus fruits, berries, raw vegetables, potato Scurvy; pain in joints and muscles; bleeding gums
Green vegetables Haemorrhage
Dairy products, bread, beans, almonds, some green vegetables
Milk
Seafood, sea salt or iodised salt
Liver, egg yolks, some green vegetables
Most foods
Most foods
Brittle bones and teeth
Brittle bones and teeth
Goitre (swelling in the neck); slow metabolic rate, congenital hypothyroidism in infants
Anaemia; not enough red blood cells; oxygen shortage
Muscle cramps
Muscle cramps
Overnutrition occurs when an individual consumes too much of one or more type of nutrients. For example, excessive consumption of fats and carbohydrates in the diet can lead to obesity (which is linked to heart disease and diabetes). Other examples are over-consumption of salt, which can cause hypertension (high blood pressure) and overconsumption of sugar, which can increase the risk of developing type 2 diabetes.
Infectious diseases are caused by invasion of body tissue by pathogens (from the Greek “pathos” meaning suffering and “gignomai” meaning cause), which are biological agents that produce disease. Infectious diseases that are contagious involve the direct or indirect spreading of a pathogen from an infected individual to a healthy individual. Infectious diseases may also be non-contagious, when the pathogen is not easily spread from an infected person to an uninfected person; instead, the infection comes from pathogens occurring in nature, from uncontrolled growth of normal body microorganisms, or from the bite of an infected animal or insect.
Most pathogens are cellular, meaning they are living organisms, such as bacteria, fungi, protozoans and different types of worms. You will learn more about living pathogens in Lesson 12.2. Other pathogens are non-living organic agents, such as prions and viruses, which you will learn about in Lesson 12.3. Pathogens are usually host-specific, meaning they will only invade and live in one type of host organism. However, some pathogens are able to cross between species. For example, the Ebola virus can affect a variety of primates, including humans, monkeys, gorillas and chimpanzees.

Parasites are cellular organisms that obtain their nutrients from a host . The host species is another organism that the parasite can take refuge in and acquire nutrients from. In doing this, parasites often cause damage to the host organism. There are two types of parasites:
• ectoparasites, which live on the outside of the host’s body
• endoparasites, which live inside the host’s body.
An example of an ectoparasite is fleas. Fleas have a piercing mouthpart that can penetrate the skin and enter the blood capillaries. They live on the outer surface of their host’s skin, and can bite through the skin to feed on the blood of their host for nutrients. An example of an endoparasite is tapeworms. Tapeworms live inside the alimentary canal of their host’s digestive system, feeding on nutrients in the digestive tract. Regardless of whether a parasite lives inside or outside the host, it is usually an advantage for parasites to keep their host alive. If the host dies, it is highly likely that the parasite will also die, unless it has some means of moving to another host.


Parasites are found among all the kingdoms of life, and have a large array of host organisms. A primary host is the organism in which the parasite remains to maturity, so it can reproduce and spread infection. Some parasites use another organism to move from one host to another. The organism used in this transfer is called a vector. The vector may be a secondary host in the parasite’s life cycle, and thus essential for its survival, or it may act as a means of transport – a reservoir host . It is common for endoparasites to have a secondary host in their life cycle. A carrier is an individual that is infected by a pathogen but does not exhibit disease symptoms and can continue to pass on the disease to other individuals.
parasite an organism that lives in or on another organism and derives nourishment from the host
host an organism that harbours a parasite
ectoparasite a parasite that lives on or in the skin, but not within the body (e.g. a flea)
endoparasite a parasite that lives in the internal organs or tissues of its host
primary host a host in which the parasite reaches maturity and, if possible, reproduces sexually
vector any agent that carries and transmits an infectious pathogen into another living organism
secondary host a temporary host for a parasite
reservoir host an organism that can harbour a pathogen indefinitely with no ill effects
carrier a person or organism infected with an infectious disease agent or gene, but who displays no symptoms of the disease
Many parasites do not cause disease – they are not in themselves pathogens. For example, the mosquito is an ectoparasite but not a pathogen. It is, however, a vector for many other pathogens, such as malaria and Zika virus. Understanding the life cycle of parasites allows strategies to be developed to control their transmission – this is discussed further in Module 13.

7 Mosquitoes are often vectors for pathogens such as the yellow fever virus and Zika virus.
An infectious disease that can pass directly between two individuals of the same species is termed “contagious” (e.g. the influenza virus or “flu” in humans). Non-contagious infectious diseases are not spread directly from person to person. They can be caused by:
• exposure to the pathogen from the environment (e.g. drinking water contaminated with a pathogen)
• an infected animal bite (e.g. rabies)
• contact with a vector (e.g. mosquitoes carrying Zika virus)
• microbes in or on the body that begin to grow uncontrollably (e.g. urinary tract infections that result from the Escherichia coli bacterium spreading from the colon to the urethra).
endemic describes a disease that is constantly present at low levels in organisms of a certain group or living in a particular location
epidemic a disease that occurs at higher rates than would be expected in a community or region during a given period
pandemic an epidemic of infectious disease that has spread across a large region (e.g. multiple continents) or worldwide
8 Summary flowchart for classifying disease
Many diseases exist at low levels in the community at all times. For example, influenza moves through a population at regular low levels. When diseases exists in this manner it is described as endemic. An epidemic of a particular disease occurs when a larger than normal number of individuals in a particular locality are infected by a disease at a particular time. If the disease spreads to other countries, it is termed a pandemic. Table 2 gives some examples of infectious and non-infectious human diseases.
Endemic Disease consistently exists in a population at low levels Epidemic
A large increase in the number of cases of a disease in a population or locality
Pandemic
An epidemic that spreads to di erent countries or regions
FIGURE 9 Endemic, epidemic and pandemic are terms used to classify the prevalence and spread of disease in populations.
TABLE 2 Examples of disease in humans
Type of disease
Infectious
Caused by non-living organic particles Prion Creutzfeldt–Jakob disease (CJD)
Caused by microorganisms
Caused by larger organisms
Non-infectious
Nutritional deficiency diseases
Metabolic disorders
Degenerative diseases
Cancer
Inherited diseases
Occupational or industrial diseases
Virus Measles, rabies
Protozoan Malaria, trypanosomiasis
Fungus Ringworm, athlete’s foot
Bacterium Cholera, tuberculosis
Parasitic worms Ascarisis, schistosomiasis, tapeworm
Beriberi, pellagra, kwashiorkor
Diabetes
Coronary heart disease, arthritis
Skin cancer, breast cancer
Sickle-cell anaemia
Silicosis
Mental disorders Depression, alcoholism
Check your learning 12.1: Complete these questions online or in your workbook.
Retrieval and comprehension
1 Define disease. (1 mark)
2 Describe the causes of non-infectious disease. (6 marks)
3 Using an example, describe a pathogen. (1 mark)
Analytical processes
4 D istinguish between infectious and noninfectious disease, giving examples. (4 marks)
5 A fly may be a vector of a certain parasite but not a host for that parasite. Other organisms may be both a vector and a host to the disease. Compare the terms “secondary host” and “vector”. (3 marks)
6 D istinguish between contagious and noncontagious disease. (x marks)
Knowledge utilisation
7 “All pathogens are parasites, but not all parasites are pathogens.” Discuss this statement, giving examples. (x marks)
Learning intentions and success criteria
virus
a non-living infectious microbe that requires a host cell to replicate
prion
an abnormal form of a normally harmless protein, found in the brain; causes a variety of fatal neurodegenerative diseases of animals, including humans
→ Viruses are non-living particles composed of nucleic acid covered in a protein coat.
→ When a virus invades a cell, it causes the host cell to produce more virus particles.
→ Many human diseases are caused by viruses, with influenza being the most virulent. Many viruses are able to cross hosts from animals to humans.
→ Some diseases result from abnormal prion proteins, which cause normal proteins to become dysfunctional.
Not all infectious diseases of animals are the result of living pathogens. Many diseases are caused by biological agents that are non-living. In this lesson you will learn about two examples of non-living pathogens: viruses and prions.
Viruses are infectious microbes that consist of a nucleic acid (DNA or RNA) encased by a protein coat. They are a tiny 30–300 nanometres in size and are considered non-living because they cannot perform the metabolic activities that are characteristic of living things. Unlike living organisms, viruses do not have their own organelles (e.g. ribosomes), and this prevents them from being able to reproduce alone. Instead, viruses invade the cells of living organisms and use the host cell’s ribosomes to construct new viruses. All viruses require a living host, so they can replicate.
virus
for attachment to bacteria
When a virus invades the cells of another organism, it can instruct the host cells’ nucleic acid to produce more virus particles. It does this by “switching off” the host’s DNA and using its own nucleic acids to instruct the cell to make copies of itself. Eventually, the host cell produces so many copies of virus particles that the cell ruptures, releasing the copies of the virus, which can then infect new cells. When viruses are outside a host cell, they form a crystal that can survive extreme conditions for many years. These inert (inactive) particles can be transmitted to the cells of a host organism through air, water or food, or by direct contact with an infected host. Many viruses are transmitted by disease-carrying organisms, called vectors, which include mosquitoes and ticks. Viruses have been found to parasitise all known living organisms.
Virus attaches to host cell and injects viral genome into cell Death of the host cell
Release
Viral nucleic acid (DNA or RNA) integrates into host genome
Viral nucleic acid (DNA or RNA)
Viral nucleic acid replicates and viral proteins are synthesised
The composition of the protein coat surrounding a virus determines the type of cells that the virus can invade. Before a virus can enter a cell, it must first adhere to it. This means different types of viruses can only infect the cells of specific types of organisms. For example, a virus that infects dogs is unlikely to infect a human. Additionally, different viruses cause specific symptoms and impacts in their host. For example, the Herpes simplex type 1 virus causes cold sores in people, while the Varicella zoster virus causes chickenpox. While viruses are specific, viral nucleic acids can undergo mutations. When this occurs, a virus that could previously only affect one type of organism may mutate in a way that allows it to infect another type of organism. Mutation also can also result in a virus having multiple variants. For example, the influenza virus has four variants.
incubation period the time it takes for a pathogen to increase to sufficient numbers in the body to produce symptoms of the disease



Prior to the development of farming, humans were hunter-gatherers who travelled in small groups over large areas in search of game and other food. If a particular group was infected by a virus, the disease did not spread to other groups, due to their isolation. About 10 00 0 years ago, some groups took up growing crops and domesticating certain animals. People settled in one place and the population of some areas started to increase. Records from fossil bones indicate that these people were more susceptible to disease than their hunting relatives. The close association between humans and their animal stock allowed mutations and transfer of animal viruses to humans. The animals had, over time, developed immunity to these viruses and so did not exhibit diseases. The human population, however, did not have this resistance and the subsequent diseases rapidly killed large numbers of people. The viruses that caused measles, tuberculosis and smallpox were transferred from cattle. Influenza and whooping cough viruses came from domesticated pigs and ducks.


Outbreaks of new viral strains originating from domestic ducks in Asian countries continue to occur. Travel between countries is now common. Because many influenza viruses have an incubation period (the time for viral numbers to increase sufficiently to produce the symptoms of disease) of up to 14 days, an infected person can contract the disease in one country and travel to several other countries before becoming aware that they have the disease. This person could, in their daily contact with others, infect thousands of people, all of whom could take the infection to another part of the world and in turn be in contact with new individuals, many of whom could also become infected. In the first 6 months of the Covid-19 pandemic, an estimated 30 00 0 people became infected with the pneumonia-like SARS-CoV-2 virus in Australia, of whom around 900 died from the infection. Coronavirus disease was first reported in humans in December 2019 in the Wuhan Province of China,
and is believed to have originated from a mutated form of a similar virus found in bats before passing to humans via an intermediate animal host (presumably a pangolin). Worldwide, it is estimated that over 3 mi llion people died from Covid-19 infection by the end of 2020. Records of viral infections in past ages are not accurate and the causes can often only be gauged by the symptoms as described at the time. Prior to the nineteenth century, most viral epidemics were attributed to yellow fever, smallpox and measles. The first pandemic of influenza was recorded in 1847. Since then, probably because of greater (and faster) mobility between countries, many more viral pandemics, resulting in large numbers of deaths, have occurred.
TABLE 1 Major epidemic and pandemic viral outbreaks
Disease
Location
Influenza Worldwide 1887–90 1,000,000
Spanish influenza (H1N1) Worldwide 1918–20 75,000,000
Asian influenza (H2N2) Worldwide 1957–58 2,000,000
Hong Kong influenza (H3N2) Worldwide 1968–69 1,000,000
HIV/AIDS Congo Basin 1960–present > 30,000,000
SARS coronavirus Asia, Canada 2002–03 775
Swine influenza (H4N1) Worldwide 2009 14,289
Measles Congo 2011–present 4,500
Dengue fever
Yellow fever
Middle East Respiratory Syndrome
Zika virus*
Pakistan 2011–present 350
Darfur, Sudan 2012–13 847
Worldwide 2012 449
Ebola West Africa 2013–16 > 11,300
Worldwide 2015–17
Yellow fever Africa 2016 Hundreds
SARS-CoV-2 Coronavirus
Worldwide 2019-present >6,800,000 (as of 2023)
*Although not directly resulting in death, this virus has been linked to microencephaly in babies whose mothers contracted the disease during pregnancy. This has been reported only in South America.
During the flu season, an individual may suffer from influenza more than once. Propose why this may occur.
Prions are a type of non-living pathogen that cause degenerative brain disease. They are proteins that trigger other proteins in the brain to fold in an abnormal way. Transmissible spongiform encephalitis (TSE) is a group of diseases in which the brain of the affected organism gradually develops holes (like a sponge). The cause of this group of diseases in mammals (including humans) was unknown until a London doctor named Tikvah Alper started researching scrapie, a type of TSE in sheep. She found that destroying the nucleic acid (DNA and RNA) in affected tissue was not effective in decreasing the infectiousness of scrapie. However, through further testing she discovered that individual proteins in the tissue were responsible for the disease.
Normal cells in the brain contain a protein called PrPC . Prions (proteinaceous infectious particles – PrPSC ) are proteins that have the same amino acid sequence as PrPC . However, prions are folded to form a different structure. It is thought that prions can rearrange the structure of normal PrPC proteins so that their structure also becomes abnormal. The abnormally structured PrPSC proteins then group together to form plaques (called amyloids) that disrupt normal brain tissue function.
Amino acids in alpha helix shape
Less than 5% of amino acids in beta sheet form
Conversion
More than 50% of amino acids in beta sheet form
FIGURE 4 Normal proteins are infected by abnormal prion pieces (red), which convert the entire protein to the abnormal prion form.
The disruption results in the brain tissue having a spongy appearance (Figure 5) in an individual with Creutzfeldt–Jakob disease (CJD). Many of the diseases associated with prions have a name that reflects the effect of that disease on the brain. For example, symptoms of bovine spongiform encephalopathy (mad cow disease, BSE) include convulsions, poor balance and coordination, and behaviour changes. All known prion diseases are untreatable and fatal.
Normal protein is similar in mammals, and a large variety of mammals are susceptible to prion diseases (Table 2). There are, however, slight differences between the proteins in different species. This reduces the likelihood that a disease will spread from one species to another. However, an exception to this was seen in the BSE or “mad cow disease” epidemic in the United Kingdom and parts of Europe between 1986 and 2000.
During the 1980s, the method of cattle feed production was altered, with cow feed being produced that contained animal remains (meat and bone meal). It is thought that this change to cattle feed introduced a scrapie disease agent from an infected cow or sheep and allowed it to survive and contaminate

cattle, causing a wave of BSE in cattle. At the time neither scrapie nor BSE were thought to be a risk to humans. However, after brain tissue from BSE-infected cattle made its way into the human food supply, particularly as sausages and hamburger meat during the height of BSE infections, over 200 young people died from a variant of Creutzfeldt–Jakob disease (vCJD), a rare form of TSE.



FIGURE 6 It is thought that (A) scrapie, which affects sheep, contributed to the occurrence of (B) BSE in cattle, which contributed to the occurrence of (C) vCJD in humans.
The new variant of CJD was found to contain the same prion strain found in BSE and was found in lymphatic tissue and brain tissue in affected people. It was proposed that the ingested abnormal prions from BSE were taken up by lymphoid tissues of the digestive tract and passed to the central nervous system via the autonomic nervous system . Once in the brain, the process of converting normal protein to abnormal prion protein was accelerated. People who contract vCJD show increasing signs of memory loss, have difficulty controlling movement and often lapse into a coma.
Until 2015, it was thought that all known mammalian prion diseases were caused by abnormal strains of the same membrane protein (PrPC ). It was then discovered that multiple system atrophy (MSA) was likely to be caused by an abnormal folding of a different membrane protein (alpha-synuclein). MSA results from deterioration of the parts of the brain that regulate internal body functions, digestion and motor control. Many other neurological diseases may be shown to be the result of prions. These are summarised in Table 2.
TABLE 2 Diseases in mammals caused by prions
Animal affected Disease
Sheep, goat
Cattle
Mink
Scrapie
Bovine spongiform encephalopathy (BSE, mad cow disease)
Transmissible mink encephalopathy (TME)
White-tailed deer, elk, mule deer, moose Chronic wasting disease (CWD)
Cat
Nyala, oryx, greater kudu
Human
Feline spongiform encephalopathy (FSE)
Exotic ungulate encephalopathy (EUE)
Creutzfeldt–Jakob Disease (CJD)
Variant Creutzfeldt–Jakob Disease (vCJD)
Familial Creutzfeldt–Jakob Disease (fCJD)
Iatrogenic Creutzfeldt–Jakob Disease (iCJD)
Sporadic Creutzfeldt–Jakob Disease (sCJD)
Gertsmann–Straussler–Scheinker Syndrome (GSS)
Fatal familial insomnia (FFI)
Familial spongiform encephalopathy
autonomic nervous system the system that controls the actions of the inner (visceral) body tube; not under conscious control. Two types of motor nerves are involved: sympathetic (secrete noradrenalin) and parasympathetic (secrete ACh), which are mainly antagonistic in their action
Check your learning 12.2: Complete these questions online or in your workbook.
Retrieval and comprehension
1 Describe the structure of a virus. (x marks)
2 E xplain why viruses and prions are considered non-living. (x marks)
5 Identify the features of prions and how they are transmitted. (x marks) Check your learning 12.2
3 Describe the life cycle of viruses. (x marks)
4 E xplain why a viral infection can rapidly become a pandemic. (x marks)
→ Pathogens may be microbes (bacteria, protists or fungi) or macroorganisms (e.g. flukes, tapeworms or roundworms).
→ Many microbes and macroorganisms are pathogens of humans, their domesticated animals and cultivated plants. Some pathogens are transmitted via the air, in contaminated food or water, or by a vector.
→ Protists are animal-like, unicellular eukaryotes, and some cause fatal diseases such as malaria and African sleeping sickness.
→ Most macroscopic endoparasites of humans are flatworms (e.g. tapeworms) or roundworms (hookworm, Ascaris). Untreated, diseases from these worms can be fatal.
Learning intentions and success criteria
bacteria microscopic unicellular organisms that lack a distinct nucleus
Many pathogens are living, reproducing organisms. There are many types of living pathogens. In this lesson you will learn how organisms such as bacteria, protists, fungi and some parasites can cause disease.
Bacteria are some of the smallest living organisms (between 0.5 µm a nd 10 µm i n diameter). Although some bacteria exist as groups of cells or in long strands, bacterial cells do not specialise for a particular function. Instead, the cells are only loosely held together. They are so small that their internal structure can only be viewed using high-powered electron microscopes. Despite their small size and simple structure, bacteria have continually thrived in all environments throughout the existence of life on Earth. It is estimated that:
• a single handful of soil contains more bacteria than the total number of people who have ever lived
• the skin of an average person has 105 bacterial cells per square centimetre
• the human gut contains 1011 bacterial cells per gram of contents (the large intestine normally holds 1 kg of material).

Bacteria are prokaryotic cells that have no true nucleus or membrane-bound organelles. They have a single, circular strand of DNA and several small segments of DNA, called plasmids Metabolic activities occur in the cytoplasm. The entire cell is enclosed by a wall composed of the glycoprotein murein. Different types of bacteria have different forms of cellular respiration (aerobic, anaerobic or both) and methods of gaining nutrition (chemosynthetic, photosynthetic or heterotrophic). This allows bacteria to live in diverse environments. Most bacteria are harmless, and many are essential for the continued existence of life on Earth. Bacteria can be identified by growing them on a culture medium such as agar jelly or in a nutrient broth, under controlled environmental conditions. Individual bacteria can grow and divide rapidly, producing colonies of millions of bacteria. The colonies of many bacteria have a characteristic colour and shape, which assists in their identification. This process can be used to distinguish between the different groups of bacteria.

plasmid a small, circular molecule of DNA that differs from a cell’s chromosomal DNA murein a glycoprotein forming the cell wall in bacteria
TABLE 1 Basic shapes of bacteria
Bacterial shape Image Examples
Cocci – spherical (singular: coccus)
Bacilli – rod-shaped (singular: bacillus)
Spirilla – spiralshaped (singular: spirillum)
Vibrio – commashaped
Rickettsiae – rodshaped
Enteric bacteria live within the guts of animals, including humans. Many are not pathogenic and are, in fact, important for gut health. The uniform temperature and constant supply of nutrients allows bacteria to grow in their millions.
Diplococcus join together in pairs.
• D. pneumoniae causes pneumonia.
• Streptococcus join to form a chain – many Streptococcus species infect the upper respiratory tract.
• S. pyogenes – scarlet fever
• S. thermophilus – gives yoghurt its creamy texture.
• Staphylococcus join together in bunches.
• S. aureus (golden staph) – different strains cause boils, pneumonia, food poisoning and other infections.
Bacillus typhosus causes typhoid fever.
Bacillus anthracis causes anthrax.
Escherichia coli lives in symbiosis in the gut.
The spirochete (a fine spirillum) Treponema pallidum causes syphilis.
Vibrio cholerae causes cholera.
Rickettsia cause typhus and are often carried on the body louse (a vector).
(Note: They are similar in size to the smallest bacilli and cocci, but they are classified into a different group because they cannot survive outside living cells; they are actually the smallest known cell.)
Bacteria can reproduce, on average, every 20 mi nutes. This means that, if a single bacterium is placed in an incubator with a large supply of nutrients, after 20 mi nutes there will be two bacteria, and after another 20 mi nutes there will be four, then eight and so on.
To calculate the number of bacteria in a population: number of bacteria at the start of the growth period × 2number of divisions
PRACTISE YOUR skills

1 From a single bacterium, calculate the number of bacteria present after 24 hours. (2 marks)
2 From 10 bacteria, calculate the number of bacteria present after 8 hours. (2 marks)
Some strains of bacteria are harmful to humans, domesticated animals or cultivated plants. These pathogenic strains of bacteria can spread in many ways (e.g. direct contact with contaminated surfaces, eating contaminated food, transmittal by infected animal or insects). Once inside the body, they may cause disease by producing poisonous chemicals (toxins), by disrupting the host’s metabolism, or by damaging tissues. For example, some Clostridium species can cause food poisoning by releasing a toxin into foods such as meat. When food containing the toxin is eaten, the toxin can affect the nervous system, causing problems with vision, paralysis or even death.

Like viruses, many bacteria will only affect specific parts of the body. For example, the bacterium that causes bacterial dysentery produces a powerful toxin that affects the cells of the large intestine. This results in loss of blood with the faeces as well as diarrhoea. Other bacteria can affect more than one type of tissue. The bacterium Treponema pallidum , which causes syphilis, initially causes inflammation of the penis or vulva but can travel to, and affect, all parts of the body, including the brain.

The system for naming species consists of two parts: the genus name and the species name. An example is Treponema pallidum. Treponema is the genus name, and pallidum is the species name.
The bubonic plague pandemic of 1347–1352, known as the Black Death, was one of the most deadly in history, resulting in the deaths of approximately half the population of Europe at the time. This disease is caused by the bacillus bacterium Yersinia pestis, found in Oriental rat fleas (Xenopsylla cheopis), which feed on humans and rats. The disease passes between organisms through flea bites. Plague can affect people in three ways.
• Bubonic plague (the most common form) occurs when the bacteria infect the lymphatic system. This causes painful swelling of the lymph glands, which begin to bleed and so become purple-black and rupture into foul-smelling lesions. Eventually the victim’s nervous system collapses, and death follows. Modern antibiotics are effective against bubonic plague if it is treated early.
• Pneumonic plague occurs when the bacteria infect the lungs. It is the most serious form of plague. It does not respond readily to antibiotics.
• Septicaemic plague occurs when the bacteria multiply in the blood. This can occur from a

direct flea bite or from untreated bubonic or pneumonic infection.
Plague epidemics and pandemics have occurred for thousands of years. The first recorded case was in China in 224 BC E. Since then, there have been many serious outbreaks. Five million people in Europe, Western Asia and Africa died between 165 and 180 CE and up to 50 mi llion died in Europe between 541 and 542 CE . The Black Death was the most significant outbreak – between 1347 and 1352 CE , 75 to 100 mi llion people died in Europe. Although the disease receded, it never completely went away and is still prevalent in 20 countries. Recently, severe outbreaks have occurred in Central Africa and parts of South America. An epidemic is more likely to occur in highly populated, urban areas with poor sanitation. As with other microorganisms with a high reproductive rate, Yersina pestis has many mutant forms and some of its genes have been acquired from other bacteria and viruses. There has been rapid evolution of the bacterium, allowing it to survive in many different environments.

Apply your understanding
1 Identify the pathogen and the vector of the bubonic plague.
2 Describe the features of the bubonic plague pathogen and how these features influenced the epidemic potential of the disease.
Protists are organisms that belong to the kingdom Protista. The Protista are a diverse group of eukaryotes, and most are unicellular. They are not fungi, plants or animals. Protists are divided into the animal-like protozoa, the plant-like algae and the fungus-like slime moulds.
Protozoa are heterotrophic protists that are divided into four main phyla. Three of these phyla are distinguished by how they move.
• Rhizopoda move by pseudopodia . A pseudopodium is a footlike extension of the cell membrane.
• Oomastigina move by a flagellum , a long hair-like appendage that helps propel a cell forward.
• Ciliophora move by cilia , small eyelash-like structures that move back and forth. The fourth phylum of protozoa, the Apicomplexa, are all parasites of animals and have complex life cycles involving both sexual and asexual phases. All protozoa live in moist environments.
protist a eukaryotic organism that is not an animal, land plant or fungus pseudopodium a temporary foot-like extension of the cell membrane of some protozoans, resulting in a flowing movement of the protozoan; plural pseudopodia
TABLE 2 Animal-like protists and their features
Type of protist
Protozoa
Features
Aquatic or endoparasites
Unicellular
Heterotrophic eukaryote
Phylum Rhizopoda Move by pseudopodia
Irregular shape
Engulf food by phagocytosis anywhere on the membrane
Mostly free-living
Phylum Zoomastigina Move using one or more flagella
Definite shape
Food intake at base of flagellum only
Free-living or parasitic
Phylum Ciliophora Move by cilia
Definite shape
Food intake in one place only, the ‘gullet’
All free-living
Phylum Apicomplexa (sporozoans)
No locomotion
Definite shape
All parasites
Have complex life cycles
flagellum a whip-like extension, containing protein filaments, of the cell membrane of some protozoans; plural flagella cilium a hair-like extension of the cell membrane; plural cilia
amoeba a microscopic unicellular protozoan that belongs to the rhizopodan order; plural amoebae
Amoebae are single-celled organisms and a type of rhizopod. An example of an amoeba that is a human pathogen is Balamuthia mandrillaris, which lives in soil and fresh water. It can enter the body through open wounds or through inhalation of dust containing the amoeba. Once the amoeba is inside the body, infection will usually spread from the lungs or the nerve fibres, and the amoeba will attack the central nervous system for nutrients. This attack causes lesions in the brain and eventually necrosis (death of tissue), leading to death. Balamuthia infection is rare, with only 200 cases reported since its discovery in the 1990s.

FIGURE 8 Balamuthia mandrillaris is an amoeba that causes a deadly infection.
Malaria is caused by a protozoan that hides inside human cells to avoid the immune system. Humans are the secondary host, while mosquitos are the primary host for the parasite, Plasmodium (phylum Apicomplexa). The parasite undergoes sexual reproduction in the digestive tract of the Anopheles mosquito, and asexual reproduction in both the human liver and blood cells. Malaria is endemic in many Mediterranean and tropical regions of the world.
There are 200 to 400 million cases of malaria annually, with more than 80% occurring in Africa. Every year, hundreds of thousands of people die of the disease, and survivors usually suffer from a wide range of other infections due to their weakened resistance.
Examples of common protist diseases in humans are given in Table 3.
TABLE 3 Some common protozoan diseases of humans
African sleeping sickness Headache, fever, enlargement of lymph nodes, drowsiness leading to coma
Giardiasis Diarrhoea, bloating, flatulence, vomiting
Vaginitis Inflammation and irritation of the vagina in women and urethra in men
Amoebic dysentry Fever, nausea, vomiting, diarrhoea
Malaria Anaemia, fever alternating with shivering
The tsetse fly takes up Trypanosoma from the blood of an infected person. The parasite multiplies in the fly’s salivary glands. It is injected into another person when the fly feeds on human blood.
Food or water contaminated with Giardia lamblia
Usually sexual intercourse, although the disease-causing flagellate, Trichomonas vaginalis, can survive for several days in moisture in towels or in droplets on toilet seats.
Food or water contaminated with Entamoeba histolytica
The Anopheles mosquito is the primary host of Plasmodium
Fungi are eukaryotic heterotrophs that have cell walls made from a substance called chitin and reproduce with spores. All fungi, except unicellular forms (yeasts), are composed of filaments called hyphae, which penetrate their organic substrate. Fungi may be decomposers or parasites, or found in association with a plant (lichen). Fungi are classified by how their spores are formed.


fungus (plural fungi) a eukaryotic organism that belongs to the kingdom Fungi

Pathogenic fungi use hyphae to enter host cells. The fungus feeds by extracellular digestion –it secretes enzymes into the substrate, and the small molecules released are absorbed by the hyphae. Only a few types of fungi are pathogenic to humans. The most common fungal infections are:
• ringworm – usually a single fungal spore from Trichophyton or Epidermophyton germinates on the skin and the hyphae spread out, digesting and absorbing the nutrients from skin cells. This causes inflammation of the skin, which may become very itchy or sore and appears as an increasing circle of red tissue, as the fungus spreads. As fruiting bodies are formed, spores may be transferred directly to another person or via towels or clothing
• athlete’s foot (tinea) – Tinea pedis primarily grows on the skin between the toes, although it may spread to other parts of the foot. It is common in people who wear shoes and socks that do not allow perspiration from the feet to evaporate. Thus, athletes who spend hours training are particularly susceptible to infection. Because athletes share change rooms and showers, the fungus can spread rapidly from person to person
• thrush (Candida albicans) – a yeast that infects the mouth, throat, intestines and vagina, where it grows as a white patch on the moist tissues. In the vagina, the symptoms are intense itchiness and an unpleasant discharge. Vaginal thrush can be transferred from mother to baby during birth.
Candida can be kept in check by bacteria that normally inhabit these regions, so a person may not be aware that they are harbouring the fungus. If these bacteria are killed by antibiotics, or if the person’s resistance is lowered due to other illness or malnutrition, over 60 different disease conditions can occur. The membranes of the epithelial cells lining the intestine can become more permeable, allowing the entrance of larger, partially digested proteins into the bloodstream. An immune reaction to these proteins can result in food allergies. Candida can change from the single-celled shape and produce a mass of hyphae that penetrate the intestinal wall and move throughout the body via the bloodstream. Rapidly growing colonies of this fungus produce toxins. Forms of arthritis, depression, mood swings and severe allergic responses have been attributed to candidiasis infection.

roundworm
a nematode worm that infests the intestines of humans or other mammals
fluke a parasitic flatworm in the class Trematoda
tapeworm
a ribbon-like parasitic worm in the class Cestoda

Most macroscopic endoparasites of humans are either flatworms (phylum Platyhelminthes) or roundworms (phylum Nematoda).
Flatworms are dorsoventrally (top to bottom) flattened animals that include both free-living and parasitic forms. The main human parasites are flukes and tapeworms. Both have a very complex life cycle involving a vertebrate and an invertebrate host. Flukes have a leaf-like body and two suckers and are generally quite small. Tapeworms have an elongated body, some reaching up to 10 met res in length, and a highly modified head that attaches to the host’s gut wall by suckers and a series of hooks.


The life cycles of many flukes, such as Schistosoma (human blood fluke) and Fasciola , are similar. Although Fasciola is most common in sheep, it can also occur in humans. In both primary hosts the adult fluke, a hermaphrodite, lives in the liver and bile ducts. The eggs are released with the bile into the intestines and pass out with the faeces. If the eggs land on moist grass and are eaten by the appropriate type of water snail, the cycle continues. The eggs hatch and the larvae feed on the snail tissues before undergoing asexual reproduction. Again, the larval form of the parasite leaves the snail’s body. This larva, however, swims to a stalk of grass, climbs above water level and forms a protective cyst. When sheep graze, or humans eat watercress, they may ingest the cysts. Inside the intestine, the cyst coating breaks down to release the larva, which burrows through the intestinal wall into the blood vessels.
In farming communities in Australia, it was common to feed offal from slaughtered sheep to the farm dogs. Since this practice has been outlawed, the incidence of the sheep liver fluke has decreased.
Egg Miracidium
Adult fluke in liver of sheep
Mouth
Oral sucker
Pharynx


Ventral sucker Branched intestine
Faeces carry eggs out
Miracidium bores into snail
Sheep eat cercaria with grass
Operculum opens In water snail Redia
Cercaria form cysts on grass
Redia develop inside; are released when sporocyst splits open Sporocyst
Cercaria released and leave snail

Adult Taenia tapeworms are the largest endoparasites of humans, growing to several metres in length in the small intestine. Although their waste products can be absorbed into the human bloodstream, causing illness, their main effects are host malnutrition and obstruction of the bowel.
Most of the organs of the tapeworm have degenerated; the body consists of a series of sections (proglottids) effectively filled with reproductive organs. The proglottids are formed from the head end (scolex) continuously throughout the life of the tapeworm. These new proglottids are pushed back as still more are formed. The scolex is an attachment organ, firmly fixed to the intestinal wall with suckers and, in some species, hooks. A thick, mucuscovered cuticle covers the entire body, preventing digestion by the host’s enzymes while still absorbing the digested food in which it is bathed.

Infectious diseases caused by macroparasites are more prevalent in countries with small economies. Using an example of a macroparasite, propose (with justification) why this is the case.
Roundworms (phylum Nematoda) occur in enormous numbers in a great variety of habitats. Most are free-living in moist soil and decomposing organic matter on the bottom of lakes and oceans; others are parasites of plants and animals. Humans are hosts to about 50 species of roundworms. Few people have escaped contracting pinworms during their childhood. Due to its low severity this infection is more an annoyance than a disease. More serious diseases caused by roundworms occur in tropical and subtropical regions. They include elephantiasis (mosquito vector), onchocercariasis (water-breeding fly vector), ascariasis and hookworm, which are spread directly from person to person through faecal contamination of food or water.
Independent and dependent variables
Science inquiry skill: Understanding the scientific method
Francesco Redi experimented with decaying meat and the presence of maggots. He noted that if flies could not get to the meat, maggots didn’t appear. This debunked the theory of spontaneous generation.
Louis Pasteur demonstrated how heating wine to between 50°C and 60°C killed bacteria and prevented lactic acid forming.
Robert Koch found a way to test whether a particular microorganism was responsible for a specific disease. He extracted Bacillus anthracis from a sheep suffering from anthrax, cultured it and injected it into mice, which then developed anthrax.
Practise your skills
1 Determine the dependent and independent variables of each experiment. Copy and complete the table to provide your answer.
TABLE 1 Redi, Pasteur and Koch’s experimental variables
Experimenter Independent variable Dependent variable
Francesco Redi
Louis Pasteur
Robert Koch
Check your learning 12.3: Complete these questions online or in your workbook.
1 Describe how bacteria may cause disease in their host, using an example to support your response. (x marks)
2 Describe how bacterial diseases are transmitted. (x marks)
3 Identify two macroparasites that are transmitted via contaminated water, and describe the symptoms in the infected person. (x marks)
4 E xplain whether thrush is caused by an ectoparasite or an endoparasite. (x marks)
5 One group of protozoans, Phylum Apicomplexa, is only found as parasites of animals. Determine which feature of these organisms is compatible with this mode of living. (x marks)
Lesson 12.4
→ Pathogenesis is the series of steps by which a pathogen causes disease in a host.
→ The virulence of a pathogen refers to its ability to cause disease.
→ Virulence factors are molecules that can contribute to the survival of a pathogen, and therefore its pathogenesis. They include adherence factors, invasion factors, capsules and toxins.
Pathogenesis is the process or mechanisms by which pathogens cause disease, from initial contact with the host, to the development and progression of the disease. The virulence of a pathogen is its ability to cause disease. It is a measure of the severity of the disease that a particular pathogen can induce in the host, and includes how many individuals the microorganism infects, how quickly it spreads through the body and how many hosts die due to the infection. For example, influenza is more virulent than the common cold virus, because more people become sicker or die as a result of the “flu”.
For an organism to cause disease, it must:
• enter the host
• multiply in the host’s tissues
• resist, or not stimulate, the host’s defence mechanisms, and
• damage the host.
Learning intentions and success criteria
pathogenesis the series of steps by which a pathogen causes disease in a host: adhesion, colonisation, invasion, evasion of host defences, and damage to host tissues virulence the ability of a pathogen to cause disease or damage to its host
virulence factor
a molecule that can contribute to the survival of a pathogen
Virulence factors are molecules that can contribute to the survival of the pathogen, and therefore its pathogenesis. They are typically proteins and include adherence factors, invasion factors, capsules and toxins.
adherence factors specialised molecular components on the surface of a pathogen that increase its ability to attach to the surface of other cells or structures
adhesin a protein on the surface of bacteria that helps them adhere to other cells or to inanimate surfaces
Before a pathogen can cause disease, it must first enter the host. For this to occur, the pathogen must adhere (stick) to a molecule on the membrane of the host cell. This provides a starting point for the microorganism to penetrate tissues and colonise the host. Adherence factors are specialised structures on the surface of a pathogen cell that allow it to bind and maintain attachment to a host cell. An example of an adherence factor is when a pathogen produces small surface glycoprotein molecules, called adhesins, which attach to specific receptors on the host cell’s membrane. Another example of an adherence factor can be in seen some bacteria, such as Streptococcus species, which have fine structures called fibrillae that can bind to human epithelial cells. Some bacteria, such as Escherichia coli , have specific adhesive organelles, called pili, that allow them to bind to almost all human cells.
invasion factor
a protein that allows a pathogen to invade a host cell


Invasion factors are proteins that allow pathogens to enter cells. Many microorganisms must insert themselves into their host’s cells. To achieve this, many produce proteins that help to disrupt the host cell membranes or stimulate endocytosis into the host cells. For example, Yersinia is a genus of bacteria that requires entry into epithelial cells in the gut. To do this, Yersinia produces a protein called invasin, which allows the bacteria to bind to and invade epithelial cells. Another example of an invasion factor is the spike (S) protein in the SARS-COV-2 strain of coronavirus. These spike proteins bind to a host cell receptor called ACE2. After the spike protein binds to the ACE2 receptor, the virus can inject its RNA into the host cell.
Host cell
Membrane fusion and viral RNA release Virus enters host cell through endocytosis
receptor
FIGURE 2 The spike protein produced by SARS-COV-2 is an invasion factor that facilitates viral entry into a host cell.
Many bacteria have a capsule, a specialised structure composed of polysaccharides that coats the outside of the cell wall. Capsules protect bacterial cells by shielding the bacteria from toxins and from desiccation (drying out). Additionally, capsules can assist with adhesion to host cells and help the pathogen evade the host’s immune system by cloaking molecules that may have otherwise triggered an immune response, such as phagocytosis by white blood cells.
Capsule
Cell wall
Plasma membrane
Ribosome
Nucleoid
FIGURE 3 A bacterial capsule encases the cell walls of the bacterium and protects the cell.
Toxins are proteins that poison host cells and cause tissue damage. Many bacteria and fungi produce toxins so they can damage host tissue to acquire nutrients needed for the pathogen’s survival. There are two main types of toxins: endotoxins and exotoxins.
Endotoxins are lipopolysaccharides bound to the outer membrane of the pathogen. When the pathogen is damaged or destroyed by the host, the endotoxin is released and causes an inflammatory response in the host.
capsule a polysaccharide layer that encases the outside of a bacterial cell’s envelope
toxin a protein that is produced by pathogens and poisons host cells
endotoxin a pathogen’s toxin that is bound to its outer membrane and is not freely liberated into the surrounding medium
FIGURE 4 Endotoxins are bound to the outer membrane of a pathogen. Exotoxins are produced inside the pathogen and released into the external environment.
exotoxin a protein produced and released by a pathogen

Exotoxins are proteins produced and released by the pathogen. Different toxins are secreted by different species. They are named descriptively to show where the toxin acts (e.g. neurotoxins affect the nervous system, haemolysin causes red blood cells to rupture). The two most potent known exotoxins are the tetanus toxin secreted by the bacterium Clostridium tetani , and the botulinum toxin produced by Clostridium botulinum.
Exotoxins act in different ways. They can:
• damage cell membranes by altering the movement of ions into or out of the cell or by inhibiting protein production and so causing cell death
• interfere with cell signalling, by disrupting the cell cytoskeleton (and thus the membrane), disrupting the proteins involved in transduction, or blocking or altering the signalling pathways
• affect the immune response by provoking the release of enormous amounts of inflammatory chemicals, which can result in toxic shock syndrome.
Check your learning 12.4: Complete these questions online or in your workbook.
Retrieval and comprehension
1 Describe how adherence factors increase the virulence of pathogens. (x marks)
2 Describe the structure and function of bacterial capsules. (x marks)
3 Describe the function of toxins and how they aid the survival of pathogens. (4 marks)
4 Explain how virulence factors affect the pathogenesis of a disease. (6 marks)
Knowledge utilisation
5 A highly virulent pathogen will often not infect as many people as a mildly virulent pathogen. Propose reasons for this. (x marks)
→ There are three lines of immune defence: the innate immune response, the inflammatory response and complement system, and the adaptive immune response.
→ The innate immune response is a system of non-specific defence mechanisms including physical barriers such as skin, chemicals in the blood, and white blood cells that attack foreign cells in the body.
→ The inflammatory response is the body’s response to an injurious agent. It is characterised by swelling, pain and/or heat.
→ The complement system is a system of proteins (formed in the liver) which, when activated by the presence of an antigen, produce chemicals that bring about inactivation of foreign matter.
→ The adaptive immune response is a specific immune response that is “learned” when a person’s immune system encounters foreign “invaders” and recognises non-self substances (antigens) – the response generates special chemicals (antibodies) to neutralise a specific pathogen.
Pathogens can enter the body through natural openings or via wounds and breaks in the skin. Each of the natural openings leads to a tube lined with soft, moist membranes that are breeding havens for many pathogens. These openings include:
• the eyes, where pathogens can enter through contact and dust (e.g. conjunctivitis)
• the nose, where airborne organisms can enter through inhalation (e.g. tuberculosis, the common cold, influenza, measles)
• the mouth, where pathogens can enter through contaminated food, drink, utensils (e.g. cholera, bacillary dysentery, tapeworm, salmonella food poisoning)
• the urinary, reproductive and anal passages, where pathogens can enter by contact (e.g. gonorrhoea, HIV, syphilis, candidiasis).
Unbroken human skin has a remarkable protective ability against microorganisms. The larvae of Schistosoma , hookworm, and the fungi that produce tinea and ringworm, are among the few pathogens that can enter unbroken human skin. Pathogens may also enter a host through vectors that penetrate the skin (e.g. mosquitoes) or through contaminated needles used for injection (which can spread HIV and hepatitis). Many pathogens, such as the bacteria that cause tetanus and septicaemia, enter the body through scratches and abrasions. For a pathogen to cause disease, it must first enter the appropriate host cell and then, in most cases, multiply. To do this, it must overcome host defences that have evolved to prevent this. The body’s different defences to protect against pathogens and disease is known as the immune system. The immune system has three lines of defence, and each plays a specific role in defending the body:
1 the innate immune response
2 the inflammatory response and the complement system
3 the adaptive immune response
Learning intentions and success criteria
immune system an organism’s host defence system, comprising many biological structures and processes that protect against disease innate immune response a system of non-specific defence mechanisms including physical barriers (e.g. skin), chemicals in the blood, and white blood cells that attack foreign cells in the body inflammatory response a response of the body to an injurious agent, characterised by swelling, pain and/or heat
non-specific immunity
immunity that an organism is born with and protects against all pathogens rather than specific pathogens
The first line of defence against pathogen invasion is the innate immune response. This response is present in all animals and is sometimes referred to as “natural immunity”. It is always active and does not require any special preparation to prevent infection. It includes both physical barriers, such as the skin, and chemical barriers, such as mucus secreted by mucous membranes, to prevent pathogens causing disease. The innate immune response is considered a form of non-specific immunity as it does not target any one specific type of pathogen but instead protects against a broad range of potential pathogens.
The skin is the first point of defence and the body’s main barrier against pathogen infection. It protects the internal organs against external elements and pathogens. The outer layer of the skin, the epidermis, is made up of closely packed cells. This structure forms a tough physical barrier that, when intact, is difficult for pathogens to penetrate. The outermost layer of skin cells is dry and sheds regularly, which helps remove pathogens attached to the surface of the skin.
mucous membranes
membranes that line various cavities in an organism’s body and cover the surface of internal organs
mucus
an aqueous fluid that is secreted by and covers mucous membranes
antibody a gamma globulin protein in the blood or lymph; produced by B-lymphocytes as an immune defence against foreign agents (antigens)

The skin also contains sebaceous (oil) and sweat glands. Sebaceous glands secrete sebum, an oily substance, onto the surface of the skin, which makes the skin’s surface more acidic.
Beneficial bacteria can live on the oil secreted by sebaceous glands, while the acidity of sebum helps prevent the growth of pathogenic bacteria and fungi on the skin. Sweat secreted by sweat glands also contains antibacterial and antifungal substances. The skin also hosts several beneficial and harmless bacterial species, which compete with pathogenic species for space and resources.
Mucous membranes are the moist inner linings of some of the body’s organs and cavities. Examples of cavities and organs with mucous membranes are the nostrils, mouth, lungs and stomach. Different mucous membranes secrete different substances that help fight pathogen infection. For example, the nostrils secrete mucus, a sticky fluid that can catch pathogens and stop them from reaching cells and tissues. Mucus also contains enzymes that can break down bacteria, and antibodies that can stop pathogen action. The mouth secretes saliva, which contains antimicrobial agents that can kill some harmful species of bacteria. Like the skin, mucous membranes are colonised by beneficial bacteria, which compete with pathogenic species for resources.


Study tip
If a pathogen makes it through the first line of defence, the second line of defence is triggered. The body’s second line of defence consists of the inflammatory response and the complement system. Both these defence mechanisms are non-specific: they react in the same way for any pathogen.
The inflammatory response is the immune system’s response to harmful pathogens, damaged cells, toxins and radiation. The inflammatory response includes the detection of harmful foreign stimuli (e.g. pathogens) and the initiation of healing processes that help to remove harmful stimuli and repair damage.
All cells in an organism have special protein molecules, called the major histocompatibility complex (MHC), on their outer membrane. MHC acts as a self-marker or identity tag. There are two types of MHC proteins:
• MHC I – found on all cells in the body
• MHC II – found only on certain cells, such as macrophages and B-lymphocytes and used to recognise foreign cells.
The immune system can therefore recognise which cells are “self” by detecting body cells that have the same MHC I on their surface. Cells that do not contain the specific MHC I for the individual are not recognised and are therefore attacked by the immune system. Pathogens such as viruses, parasites, fungi and bacteria do not contain the specific host identification marker. Any non-self-marker is known as an antigen (Ag) to the host organism and will trigger the immune response.
The word ‘skin’ should not be used on its own to mean a physical barrier, as the skin may have small wounds or breaks. It must be described as ‘intact skin’ to indicate that it is an effective barrier to pathogens.
MHC marker Antigen
Immune cells recognise cells with the correct MHC marker as “self”.
Recognition of an antigen triggers an immune response.
FIGURE 3 MHC markers are used to identify “self” cells, while antigens trigger an immune response.
macrophage
a type of white blood cell that engulfs and kills microorganisms, removes dead cells and triggers the action of other immune cells
B-lymphocyte
a white blood cell that does not pass through the thymus as it matures; involved in antibody formation
antigen a protein on the surface of matter that is foreign to the body
prostaglandin a chemical released from damaged cells that directs blood flow to an injured area
The inflammatory response involves a variety of cellular components and processes that work to attack pathogens and initiate healing. It includes:
• prostaglandins and vasodilation
• neutrophils and macrophages
• natural killer cells.
Prostaglandins and vasodilation
Prostaglandins are a group of chemicals released by a variety of cells when an area of the body is infected or damaged by pathogens. One of the primary roles of prostaglandins is to initiate the widening of blood vessels, known as vasodilation (Lesson X.X). Vasodilation allows blood flow to be directed to the site of injury or infection. The increased amount of blood in the injured area causes the area to become red, swollen and warm –common signs of inflammation. Vasodilation also assists in bringing increased numbers of phagocytes into the area to help destroy pathogens at the site of injury or infection.

neutrophil a phagocytic, granulocytic white blood cell
Prostaglandins also increase the permeability of blood vessels, which helps transport other immune cells and proteins from blood to tissue, to help fight infection. Finally, prostaglandins can also work to induce fever, raising the body’s temperature to fight off pathogens.
FIGURE 4 Prostaglandins can trigger vasodilation to direct blood flow to the site of an injury, causing swelling and redness.
Neutrophils and macrophages are both types of white blood cells (leucocytes) that play a significant role in the immune process. They are both phagocytes (able to perform phagocytosis) to engulf foreign invaders such as pathogens and harmful substances. A sac of enzymes (a lysosome) within these phagocytic cells fuses with the engulfed pathogen, causing it to be digested.
The phagocyte forms a groove, which engulfs the foreign cell.
The phagocyte ingests the foreign cell, forming a package or vesicle around it.
A lysosome and the vesicle containing the unwanted cell fuse together.
The unwanted cell is ‘lysed’ or broken down by lysozymes within the lysosome.
Foreign cell
Macrophage
Vesicle containing unwanted cell
Vesicle containing unwanted cell
Lysosome
Foreign cell
Lysozymes
Fused lysosome and vesicle
FIGURE 5 Phagocytosis occurs when a macrophage engulfs a foreign cell, forming a vesicle around it so it can digest the invader.
Neutrophils are the most abundant white blood cell in humans and the first to arrive at sites of infection. They have a short lifespan and when they die, due to bacterial toxins, they form pus.
Macrophages are scavengers that remove dead cells as well as foreign invaders such as pathogens. They arrive at a site of infection after neutrophils but stay longer, to continue engulfing dead cells and invaders. Macrophages can be fixed or wandering. Fixed macrophages are found in areas vulnerable to pathogen infection, such as the lungs and intestines. Wandering macrophages are found in several areas of the body, as they move through blood and lymph nodes to help detect invaders. Macrophages also release signals to recruit more immune cells to an area to assist with healing.


Blood clotting elements
Phagocytic leucocyte
Phagocytosis
The release of prostaglandins is triggered by chemical signals at site of injury.
Vasodilation increases blood flow to site of injury and helps transport of immune cells to injury site.
Neutrophils and macrophages attack foreign cells like pathogens.
Macrophages continue to attack foreign cells and clean up debris.
lymphocyte
a white blood cell in the lymphatic system
Lymphocytes are a type of small white blood cell in the lymphatic system. They play a significant role in the immune system. The lymphatic system is a series of vessels that pass tissue fluid through lymph nodes before returning it to the blood circulatory system. Pathogens become trapped in the lymph nodes, where they are systematically attacked by both lymphocytes and macrophages.
Right lymphatic duct
Right subclavian vein
Thoracic duct
natural killer (NK) cell a specialised lymphocyte involved in the innate immune response; induces apoptosis in tumour cells and virus-infected cells
apoptosis controlled cell death
Bone marrow
FIGURE 9 The human lymphatic system
Tonsil
Lymph nodes
Left subclavian vein
vessels
Masses of lymphocytes and macrophages
node
Natural killer (NK) cells are specialised lymphocytes involved in the inflammatory response. Like macrophages, NK cells are non-specific, as they lack antigen-specific binding receptors on their cell surface. These cells can detect virus-infected and cancerous host cells and induce the host cell to undergo controlled cell death, termed apoptosis. By doing so, NK cells help limit the spread of the disease.

The complement system consists of about 20 types of proteins that are formed in the liver. They are normally found in the blood plasma and intercellular spaces. Each type is produced in an inactive form and, when activated, can undergo a series of changes (termed a cascade) that results in parts of the protein being removed. Each step in the cascade produces a chemical that may react with a specific chemical on the foreign matter.
There are three pathways through which the protein complement can be activated on pathogen surfaces. The first pathway is activated by antibodies attaching to a pathogen’s antigen. In the second pathway, a chemical, lectin, attaches to the pathogen and this attachment activates the complement protein. In the third pathway, a complement protein recognises specific chemicals on the bacterial surface.
Alternative pathway
complement system a system of proteins that, once activated, support the ability of the body to eliminate pathogens and clear damaged cells
Antigen–antibody
Recruitment of inflammatory cells
Opsonisation of pathogens
FIGURE 11 The three pathways of complement activation
In each case, the complement may trigger:
• phagocytosis, by signalling phagocytes (opsonisation)
Killing of pathogens
• direct destruction, by the cascade’s terminal enzyme ‘punching’ holes in a bacterium’s wall and causing it to burst
• agglutination, by altering the surface of the bacterial cells and causing them to stick together, thus aiding phagocytosis
• neutralisation of viruses, by direct attack
• cell signalling, causing neutrophils and macrophages to move to the pathogen
• activating mast cells and basophils to release substances that lead to increased blood flow, and increased leakage of complement proteins to help inactivate or immobilise bacteria
• inflammation.
The complement system has the potential to cause damage to the body’s own cells, and so its activation needs to be tightly regulated. This is achieved by complement control proteins that are present at a higher concentration in the plasma than the complement proteins themselves. Some of these control proteins are also present on the membranes of self-cells to prevent them being targeted.
The adaptive immune response needs to be “primed” before it can be fully effective – that is, it needs to form a record of past exposure of the body to potentially dangerous molecules and pathogens. This last line of defence specifically targets foreign substances on pathogens or proteins on cancerous cells.
Antigen-binding sites
Light chain
Heavy chain
Hinge region
FIGURE 12 Antibodies are quaternary proteins with two heavy chains and two light chains. The hinged regions of antibodies provide the flexibility to link pathogens together.
T-lymphocyte a lymphocyte that has passed through the thymus during maturation humoral response
immunity conferred to an individual through the activity of B-lymphocytes and their progeny, which produce circulating antibodies in response to the presence of an antigen and recognise the substance upon subsequent exposure
The adaptive immune system distinguishes two groups of foreign substances:
• antigens – molecules on the surface of viruses and foreign cells
• self cells that display abnormal MHC self-marker proteins (from antigens that have been engulfed and broken down, or from virus-infected and tumour cells that are actively synthesising foreign proteins).
These two groups of molecules are detected as foreign to the body by specialised white blood cells called lymphocytes. Lymphocytes enter the bloodstream from the bone marrow and follow one of two pathways as they mature. Those that pass through the thymus gland become sensitised and form T-lymphocytes or T-cells. Lymphocytes that do not pass through the thymus are called B-lymphocytes or B-cells.
B-lymphocytes are a special group of white blood cells. They congregate in lymph nodes, the tonsils, spleen, appendix and specialised areas (Peyer’s patches) in the gut. The humoral response is a specific immune response that involves the activation of B-lymphocytes to produce and clone antibodies. When B-lymphocytes encounter a particle with a non-self antigen on its surface, they produce a gamma globulin molecule. The gamma globulins contain five classes of immunoglobulin or antibodies that differ in the amino acid sequence of one part of the gamma globulin molecule. The specific sequence is initiated by the B-lymphocyte in response to a particular antigen. The antibodies produced by each B-lymphocyte will recognise the shape of only one antigen molecule.
Secretory protein
FIGURE 13 There are five main types of antibodies. Each plasma cell only produces a single kind of antibody.
When an antibody binds with an antigen, it may:
• block parts of the pathogen needed to survive (neutralisation)
• cause the foreign matter to agglutinate (stick together) to facilitate phagocytosis
• cause the foreign matter to break up and dissolve (precipitation)
• produce an antitoxin to the pathogen’s toxins (complement activation).
Clone of
cells
antibodies Soluble antigens or Pathogen Antigen
Formation of antibody–antigen complex inactivates antigens by
Neutralisation
Agglutination blocks viral binding sites; coats bacteria
clumping of antigenbearing particles, such as microbes
Bacterium
Virus Bacterium
is followed by
Phagocytosis
Macrophage
Antibody
Precipitation of soluble antigens action of complement
Complement activation
Complement
Soluble antigens
Foreign cell membrane
Complement embeds into the foreign cell membrane and breaks the membrane so the cell lyses

Cell lysis

FIGURE 14 Antibodies produced by B-lymphocytes can perform a variety of actions to fight off pathogens.
After an antigen has bound to the complementary receptor on the B-lymphocyte and the B-lymphocyte has come in contact with cytokines produced by T-helper cells, B-lymphocytes are activated to rapidly divide and produce many identical cells. These cells can differentiate into two cell types: plasma cells and memory B-cells.
Plasma cells are mature B-lymphocytes that produce and secrete large numbers of antibodies that have combining sites complementary to a particular antigen. Other B-lymphocytes become memory cells called memory B-cells. These cells persist long after the original antigen has been removed or destroyed, and become new antibodyproducing plasma cells in reinfection.
When a memory B-cell is produced, antibodies bind to its plasma membrane and act as receptors. If a complementary antigen binds to the antibody receptor, a message is passed to the memory B-cell. Memory B-cells often act as antigen-presenting cells and help activate T-lymphocytes (in the cell-mediated response). This can help accelerate the immune response the second time a pathogen attacks. When a memory B-cell
plasma cell a cell developed from activated B-lymphocytes that makes large numbers of a specific antibody memory B-cell a small, long-lived B-lymphocyte that has previously encountered a given antigen; on re-exposure to the same antigen, it rapidly initiates the immune response Plasma cell Memory B-cell
15 B-lymphocytes can differentiate into either plasma cells or B-memory cells.
First infection
detects an antigen, it reproduces and differentiates into more plasma cells more quickly than unspecialised B-lymphocytes. This rapid response can prevent infection spreading through the body.
Primary antibody response
Short-lived plasma cells in lymphoid organs
Activated B-cells
0
Second repeat infection
Long-lived plasma cells in bone marrow
Low-level antibody production
Long-lived plasma cells in bone marrow
Days after antigen exposure
FIGURE 16 Memory B-cells can produce a larger number of antibodies the second time an antigen presents itself in the body.
cell-mediated
response
antigen activation of T-lymphocytes in the thymus to release soluble proteins to inactivate a pathogen
antigenpresenting cell (APC)
an immune cell that processes and presents an antigen for T-lymphocyte recognition
helper T-lymphocyte
a type of T-lymphocyte that stimulates the activity of other immune cells by producing cytokines
cytotoxic T-lymphocyte
a type of T-lymphocyte that kills cancerous cells and virus-infected cells
The cell-mediated response is an adaptive immune response that involves T-lymphocytes to remove infected or cancerous cells. When a cell becomes infected by a pathogen, it processes the pathogen’s antigen and presents the antigen on the surface of its cell membrane. Other cells that present antigens on their surface are macrophages, B-cells and dendritic cells. These cells are referred to as antigen-presenting cells (APCs). Antigens stimulate the production of T-lymphocytes in the thymus gland. In the thymus, mature T-lymphocytes differentiate into different cell types.
Helper T-lymphocytes are activated by antigens presented on the MHC-II markers of APCs (e.g. macrophages, B-cells). Once activated, helper T-lymphocytes undergo clonal proliferation, producing more helper T-lymphocytes, which release cytokines. Cytokines produced by helper T-lymphocytes can activate B-lymphocytes (to stimulate antibody production) and activate cytotoxic T-lymphocytes.
Cytotoxic T-lymphocytes are activated by antigens presenting on cells with MHC-I markers and by cytokines produced by helper T-lymphocytes. Once activated, these cells kill cancerous, virus-infected or damaged cells by producing cytotoxic molecules (perforin and granzyme) that can initiate apoptosis (cell death) in an infected cell. Cytotoxic T-lymphocytes will not attack APCs, as they present an MHC-II marker.

FIGURE 17 Cytotoxic T-lymphocytes produce cytotoxic molecules (perforin and granzyme) to initiate apoptosis in infected cells.
Other T-lymphocytes include:
• suppressor T-lymphocytes, which switch off the immune response and suppress the activity of other immune cells when they are no longer needed.
suppressor T-lymphocyte a type of T-lymphocyte that regulates the actions of some other lymphocytes to prevent over-activity of the immune system
• memory T-lymphocytes, which are formed after infection and remain present to recognise the antigen if it is reintroduced, providing long-term immunity.
T-lymphocytes are responsible for reactions such as graft rejections, delayed hypersensitivity and resistance to cancer. Although T-lymphocytes and B-lymphocytes are capable of producing independent immune responses, they sometimes work together.
The HIV virus attacks helper T-lymphocytes, thus inhibiting the whole immune system. A person with AIDS is therefore vulnerable to all kinds of diseases. It has also been found that mental stress, bereavement, loneliness and depression affect the operation of the lymphocytes and reduce T-lymphocyte activity.

memory T-lymphocyte a long-lived T-lymphocyte that has previously encountered a given antigen; on re-exposure to the same antigen, rapidly initiates the immune response
Free pathogen clearence by specific antibody










Cytotoxic molecules MHC/antigen complex

Production of pathogenic self-reactive antibodies

















Whole-self antigen Apoptosis




























18 The cell-mediated response involves the recognition of antigens, which activates helper T-lymphocytes and cytotoxic T-lymphocytes.
Thanks to advances in medical technology, it is possible to replace a diseased organ from one individual with a healthy organ from another individual. In kidney transplants, this usually involves the transfer of a single kidney from a healthy living donor. Both recipient and donor are able to survive with a single kidney. The success of the transplant depends on the compatibility of the donor and recipient cells. Only identical twins have exactly the same MHC I markers on their cells. Closely related individuals generally have similar antigens, due to their similar genetic backgrounds; however, inheriting different sets of genes from each of their parents will result in some differences. The tissues of potential recipients are carefully examined to ensure their markers are as closely matched as possible to that of the donor. The closer the MHC I compatibility between donor and recipient, the smaller the immune response. Low compatibility can result in tissue or organ rejection (graft-versus-host disease). Most recipients are treated with immunosuppressant drugs to prevent the action of the immune system and its rejection of the transplanted organ. This can delay rejection for many years.
Apply your understanding

1 Describe the immune response in a patient receiving transplanted donor tissue.
2 Describe why your identical twin would be the safest option for an organ transplant.
Component
Description
Antibodies Proteins produced by the body when it detects specific antigens.
Different antigens stimulate the production of different corresponding antibodies.
B-lymphocytes Special kind of lymphocytes. Produced in bone marrow.
Control (humoral) antibodymediated immunity.
T-lymphocytes Special kind of lymphocytes. Produced in the bone marrow.
Mature in thymus gland.
Control cell-mediated immunity.
Role
Bind with antigens, causing them to clump together to form an antibody–antigen complex.
An antibody–antigen complex is more easily recognised and destroyed by macrophages than antigens alone.
When a B-lymphocyte recognises an antigen, it is cloned to produce a mass of identical cells.
The B-lymphocytes work as antibody producers (plasma cells) or memory cells, which provide long-term immunity.
Cytotoxic T-lymphocytes produce toxic substances that destroy cells that have been invaded by a pathogen. They defend the body from cancer cells and transplant tissue.
Helper T-lymphocytes help B-cells divide rapidly.
Suppressor T-lymphocytes turn off the immune response and suppress the production of antibodies when they are not needed.
Memory T-lymphocytes recognise the antigen if it is reintroduced, providing long-term immunity.
Contaminated food and water
Digestive system
Respiratory system Reproductive and urinary systems
First lines of defence
Lysozyme in saliva
Stomach acid and enzymes
Mucus containing glycogen broken down to acids
Mucus moved by cilia
Skin
Vector organisms
Vector-transmitted parasites bypass first line of defence
Acid, salty, oily skin
Sweat
Sebum
Ciliated cell
Macrophages in alveoli Goblet cell Gastric pits
Stratified epithelium Connective tissue
Periodic flow of urine
A few parasites get through
Second lines of defence
Sweat gland
Sebaceous gland
Non-specific immune responses: ∙ inflammation ∙ complement system
Third lines of defence
Specific immune responses:
antibodies
T-lymphocytes
B-lymphocytes
Stratum corneum
Rapid wound healing
Check your learning 12.5
Check your learning 12.5: Complete these questions online or in your workbook.
Retrieval and comprehension
1 Describe ways in which pathogens can enter the body. (4 marks)
2 Define the immune system. (1 mark)
3 Explain how host cells recognise self from non-self and the importance of this in the immune response. (4 marks)
4 Describe the inflammatory response. (6 marks)
5 E xplain the role of memory cells in the immune response. (4 marks)
Describe and explain
6 C ontrast the specificity of the three lines of defence in vertebrates. (3 marks)
7 C ontrast an antigen and an antibody. (3 marks)
Learning intentions and success criteria
Knowledge utilisation
8 a Explain why B-lymphocytes and T-lymphocytes are considered part of the adaptive immune system rather than the innate immune system. (2 marks)
b Predict how B-lymphocytes and T-lymphocytes would be involved in the body’s response to:
i an infected cut on a finger (2 marks)
ii virus-infected cells (2 marks)
iii a grafted kidney. (2 marks)
→ Immunity is the ability to resist disease. It can be acquired actively or passively.
→ Natural active immunity can occur when memory T-lymphocytes and B-lymphocytes have formed following infection.
→ Artificial active immunity can be achieved by vaccination with inactivated antigens.
→ Passive immunity results from the intake of antibodies. They may be acquired naturally, by placental diffusion or from breast milk when a baby feeds (natural), or acquired artificially by an injection of antibodies from a previously infected individual (artificial).
→ Immunological tolerance is the ability of some organisms to tolerate cells other than their own, provided they are introduced to the organism during the early stages of its development or in supervised, minute amounts at later stages.
Individuals may recover from disease caused by pathogens as a result of the immune responses of the B-lymphocytes and T-lymphocytes. Due to the formation of memory cells for a particular pathogen, the body builds up resistance or immunity to further attacks by the
same type of organism. This is termed natural active immunity. “Natural” refers to the individual being exposed to the living pathogen, and “active” refers to the production of the memory cells.
Natural passive immunity is obtained when a mother is exposed to the living pathogen (natural) and then passes her antibodies to the foetus through the placenta. As the baby does not produce memory cells, the immunity is termed “passive”. These antibodies are also present in the first “milk” (colostrum) secreted after birth. This immunity lasts for only a short time after birth, but further antibodies are contained in the mother’s milk.

FIGURE 1 Antibodies are present in colostrum.
natural active immunity immunity that occurs when a person is exposed to a live pathogen and develops a primary immune response, which leads to immunological memory
natural passive immunity antibody-mediated immunity conveyed to a foetus or infant by the mother
colostrum the first form of milk produced by the mammary glands of mammals (including humans) immediately following delivery of a newborn
Immunity can also be acquired artificially. Injection of an individual with deactivated antigens, or parts of antigens, can induce the immune system to react and ultimately produce memory cells. This vaccination or immunisation allows an individual to acquire artificial active immunity. Three general types of antigens used in vaccines are:
• sterile bacterial exotoxins
• sterile, dead microorganisms
• living infectious microorganisms whose ability to cause serious infection has been altered.
A vaccine is produced to target a specific pathogen, usually from a cultured sample. The pathogen is either killed or genetically altered so that it is no longer harmful. Once injected into an individual, the immune system reacts to the foreign antigen on the pathogen’s surface and forms memory cells that last for a period of time. The body’s defence system is thereby “sensitised” and immunity is achieved without the individual having to suffer the effects of infection by the pathogen. If the immunised person or animal becomes infected by the pathogen during that time, the memory cells quickly recognise it and the immune reaction is rapid enough to prevent the disease developing.

artificial active immunity active immunity acquired by vaccination with a vaccine containing active antigens, to prevent the development of a disease in the future vaccine a biological suspension administered to provide artificial acquired immunity against a particular disease
Vaccines against viruses are more difficult to produce than those for bacteria, because viruses undergo rapid changes to their protein coats and, therefore, their antigens. So an influenza vaccination from one year could be ineffective in preventing people from contracting a different form of flu in the following year. Also, because viruses are not living organisms, they cannot be killed. To produce the virus in adequate numbers for a vaccination program, a living host or tissue culture is required. The virus’s nucleic acid core is removed or chemically destroyed, leaving just the antigenic protein coat, so the viral particle cannot cause a host cell to produce more viral particles. When a vaccine is produced, it must undergo rigorous testing to ensure it is effective.
TABLE 1 Types of vaccines and their effectiveness
Disease Type of vaccine Effectiveness Possible complications if the disease is contracted
Diphtheria (bacterial) Toxoid
Almost 100% for 10 years
Influenza (viral) Altered One season
Measles (viral) Weakened
Mumps (viral) Weakened
Poliomyelitis (viral) Weakened (Sabin), and nucleic acid destroyed (Salk)
Rubella (viral) Weakened
Human papillomavirus (viral)
Synthesised viral particles
95% for at least 21 years
90% for 12 years
95% for 10 years
95% for 16 years
Long term if given to 12- to 13-year-old boys and girls
Tetanus (bacterial) Toxoid 100% for 10 years
Whooping cough (pertussis) (bacterial)
Meningococcal C disease (meningitis) (bacterial)
Killed
A conjugate vaccine composed of a carrier protein attached to an antigen made from the coat of the bacteria*
70 to 80% for 2 to 10 years
Individuals 1 to 19 years: one dose gives long-term immunity.
Nerve, heart problems, death
Respiratory, cardiac problems, death
Infants 6 weeks to 4 months: need three doses of the vaccine for long-term immunity.
Infants 1 to 12 months: need two doses of the vaccine for long-term immunity.
Blindness, deafness, encephalitis, death
Sterility in males, inflammation of male and female sex organs
Paralysis, lameness
Possible foetal deafness and/or blindness if a pregnant woman contracts the disease in the first 12 weeks of pregnancy
Cervical cancer in females and penile cancer in males; also throat and/or anal cancer
Respiratory, cardiac problems, death
Pneumonia, convulsions, encephalitis, death in infants
Meningitis (inflammation/ swelling of the lining of the brain)
Septicaemia (blood poisoning)
*This vaccine has been introduced as a free vaccine for 1- to 19-year-old individuals in response to the increased incidence of meningococcal C disease in recent years.
Notes:
• Weakened pathogens are altered to decrease infection. Many bacterial pathogens are killed for vaccination. A toxoid is an inert toxin of the type produced by the bacterium in question.
• Effectiveness is for adults or from teenage years on.
Serums contain antibodies to specific antigens. In the case of serious infections, such as diphtheria and tetanus, the reaction to the bacterial toxin may be too fast for the individual to develop antibodies. Specific antibody serums are administered to counteract the infection and produce immediate resistance. In the case of most snake or spider bites, serums containing the antibodies to the specific toxins in the venom are produced (antivenom).
This is termed artificial passive immunity. This type of immunity typically lasts for a year or so.

3 Injection of a snake antivenom serum can provide artificial passive immunity.
serum a suspension of preformed antibodies administered to provide artificial passive immunity against a particular disease
artificial passive immunity immunity acquired by injection of serum containing antibodies into an individual who may have been infected with a particular pathogen
Natural Production of antibodies following exposure to antigens on living pathogen, producing immunological memory.
Artificial
Production of antibodies following exposure to antigens by vaccination, producing immunological memory.
4 Summary of the different types of immunity
Natural Antibodies passed to a foetus or infant by its mother, with no development of immunological memory.
Experimental evidence indicates that the ability of lymphocytes to distinguish “self” from “non-self” is learned over time. This principle has been applied to some people who have an allergy to bee stings. Under medical supervision, it has been possible to introduce very small amounts of the bee venom to the allergic individual. Over time, the immune system learns that the allergens in the bee venom are not dangerous and starts producing a special type of T-lymphocyte that suppresses the rest of the immune cells. This condition is known as immunological tolerance. It is possible to develop this tolerance if:
• the animal receiving the antigen is very young
• the dose of antigen is high
• the antigen has a low molecular weight
• the dose of antigen is prolonged or repeated.
Artificial
Antibodies passed to an individual by injection of serum, with no development of immunological memory.
allergen an antigen that causes an allergic reaction in an organism immunological tolerance the body’s failure to mount an immune response to an antigen
+ some non-self cells introduced
These cells will be included as self-cells.
Developing lymphocytes: those with shaded receptors are tolerant of self-cells and those with cross-hatched receptors are tolerant to non-self cells.
The lymphocytes that tolerate the non-self cells will remain in the system and recognise the non-self cells that have been introduced early in development as self.
The lymphocytes that do not tolerate self will not develop further.
FIGURE 5 The development of immunological tolerance
autoimmune disease a disease in which the body produces antibodies that attack its own tissues
haemolytic anaemia a form of anaemia due to haemolysis, the abnormal breaking down of red blood cells
interferon
a small protein- and glycoprotein-signalling molecule produced by lymphocytes in response to infection and other biological stimuli
Autoimmune disease occurs if an organism loses its ability to distinguish “self” from “non-self”. As a result, the individual’s immune system manufactures antibodies against certain of its own cells. Cells of the blood, liver, kidneys, endocrine glands and stomach lining are most susceptible. Some autoimmune diseases can be treated with immune-suppressive drugs to prevent destruction of healthy cells. These drugs are similar to those used in grafting when a tissue or organ comes from another individual.
Haemolytic anaemia occurs when antibodies are formed against the individual’s own red blood cells. The red blood cells break down after only a few days in circulation instead of the normal 100 to 120 days. The body cannot produce enough red blood cells to compensate for the large number being broken down. This results in a much depleted oxygen supply to the cells.
Many animals, including humans, produce a group of substances in response to viral infections. These small protein molecules, collectively termed interferons, prohibit further increase in viral numbers. Interferon prevents viral DNA instructing the host cell to produce more virus particles. Each species produces a specific interferon. Unlike other proteins, interferons are resistant to excessive heat and acidity.
Check your learning 12.6
Check your learning 12.6: Complete these questions online or in your workbook.
Retrieval and comprehension
1 E xplain how memory B-cells or memory T-cells are formed. (4 marks)
2 Describe two ways in which a person can become immune to a pathogen. (2 marks)
3 Describe what a vaccine is, using an example. (2 marks)
Analytical processes
4 Compare naturally acquired and artificially acquired immunity. (4 marks) Knowledge utilisation
5 Travellers to Africa are given immunoglobulin injections against hepatitis A infection. Deduce the type of immunity that has been conferred. (1 mark)
→ Plants are subject to pathogenic attack by viroids, viruses, bacteria, fungi, oomycetes, slime moulds, roundworms and parasitic plants.
→ Plant physical defences against pathogens include bark and waxy cuticles.
→ If pathogens breach a plant’s physical barriers, the plant can respond with secondary metabolites, which are often toxic compounds that may harm the pathogen.
→ Plant chemical defences again pathogens include defensins and toxins.
Like animals, plants can be infected with pathogens. All humans depend, either directly or indirectly, on plants for food. Plants also provide many non-food products such as wood, dyes, textiles, medicines, cosmetics, soaps and industrial chemicals. Pathogenic infections of plants therefore directly affect the human population. The main plant pathogens are viroids (RNA molecules without a protein coat), viruses, bacteria, fungi, fungus-like oomycetes, protozoa, nematodes (roundworms) and parasitic plants. Ectoparasites, such as insects and mites, affect plant growth by eating the tissues. This may make the plant more susceptible to pathogen entry through wounds. Some ectoparasites are vectors for pathogens.


Learning intentions and success criteria viroid an RNA molecule without a protein coat
ectoparasite a parasite that lives on or in the skin, but not within the body (e.g. a flea)
In Australia, diseases of bananas have resulted in financial loss to growers and food shortage for consumers. Bunchy top is a viral infection that attacks conducting tissue in newly emerging leaves in banana plants in south-east Queensland and northern New South Wales. It results in short, narrow leaves that stand more upright than normal. A sap-sucking aphid is the vector for the virus. All banana plants in the area have to be destroyed to prevent further spread.
Bananas can also be affected by Panama disease, which is caused by a fungus (Fusarium sp. TR4 variety) and causes wilting of the plant by blocking water-conducting vessels. This disease destroyed a large proportion of commercial Cavendish banana crops in the Northern Territory in 1997 and in a plantation in Tully, North Queensland, in 2015. Because the fungus can remain in the soil for decades, the plants must be destroyed and the property quarantined, to prevent soil movement to other properties.
Two types of oomycetes also affect Australian crops. Phytophthora cinnamomi causes die-back in avocadoes and eucalypts (particularly the jarrah forests of Western Australia) as well as affecting flowering rhododendrons, azaleas and camellias. Phytophthora citrophthora causes collar rot in a variety of fruit trees, resulting in cracking and oozing of sap from the bark at the base of the trunk.
TABLE 1 Some additional plant pathogens and their effects
Pathogen
Viroids
Viruses
Tobacco mosaic virus
Squash mosaic virus
Rice mosaic virus
Bacteria
Erwinia
Agrobacterium
Pseudomonas syringae
Fungi
Thielaviopsis
Sclerotmia sclerotiorum
Claviceps purpurea
Urstilago
Puccinia
Armillaria
Slime moulds
Plasmodiophora
Spongospora
Nematodes (roundworms)
Globodera
Root knot
Parasitic plants
Mistletoe
Dodder
Plant affected and symptoms
Potatoes – spindle-tuber disease
Tomatoes – twisted leaves, stunted growth
Large number of species – stunted growth
Members of the melon family – distorted fruit, mosaic leaf pattern
Rice plants – mottled and stunted leaf growth
More prevalent in tropics and subtropics
Soft rot
Stone fruit – tumours (on stems)
Gladioli bulbs – scabs
Tomatoes – reduced fruit production
A large range cause black spot on roses, gerberas and strawberries, grey mould on flowering annuals, dollar spot in lawns, downy mildew and powdery mildew on leaves.
Cancer root, black root rot
Cotton rot
Dutch elm disease
Smut
Rusts on cereals and grasses
Ringbark the roots of trees
Cabbages – club root
Potatoes – powdery scab
Affect roots (e.g. tomato) and bulbs (e.g. daffodil)
Potato cyst
Affects uptake of water and nutrients for normal growth in a wide variety of plants
Compete with the host plant for nutrients
Extract nutrients from the host plant
Transmit viruses
Plants have a range of innate mechanisms to inhibit entry, detect invading organisms and stop them before they cause extensive damage. Most plant pathogens are hostspecific or only infect a related group of plants. For example, the family Solanaceae includes tobacco, potato and tomato plants, all of which can be infected by the tobacco mosaic virus. Other groups of plants are not susceptible to this virus. Some pathogens have evolved mechanisms to overcome or avoid the plant’s defences. Plant defence mechanisms may be physical, such as barriers and leaf structure, or chemical, such as production of defensins and toxins.


4 Tobacco mosaic virus: (A) virus particles, and (B) effect on the leaf. This virus was the first to be identified (1930) although its effects were first noticed in tobacco crops in the 1800s. The virus affects over 350 species, causing stunting, mosaic pattern of light and dark green (or yellow and green), with yellow streaking or spotting on the leaves and malformation of leaves or growing points.
Many plants have impenetrable barriers, such as bark, waxy cuticles and cell walls, which are resistant to many pathogens, although some pathogens can infect young leaves that have thin cuticles. Because plants can be attacked by other organisms, such as insect pests and herbivores, many have leaf hairs (often containing chemicals) to defend themselves. Others have thorns (modified branches), spines (modified leaves) or prickles (outgrowths of the epidermis) to protect against grazing animals. These features also act as barriers to pathogens. Some plants have a thick waxy cuticle on their leaves, which hang vertically. This prevents the formation of a moisture film on the leaf surface. Dry surfaces inhibit infection by bacteria, fungi and nematodes, as these organisms need water to survive while they adhere to the cell’s surface. Vertical surfaces, however, are more prone to windborne pathogens.


plant defensin a protein produced by a plant to inhibit development of fungi, bacteria and viruses
toxin a chemical compound
Stomata are natural openings in plants that are potential entry points for pathogens and their vectors. Stomatal size relative to the size of the pathogen may be important. For example, mandarins are resistant to citrus cancer because their stomata are too small for the causative agent to enter.

. These are small proteins that inhibit the development of fungi, bacteria and viruses. Some plant defensins accumulate during normal development, while others are induced by a plant wound. For example, MsDef1 is a plant defensin produced by alfalfa. It protects the plant against several fungal pathogens by destabilising the fungal cell membranes, causing leakage of contents and eventual
Some plants also produce toxins, which are chemical compounds that deter or fight against herbivores and pathogens. There are many types of plant toxins, and each toxin acts in a specific way. It can interfere with the metabolic processes of pathogens or herbivores by interfering with enzyme action, breaking down cell membranes, disrupting neurotransmission or producing other toxic effects. For example, nicotine is a neurotoxin produced by tobacco plants. Nicotine is extremely toxic to herbivorous species; when consumed, it disrupts the nervous system functioning of insects and herbivores, causing muscle spasms and overstimulation of neurons.

Another example of a plant toxin is a group of chemicals called saponins, which are produced by a range of plant species including peas, quinoa, soybeans, spinach and clematis. Saponins bind to cholesterols in the plasma membranes of pathogenic species and cause the cells to lose their structural integrity and undergo lysis. Saponins can also give plants a bitter taste and cause digestive discomfort to herbivores, which helps to deter herbivore species from consuming the plant.
Check your learning 12.7: Complete these questions online or in your workbook.
Retrieval and comprehension

1 E xplain why diseases in plants can have a significant impact on human survival. (2 marks)
2 Identify and describe a plant pathogen. Include the method of infection and the effects of the disease. (4 marks)
3 Identify two plant diseases that are of economic significance to humans. For each disease, name the pathogen that causes the disease, and how the disease affects the plant. (6 marks)
4 Describe how the physical defence strategies of barriers and leaf structure defend plants against a large variety of pathogens. (2 marks)
5 Describe how the production of toxins protects a plant from infection. (2 marks)
• Disease is any physiological abnormality or significant disruption in the “normal” health of an organism.
• Non-infectious diseases cannot be spread from an affected individual to another individual.
• Infectious diseases can be spread from an infected individual to another individual.
• Pathogens are biological agents that spread disease.
• Parasites are cellular organisms that obtain nutrients from a host and rely on a host for survival.
• An endemic disease is one that exists in a population at regular low levels. An epidemic occurs when a larger than normal number of individuals in a particular locality are infected by a disease at a particular time. If the disease spreads to other countries, it is termed a pandemic.
• Viruses are non-living particles composed of nucleic acid covered in a protein coat.
• When a virus invades a cell, it causes the host cell to produce more virus particles.
• Many human diseases are caused by viruses, with influenza being the most virulent. Many viruses are able to cross hosts from animals to humans.
• Some diseases result from abnormal prion proteins, which cause normal proteins to become dysfunctional.
• Pathogens may be microbes (bacteria, protists or fungi) or macroorganisms (e.g. flukes,, tapeworms or roundworms).
• Many microbes and macroorganisms are pathogens of humans, their domesticated animals and cultivated plants. Some pathogens are transmitted via the air, in contaminated food or water, or by a vector.
• Protists are animal-like, unicellular eukaryotes, and some cause fatal diseases such as malaria and African sleeping sickness.
• Most macroscopic endoparasites of humans are flatworms (e.g. tapeworms) or roundworms (hookworm, Ascaris). Untreated, diseases from these worms can be fatal.
• Pathogenesis is the series of steps by which a pathogen causes disease in a host.
• The virulence of a pathogen refers to its ability to cause damage to its host.
• Virulence factors are molecules that can contribute to the survival of a pathogen, and therefore its pathogenesis. They include adherence factors, invasion factors, capsules and toxins.
• There are three lines of immune defence: the innate immune response, the inflammatory response and complement system, and the adaptive immune response.
• The innate immune response is the system of non-specific defence mechanisms including physical barriers such as skin, chemicals in the blood, and white blood cells that attack foreign cells in the body.
• The inflammatory response is the body’s response to an injurious agent. It is characterised by swelling, pain and/or heat.
• The complement system is a system of proteins (formed in the liver) which, when activated by the presence of an antigen, produce chemicals that bring about inactivation of foreign matter.
• The adaptive immune response a specific immune response that is “learned” when a person’s immune system encounters foreign “invaders” and recognises non-self substances (antigens) – the response generates special chemicals (antibodies) to neutralise a specific pathogen.
• Immunity is the ability to resist disease. It can be acquired actively or passively.
• Natural active immunity can occur when memory T-lymphocytes and B-lymphocytes have formed following infection.
• Artificial active immunity can be achieved by vaccination of inactivated antigens.
• Passive immunity results from the intake of antibodies. They be acquired naturally, by placental diffusion or from breast milk when a baby feeds (natural), or acquired artificially by an injection of antibodies from a previously infected individual (artificial).
• Immunological tolerance is the ability of some organisms to tolerate cells other than their own, provided they are introduced to the organism during the early stages of its development or in supervised, minute amounts at later stages.
• Plants are subject to pathogenic attack by viroids, viruses, bacteria, fungi, oomycetes, slime moulds, roundworms and parasitic plants.
• Plant physical defences against pathogens include bark and waxy cuticles.
• If pathogens breach a plant’s barriers, the plant can respond with secondary metabolites, which are often toxic compounds that may harm the pathogen.
• Plant chemical defences again pathogens include defensins and toxins.
Review questions: Complete these questions online or in your workbook.
1 Phagocytes are best described as
A complex chemical compounds consisting of molecules with large numbers of atoms.
B arrangements of protein molecules with digestive properties similar to those of enzymes.
C living cells that reproduce rapidly at points of bacterial invasion.
D living cells able to ingest bacteria and cell pieces.
2 Which one of the following statements about antibodies is correct?
A They are molecules on the outer surface of a pathogen that can initiate an immune response.
B They combine with phagocytes to form cells that are resistant to invading particles.
C They are produced in response to the stimulus of bacteria and viruses entering the body.
D They are produced by antigens present in the body.
3 A non-infectious disease may be caused by all of the following except
A an inherited condition.
B drug abuse.
C prions.
D malnutrition.
4 Infectious diseases may be
A caused by overnutrition or undernutrition.
B contagious or non-contagious.
C a dysfunction of the body due to environmental pollution.
D a result of poor lifestyle choices.
5 The virulence of a pathogen refers to
A its ability to infect a range of different organisms.
B the independence of its ability to resist the host’s immune system.
C its ability to cause damage to its host’s tissues
D the variety of toxins all pathogens can produce.
6 Viruses
A are molecules of protein surrounding a nucleic acid core.
B can be considered living because they can reproduce.
C can infect other organisms but only cause disease in humans.
D can only be transmitted through direct contact from an infected to a non-infected individual.
7 Which of the following is correct?
Barrier Method of defence
A Skin Oil and sweat glands produce antiviral substances.
B Mucous membranes
The cells produce substances that inhibit the growth of pathogens.
C Skin The acidity of skin makes it inhospitable to all microbes.
D Mucous membranes
All secrete mucus to defend against pathogens.
8 The difference between the innate and adaptive immune systems is that the innate immune system
A needs the stimulation of a pathogen to bring about a response.
B is always working and does not require any special preparation to prevent infection.
C involves T-lymphocytes that engulf and destroy pathogens.
D is stimulated by the complement system of proteins.
9 An example of natural passive immunity is
A diffusion of antibodies across the placenta from foetus to mother.
B diffusion of antibodies across the placenta from mother to foetus.
C injection of sterile, dead pathogens.
D formation of memory cells to an antigen.
10 The blood types of humans are classified according to two major blood group systems, the ABO system and the Rhesus (Rh) system. These groups are identified by the presence or absence of antibodies in the plasma, and antigens on the surface of the red blood cells. For example, an individual with B type blood produces B type antigen on the surface of their red blood cells, and would produce anti-A antibodies, as their immune system has never been exposed to the A type antigen. The table gives the proportion of Australians who have each of the blood groups.
Blood group Percentage of Australian population (%)
9
Which antibodies would be present in the blood of people in the Australian population with the rarest blood group?
A anti-A only
B anti-B only
C anti-A and anti-B
D no antibodies
11 Mercury poisoning can cause paralysis and brain damage. What type of illness is this?
A infectious disease
B environmental exposure
C genetic disease
D metabolic disease
12 Bordetella pertussis is a bacterial pathogen that causes whooping cough. B. pertussis produces a protein that is excreted by the cell. The protein disrupts the host’s immune response by inhibiting the actions of infected cells that would attract and recruit immune cells in defence. Determine the type of protein.
A adhesion
B invasion factor
C endotoxin
D exotoxin
13 Identify which of the following is not a type of antigen used in vaccines.
A sterile bacterial exotoxins
B dead microorganisms
C living, fully pathogenic microorganisms
D living microorganisms that have been altered to remove pathogenicity
14 A patient visits their doctor complaining of being short of breath and lacking in energy. The doctor notes that the patient is quite pale. Which nutrient is the patient likely to be deficient in?
A iron
B sodium
C phosphorus
D carbohydrate
Review questions: Complete these questions online or in your workbook.
and comprehension
15 Define the term “antigen”. (1 mark)
16 Describe which structural features of a tapeworm enable it to survive in its host. (3 marks)
17 Explain how invasion factors increase the virulence of a pathogen. (6 marks)
18 E xplain why it is useful for B-lymphocytes to be highly variable, but essential that helper T-lymphocytes do not change. (4 marks)
19 E xplain why an injection of ready-made antibodies is called “passive” immunity. (2 marks)
20 Explain the importance of host cell selfrecognition, using an example of an autoimmune disease to support your response. (4 marks)
21 Explain the cell-mediated response to an infectious disease. (5 marks)
22 Describe the chemical defence strategies of the immune response in plants. (4 marks)
23 Some vaccines provide long-term immunity, while others are only effective for a short period. Explain why immunity may not last for the life of an individual after infection or vaccination. (3 marks)
Analytical processes
24 Compare active and passive immunity. (6 marks)
Knowledge utilisation
25 Many women suffer from high blood pressure during pregnancy. Using the definition of disease, determine whether this increase in blood pressure would be considered a disease compared to high blood pressure in non-pregnant people. (2 marks)
immune system, giving reasons to support your predictions. (4 marks)
27 The Hendra virus was discovered in 1994 after the death of 13 horses and a trainer in Queensland. Horses become infected after coming into contact with the bodily fluids of flying foxes. Humans, such as trainers and veterinarians, are most at risk when they come into contact with a horse’s bodily fluids.
a Determine the primary host of the Hendra virus. (1 mark)
26 Scientists wanted to test the hypothesis that a given B-lymphocyte makes only one specific antibody against an antigen. They injected an animal simultaneously with two different antigens. After waiting for the animal’s immune system to respond, they took a sample of blood. From the blood, they isolated single plasma cells and tested whether each one produced antibodies to one or both of the antigens.
Predict the results you would expect for the B-lymphocytes based on your knowledge of the
b Determine the secondary host of the Hendra virus. (1 mark)
Analysing antibody data
Prior to birth, antibodies in the mother are passed to the infant via the placenta. After birth, the infant starts making their own antibodies, while also receiving maternal antibodies from breast milk, which help protect the infant until their immune defences are developed. The figure shows the levels of different forms of antibodies (Ig) in an infant, from three months prior to birth to 18 months old.
The table shows some of the characteristics of the different types of antibodies in body fluids.
Ability to cross placenta
Present in saliva and tears
Present in milk
Active against viruses
Active against some bacteria
Involved in allergy reactions
The figure shows the changes in the levels of these immunoglobulins during pregnancy and for a period after birth.
Apply understanding
1 Identify the age when maternal IgG is no longer detectable in the infant. (1 mark)
2 Determine when the newborn infant has the greatest chance of infection by bacteria, supporting your response with information from the graph. (2 marks)
Analyse data
3 With reference to the graph, describe the changes in how immunity is acquired, from prior to birth to 12 months after birth. (4 marks)
Interpret evidence
4 Information about the levels of IgA has been deleted from the graph until 2 months after the birth. Predict when IgA would first be detectable in the infant, giving reasons to support your response. (4 marks)
To control or prevent disease, the causative agent for the disease must first be identified. Identification of disease is achieved through epidemiological studies. The method used to identify the pathogen causing an infectious disease varies according to the organic particles or organisms causing it. Monitoring a disease at the local, national and global levels is important in determining vector control measures, predicting the spread of the disease and establishing vaccination programs. Various means are available to control disease within a community. Quarantine and border control are significant in preventing the entry and spread of disease within and between countries. Personal hygiene and contact tracing are also important control measures. Treatment of disease is mainly by chemical means, with most active ingredients derived from plants or animals (natural or synthesised). Antibiotics are produced by various species of fungi and bacteria, and are effective against bacterial infections only. Misuse of antibiotics has resulted in some strains of bacteria becoming resistant to them.
Check your understanding of concepts related to epidemiology before you start.
→ Interpret data from an experiment investigating the effect of an antimicrobial agent on the growth of a microorganism.
→ Describe modes of disease transmission, including direct contact, contact with body fluids, contaminated food, contaminated water and disease-specific vectors.
→ Explain how the following factors affect the spread of disease – persistence of pathogens within host – transmission mechanism – proportion of the population that are immune or have been immunised – mobility of individuals in the affected population.


→ Explain how personal hygiene measures, contact tracing and quarantine are used to control the spread of disease.
→ Analyse data to – predict outbreaks – determine the source of an outbreak – infer the mode of disease transmission – determine the effectiveness of different strategies in controlling the spread of disease.
→ Appreciate that – for thousands of years, First Nations peoples’ knowledges of natural antiseptics and bush medicines have been used to prevent and treat infections – scientific advancement and the development of complex models often requires contribution from multiple individuals across a range of disciplines – Australia has an advantage over many other countries because its borders are easier to protect against the influx of disease-carrying materials and organisms. However, as global trade and air travel become more prevalent, it is increasingly important for Australia to protect its agriculture industry and environment through quarantine measures. These include surveillance, monitoring, examination and clearance activities and conform to policies and protocols that are based on scientific data and risk analysis – mass vaccination programs are more successful when informed by disease outbreak models
→ Investigate
– the effect of an antimicrobial agent on the growth of a microorganism (via the measurement of zones of inhibition) in either a laboratory or virtual context – how the transmission of disease is facilitated by regional and global movement – the effectiveness of health programs for the prevention and eradication of infectious diseases, e.g. smallpox, influenza, polio, smallpox, Ebola, cholera, malaria.
→ Explore – how First Nations peoples’ knowledges of natural antiseptics and bush medicines are used to prevent and treat infections
Source: Biology 2025 v1.0 General Senior Syllabus © State of Queensland (QCAA) 2025

These lessons are available exclusively on Oxford Digital.
Lesson 13.3 The effect of an antimicrobial agent on the growth of a microbial organism
→ Epidemiology is the scientific study of factors that determine and influence the frequency and distribution of disease, injury and other health-related events.
→ The transmission of disease can occur through direct or indirect contact with the source of infection.
→ Direct contact includes the transmission of a pathogen through physical touch, contact with infected body fluids and the spread of airborne droplets.
→ Indirect contact includes the transmission of a pathogen through consuming contaminated food or contaminated water, and by infection via a vector.
→ The spread of disease is also influenced by factors such as the persistence of the pathogen within the host, the transmission mechanism, the proportion of the population who are immune or have been immunised, and the mobility of individuals in the affected population.
Epidemiology is the scientific study of the factors that determine and influence the frequency and distribution of disease, injury and other health-related events in a defined human population. The purpose of epidemiology is to establish programs to prevent and control the development and spread of these health-related events. Epidemiology can be used to evaluate health services and preventative programs or to identify individuals who are at high risk of contracting disease. In this lesson you will look at modes of disease transmission and factors that affect the spread of disease.

Learning intentions and success criteria
epidemiology the study and analysis of the distribution (who, when, where) and determinants of health and disease conditions in defined populations
pathogen a biological agent that causes disease or illness direct contact spread of infectious disease through physically touching, exchanging bodily fluids with, or inhaling droplets from, an infected individual
droplet spread the movement of small amounts of fluid (e.g. saliva) containing a pathogen being spread to another individual through coughing, sneezing or talking
There is more than one mode of transmission of pathogens between individuals. Diseasecausing pathogens can be spread directly or indirectly from the infection source to healthy individuals.
Direct contact is the transmission of a pathogen that occurs when an infected person comes into close contact with another susceptible person, allowing the pathogen to transfer. Direct contact can occur through:
• physical touch – for example, shaking hands, hugging, kissing, sexual intercourse
• contact with infected body fluids – such as blood, saliva, faeces, sweat, tears, breast milk, semen, vaginal fluids
• droplet spread
An example of transmission through direct contact is cold sores, which are caused by herpes simplex virus 1 (HSV-1). Cold sores can spread from an infected person to another person through physical contact with a cold sore blister or through the exchange of saliva containing the virus. Kissing is a common means of transferring the HSV-1 virus between individuals. It is estimated that 67% of the world’s population are affected by HSV-1. Other pathogens can be passed from mother to child via the placenta or the vaginal canal during birth. Pathogens such as the influenza virus can pass directly from an infected person into small water droplets in the air, which can then be inhaled by an uninfected person if they are in close proximity.
indirect contact a means by which infectious disease can spread without direct contact with the infected person, e.g. airborne droplets, contaminated objects, soil, food or water, or by animal or vector transmission
Infections can also be spread through indirect contact , where the pathogen can be spread to a healthy individual without them coming into direct contact with an infected person. Many pathogens can survive in air, soil and other substrates for long periods and may cause disease once transferred to a healthy individual. Forms of indirect transmission of disease include:
• consuming contaminated water
• consuming contaminated food
• disease-specific vectors.

Water contaminated with bacteria (e.g. Vibrio cholerae , which causes cholera) can infect anyone who drinks that water. Many diseases are spread by water, through consumption of contaminated water or via a vector. In Australia, clean drinking water is often taken for granted. All major towns and cities have strict treatment and quality control of household water supplies. This is not the case in many parts of the world, particularly in developing countries, where people may need to rely on local streams or wells for water. Contamination of these waters by human and domestic animal wastes frequently occurs. Moving water can swiftly transport microorganisms over large distances. Even in places where there is sterilised, reticulated (piped) water, defects in pipes, flooding and other factors can result in contamination of water supplies.
Cholera, an intestinal disease common in tropical Africa and Asia, is caused by a bacterium that enters a person’s body in drinking water or in contaminated food. The bacterium produces toxins that cause diarrhoea and vomiting. Even after all food contents have been voided from the person’s body, there is constant elimination of digestive juices. The fluid to produce these juices is withdrawn from other body tissues. Death is a result of dehydration and loss of potassium. In many places where cholera is endemic, human faeces are collected and used as manure for growing vegetables. Bacteria from an infected person are rapidly transferred via the vegetables to other people. Flies that move between the house and garden can transfer bacteria from plants to food. In other areas, toilets are built over the banks of streams or rivers and the flowing water carries the wastes away. The cholera bacteria reproduce in these warm waters, and water used downstream for drinking or watering vegetables can be contaminated, resulting in further infections.

Like water, food that is contaminated with a pathogen may cause disease in anyone who consumes the food. Food poisoning often occurs because food is kept too long or stored incorrectly, allowing pathogenic species to grow. Some decomposing bacteria in food may release toxins, which then affect the person who eats the spoilt food. Some pathogens can be passed from animal to person when the person handles faeces from the animal, if some faeces are transferred to the person’s hands and then to food during food preparation. Contagious diseases can be unwittingly transferred from people preparing food, as they can be carriers of disease without displaying any symptoms. Strict laws govern the cleanliness of commercial food preparation areas. All people working in the industry must wear special protective clothing and disposable gloves.


transmit diseases to other organisms.
Other diseases are spread through specific vectors. For example, Aedes aegypti mosquitoes carry Dengue virus, while Anopheles mosquitoes carry the Plasmodium that causes malaria. Occasionally, pathogens that are normally only transmitted from animal to animal are transferred to humans – this is termed zoonosis Some zoonotic pathogens are spread by vector s, especially those that consume blood. These types of vectors can play a major role in passing pathogens from one host to another.
The spread of disease (through direct or indirect contact) is also influenced by factors including the following:
• persistence of the pathogen within the host
• transmission mechanism
zoonosis an infectious disease that is transmitted from animals to humans pathogen persistence a pathogen’s ability to survive within a host organism after infection
• proportion of the population who are immune or have been immunised
• mobility of individuals in the affected population.
Pathogen persistence describes the length of time and the conditions in which a pathogen can survive within a host. Pathogens with high pathogen persistence can survive for an extended time. This gives the pathogen more time to infect new cells within the host and increases the period during which an infected individual may transmit the pathogen to others. For example, once a person becomes infected with human immunodeficiency virus (HIV), they are infected for life. This means they are at risk of transmitting the disease to others through contact of infected body fluid. Fortunately, treatments such as antiretroviral therapy (ART) are available to HIV-affected individuals and are effective in preventing the spread of HIV.
Pathogens with low pathogen persistence are unable to survive for long within a host. To survive, these pathogens must infect individuals rapidly. For example, norovirus infection is typically cleared from a host within three days. Despite its low persistence, norovirus brings on symptoms (vomiting and diarrhoea) quickly and is highly contagious. It can also survive in the environment and on surfaces for longer periods of time, allowing it to be transmitted through indirect contact.
Specific transmission mechanisms affect the rate at which disease spreads. Diseases that spread through direct contact tend to

spread more slowly unless there is regular direct contact, of the specific type required, between infected and non-infected individuals. For example, genital herpes (HSV-2) is spread through skin-to-skin contact with an affected genital area (usually through sexual contact). The specific type of contact required for HSV-2 transmission limits its spread in a population.
Airborne pathogens tend to spread more easily, especially in crowded or dense areas. For example, diseases such as COVID-19, influenza and the common cold can survive in the air in droplets from infected people, and will often spread rapidly in a population. The rate of spread of a disease that is transmitted by vectors will vary depending on the vector population and how likely it is that the vector will infect hosts. For example, in Nigeria there are large populations of Anopheles mosquitoes, which are the vector for malaria. Nigeria has the highest incidence of malaria cases in the world. Because Australia is free of Anopheles mosquitoes, it is also free of endemic malaria.

7 Airborne pathogens tend to spread more easily, particularly in dense or crowded areas.
The spread of a disease is also influenced by the proportion of people in the population who are immune to the disease or have been immunised. There are always a few people in a population who are especially vulnerable to an infectious disease. These include individuals who are immunosuppressed (e.g. people with AIDS or transplanted tissue), very young children, the elderly, individuals who are unable to be vaccinated due to allergies, and individuals at high risk of severe complications if they become infected. These individuals must rely on the immunity of others around them to protect them from the disease. The greater the proportion of people in a population who are immune or immunised against a disease, the less likely it is that the disease will spread.
Herd immunity can help prevent the spread of disease. Herd immunity exists when a large enough percentage of the population is immune to an infection that the disease is limited in its ability to spread in that population. Herd immunity can be achieved through vaccination (Lesson 12.6). For example, most people in Australia receive the measles, mumps and rubella (MMR) vaccine by the age of two. This high rate of immunisation reduces the spread of measles in Australian populations, even among those who are unvaccinated. Depending on the type of disease, different rates of vaccination in the population are needed to achieve herd immunity. For example, to prevent the spread of smallpox, a vaccination rate of 80% would be effective. To prevent the spread of measles, 95% of the population needs to be vaccinated, because measles is more contagious than smallpox.
herd immunity a form of indirect protection from infectious disease that occurs when a large percentage of a population is immune to an infection, thereby providing a measure of protection for individuals who are not immune
= not immunised but still healthy
= immunised and healthy
= not immunised, sick and contagious
mobility the movement of people within and between populations
No one is immunised.
Influenza (flu) spreads through the population.
Some of the population gets immunised.
Influenza (flu) spreads through some of the population.
Most of the population gets immunised.
Spread of influenza is contained.
Mobility describes how frequently and far an individual will travel within and between different populations. The more mobile individuals are, the more likely they are to contract a disease or transmit a disease to their own or another population.
Patterns of human travel and trade of goods have changed dramatically over the last century. It was once unusual for people to move beyond their local area. There were, however, some significant trade routes (e.g. the Silk Road, and shipping between China and Europe in the fourteenth century). Diseases such as the plague were widely spread as a result of these trade movements.
Regional travel within and between areas of a country is now common for recreation and work. Tourists can return to their home countries and inadvertently bring back pathogens picked up from overseas. Large numbers of people travel overseas on business. Huge volumes of goods are transported between countries in large shipping containers, inadvertently carrying new vectors for disease.




FIGURE 9 The fourteenth century land and sea routes that resulted in the spread of the plague from China to Europe.
Air travel can play an important role in global outbreaks. For example, during the COVID-19 pandemic, COVID-19 was first localised to the Wuhan area of China. Once it spread rapidly through this population, individuals carrying COVID-19 travelled to other parts of world, spreading the disease globally.
The less mobile individuals are, the less likely they are to contract and spread disease. Quarantine involves the isolation and travel restriction of individuals who may have encountered or been infected by a disease. Quarantine measures help to reduce mobility, in order to limit the spread of disease in populations. You will learn more about quarantine in Lesson 13.2.
Check your learning 13.1
Check your learning 13.1: Complete these questions online or in your workbook.
Retrieval and comprehension
1 Define the term ‘epidemiology’. (1 mark)
2 Describe the modes of disease transmission. (6 marks)
3 Over the past 100 years, the spread of infectious diseases has increased dramatically and globally. Explain how mobility of vectors and infected individuals has contributed to this spread. (3 marks)
quarantine strict isolation of an individual, imposed to prevent the spread of disease
4 E xplain how pathogen persistence can affect the spread of disease. (4 marks)
5 E xplain the concept of herd immunity and how it affects the spread of disease. (4 marks)
6 E xplain how a pathogen having multiple transmission mechanisms can affect the spread of disease. Use an example in your response. (4 marks)
processes
7 D istinguish between direct and indirect contact. (2 marks)
8 Determine the mode of transmission in the examples below.
a A person contracts chickenpox after shaking hands with an infected individual. (1 mark)
b A person contracts salmonella after
consuming chicken that was not cooked to the correct temperature. (1 mark)
c A person contracts malaria after being bitten by a mosquito carrying Plasmodium. (1 mark)
d A person contracts Epstein-Barr virus (EBV) after kissing and exchanging saliva with an infected individual. (1 mark)
e A person contracts cholera after drinking water collected from a stagnant pool. (1 mark)
→ Measures to control the spread of disease include personal hygiene measures, contact tracing and quarantine.
→ Good personal hygiene and rigid hygiene standards at food preparation outlets are significant deterrents to the spread of infectious disease.
→ Contact tracing involves identifying and providing advice to individuals infected with a disease and the contacts they may have spread the disease to.
→ Quarantine is the isolation of individuals infected with a disease; it can occur at a local, national or international level.
→ Treatments that may be administered to treat disease include plant-derived chemicals, antibiotics and chemicals produced by other organisms.
Learning intentions and success criteria
The spread of disease can be minimised by implementing prevention and control measures. Some examples of control measures are:
• personal hygiene measures
• contact tracing
• quarantine
• public health programs.
Personal hygiene is important in reducing the risk of contracting pathogens. People continually touch objects that have been previously touched by others or may harbour pathogens, such as doors and seats of public toilets, money, pets and taps. All have the
potential to transfer pathogenic organisms. Examples of personal hygiene measures to limit the spread of disease are summarised in Table 1.
TABLE 1 Examples of personal hygiene measures and how they help reduce the spread of disease.
Sneezing into elbow instead of hands Limits droplets containing bacteria or viruses from being spread to others through the air or on hands.
Wearing a face mask when sick with a virus or during cold and flu season
Regular washing of hands with soap and water after using the toilet and before eating
Correctly storing food and disposing of food that has gone bad
Cooking meat to the correct temperature
Food safety laws, including wearing special protective clothing and disposable gloves
Keeping kitchens and food preparation areas free from vermin or infestation
Limits the spread of pathogens transferring into the air. Protects individuals from inhaling airborne pathogens.
Many microorganisms stick to small droplets of oils released by skin glands. Water alone will not remove these. Soap affects surface tension so the area of contact between oil and skin is reduced and the oil and microorganisms can be washed away.
Both contagious and non-contagious diseases can result from contaminated food. Some decomposing bacteria in food release toxins, which then affect the person eating the spoilt food.
Heat generated in the cooking process can kill the larvae of tapeworms, flatworm parasites and other pathogens that can be passed on to humans from meats.
Prevents the spread of pathogens from the surface of skin to food consumed.
Vermin such as cockroaches, flies and rats can be disease vectors. Keeping homes/kitchens free of these can prevent the spread of disease.



1 Personal hygiene measures to help reduce the spread of disease include (A) washing your hands with soap, (B) sneezing into your elbow instead of your hands and (C) keeping food preparation areas clean.
contact tracing a process that identifies people who have been exposed to an infected person
Contact tracing is a public health strategy that involves identifying people who have come into contact with a person who is known to be infected by a disease. If a disease outbreak occurs, health officials attempt to trace all contacts of the original infected person. By identifying who is at risk of spreading an infectious disease and the areas they have travelled to, health officials can implement other restrictions to prevent further spread as well as predict where further infections may occur.
Confirmed case is identified by public health department. The person is recommended to self-isolate and they are questioned about contacts.
Contacts who show symptoms or test positive self-isolate and reach out to contacts.
Contact tracers reach out to contacts.
Contacts monitor for symptoms and isolate if required.
Contacts showing no symptoms test for disease and monitor for symptoms.
The contact is cleared once they test negative.
FIGURE 2 Contact tracing helps track down potential future infections and prevent the spread of disease.
For example, in 2017 there was a small outbreak of measles that affected eleven people. Eight of these people were linked to a particular building in Melbourne, where they had come into contact with the original infected person. All these people were quarantined to prevent the spread of the disease. Contact tracing was also used to manage the spread of the COVID-19 virus in Australia. Individuals who had come into contact with people infected with COVID-19 were traced and monitored.
The word “quarantine” is derived from a phrase meaning 40 days. It relates to the idea that 40 days is adequate time for a disease to pass and treatment to be completed. The 40 days is no longer strictly adhered to and varies from disease to disease. Quarantine can be applied locally, nationally or internationally.
At a local level, individuals who have a contagious disease should ideally be isolated from other people. Many bacteria and viruses pass from person to person in airborne droplets of water. Isolation reduces the chance of this occurring by minimising the number of people with whom the infected person comes in contact. The period of isolation depends on the
incubation period of the pathogen as well as the length of time of infection. For example, a person infected with chickenpox must be kept isolated until all skin lesions have dried. For serious contagious diseases (e.g. Ebola), patients are kept in special hospital isolation wards. Only hospital staff can attend the patient, usually in special biohazard clothing, and they undergo a sterilisation treatment when they leave the ward to prevent spread of the pathogen.

For serious outbreaks within a community, further action is taken. Schools, aged care facilities and public places may be closed. Often, there is a period between contraction of a pathogen and symptoms of disease appearing. This means an apparently healthy person could be contagious. Preventing large assemblies of people can help minimise the spread of the disease.
Quarantine is important at both state and federal levels in Australia. To prevent the spread of exotic plants and animals, and the pathogens they may carry, there are sometimes limitations on what may pass between states or regions within a state. For example, only livestock that have recently been sprayed to destroy ticks can pass from Queensland into New South Wales or from coastal areas of Queensland into western, tick-free areas.
All sites of international entry – ports, airports and mail exchanges – are also controlled. Aeroplanes are sprayed with insecticide on arrival. Clearance of passengers, cargo and other effects by quarantine officers is of major importance. Many airports use thermal cameras to screen arriving passengers for fever. Animals imported into Australia, including insects, fish, birds and mammals, and even semen for artificial insemination, are placed into special quarantine stations for a specified time to ensure they are not carrying disease. All plants or their parts (e.g. fruit, seeds, honey) must pass quarantine inspection, and possibly treatment and a period in isolation, as do objects made from plant material.
4 Tick areas in South East Queensland. Stock not sprayed prior to transport will be sprayed at the areas labelled with a star (e.g. Helidon) before they can enter a tick-free zone.
The cabins of passenger planes arriving in Australia from certain regions of the world are sprayed before people can disembark, to kill any aerial pathogens. Passengers travelling from certain countries or at certain times are also given special consideration. For example, during the mad cow epidemic in the United Kingdom (in the 1980s and 1990s), all passengers had to declare whether they had been to a farm; if they had, their footwear was sterilised. Similarly, passengers from certain parts of Africa must have all shoes and boots sterilised. If coming from areas where a disease is rife (e.g. yellow fever in Tanzania), the passenger must have a current vaccination card for that disease, otherwise they are placed in quarantine. People are checked if they show fever symptoms, particularly if they are coming from an area with a virulent influenza epidemic.
Biosecurity stations have been set up along Australia’s northern regions, where a variety of animals (e.g. horses, cattle, pigs, poultry and insects) are kept. Regular blood tests are performed on these ‘sentinel’ animals to monitor diseases that may have come from SouthEast Asia or the Pacific region via migrating animals. A range of other procedures, such as management of ballast water (which may contain disease-causing pathogens or pests) released from international ships, also exist.
Although Australia’s border controls have been effective in preventing the spread of diseases and pests, they are not infallible. Not all entry into Australia can be controlled along its thousands of miles of coastland. Many pathogens are carried by birds and flying foxes that migrate between Asia and Australia. Sailing boats moving between the Pacific islands and Australia often pull into small coastal towns. This means they might avoid surveillance and, as a result, biosecurity checks.
Coastal regions from the New South Wales border north to Broome in Western Australia are tick infested. Movement of stock from Queensland into New South Wales or west of the Great Dividing Range is controlled and can occur only if the stock have been sprayed to kill any ticks they may be harbouring. Propose two reasons for this control.
Public health programs are very important in disseminating information and implementing control measures. Vaccination is another measure to prevent the contraction and spread of disease. Programs that encourage all children to be vaccinated before starting childcare or school improve herd immunity. Needle-exchange centres for drug users have helped prevent the spread of HIV or hepatitis through people sharing needles. The spread of insect-borne disease is reduced by programs that advise of breeding sites for vectors.

Eradicating disease
Smallpox was a contagious infectious disease caused by the smallpox virus. It was a serious disease that caused symptoms such as fever, sores on the skin and in the mouth, and fatigue. It caused millions of deaths before its eradication in 1980. In 1967, the World Heath Organization set out to eradicate smallpox through an intense public health campaign, including widespread immunisation using the smallpox vaccine. The last case of smallpox was in 1977 in Somalia. The smallpox campaign still stands as a profound success story of the effectiveness of public health campaigns.
Apply your understanding
1 Determine the factors that led to the prevention and eventual eradication of smallpox. (5 marks)
public health program a program undertaken by organisations to prevent disease, prolong life and promote human health through informed choices vaccination injection of a killed or weakened microbe, or parts of a microbe, in order to stimulate the immune system against the microbe, thereby preventing disease

Animals have long been known to use natural remedies to alleviate ill health. Examples are domestic cats eating grass, and birds and primates deliberately ingesting kaolin clay to cure intestinal upsets. Early humans also developed knowledge and understanding of the curative aspects of particular plants. Even today, approximately 60% of the world’s population does not have regular access to pharmaceutically produced medicines. Instead they may need to rely on plants for preventing and treating illness. In South America, for example, 1300 plant species are used for medicinal purposes. The number of plant species used in healing in other parts of the world is staggering – in India 2500 species, in South-East Asia approximately 6500 species, and in China 5000 species. Chinese herbalists can be found in most cities throughout the world. Many plants in Australia have also been used by First Nations peoples as medicinal treatment. In recent times, there has been a resurgence in investigating native Australian plants for possible drug applications, particularly those with antimicrobial properties.
antimicrobial describes a substance that kills or inhibits the growth of microorganisms, such as bacteria chemotherapy the treatment of disease using chemicals that have a specific toxic effect on disease-producing microorganisms (e.g. antibiotics) or that selectively destroy cancerous tissue
Although the term chemotherapy is now applied to the injection of specific chemicals to prevent cell division, and therefore cancer growth, it is more generally defined as the use of chemicals to prevent and cure diseases and disorders. Many of these chemicals have been isolated from living organisms. Once the active components have been identified, they can often then be synthesised in the laboratory. Others, such as sulphonamides, are purely synthetic. Sulphonamides were widely used in the mid to late 1900s to treat urinary and bowel infections and pneumonia.
Plant chemicals with healing properties are known as secondary plant products, because they are not involved in creating carbohydrates, proteins or lipids. These secondary products are actively made by the plant, and at least some are thought to be adaptations to protect the plant. They act by mimicking existing chemicals that inhibit or stimulate natural processes, or by producing an antibiotic or antiseptic to protect the plant from infection.
Studies of particular plants, isolation of their active ingredients and rigorous testing have resulted in the development of approximately 40% of all prescription drugs. The identification and isolation of active ingredients from plants has allowed the production of synthetic drugs. However, not all plant chemicals can be synthesised. For example, digitalis, a heart stimulant that slows down and strengthens the heartbeat and has saved millions of lives, is still produced from dried foxglove (Digitalis purpurea) leaves. After the Second World War, the anti-malarial

FIGURE 8 The term “chemotherapy” is most commonly used to describe a treatment administered to cancer patients; however, it also refers to the use of chemicals to prevent and cure other diseases or disorders.
drug quinine, produced from the bark of the Cinchona tree, was replaced by synthetic products. In recent years, however, malarial parasites have shown increasing resistance to these drugs. Quinine has had a revival as the only effective drug against certain Plasmodium strains. Less than 10% of the active higher plant chemicals used in prescriptions are commercially prepared by synthesising them. This is either because scientists have not yet found a way to synthesise them or because they can be more economically produced by growing the plants.

9 Foxglove (Digitalis purpurea).Real-world biology

For tens of thousands of years, First Nations peoples have used traditional methods of treating disease, passing their knowledge on through the generations. Many of these treatments were sourced from Australian flora, and so are termed “bush medicines”. They contain antibacterial and antiinflammatory properties that could be used to prevent and treat infections. Examples of bush medicines are tea-tree oil from Melaleuca trees, which is a strong antiseptic that can be used to treat many fungal infections, and Kakadu plums, which are a rich source of vitamin C and can be used for a variety of health benefits, from boosting immunity to lowering blood pressure. Eucalyptus leaves, used to create antiseptic tonics for treating a variety of illnesses, are used in smoking ceremonies, a highly significant ritual of some First Nations peoples, as a means of cleansing the people present and the surrounding area of the ceremony and to encourage good health. Recent clinical studies have shown that compounds from Eucalyptus plants have the potential to treat and prevent a wide range of diseases, including as an antimicrobial against bacterial infections and as pain relief for muscle and joint injuries.
Apply your understanding
1 Explain how knowledge of traditional medicines, such as First Nations bush medicine, can be used to inform modern medical practices.
Plants are not the only organisms that can have therapeutic effects. Many modern antibiotics are produced naturally by various species of bacteria or fungi, or they can be artificially synthesised from their natural products. Antibiotics are chemicals that interfere with either the metabolism or the structure of bacterial cells. Some ways in which antibiotics destroy bacteria are by interfering with:
• cell wall structure (e.g. penicillin)
• cell membranes (e.g. amphotericin)

• synthesis of proteins (e.g. streptomycin and tetracycline)
• synthesis of nucleic acids (e.g. rifampicin).
It is probable that production of these chemicals is a defence mechanism of one species to prevent competition for resources. Antibiotics have selective toxicity – they act only on bacteria other than the one producing it. Some antibiotics are broad spectrum, acting on a range of bacteria (e.g. tetracycline), while others are specific to a particular type. This difference has been used in the commercial production of antibiotics.
The antibiotics streptomycin and aureomycin are produced by bacteria. Several antibiotics are produced from fungi. Penicillin (used to combat many Gram-positive bacteria and staphylococcal infections) is produced from several species of Penicillium , notably P. notatum.
Since the discovery of penicillin in 1929, much research has been conducted into the production of antibiotics by bacteria and fungi, and into their purification and ability to act on specific pathogenic bacteria.
Now there is an antibiotic treatment for most diseases caused by bacteria. The success of these treatments over the past century has been responsible for a massive decrease in many potentially lethal infections, such as tuberculosis.
• uptake of resistant genes during transformation antibiotic resistance the ability of bacteria to resist the effects of an antibiotic to which they were previously sensitive
This success in producing antibiotics has led to a major problem – antibiotic-resistant strains of bacteria have developed. Bacteria are able to evolve resistance because they have:
• an extremely large population size
• a short generation time
• an unusually flexible genetic system.
Bacteria have a single, circular chromosome composed of DNA, and spontaneous changes (mutations) can occur in sections of this DNA (i.e. in genes). A change can be neutral (have no effect), harmful to survival, or beneficial (e.g. resistance to an antibiotic). Because bacteria can divide rapidly in a favourable environment, any beneficial mutation can spread within a population very quickly. Although bacteria do not reproduce sexually, they have three mechanisms for transferring genes from one individual to another.
Some bacteria can take up segments of naked DNA from their environment (e.g. DNA released when the cell wall/membrane from another bacterium or organism has been destroyed) and incorporate it into their chromosome. In this way, the bacterial DNA is transformed . If a bacterium is infected with a non-lethal virus, some of the bacterial DNA can be incorporated into the viral particles it produces. If these viruses infect a new bacterium, the host can pick up and incorporate the transported bacterial DNA into its chromosome in the process of transduction . Conjugation is a process whereby genes can be transferred between two bacterial cells that are temporarily joined by extensions of their membranes, called pili. In addition to the main chromosome, bacteria have other small circular DNA molecules, called plasmids. Plasmids replicate separately from the bacterial chromosome and are important in conjugation transfer. One group of plasmids (R-plasmids) carry genes for antibiotic-destroying enzymes. These can be passed to non-resistant individuals of the same or a different species of bacteria.
Bacteria can therefore become resistant to one or more antibiotics by:
• mutations that are passed from generation to generation
• transfer of resistant bacterial genes by viruses in transduction
• exchange of genes during conjugation
• movement of R-plasmids between bacteria.
This resistance has not developed as a cumulative tolerance of the bacteria to the drug, but as a chance mutation. For example, some bacteria in a population have an enzyme capable of breaking down a drug (e.g. penicillin). In the presence of penicillin, non-resistant forms are destroyed, and resistant forms survive. The greater the quantity and frequency of penicillin use, the higher the proportion of resistant forms left in the population. Because the resistant gene can be transferred between different species, a pathogen can be resistant to the antibiotic even before the antibiotic is used against it.
Taking antibiotics for a non-bacterial infection or as a precaution increases the likelihood that antibiotic-resistant forms will develop. Similarly, if an incomplete course of prescribed antibiotics is taken, not all the invading bacteria will be killed. Because they will continue to reproduce, there is a good chance that a random mutation will occur that will confer resistance to the drug.
Some bacteria are drug resistant.
Normal bacterium Antibiotics kill the non-resistant bacteria. Some good bacteria that protect the body are also killed by the antibiotics.
The drug-resistant bacteria can continue to grow and take over.
Some bacteria give their drug resistance to other bacteria.
Other chemicals produced by fungi can be used to treat other pathogens. Griseofulvin, produced by Penicillium griseofulvum, has antifungal properties; fumagillin, produced by Aspergillus fumigatus, is frequently used against amoebic dysentery.
Although some antiviral drugs disrupt a virus’s ability to adhere to or leave a host cell, most treatment of viral infections relies on boosting the individual’s immune system through rest and taking vitamin C and zinc.
Although only a small fraction of marine organisms has been examined, many valuable chemicals have been found in them. A sea squirt, for example, produces a substance that is active against a broad range of viruses responsible for such diseases as colds, influenza, herpes and meningitis. Serum from horseshoe crabs can isolate tumour cells from the blood of cancer victims. Shark livers contain lipids thought to increase human resistance to cancer. Over 500 marine organisms have been found to produce chemicals that have the potential to combat cancer.
Terrestrial animals have provided fewer chemicals to medicine. Bee venom is used to treat arthritis, and captopril, produced from the venom of a Brazilian snake, aids in controlling hypertension.

FIGURE 13 Bee venom can be used to ease the pain of arthritis.
Check your learning 13.2: Complete these questions online or in your workbook.
Retrieval and comprehension
1 Identify three personal hygiene measures and explain how they can prevent the spread of disease. (6 marks)
2 E xplain why it is important to wash your hands with soap and water rather than just water. (2 marks)
3 E xplain how quarantine is used to control the spread of disease, using an example. (3 marks)
4 E xplain how contact tracing is used to control the spread of disease. (3 marks)
5 Identify three plants that produce chemicals that are of medicinal value to humans. (3 marks)
6 Describe the ways in which plant and animal chemicals (active ingredients) can act on human pathogens. (2 marks)
7 E xplain the function of antibiotics and why they are not prescribed for viral infections. (2 marks)
8 E xplain the term ‘antibiotic resistance’. (2 marks)
9 Despite stringent federal quarantine control, some diseases still enter Australia from overseas. Describe how this could occur (2 marks).
Learning intentions and success criteria
This lesson is available exclusively on Oxford Digital. Go to page XX.
→ Certain diseases must be reported to state and federal authorities. Other diseases are notifiable to the World Health Organization to reduce pandemic outbreaks.
→ Mathematical models developed from surveillance data can predict the likely outcomes of disease outbreak.
→ Viruses are non-living particles that can only be cultivated in living cells.
→ Bacteria and pathogenic fungi are living cells and can be cultivated on a nutrient agar medium in a Petri dish under sterile conditions.
→ Different groups of bacteria can be distinguished using growth inhibition by specific antibiotics and staining techniques (Gram stain or fast-acid stain). Identification to species level is achieved by DNA analysis.
Governments and scientists concerned about the global spread of diseases first met at the International Sanitary Conference in 1851. Over the next 70 years, the participants developed programs to deal with pandemics of cholera, yellow fever and bubonic plague. After the Second World War, this group of governments and people expanded and became the World Health Organization.
World Health Organization data shows that, in 2015, 26.6% of 56.4 million deaths worldwide were attributed to heart disease and stroke. These diseases have remained the leading cause of death globally since 2000 regardless of socio-economic status, although the death rate due to stroke is lower in high-income economies, probably as a result of better medical facilities. Non-infectious diseases cause 70% of deaths globally. It is therefore crucial that the causes of these diseases be identified, so treatments or preventative measures can be developed.
In the past, many connections were made between a disease and its possible cause, but the evidence was not scientific. In the nineteenth century, for example, people embarking on long sea voyages often suffered from scurvy. It was found that a daily intake of lime juice (high in vitamin C) reduced this illness.


random sample sample of individuals from a larger population chosen in a way where everyone is equally likely to be selected
Now, studies involving the collection and careful statistical analysis of data assist the causal identification of diseases.
Epidemiological studies include how common the disease is (the number of people affected), what proportion of the population is affected, how many people in the population died as a result of the disease, and what other factors might have affected their chances of survival (e.g. age, gender, race, diet, geographic location, lifestyle, and family history of the disease).
In any study, conclusions regarding risk cannot be drawn from purely clinical data (i.e. the number of sick people seen) but must relate to all members of a population. In most cases, it is impractical to try to study the entire population, so a large random sample of the population is used. This allows comparisons to be made – for example, the incidence of lung cancer in people who smoke cigarettes versus non-smokers, or the rate of mesothelioma in people with or without exposure to asbestos.
In this lesson, you will learn how data analysed from epidemiological studies can help:
• predict outbreaks
• determine the source of an outbreak
• infer the mode of disease transmission
• determine the effectiveness of different strategies in controlling the spread of disease.
Predicting outbreaks involves epidemiologists using data to estimate the locations and times in which disease may occur. The types of data used to help predict outbreaks can vary.

Environmental data on factors such as temperature, rainfall and humidity can be used to make predictions about pathogen or vector populations known to be affected by these environmental factors. For example, weather patterns can be used to predict mosquito populations. In countries affected by mosquito vectors, this can be used to predict outbreaks of diseases such as malaria, yellow fever and Dengue. Historical data can also be analysed to look for patterns in disease transmission. For example, historical data on the spread of influenza in Australia shows that transmission of influenza is highest between May and September. This information can be used not only to predict an outbreak of influenza, but also to help prevent transmission. For example,
governments may encourage workplaces to offer annual flu vaccines at the start of May, to limit contraction and spread of the disease.
Population data such as population density, immunisation rates and data on the mobility of individuals can also be used to predict the likelihood of a specific disease outbreak. For example, during the COVID-19 pandemic, cities with highly dense populations, such as New York, were predicted to have high transmission rates of the virus.

Most models for predicting the spread of an infectious disease are mathematical in nature. Two measures used in analysing disease are:
• mortality rate – the rate of death per population size. This is usually represented as a proportion (e.g. per 1,000,000 individuals).
• case fatality ratio – the number of deaths among those who have contracted the disease. This is usually expressed as a percentage.
For example, in a population of 3.5 million, if 70 of the 210 reported cases died of a particular infectious disease: mortality rate = 70 × 1000 000 3500 000 = 20per million and case fatality ratio = 70 × 100 210 = 33.3%
Because case fatality ratios do not depend upon actual population size, health organisations can make some predictions about the severity of an outbreak. By comparing these figures across country groups, they can be used to predict the spread of disease outbreaks to other countries, and whether to impose travel restriction advice to particular countries.
The SIR model is a basic model used to analyse the spread of disease. It uses an advanced mathematical formula that examines:
• the proportion of a population that is susceptible to a particular infection (S),
• how many of these people go on to become infectious ( I ), and
• the proportion of these who then recover ( R), and in what time frame.
This model assumes that the population being investigated does not change (i.e. births, deaths, immigration and emigration are not considered) and that a single infected person introduces the disease into the population, and that there is no incubation period.
With the advent of complex computer programming and its massive processing power, this basic model can now generate models that also consider such factors as weather, human travel, trade patterns and warfare.
mortality rate the ratio of deaths in an area to the population of that area; expressed per 1000 per year
case fatality ratio the proportion of deaths within a designated population of “cases” (people with the disease) over the course of the disease
SIR model a method that models or tracks the numbers of susceptible, infected and recovered individuals during an epidemic

One of the important features of the SIR model is that it can be used to predict the level of vaccination needed to protect a population. The SIR model also makes it possible to predict the spread of an infectious disease in a totally susceptible population (i.e. no one is vaccinated against the pathogen). R0 is a measure of the number of people who become infected by a single person with the disease. This varies depending on the disease and the mode of transmission. Malaria, for example, is transmitted by mosquitoes, and one mosquito can transfer the pathogen from one infected person to a large number of people in a short time. AIDS, which is transferred from person to person only in body fluids, has a lower transmission rate among a particular contact group of individuals.
For a disease with an R0 of 2 (e.g. hepatitis C and Ebola), each infected person is likely to infect two other people, whereas one person with mumps (R0 of 10) will infect 10 other people.
The proportion of the population that needs to be vaccinated to prevent the spread of the pathogen can be worked out using the formula: VT = 1 1
0 where VT is the proportion of the population that needs to be vaccinated.
TABLE 1 The value of R0 for some common diseases.
AIDS 2 to 5 Smallpox 3 to 5
Measles 16 to 18
Malaria > 100 Skill drill
Using models to predict disease
An emerging disease has caused 32 deaths out of 100 reported cases in a population of 100,000 people. Epidemiologists have determined that the disease has an R0 of 6.
1 Calculate the mortality rate per million people. (1 mark)
2 Calculate the case fatality ratio of this disease. (1 mark)
3 Determine the proportion of the population that needs to be vaccinated to prevent the spread of the disease. (2 mark)
Need help processing and analysing data? Go to Lesson 1.8 in your biology toolkit (page xx).
To determine the source of an outbreak, scientists need to first determine whether the source of the outbreak is infectious or non-infectious. For non-infectious diseases, a number of key questions must be investigated, to determine whether key factors in a population contribute to the cause and spread of the disease.
1 Is there a significant statistical correlation between the disease and the proposed cause? For example, it has been shown that deaths due to lung cancer are significantly higher in smokers than in non-smokers, which implies a high correlation between smoking and lung cancer. With further information, it can be concluded that smoking is a cause of lung cancer.
2 Is the cause–effect relationship consistent across all other variable characteristics, such as age, occupation, gender, geographical location and race? For example, the correlation of smoking with a higher incidence of lung cancer is observed across all variables.
3 Is there a temporal sequence or direct timeline – that is, does the proposed cause occur before the onset of the disease? The incidence of lung cancer began to increase 10 years after rates of cigarette smoking began to rise. This typically corresponds with the time between exposure to cancer-causing chemicals (in cigarette smoke) and the onset of cancer.
4 Does an increase in exposure to the proposed cause mean an increased risk of the disease? It has been found that the death rate due to lung cancer is higher in heavy smokers than in less regular smokers.
5 Do the trends observed have a plausible relationship or explanation of why this factor causes clinical symptoms? The chemicals in cigarette smoke have been identified as carcinogens. Therefore, it is plausible that they cause lung cancer.

For many non-infectious diseases, this approach has been used to determine the cause, whether inherited, environmental or nutritional.
For infectious diseases, scientists need be able to identify the type of pathogen causing the disease. Depending on the nature of the pathogen, different identification techniques must be used for:
• identifying macroparasites and protists
• identifying bacterial and fungal pathogens
• identifying viruses
• using Koch’s postulates.

Macroparasites and protists can be readily seen with the naked eye or through a light microscope. Intestinal worms lay uniquely shaped and sized eggs that can be identified from a faecal smear. Intestinal protozoans can be identified in a similar way. Other pathogens can be easily identified by microscopic examination of blood samples. Micropathogens (prions, viruses, bacteria and many fungi), on the other hand, need more specialised methods of identification. Prions are identified using chemical analysis of blood proteins.
Bacterial and fungal pathogens can be isolated from host cells by centrifuging tissue samples and filtering the smaller pathogens from the host cells. The pathogenic cells are then cultured on nutrient agar jelly in a Petri dish. Similarly, the plates can be smeared with blood serum or scrapes of tissue. Sterile conditions are employed to ensure that the culture is not contaminated with airborne organisms.
Bacteria and fungi (including moulds and yeasts) grow well on nutrient agar plates. Single cells of these organisms reproduce and form colonies. Different types of cells produce colonies with distinctive features or colony morphology. Basic characteristics of this morphology include their colour or shape, the elevation or surface of the colony, the smoothness of the edges and even the odour of the colony. Figure 8 shows some examples of shape, elevation and edge margin.
Most bacterial colonies are roughly circular in shape and are coloured white, cream or yellow.
Antibiotics are molecules that kill bacteria or block their growth. Each antibiotic works in a different way, depending on the presence of specific antigens on the bacteria. When special filter papers, each impregnated with a different antibiotic, are laid over the bacterial colonies growing on agar, particular antibiotics will inhibit the growth of the bacteria. This inhibition can be seen by a zone clear of bacteria around that specific antibiotic (Figure 10). This allows the identification of the bacteria by noting their susceptibility to the antibiotic.
Further identification can be achieved by staining the colonies. Gram-staining determines two major groups of bacteria – Gram-positive and Gram-negative – depending on the chemicals present in the outer cell wall. Another important identifier is the shape of the bacterium. A bacterial cell can be spherical (known as coccus; a pair or a chain of cells is known as cocci), rodshaped, or spiral or comma-shaped. Some fungus-like bacteria, Mycobacterium , have a Gram-negative result because they have a waxy surface on their cell walls, which prevents uptake of the stain. Identifying these bacteria requires an alternative, fast-acid (pink) stain.






These staining techniques are useful for identifying the genus of the bacterium, but not the species within the genus – a Mycobacterium can be differentiated from a Streptococcus by staining, but differentiation of the exact species requires DNA analysis.
Yeast colonies also have a circular shape, and some look remarkably like bacterial colonies. For example, Candida albicans, which causes thrush, has white, round colonies. Microscopic examination of individual cells will determine whether they are prokaryotic (no nucleus and therefore a bacterium) or eukaryotic (nucleus present and therefore a fungus).
Moulds grown on an agar plate often appear whitish grey with fuzzy edges. They usually turn a different colour from the centre outwards. The cell structure, method of spore


formation and general body function can be determined using a microscope. Fungi can be further tested by growing on selected media or by enzymatic reactions.
Viruses are difficult to identify in a laboratory, because they cannot survive on their own. Instead they must be grown in a liquid culture with host cells. Because each virus can only bind to the host cell that contains the correct adhesion molecule, trial and error may be required to determine a suitable type of host cell.
Once the virus can be grown in a host cell, different strategies are used to identify it, depending on the purpose of identification. Often a virus causes specific changes to the host’s cells – a cytopathic effect – and this can be seen under a light microscope. If these changes are seen in the cultured host cells, then the virus can be identified. Other techniques include X-ray diffraction, electron microscope examination and DNA analysis.

cytopathic effect a degenerative change in the appearance of cells

Once a pathogen has been isolated and identified, techniques using Koch’s postulates are employed to ensure that the organism is responsible for the disease. These postulates, or criteria, are as follows:
1 The microbe is present in organisms with the disease but not in healthy organisms.
2 The microbe is isolated from the diseased organism and cultured in pure form (i.e. with no other microorganisms present).
3 When this cultured microbe is injected into a healthy organism, the organism develops the disease symptoms.
4 The microbe is re-isolated from the experimentally infected organism and again cultured. This new culture shows only the original form of microbe.
Koch’s postulates general criteria that assess whether an organism is the cause of a disease
Different types of data can also be analysed to determine the mode of disease transmission (Table 2).
TABLE 2 Different types of data and how they can be used to help establish the mode of disease transmission.
Type of data
Epidemiological data
(e.g case studies, information collected from contact tracing)
Demographic data
(e.g. age, occupation, gender, etc)
Genetic and molecular data
(e.g. data on the genetic make-up of pathogens, hosts and their molecular responses)
Behavioural data
(e.g. data on the behaviour, lifestyle factors and social interactions of individuals)
How data can be used to establish mode of transmission
• Examining case studies of disease occurrence can help to identify common factors between affected individuals (e.g. if all affected individuals obtained water from the same source, this suggests the disease is spread through contaminated water).
• Information gathered from contact tracing can help establish commonalities in the behaviours or interactions of individuals (e.g. if it was observed that many non-infected individuals became infected after being in proximity with infected individuals, this suggests transmission through direct contact).
• Establishing whether there is a higher incidence of disease in certain demographics can help determine the mode of transmission (e.g. if workers who regularly handle asbestos have a higher incidence of mesothelioma, this suggests that exposure to asbestos particles contributes to the onset of mesothelioma).
• Data that sequences pathogens can trace transmission pathways. Also, studying host genetics can reveal how susceptible a host is to a specific pathogen (e.g. genetic data has shown that an individual with one copy of the sickle cell gene is less likely to be affected by malaria than an individual with two copies of the sickle cell gene).
• Analysing behavioural data can help establish whether behaviour or lifestyle factors contribute to transmission of disease (e.g. if data showed that unaffected sexual partners of individuals infected with Zika virus contracted Zika after sexual intercourse with their partner, this would establish that the disease does not just spread through the bite of mosquito vectors but also through contact with infected body fluids).

John Snow and the cholera outbreak
Cholera is an extremely virulent disease caused by the bacterium Vibrio cholerae. It is spread by the consumption of contaminated food or water. In 1854, a severe outbreak of cholera in London killed 616 people. At the time, it was thought that the disease was spread by particles in the air. This was debunked by the physician John Snow, who instead traced the cause of the disease to a contaminated water source – a water pump in Broad Street. Snow tracked all cases of cholera (Figure 1) and concluded that the pattern of the disease suggested the water people were consuming from a nearby pump was infected. Snow started a public health campaign that led to the pump no longer being used and, subsequently, a decline in the disease.

Apply your understanding
1 Using the steps that need to be followed to reach an epidemiological conclusion, explain how Snow was able to conclude that the cholera outbreak was caused by a contaminated water source. (3 marks)
Mary Mallon was born in Northern Ireland in 1869. At the age of 15, she migrated to the United States, where she eventually found work as a cook for well-to-do families in New York. It is not known where Mary was first exposed to typhoid, but in 1900 she started cooking for a new family. Within two weeks, family members became sick with typhoid. Mary herself did not show any symptoms of the disease (fever and diarrhoea). Within a year, Mary needed to move on (as family members started dying). The family members of her new employers also contracted typhoid, and the laundress died. In the third family Mary cooked for, seven out of eight members of the family contracted the disease. This pattern of asymptomatic (no symptoms) Mary cooking for new families who then contracted the disease continued for seven years, before a typhoid researcher named George Soper investigated the outbreak. Despite several confrontations by the health authorities, Mary denied that she was the cause (carrier) of the typhoid outbreaks. She was jailed several times for refusing to stop cooking and spreading the disease. Eventually, she was placed in quarantine at the Riverside Hospital for the last 23 years of her life. It is thought that ‘Typhoid Mary’ was responsible for at least three deaths and over 50 infections as a result of being a typhoid carrier.
Apply your understanding

1 Determine the factors that established Mary as the source of the outbreak of typhoid. (3 marks)
2 Infer the mode of transmission of typhoid. (1 mark)
Once the source and mode of transmission of a disease have been established, government and public health agencies can implement strategies such as public health campaigns, education on personal hygiene measures, vaccinations, contact tracing and quarantine in an attempt to reduce the spread of the disease. The effectiveness of strategies used in controlling the spread of disease can be evaluated through comparison of data, controlled studies and statistical analysis. Table 3 summarises how these methods can be used to evaluate the effectiveness of a strategy or treatment.
TABLE 3 Methods of data analysis used to evaluate the effectiveness of a strategy or treatment for controlling disease.
Method of evaluation
Comparing data
Comparing data on the incidence or transmission rates of a disease before and after a control measure has been applied, or comparing data between different control measures
Controlled studies
Conducting and analysing data from studies that test whether a strategy influences the number of cases of disease or test whether a treatment is effective in managing symptoms of disease
Statistical analysis
Using statistical models to determine whether changes in the number of cases observed can be attributed to the control measure used
Example
During the COVID-19 pandemic, researchers compared data on transmission rates before and after different lockdown measures were implemented in various countries. The comparison showed that countries that enforced stricter lockdown rules had slower rates of transmission than those with more lenient lockdown rules. This suggests that stricter lockdowns are effective in reducing the transmission of COVID-19.
During COVID-19 vaccine development, clinical trials involved some participants receiving an active vaccine and others receiving a placebo. Results showed that the vaccine group had fewer cases of COVID-19, demonstrating the effectiveness of the vaccine.
Water, sanitation and hygiene (WASH) interventions are often implemented to manage outbreaks of cholera. A meta-analysis of data related to papers studying WASH strategies found that household water treatment (HWT) interventions, such as chlorination and filtration, reduced the risk of cholera by 47%.
Check your learning 13.4
Check your learning 13.4: Complete these questions online or in your workbook.
1 E xplain why it is mandatory for some diseases to be reported to the World Health Organization. (2 marks)
2 Describe a cytopathic effect and how it is used. (2 marks)
3 Identify some of the morphological features of a bacterial colony that are used to identify bacteria. (3 marks)
4 Describe what causes the different reactions of certain bacteria to Gram stain (2 marks).
5 Certain bacteria and the yeast Candida both form smooth, white colonies. Describe the differences between them. (2 marks)
6 Describe how data from disease monitoring is used. (2 marks)
7 Describe three types of data that can be used to
infer the mode of disease transmission. (3 marks)
8 E xplain why the value of R0 varies according to the type of pathogen and its mode of transmission. (2 marks)
9 E xplain how comparing data can be used to evaluate the effectiveness of a strategy for reducing the spread of disease. (2 marks)
Knowledge utilisation
10 Predict the likelihood of an epidemic occurring in a population in which:
a no one is vaccinated against the disease (2 marks)
b most people are vaccinated against the disease. (2 marks)
• Epidemiology is the scientific study of factors that determine and influence the frequency and distribution of disease, injury and other health-related events.
• The transmission of disease can occur through direct contact or indirect contact with the source of infection.
• Direct contact includes the transmission of a pathogen through physical touch, contact with infected body fluids and the spread of airborne droplets.
• Indirect contact includes the transmission of a pathogen through consuming contaminated food or contaminated water, and by infection via a vector.
• The spread of a disease is also influenced by factors such as the persistence of the pathogen within the host, the transmission mechanism, the proportion of the population who are immune or have been immunised, and the mobility of individuals in the affected population.
• Measures to control the spread of disease include personal hygiene measures, contact tracing and quarantine.
• Good personal hygiene and rigid standards at food preparation outlets are significant deterrents to the spread of infectious disease.
• Contact tracing involves identifying and providing advice to individuals infected with a disease and the contacts they may have spread the disease to.
• Quarantine is the isolation of individuals infected with a disease; it can occur at a local, federal or international level.
• Treatments that may be administered to treat disease include plant-derived chemicals, antibiotics and chemicals produced by other organisms.
• Practical: The effect of an antimicrobial agent on the growth of a microbial organism.
• Certain diseases must be reported to state and federal authorities. Other diseases are notifiable to the World Health Organization to reduce pandemic outbreaks.
• Mathematical models developed from surveillance data can predict the likely outcomes of disease outbreak.
• Viruses are non-living particles that can only be cultivated in living cells.
• Bacteria and pathogenic fungi are living cells and can be cultivated on a nutrient agar medium in a Petri dish under sterile conditions.
• Different groups of bacteria can be distinguished using growth inhibition by specific antibiotics and staining techniques (Gram stain or fast-acid stain). Identification to species level is achieved by DNA analysis.
Review questions: Complete these questions online or in your workbook.
1 Factors that aid in the transmission of pathogens do not include
A small droplets of water in the air.
B global wind patterns.
C direct contact with an infected individual.
D contaminated food and water.
2 Pandemics have not been caused by
A regional travel within a country.
B increased tourism.
C movement of goods between countries.
D migration of certain animals.
3 Epidemiology is the
A identification of species from their genome.
B use of X-ray diffraction to determine the molecular structure of pathogens.
C ability to rapidly make multiple copies of segments of DNA.
D identification of the causes of disease.
4 Globally, the leading cause of human deaths is
A non-infectious diseases, of which the prime cause is smallpox.
B non-infectious diseases, of which the prime cause is heart disease and stroke.
C infectious diseases, of which the prime cause is influenza.
D infectious diseases, of which the prime cause is cholera.
5 R0 is a measure of the number of people who become infected by each person with a disease. This parameter
C the isolation period for a person, animal or plant required to ensure non-transmission of an infectious disease or a potential infectious disease.
D the isolation of all people with a contagious disease in a special hospital ward.
7 For some planes that arrive in Australia from overseas, the passenger cabins are sprayed prior to disembarkation. The purpose of this procedure is to
A provide deodorant to passengers after being in stagnant air for a long time.
A varies depending on the disease and the mode of transmission.
B varies depending on the disease but not the mode of transmission.
C is the same for all diseases that have the same mode of transmission.
D is the same for all diseases irrespective of the mode of transmission.
6 Quarantine refers to
A the 40-day period of isolation of a person with a disease to ensure that the disease is no longer viable.
B the 40-day period of isolation of a diseased person to ensure treatment is completed.
B reduce stress in the passengers before they pass through quarantine.
C attempt to reduce ectoparasites on the passengers.
D attempt to eliminate airborne pathogens.
8 Antibiotics
A can be used to treat all the effects caused by pathogens.
B are only effective against bacterial and viral infections.
C are toxic to all bacteria.
D each have selective toxicity to specific bacteria.
9 Identify the morphological features of the yeast colonies shown.
A circular, raised, entire
B irregular, umbonate, entire
C circular, umbonate, entire
D circular, crateriform, undulate
10 Calculate the mortality rate of a disease per million people, if 125 of the 250,000 people in the population die.
A 0.05%
B 125 people per 250,000
C 500 per million
D 1 in 2000
11 Alcohol-based hand sanitiser gels have been used since the 1980s, but have risen in popularity in the last decade. Tests have shown that they are as effective as soap and water and are useful when there is no safe water available. Identify the role of hand sanitiser in managing disease.
A preventative measure
B control measure
C quarantine measure
D biosecurity measure
12 Conjugation is a common way for a bacterium to obtain antibiotic resistance. Define conjugation.
A the dividing of bacterial cells
B the transformation of bacterial DNA
C the transduction of DNA from viruses
D the transfer of DNA from one cell to another that is temporarily joined to it
Review questions: Complete these questions online or in your workbook.
13 Define ‘contact tracing’. (1 mark)
14 Describe how vector organisms affect the spread of disease. (2 marks)
15 E xplain how public health programs control and/ or prevent disease. (5 marks)
16 Describe the role of the Australian Quarantine and Inspection Service in preventing infectious disease outbreaks. (2 marks)
17 Between 2000 and 2022, people who had lived in England during the mad cow epidemic were not permitted to donate blood in Australia. Explain the rationale behind this. (2 marks)
18 Recently a number of miners have developed black lung disease. Describe how an epidemiological study could determine the cause of this disease. (5 marks)
19 The bacterium Staphylococcus aureus, or ‘golden staph’, causes a range of pus-forming infections through the production of toxins. Some strains of this bacterium are highly adapted to hospital environments because they are resistant to a large number of antibiotics, and are highly dangerous for individuals recovering from surgery. Strains of this bacterium found outside the hospital environment are sensitive to antibiotics. Describe how different sensitivity to antibiotics has occurred in these strains. (3 marks)
20 In 1957, scientists in England discovered a natural substance, now known as interferon, that interferes
with viral replication. Interferon is produced in the cells of infected humans (and closely related species, such as chimpanzees) within 2 hours of viral infection. Antibody production takes 7 to 10 days after infection. Nearly all cell types can synthesise interferon, but it cannot be synthesised in embryos less than 3 months old. The production of interferon is variable among different people.
a The mosquito-borne Zika virus may not have serious effects on a pregnant woman. Her unborn child, however, may die or suffer microencephaly (a condition in which the brain is significantly undeveloped). Explain this occurrence. (3 marks)
b Some people rarely suffer from viral infections, while others constantly contract diseases such as colds and influenza. Identify what factors might contribute to this difference. (3 marks)
21 Herd immunity refers to the resistance of a population to disease through immunity, often achieved by vaccination. The probability of someone catching a contagious disease from someone infected depends on the vaccination rate, and it is expressed as a ratio. For instance, when a population is 99% vaccinated, the probability of encountering someone unvaccinated is 1:100.
a If 95% of a population is vaccinated for a bacterial disease, calculate the probability that the first person you meet is unvaccinated. Provide your final answer as a ratio. (1 mark)
b If 80% of a population is vaccinated for a viral disease, calculate the probability that the first person you meet is unvaccinated. Provide your final answer as a ratio. (1 mark)
22 Compare the use of historical data and environmental data to predict outbreaks of disease. (3 marks)
23 In March 2017, a vaccine against malaria developed by researchers at Griffith University, Queensland, passed early human trials.
a Assuming that the R0 for malaria is 100, determine what percentage of any given population would need to be vaccinated to prevent the spread of this disease. (1 mark)
b Describe factors that would affect the success of such a vaccination program in countries where malaria is most prevalent. (4 marks)
24 The table shows the incidence of avian influenza A (H5N1) in humans at a particular time.
a Calculate the mortality rate and case fatality rate for each group of countries, to complete the table. (1 mark)
b Contrast the mortality rates and case fatality ratios for the groups of countries. (3 marks)
c Identify two possible explanations for the differences in mortality rates in the country groups. (2 marks)
d Determine, with reasons, whether you would recommend issuing travel warnings to tourists for any of the countries listed. (2 marks)
e Dicusss how personal health measures may reduce the likelihood of contracting the disease. (4 marks)
Djibouti, Egypt, Iraq, Nigeria, Turkey
Many strains of bacteria have developed resistance to commonly used antibiotics. Microbiologists are experimenting with new substances that may have antimicrobial properties. The disc method of testing antibiotics and antibiotic-resistant bacteria involves impregnating a small disc of filter paper with a substance and placing it on an agar plate with bacteria. If bacterial growth is inhibited, after 48 hours there will be a clear zone around the disc where there has been little to no growth. Six new substances have been isolated from Australian fungal species. Their potential for future use as antibiotics is being tested. The clear zones around the antibiotic-impregnated discs indicate inhibition of bacterial growth.

TABLE 1 Zone of inhibition by penicillin, for five bacterial species.
Substance
TABLE 2 Resistance of five bacterial species to six new substances. Substance
Notes
‘–’ indicates no resistance ‘+’ indicates resistance (‘+++’ = highest resistance).
Apply understanding
1 Calculate the average zone of inhibition for penicillin action on Bacillus subtilis (1 mark)
Analyse data
2 Contrast the statistical accuracy of the results of penicillin action on Escherichia coli and Staphylococcus aureus. (2 marks)
Interpret evidence
3 Determine which substance might be worth purifying into an antibiotic for patients suffering from botulism, an illness caused by C. botulinum. Give reasons to support your response. (2 marks)
4 Many strains of golden staph (S. aureus) have developed resistance to penicillin and penicillin derivatives (such as ampicillin and amoxycillin). Identify an alternative substance that could be developed into an antibiotic for golden staph, justify your response. (2 marks)
Question 1
A larger than normal number of individuals in a particular locality being infected by a disease at a particular time is referred to as
A a pandemic.
B an epidemic.
C genetic disease.
D non-infectious disease.
Question 2
“Droplet spread” is a type of disease transmission called
A direct transmission.
B immunisation.
C indirect transmission.
D vector transmission.
Question 3
Parasites obtain nutrients
A by consuming sugars produced by plants.
B by eating dead and decaying matter.
C by photosynthesis.
D from their host.
Question 4
In terms of vector-borne disease, which of the following can be classified as a carrier?
Question 6
Vitamin C deficiency can be classified as which of the following?
A genetic disease
B infectious disease
C nutritional disease
A a human infected with malaria
B a mosquito that can carry malaria but is not currently infected
C the bloodmeal taken by a mosquito from a human infected with malaria
D the Plasmodium protozoan that causes malaria infection
Question 5
Which of the following is not an infectious disease?
A influenza
B iron deficiency
C malaria
D the common cold
D pathogenic disease
Question 7
Antibodies being passed from mother to baby during pregnancy is an example of
A active artificial immunity.
B active natural immunity.
C passive artificial immunity.
D passive natural immunity.
Question 8
Herd immunity describes the
A ability of a pathogen to spread between different species.
B limited spread of disease due to the high vaccination rate of a population.
C movement of disease within a herd of cattle.
D number of people infected within a community at a given time.
Question 9
The immune cells responsible for producing memory cells are called
A antibodies.
B antigens.
C B-lymphocytes.
D T-lymphocytes.
Question 10
Natural killer cells fight disease by
A destroying pathogens through endocytosis.
B making copies of antibodies.
C raising the body temperature of the organism.
D triggering apoptosis in virus-infected cells.
Isolating and restricting the travel of individuals who may have been exposed to an infectious disease is called
A epidemiology.
B herd immunity.
C indirect contact.
D quarantine.
Question 12
The major histocompatibility complex is
A composed of protein markers on the outside of cells.
B needed to break down pathogens engulfed through endocytosis.
C recognised as an antigen by the immune system.
D triggered by white blood cells when an antigen is detected.
The inflammatory response involves the activation of
A neutrophils and macrophages.
B T-lymphocytes and B-memory cells.
C vaccines and antibodies.
D vasoconstriction and reduced heart rate.
Question 14
Which of the following is an example of a vector of human disease?
A bacteria
B contaminated water
C intestinal worms
D ticks
Question 15
Question 1 (5 marks)
The image shows the movement of pathogens into a cell of the immune system.
The complement system is a part of the immune system that
A adapts to specific pathogens.
B consists of proteins formed in the liver.
C is secreted by skin cells to support the physical barrier provided by the epidermis.
D responds to vaccines.
a Identify the name of this process. (1 mark)
b Suggest what type of immune cell is depicted in this image. (1 mark)
c Explain how pathogens are destroyed once they are inside the cell cytoplasm. (3 marks)
Question 2 (3 marks)
Describe how disease can be spread through water, and provide one example of a disease that can be spread this way.
Question 3 (4 marks)
Explain how quarantine can effectively minimise transmission of disease.
Question 4 (5 marks)
Classify the modes of transmission in the table as direct or indirect contact.
Mode of transmission
Airborne droplets through sneezing
Sexual contact
Infection through mosquito bites
Drinking contaminated water
Physical touch
Question 5 (3 marks)
Direct or indirect?
Describe how contact tracing can reduce the number of infections during a pandemic.
Question 6 (3 marks)
Identify the characteristics of bacteria that allow them to readily develop antibiotic resistance.
Question 7 (4 marks)
Contrast endoparasites and ectoparasites, and give an example of each.
Question 8 (3 marks)
Describe a pathogen and provide two examples.
Question 9 (3 marks)
Describe how each of the following personal hygiene measures reduce disease transmission:
• cooking food to high temperatures
• washing hands with soap and water after using the toilet
• wearing a face mask when unwell and when travelling on public transport.
Question 10 (4 marks)
Explain how mosquitoes can act as vectors that transmit disease to humans.
Question 11 (2 marks)
Contrast the terms “vector” and “reservoir” with respect to disease transmission.
Question 12 (5 marks)
Explain the role that air travel plays in the transmission of disease.
TOTAL MARKS /59 marks
Part A of the Unit review asks you to reflect on your learning and identify areas in which you need more work.
Topic 1: Homeostasis –thermoregulation and osmoregulation
Module 10: Control and coordination
Module 11: Thermoregulation and osmoregulation
Topic 2: Infectious disease and epidemiology
Module 12: Disease
Module 13: Epidemiology
Now that you’ve completed your revision for Unit 2, it’s time to learn and practise some of the skills you’ll need to answer exam questions like a pro! To help you, our expert authors have created the following advice and tips to help you maximise your results on the end-of-year examination.
Some marks rely on sufficient detail and use of scientific terms from the syllabus. A response can be correct but lose marks if it does not contain the correct term or a detailed explanation. To prepare for this, you can do the following:
• Build a list of the scientific terms you are likely to need, and practise defining them and using them in a variety of responses.
• Practise writing out all you know about a concept using all the scientific terminology you can think of, then go back to your notes or textbook and look for terms you may have missed or misused and detail you can add. Write the improved response.
Read the exam question below and see how the tip has made a difference between a response that has scored full marks and a response where marks have been lost.
Question 1
Marielle works as a kitchen hand at a restaurant. During her shifts she will often go between spending time collecting food from the walk-in refrigerator to spending time stocking and preparing food in the warm kitchen. Marielle’s body initiates several actions to ensure her body maintains a stable internal temperature. Name the regulatory process that enables the body to maintain a steady internal body temperature despite changes in external conditions. (1 mark)
Complete response
Thermoregulation
1 mark awarded for identifying the specific scientific term used to describe the regulatory process that enables the body to maintain a steady internal body temperature despite changes in external conditions.
Incomplete response
Homeostasis
No marks awarded; the specific scientific term for the process that allows the body to regulate internal temperature is “thermoregulation”. While thermoregulation is a homeostatic mechanism, “homeostasis” is not specific enough to be awarded a mark in this question.
To maximise your marks on an exam, it can help to think like a QCAA assessor. Consider how many marks each question is worth and what information the assessor is looking for.
A student has given the following response in a practice exam. Imagine you are a QCAA assessor and use the marking guide below to mark the response.
QUESTION 1 (1 mark)
During winter seasons, many animals enter a state of hibernation. Define hibernation.
Hibernation is when an animal enters a long period of sleep.
Marking guide
Question 1
• Definition identifies that hibernation as an extended period of torpor and includes characteristics such as sleep, a reduction in body temperature and a reduction in metabolic activity. [1 mark]
Consider where you did and did not award marks in the above response. How could the response be improved? Write your own response to the same question to receive full marks from a QCAA assessor.
During an exam, you may feel under pressure to get through all the questions as quickly as you can. However, rushing through questions can lead to missing key terms or cognitive verbs in a question. You should read each question carefully to ensure you have identified what you need to provide in your response, in order to address the question without missing elements. Here are some tips to help you.
• Use your perusal time well. This is your first opportunity to read through the questions in the exam. If you pick up on a key term or instruction in the question, make a mental note of it.
• During writing time, be sure to re-read each question and underline key terms, instructions and cognitive verbs.
• After you have written your response, re-read the question a final time to ensure that your response has appropriately addressed all elements of the question.
Read the exam question below and see how the tip has made a difference between a response that has scored full marks and a response where marks have been lost.
Question 2
There are many cells in the human immune system that work to eliminate infected cells. Name one of these cells and describe how it works to eliminate an infected cell. (2 marks)
1 mark for correctly identifying a cell type that eliminates infected cells.
A macrophage, which uses phagocytosis, the engulfment of a foreign cell, to capture infected cells and digest them
1 mark for describing how the selected cell type eliminates an infected cell.
1 mark for correctly identifying a cell type that eliminates infected cells.
Natural killer (NK) cells work to eliminate infected cells.
Response is not awarded a second mark, as it does not describe how natural killer cells work to eliminate infected cells.
To maximise your marks on an exam, it can help to think like a QCAA assessor. Consider how many marks each question is worth and what information the assessor is looking for.
A student has given the following response in a practice exam. Imagine you are a QCAA assessor and use the marking guide below to mark the response.
QUESTION 2 (2 marks)
Plants have evolved several defence strategies to protect themselves from infection and injury. Identify one chemical defence strategy used by plants and describe how it protects the plants from pathogens.
One plant defence strategy includes barriers such as bark, which provides a thick casing over the plant that makes it difficult for pathogens to enter the internal structures of the plant.
Marking guide
Question 2
• Identifies a chemical defence strategy [1 mark]
• Describes how the selected chemical defence strategy protects the plant from pathogen invasion or infection [1 mark]
Consider where you did and did not award marks in the above response. How could the response be improved? Write your own response to the same question to receive full marks from a QCAA assessor.
Some questions that include data sets such as graphs and tables may instruct you to “refer to data” or “use evidence from the data” to support your answer. This means that your response must include values or trends that are presented in the data set. Even if your response is correct, if you have not referred to the data after being instructed to, you will lose marks.
See it in action
Read the exam question below and see how the tip has made a difference between a response that has scored full marks and a response where marks have been lost.
Diphtheria is an infectious disease transmitted via the transfer of body fluids through sneezing, coughing and open wounds. Approximately 10% of individuals infected with diphtheria will die from the disease. While it can affect people of all ages, it was most often found in children. The causative agent, Corynebacterium diphtheriae, was identified in the 1920s and a vaccination program was first implemented in1932. In 1953, the vaccination program in Australian schools was updated to include a combination vaccine for diphtheria, tetanus and whooping cough (DTP).
Referring to Figure 1, describe the effectiveness of the diphtheria vaccination program in Australian schools. (3 marks)
Diphtheria outbreaks in Australia from 1917 to 2018
1 mark for identifying a steady low incidence of diphtheria following introduction of DTP vaccination.
1 mark for identifying trend in graph after first implementation of diphtheria vaccine.
After the diphtheria vaccination program commenced in 1932, the rate of diphtheria infections began decreasing steadily until it was almost eradicated from the population. There were some spikes of diphtheria in 1942, but after 1953, when the DTP vaccination was introduced into Australian school vaccination programs, the rate of diphtheria decreased again and has remained under control ever since. This decline in cases provides evidence that diphtheria vaccination programs in Australian schools are effective in controlling the incidence of diphtheria.
1 mark for identifying how trends in data support the e ectiveness of the diphtheria vaccination program.
Incomplete response
Figure 1 provides evidence that diphtheria vaccination programs in Australian schools are effective in controlling the ncidence of diphtheria.
No marks awarded for this question. While the student has stated that the evidence supports the e ectiveness of diphtheria, they have not described the data and explained how this data supports the e ectiveness of the vaccination program.
To maximise your marks on an exam, it can help to think like a QCAA assessor. Consider how many marks each question is worth and what information the assessor is looking for.
A student has given the following response in a practice exam. Imagine you are a QCAA assessor and use the marking guide below to mark the response
QUESTION 3 (4 marks)
Figure 2 shows changes in urine osmolality and urine production in response to increasing concentrations of ADH. Describe the e ect that increasing ADH concentration has on urine osmolality and urine production, using data from Figure 2 to support your answer.
Figure 2 Changes in urine osmolality and urine production in response to increasing concentrations of ADH
As ADH concentration increases, urine osmolality increases. As ADH concentration increases, urine production rate decreases.
• Identifies that an increase in ADH concentration results in a decrease in urine production rate [1 mark]
• Identifies points from the data displayed to support that an increase in ADH concentration results in a decrease of urine production rate [1 mark]
• Identifies that an increase in ADH concentration results in an increase of urine osmolality [1 mark]
• Identifies points from the data displayed to support that an increase in ADH concentration results in an increase of urine osmolality [1 mark]
Consider where you did and did not award marks in the above response. How could the response be improved? Write your own response to the same question to receive full marks from a QCAA assessor.
Now that you know all these tips, it’s time for you to move on to Part C – Practice exam questions to put them into practice.
Now it’s time to put the tips and advice you’ve learned into practice while you complete these exam-style questions! You will complete two papers as part of your external examination: Paper 1 tests you on multiplechoice and short-response questions, and Paper 2 tests you on more complex, multi-part short-response questions.
1 A synapse is the site of communication between
A two axons.
B two dendrites.
C an axon and a dendrite.
D the central and peripheral nervous systems.
2 Experimentally it is found that the rate of heat loss from a rat is greater than that of an elephant. The best explanation for this observation is that
A small animals eat proportionally more than large animals.
B the simple structures of smaller mammals compared to larger mammals means they are not able to conserve heat.
C small mammals have a larger surface area-tovolume ratio than large mammals.
D small mammals are more active than large mammals.
3 A pandemic occurs when
A a particular infectious disease spreads through many countries at the same time.
B many individuals in a population contract the same disease.
C the pathogen can multiply rapidly.
D a reservoir host is incapacitated.
4 Identification of a viral cause of disease is difficult because
A viruses are too small to be seen through a microscope.
B viruses can only be cultured in living tissue.
C cytopathic effects are only caused by bacteria.
D it can only be achieved by gene sequencing of the viral nucleic acid.
5 In the modelling of infectious diseases, “mortality rate” refers to
A the number of deaths from the disease.
B the rate of death per population size for the disease.
C the number of deaths among those that have contracted the disease.
D the percentage of individuals that have contracted the disease.
6 In thermoregulation,
A thermoreceptors are the effectors.
B the control centre is the hypothalamus.
C the receptors are connected to blood vessels.
D the response is initiated by thermoreceptors.
7 Which of the following types of sensory receptors detect details of light wavelength and intensity entering the eye?
A chemoreceptors
B thermoreceptors
C mechanoreceptors
D photoreceptors
8 The set of chemical reactions in a cell that occurs when a molecule, such as a hormone, attaches to a receptor on the cell membrane is best known as
A thermoregulation.
B osmoregulation.
C signal transduction.
D homeostasis.
9 In the endocrine system,
A the pituitary gland acts as the control centre.
B hormones act faster than the electrical signals transmitted in the nervous system.
C the posterior pituitary lobe accounts for 80% of the pituitary gland and functions to produce and release hormones.
D target cells have recognition sites for specific hormones.
10 Salicylic acid (SA) is a plant hormone with a role in defence. On contact with a pathogen, SA is released, which triggers defensive responses in nearby cells. Which type of hormone is SA an example of?
A autocrine
B paracrine
C endocrine
D exocrine
11 A bacterium that is spherical in shape can be described as
A coccus.
B spirillum.
C bacillus.
D vibrio.
12 The humoral response involves activation of
A T-lymphocytes.
B B-lymphocytes.
C histamine.
D antigens.
13 Which of the following is an example of a non-living agent of disease?
A protists
B bacteria
C viruses
D fungi
14 Plasma cells differentiate from
A memory B-cells.
B helper T-cells.
C B-lymphocytes.
D cytotoxic T-cells.
15 The diagram below represents an action potential travelling along an axon. Which one of the following statements about the diagram is true?
A The axon membrane is resting at point A, repolarising at point B and depolarising at point C.
B The axon membrane is resting at point C, repolarising at point B and depolarising at point A.
C The axon membrane is resting at point B, repolarising at point A and depolarising at point C.
D The axon membrane is resting at point A, repolarising at point C and depolarising at point B.
16 Brown adipose tissue contains high concentrations of
A ribosomes.
B nuclei.
C mitochondria.
D chloroplasts.
17 The following graph shows an individual’s antibody concentration over time.
Antibody concentration
0306090120150180 Time (days)
Secondary exposure to an antigen would have occurred at
A 0 days.
B 90 days.
C 180 days.
D 60 days.
18 What is the main method ectotherms use to regulate their body temperature?
A food metabolism
B behavioural responses
C physiological responses
D structural features
19 Bordetella pertussis is the bacterial pathogen that causes whooping cough. B. pertussis produces a protein that is excreted by the cell. The protein disrupts the immune response by inhibiting the actions of infected cells to attract and recruit immune cells in defence. Determine the type of protein.
A adhesin
B invasion factor
C endotoxin
D exotoxin
20 An antigen is
A a Y-shaped protein produced by B-lymphocytes.
B any agent that transmits an infectious pathogen to another living organism.
C a non-self protein of the surface of an invading pathogen.
D the process of engulfing a bacterium carried out by a macrophage.
Question 21 (3 marks)
Identify three characteristics of skin that aid the prevention of infection.
Question 22 (2 marks)
Describe how quarantine can be used to control the spread of disease.
Question 23 (1 mark)
Define homeostasis.
Question 24 (2 marks)
Parasites need at least one host to survive. Describe two problems that can threaten a parasite’s chance of survival.
Question 25 (2 marks)
Contrast infectious and non-infectious diseases.
Question 26 (2 marks)
Distinguish between positive and negative feedback.
Question 27 (2 marks)
Explain how a host’s immune cells are able to fight pathogens and foreign material without attacking the host’s own cells.
Question 28 (3 marks)
Compare torpor and aestivation.
Question 29 (3 marks)
Describe the three pathways of complement activation in the immune system.
Question 30 (2 marks)
Herd immunity refers to the resistance of a population to a disease through immunity, often achieved by vaccination. The probability of someone catching a disease from an infected person depends on the vaccination rate, and is expressed as a ratio. For instance, when a population is 99% vaccinated, the probability of encountering someone who is unvaccinated is 1:100.
a If 95% of a population is vaccinated against a disease, calculate the probability that the first person you meet is unvaccinated. Provide your final answer as a ratio. [1 mark]
b If 80% of a population is vaccinated against a disease, calculate the probability that the first person you meet is unvaccinated. Provide your final answer as a ratio. [1 mark]
Question 31 (2 marks)
Hendra is a virus that was discovered in 1994 after the death of 13 horses and a trainer in Queensland. Horses become infected after coming into contact with the bodily fluids of flying foxes. Humans, such as trainers and veterinarians, are most at risk of contracting the virus when they come into contact with a horse’s bodily fluids.
a Determine the primary host of the Hendra virus. [1 mark]
b Determine the secondary host of the Hendra virus [1 mark]
Question 32 (7 marks)
Kiff is walking to work one winter morning and he is feeling extremely cold. His body is shivering as he walks, and his hands feel cold to the touch.
a Explain how shivering works as a thermoregulatory mechanism to conserve heat. [2 marks]
b Explain the thermoregulatory mechanism that might be causing Kiff’s hands to feel cold and how this mechanism works to prevent excessive loss of heat. [3 marks]
c When Kiff enters his heated office, he begins to feel excessively warm and begins to sweat. Explain how sweating acts as thermoregulatory mechanism to reduce body temperature. [2 marks]
Question 33 (8 marks)
During a bike ride on a hot day, India is feeling thirsty. She goes to take a drink of water from her bag, but realises she has forgotten her water bottle. She will need to wait until she cycles back home before she can have a drink of water.
a Identify the name of the type of receptor responsible for detecting changes in water levels in India’s blood. [1 mark]
b Explain whether the concentration of ADH in India’s blood on her way home would be higher or lower than normal. Justify your answer. [2 marks]
c Describe how the concentration of ADH identified in part b would impact the excretion of urine. [1 mark]
d When India returns home, she drinks a litre of water. Identify what would happen to the secretion of ADH after India drinks enough water to feel hydrated. Justify your answer. [2 marks]
e Identify whether the ADH feedback loop is an example of a positive or negative feedback mechanism. Justify your answer. [2 marks]
34 (7 marks)
Malaria is caused by a single-celled parasite called Plasmodium , which is transmitted to humans by Anopheles mosquitoes. The parasite infects red blood cells, growing and multiplying within the red blood cells until they rupture. If an Anopheles mosquito bites a malaria-infected person and then bites a non-infected person, that person can then become infected.
a Define what a vector is and identify the vector of malaria. [2 marks]
b Explain why malaria is considered an infectious disease but not a contagious one. [1 mark]
c Infectious diseases can re-emerge in different ways. Can malaria re-emerge after being controlled in a population, and if so, how? [2 marks]
d Describe two control measures that may be effective in controlling the spread of malaria in a population. Justify your answer. [4 marks]
Question 35 (6 marks)
A researcher is investigating the stomatal densities of two plant species, a water lily and a sunflower. After calculating the stomatal densities for the upper side and lower side of the leaf for each plant sample, they realise they have forgotten to label their samples. The calculated stomatal densities for the samples are provided in the table.
Plant sample Stomatal density (stomata/mm2)
Upper side of leaf
Lower side of leaf
Sample 1 420 0
Sample 2 198 140
a Use data from the table to infer which plants sample 1 and sample 2 correspond to. Justify your answer. [4 marks]
b Propose what type of environment each plant is adapted to live in, based on their stomatal densities. [2 marks]
Question 36 (7 marks)
Before there was a vaccine for varicella-zoster virus (the virus that causes chickenpox), some parents would arrange ‘pox parties’ where otherwise healthy children would play with an infected child. This would greatly increase the chance of their children contracting chickenpox through exposure to the virus by droplet spread or by touching an infected sore. Chickenpox is milder in children than it is in adults (where it may develop into shingles). Pox parties also allowed parents to plan for the illness that follows. Now that there is an effective vaccine for chickenpox, pox parties are discouraged by medical professionals.
a Identify whether chickenpox is spread through direct or indirect contact. Justify your answer. [1 mark]
b Chickenpox is typically only caught once in a lifetime. Some people with compromised immune systems can catch chickenpox more than once. Using your knowledge of the adaptive immune system, explain why most people only contract the disease once. [4 marks]
c A person’s immunity to chickenpox can build after becoming infected from another individual or by receiving the chickenpox vaccine. Compare these forms of immunity in terms of whether they are active or passive, and natural or artificial. [2 marks]
oup.com.au oxford-university-press-australia-new-zealand facebook.com/oupanz @OxfordAustraliaNZ